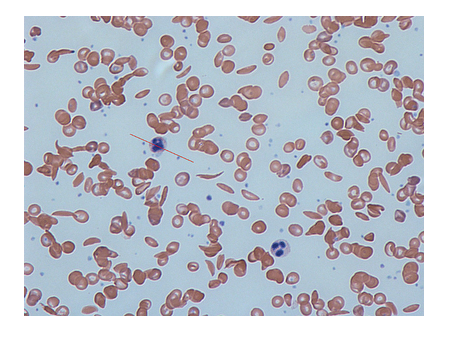

We are happy you have joined us in our exploration of the fundamental principles of
biology. Biology is the scientific study of life. Biologists are scientists who study
living organisms.
Life is everywhere. Biologists study the human body and figure out how it works when it
is healthy, and compare that to the way it works when things go wrong. They study the
bacteria that live in your digestive system and explore the reasons why these bacteria
are critical to your health. They study mice and flies and yeast and plants and learn
about how living organisms are alike, and how they are different.
 Biology montage. Photographs donated by Eric Guinther, 2004.
Wikimedia.
Biology montage. Photographs donated by Eric Guinther, 2004.
Wikimedia.
Different kinds of biologists study different things. Cell biologists are currently
researching the causes and symptoms of various types of cancer, enabling doctors to find
cures and treatments. Ecologists are biologists who specialize in studying the way that
living organisms interact with their environments. They examine important issues such as
acid rain and observe what happens to the health of living systems when acid rain falls.
There are even specialized biologists, called astrobiologists, who study conditions on
other planets and design experiments to determine whether or not life could exist in
other places in our solar system.
Understanding biology can help us understand ourselves and the environment around us. For
example, understanding how climate change affects ecosystems will help identify the ways
in which sustainable food production can keep up with a growing human population.
Biological research is constantly adding to our understanding of human health and
disease, and often results in treatments that lead to longer, healthier, and more
productive lives. Biological research can also help address the growing demand for
renewable energy and sustainable resource use.
Being a Critical Consumer of Information
Every day we are bombarded with information about health issues, new vaccines and
medicines, ecological problems, and other issues related to biological research.
This information comes at us from a myriad of diverse sources, including
friends, healthcare providers, the media, your neighbors, and the Internet. As
you gain a deeper understanding of life and the processes that sustain it, you
will be able to more effectively sort through and interpret this deluge of
information, and make informed decisions about your health and how you interact
with the environment.
 Every day, we are bombarded with reports of new discoveries in biology
that are exciting, relevant, and sometimes controversial. See University of Oxford (2012, June
18)
Every day, we are bombarded with reports of new discoveries in biology
that are exciting, relevant, and sometimes controversial. See University of Oxford (2012, June
18)
After completing this course, you will have a basic understanding of biological
principles and how they relate to your life.
|
Portions of this course are built on materials developed and generously
provided by University of Maryland University
College, made available with permission under a CC-BY-NC
license. Direct use of specific activities and media elements are noted
throughout the course.
|
References
- University of Oxford(
June,
2012).
"'Facebook for animals' tested on wild great tits." ScienceDaily. Retrieved June 20, 2012, from
http://www.sciencedaily.com/releases/2012/06/120618150519.htm.
The purpose of this course introduction is to prepare you conceptually and technically for the
course. Since you may not have experienced an online course like this before, we will
start with a short section describing the course and offer some learning strategies that
will help you use the materials most efficiently. Finally, we will discuss what biology
is all about — the "big
picture"
— our framework for exploring the relationship between the themes in
biological research and the fundamental concepts and principles included in this course.
Information in this course is organized into units. Each unit begins with an introduction that
orients you toward the major themes you’ll explore in that section. The unit
introduction will also show you how the content fits into the course as a whole. Each
unit consists of several modules. Modules are like chapters in a book, and when you
start a new module, you will see the list of learning outcomes you will achieve after
completing that section of the course. Each module consists of several pages designed to
help you achieve the learning outcomes. The introduction highlights what you will learn
and how it relates to the big picture. The following pages make up the informational
“meat” of the module. This explanatory content consists of short passages of text with
information, examples, images, and explanations. As you work through the content, you
will have many opportunities to practice what you are learning. The practice usually
takes one of two forms:
-
“Learn By Doing” activities give you the chance to practice
the concept that you are learning, with hints and targeted feedback to guide you if
you struggle.
-
“Did I Get This?” activities give you the opportunity to do
a quick "self-check" to assess your own understanding of the material before
completing a graded quiz.
Directed feedback during these learning activities will help you stay on track as you
assimilate new information. Most modules will also include an “Application Spotlight” that gives you the opportunity to apply your
understanding of the module’s content to a specific case study or real-life example.
After completing a module, you will have a chance to demonstrate what you learned by taking a
graded quiz. The module quizzes will assess and reinforce your learning as you progress
through the unit. When you complete all the modules in a unit, you can participate in a
“My Response” activity, where you will assess your own
understanding of the unit content. After reflecting on your ability to achieve the
learning objectives, you will have a chance to submit questions to your instructor, and
then you will conclude your activities with a unit quiz.
Other Course Features
You can navigate through this course using the navigation bar at the top of the screen, the
course syllabus, the course outline, and the page number box. All are accessible
on any page in the course.
Also provided is an Appendix, which includes information such as a
glossary of key terms and their definitions, a table illustrating the various
ways biologists represent chemical structures, and an interactive image of the
cell (the smallest unit of life).
This course is divided into 10 units. This first unit, "Biology:
The Science of Life,"
lays the foundation upon which the rest of the course is built. This
unit begins by defining
biology and characterizing its relationship to other fields of
scientific study. It then elaborates on a few of the themes that emerge
over and over throughout this course.
Finally, in this unit you will explore the nature of science. This
introduction represents the toolkit
you’ll need to understand the rest of the course, and will enable you
to create context
for all the new information you will learn.

The diagram above represents the "Big Picture" of biology. It illustrates how the course
is organized and depicts the relationships between the main topics you will learn about
as you progress through the material. You will find that as you go, the material is telling a
story. It is a story based on the research and collaboration of centuries of scientific
thinkers. The story begins with the smallest particles of matter: atoms. Atoms are the
building blocks of all matter and they can be put together, like Legos, to form
molecules. A special class of molecules called biomolecules are the “legos” used to
build the structures required for life. The fundamental unit of life is the cell, and all
cells are made of biomolecules. The cell is the first level of organization to display
all the characteristics of life. Cells, and all living organisms, require energy to
function. Organisms capture and use energy through a chain of chemical reactions called
metabolic processes. The energy that cells capture through metabolism can be used to do
work, including the work required for reproduction. All living organisms reproduce,
passing their genetic information from generation to generation. This results in a unity
and diversity of all living organisms, because we all share a common ancestor. Some
organisms are more likely to survive than others, and this leads to evolutionary
processes that result in the incredible diversity of life you see around you. The final
chapter in the story reminds us that the diversity of life exists within a rich context
of interactions, causes, and effects. Life does not take place in a vacuum; instead,
living organisms rely intimately on other living organisms, as well as in the nonliving
environment. All matter, living and nonliving, exists within a delicate interconnected
balance, and humans are just one part of this biosphere.
This is a fascinating story and one that inspires a deep understanding and appreciation of the
living world within us and around us. As we study the fundamental principles of biology,
we will systematically explore the following characteristics of life.
1. Life is organized into hierarchical levels.
Atoms are tiny particles that are put together to build living organisms. While
atoms do not possess life, they are required for life. The atom
is the smallest organizational level that we will explore in this course, and
you will learn more about atoms in Unit 2: Introduction to
Chemistry. You will also learn how atoms can be linked together by
chemical bonds to form molecules. In Unit 3: Biological Macromolecules,
you will focus on the four classes of carbon-based macromolecules that comprise
living systems: carbohydrates, fats, proteins and nucleic acids.
2. Life maintains internal stability through a process called
homeostasis.
Atoms and molecules are not alive. After exploring the world of atoms and
molecules, you will learn how these building blocks are put together to
construct the fundamental unit of life: the cell. The cellular level of
organization is the first time all the characteristics of life emerge, resulting
in a structure that is able to maintain its own internal constancy. In Unit
4: The Cell, you will learn how the unique structures that make up a
cell enable it to maintain homeostasis and carry out the varied functions of
life.
3. Life requires energy.
Energy is required to sustain life and all living organisms need energy to fuel
their metabolic activities. Some organisms get this energy directly from the sun
through the process of photosynthesis. Other organisms harvest their energy from
the food they eat. Humans are an example of organisms that obtain energy from
food. In Unit 5: Metabolism, you will take a closer look at what energy
is and explore how different cells acquire and use energy.
4. Life grows, develops, and reproduces.
All living things grow, develop and reproduce. We will focus on the ways
different types of cells reproduce themselves in Unit 6: Cell Division.
Genetic information in cells provides the instructions for carrying out life
processes. In order for life to continue, organisms must pass information to the
next generation. How genetic information is passed from one
generation to the next is discussed in Unit 7: Classical Genetics. The physical traits
an organism displays are ultimately determined by the DNA found within the
organism’s cells. In Unit 8: Molecular Genetics, we will connect
heredity to DNA, the genetic material of the cell. We will specifically explore
DNA function and figure out how DNA determines the heritable traits that
individual organisms can pass to their offspring.
5. Life evolves.
Life changes and evolves over time. In Unit 9: Evolution, you will
examine the process of evolution taking place within populations of organisms.
This unit will explicitly link evolutionary change with the heritable
characteristics you will learn about in Classical Genetics and
Molecular Genetics.
6. Life is interdependent.
You will conclude your exploration of biology by learning about the interactions
between groups of living organisms and their environments. Unit 10:
Ecology discusses how humans are part of a living biosphere and how
our actions, both intentional and inadvertent, have widespread consequences.
Biology is the scientific study
of life and is the branch of science that studies living organisms and the way organisms
interact with their environments. The subject is vast and includes topics as diverse as
acid rain, evolution, and genetically modified foods. In this module, you will
investigate the definition of life and explore some of the characteristics of living
systems.
 Biologists study many varieties of living organisms. Clockwise from top left:
salmonella bacteria; a koala bear; a fern plant; fly amanita, a poisonous
fungus; the red-eyed tree frog; a tarantula. Source: Andrew Colvin; August,
2010; Wikipedia. Biologists study many varieties of living organisms. Clockwise from top left:
salmonella bacteria; a koala bear; a fern plant; fly amanita, a poisonous
fungus; the red-eyed tree frog; a tarantula. Source: Andrew Colvin; August,
2010; Wikipedia.
|
 Biologists study how humans and other living organisms interact with their
environment. A couple from Northern Thailand. The husband is carrying the
stem of a banana plant, which will be fed to their pigs. Source: Manuel Jobi
Weltenbummler, 2007, Wikipedia. Biologists study how humans and other living organisms interact with their
environment. A couple from Northern Thailand. The husband is carrying the
stem of a banana plant, which will be fed to their pigs. Source: Manuel Jobi
Weltenbummler, 2007, Wikipedia.
|
Characteristics of Life
There are five distinct qualities used to determine whether or not something is
(or was) alive. A living organism is something that displays all these
qualities. To be considered alive, something must:
- Be made of materials organized in a hierarchical pattern.
- Use energy and raw materials to survive.
- Sense and respond to changing environments and maintain internal stability,
or homeostasis.
- Grow, develop and reproduce with the help of DNA.
- Evolve.
The cell is the smallest unit that displays all of these characteristics. Because
of this, living organisms are often identified based on whether or not they are
made of cells. Nonliving things can show several of these characteristics. For
example, a rock crystal can “grow” in a simple fashion. However, if even one of
these conditions is not met (rock crystals do not reproduce with help from DNA),
the object in question cannot be considered alive.
Classification of Matter
Matter is any substance that has mass and takes up space. All matter can be classified in one
of two categories: biotic (living) or abiotic (nonliving). Matter is considered biotic if it was ever
alive at some point in time. In this sense, a dead human buried underground in a
wooden coffin is still biotic, as is the wood used to make the coffin (the wood
came from a tree that was once alive). However, not everything within, or made
by, a biotic organism is biotic. For example, urea, a chemical component of
urine, is an abiotic substance.
To be classified as biotic, all of the required conditions for life must be met or have been
met in the past. Otherwise, the matter being classified is considered to be
abiotic, or nonliving.
Levels of Organization
Observe the following diagram.
All living things consist of smaller parts that are organized in a hierarchical
way.
Living things are highly organized and structured, following a hierarchy that can
be examined on a scale from small to large. In this course, the smallest level
we will examine is the atom, which is the basic unit of matter. The atom consists of a
dense nucleus surrounded by electrons. Atoms join together to form molecules. A
molecule is a
chemical structure consisting of at least two atoms held together by a chemical
bond. Macromolecules are biologically important molecules, and they are
technically polymers. Polymers are made by combining smaller units called
monomers, which are simpler macromolecules. An example of a macromolecule is the
genetic molecule deoxyribonucleic acid (DNA) that contains the instructions for
the development of all living organisms. DNA is built of four kinds of monomers
(nucleotides). They are strung together, or polymerized, in a sequence that
codes for the structure of proteins and other biological molecules. The DNA in
one of your microscopic cells contains a sequence of almost three billion
nucleotides.
When macromolecules are used as building blocks to form a membrane-bound sphere,
you have a cell, which is
the fundamental unit of life. A cell is essentially a tiny droplet of water and
other molecules enclosed by a fluid “skin” or membrane. The cell is the smallest
and simplest entity that possesses all the characteristics of life. There are
two main types of cells: prokaryotes and eukaryotes. The cells of prokaryotes
are relatively small and simple; they do not have any clearly defined
compartments inside of them. The cells of eukaryotes, by contrast, include
membrane-bound organelles: compartments inside the cell that contain specific
groups of macromolecules and carry out specific cellular functions. One of these
organelles is the nucleus; it encloses the DNA within the cell.
Some organisms consist of just one cell and include unicellular organisms such as
bacteria and protists. Single-celled life forms are typically referred to as
microorganisms. Other organisms consist of many cells working
together. These multicellular organisms include animals, land plants, and most
fungi. Most multicellular organisms have cells that are specialized to carry out
specific functions. Tissues are formed when many different kinds of cells work together
to fulfill the same detailed function. Organs are collections of tissues that work
together to carry out a common general function. Organs are present not only in
higher level animals but also in plants. An organ system is a higher level of
organization that consists of functionally related organs. Mammals have many
organ systems. For example, the circulatory system transports blood through the
body and includes organs such as the heart and blood vessels. Organisms are individual
living entities that survive and reproduce as a unit. For example, each tree in
a forest is usually an individual organism.
Consider this example to help clarify the nature of the levels between a cell and
an organism. A human is an organism which has a circulatory system (organ system) that transports blood through the body.
It is made up of organs such as the heart and blood vessels. Each of the organs,
in turn, is made of more specific tissues. Your heart, for example, has muscle
tissue for pumping and nerve tissue that helps coordinate each heartbeat.
The hierarchical organization of living systems continues beyond single
organisms. A population consists of all the individuals of a species living
within a specific area. For example, a forest may include many pine trees. All
those pine trees represent the population of pine trees in that forest. As you
know, many different populations can live in any specific area. All of these
populations can interact with each other in positive and negative ways, and
together they form a . Continuing with our example, the forest with pine trees
includes populations of flowers, mammals, birds, insects, fungi, and bacteria,
all of which can interact. These interacting populations make up a community. An
ecosystem
consists of all the living things in a particular area together with the
abiotic, or nonliving, parts of that environment. The pine forest ecosystem
includes not just plants, animals, and microbes but also rocks, water,
temperature changes, air chemistry, and other abiotic factors that interact with
living organisms in the area. Finally, the highest level of organization in
living systems is the biosphere, which is the collection of all ecosystems on Earth. The
biosphere includes all habitable zones on the planet, including land, soil, and
rocks to a great depth in the Earth’s crust; water and ice; and the atmosphere
to a great height.
Life: An Emergent Property
Life is organized into hierarchical levels of increasing complexity. The study of
biology involves all these levels, from single atoms or molecules up to global
relationships among organisms and the environment. As we ascend through this
hierarchy to more and more complex levels, emergent properties appear. These are
characteristics of a system that are not present in any of its component parts.
Take, for example, an automobile. The separated parts of the automobile amount
to a heap of junk. Only when properly assembled, with gas, the right key, and a
human driver, does the car fulfill its function, which is to transport us from
place to place.
Emergent Properties
 Emergent properties are visualized in this diagram. If you zoom in on
the photograph, it eventually appears as a collection of individual pixels,
each of one color. Only when seen in relationship to each other do these
pixels make sense as an image. If you zoom in on a cell, it looks like a
random mixture of molecules. Only when they are organized within a cell do
these molecules work together to permit life.
Emergent properties are visualized in this diagram. If you zoom in on
the photograph, it eventually appears as a collection of individual pixels,
each of one color. Only when seen in relationship to each other do these
pixels make sense as an image. If you zoom in on a cell, it looks like a
random mixture of molecules. Only when they are organized within a cell do
these molecules work together to permit life.
Life is an emergent property, and one that appears at the cellular level of organization.
Molecules are not alive, but they are the components of life. More than 2,000
years ago, Aristotle said “The whole is much greater than the sum of its parts.”
In biology, this is a constant theme: we can learn much about a system by
looking at its details, but we also must step back and look at the big picture
to truly understand the workings of life.
Have you ever gotten sick with the flu and said something like, “I’ve come down with a bug,” or
“I’ve got the flu bug”? In fact, the flu (short for influenza) is not really caused by a
“bug” at all. It is caused by a virus, and there is some controversy in the scientific
community regarding whether or not viruses are alive. But what are viruses, really? And
how would you determine whether or not they are alive? In this lesson, you’ll learn more
about what viruses are, so you can figure out if they are actually alive.
Components of a Virus
 Viruses contain genetic material within a protein or membrane coat.
Viruses contain genetic material within a protein or membrane coat.
Viruses contain genetic information in the form of either DNA or RNA. The genetic
information is surrounded by a protein coat called a capsid. Some viruses also have a
membrane structure surrounding their genetic information. Viruses are tiny particles and
they lack the machinery necessary for growth and reproduction. In order to reproduce, a
virus must infect a host cell and hijack the host cell’s machinery. In other words, a
virus cannot reproduce without using the tools of another cell.
So are viruses alive? There is much debate on the subject. Complete the following
activity and draw your own conclusions.
Throughout the study of biology, several themes emerge. These recurrent concepts will
continually appear as we delve deeper into the scientific study of life. As we progress
through the course, we will highlight the lessons that help to illustrate these six
themes:
- Structure determines function.
- Living organisms maintain homeostasis.
- Energy flows through living systems; matter is recycled.
- Life’s components are interconnected and interdependent.
- Organisms grow, develop, and reproduce.
- Evolutionary processes explain both the unity and adaptive diversity of life.
In this module, we will explore an overview of each of these themes separately.
Biologists describe how organisms are put together (structure) and explain how organisms
stay alive, move, grow, reproduce, and do other activities (function). In biological
systems, the structure of a cell or body part is tightly linked to its function within
the life of the organism.
The structure of something is determined by two factors: its three-dimensional shape, and the
materials from which it is made. The structure that something takes directly influences
its possible functions. Consider a piece of wood. Depending on how it is shaped, it
could be used as a spear for hunting, a cup for drinking, a pipe for smoking, or even a
flute for playing music. The wood also possesses unique properties that influence how it
can be used. For example, the piece of wood could never function as a hot air balloon,
no matter what kind of shape it took. It would always be too heavy to lift off the
ground.
At the smallest levels of biological organization, the structure of a molecule determines
its function within a cell. In this course, you might investigate the structure of a
molecule and then learn what it does. It will help you to remind yourself: the structure
and the function of this molecule are connected.
Enzymes are molecules found within a
cell that speed up the rate of the chemical reactions necessary to support life. Enzymes
break down food molecules, help build muscle proteins, can destroy toxins, and much
more. An enzyme’s ability to function depends directly on its three-dimensional shape.
If exposed to excessive heat or harsh chemical conditions, enzymes unravel and change
shape. When this occurs, the enzymes stop working and the chemical reactions of life
slow down or cease.
At a larger scale, the structure of a cell is directly linked to its function within the
body of a multicellular organism. Compare the following images of some different cell
types and explore how structure relates to function at the cellular level.
 First division of a sea urchin cell just after egg and sperm join to start the life
cycle. The cells are relatively large, because they are full of nutrients
that will be used to feed the developing animal. Otherwise, there is little
noticeable structure to the cells. Their main function at this point is
simply to divide, laying the groundwork for future more specialized
generations of cells within the body. (Source: Evelyn Spiegel and Louisa
Howard, The Cell Image Library) First division of a sea urchin cell just after egg and sperm join to start the life
cycle. The cells are relatively large, because they are full of nutrients
that will be used to feed the developing animal. Otherwise, there is little
noticeable structure to the cells. Their main function at this point is
simply to divide, laying the groundwork for future more specialized
generations of cells within the body. (Source: Evelyn Spiegel and Louisa
Howard, The Cell Image Library)
|
 Developing nerve cells in the spinal cord of an embryo. When mature, the reddish
structures will connect to other cells to relay nerve signals. Right now
they are exploring the environment, responding to chemical signals, and
growing toward their destinations. This function is supported by the
branching “hand-like” structure; these cell structures are chemically
“feeling their way along” through the embryo. The long thin yellow
structures will act as cables, carrying signals over long distances — just
as their structure suggests. Developing nerve cells in the spinal cord of an embryo. When mature, the reddish
structures will connect to other cells to relay nerve signals. Right now
they are exploring the environment, responding to chemical signals, and
growing toward their destinations. This function is supported by the
branching “hand-like” structure; these cell structures are chemically
“feeling their way along” through the embryo. The long thin yellow
structures will act as cables, carrying signals over long distances — just
as their structure suggests.
|
 Lining of a human oviduct, or fallopian tube. This view shows several
cells. Together they form a lining. They are shaped to form a sealed
surface. Broom-like structures sprout from the exposed surface of each cell.
These beat against the fluid in the tube, creating a gentle current that
moves the egg cell toward the uterus, where it may implant to begin a
pregnancy. Lining of a human oviduct, or fallopian tube. This view shows several
cells. Together they form a lining. They are shaped to form a sealed
surface. Broom-like structures sprout from the exposed surface of each cell.
These beat against the fluid in the tube, creating a gentle current that
moves the egg cell toward the uterus, where it may implant to begin a
pregnancy.
|
 Hair cells in the inner ear of a guinea pig. These cells are shaped so that they are
easily disturbed by vibrations. When they are flexed, a signal passes to
nerve cells that take the message to the brain, where it is interpreted as
sound. (Source: Dr. David Furness, Wellcome Images) Hair cells in the inner ear of a guinea pig. These cells are shaped so that they are
easily disturbed by vibrations. When they are flexed, a signal passes to
nerve cells that take the message to the brain, where it is interpreted as
sound. (Source: Dr. David Furness, Wellcome Images)
|
Structure also determines function at higher levels of biological organization. Your body’s
organs function as they do because of how tissues are put together, forming filters,
pumps, levers, surfaces for gas exchange, and pipes for air and fluid flow. And, of
course, the entire body of an organism is suited to its lifestyle and environment. For
example, the earthworm is well-suited for burrowing: it is slimy, muscular, flexible,
and cylindrical. Yet there are many surprising details in the worm’s structure. The next
time you get the chance, feel an earthworm. Pinch it carefully
near the head with one hand, then rub your free forefinger against its belly. You’ll
notice prickly hairs on the worm’s underside. And you’ll find that you only feel them
when you move your finger toward the worm’s head: the hairs are set at an angle,
enabling the worm to grip the soil to and move it forward through the earth.
You can probably imagine other ways to use different shapes and materials to build a
functional body that enables Structo to overcome many different challenges.
Environmental pressures have led (and continue to lead) to the evolution of organisms
with a virtually infinite range of such combinations.
In fact, organisms are so well adapted to their environments that humans are now looking to
them for inspiration. Today, a fast-growing field called biomimicry brings biologists
together with engineers to develop new products based on solutions found in nature. One
of the earliest products of this approach was the invention of Velcro (the hook and loop
attachment) by Swiss engineer Georges de Mestral. He was inspired by the burrs that got
stuck in his dog’s fur. To learn more, visit the Biomimicry Institute.
Living organisms detect and respond to changes in the conditions of their external
environment. In response to threats and opportunities, organisms may move or change
their activities. For example, plant stems can grow toward a source of light. Over time,
the trunks of trees strengthen when they are flexed by the wind. Animals, of course,
respond to stimuli with a huge range of behaviors from the hibernation of bears to your
own development of “goosebumps” on a chilly day.
In contrast to the extreme variability of the outside world, the interior of a cell is a
remarkably constant environment. For example, cells typically keep their internal pH
(acidity) within a narrow range. This is important because changes in pH can cause
molecules like enzymes to change their shapes. As you already know, a molecule’s shape
(or structure) determines its function. If its shape changes, it may lose function.
Because of this, many of the chemical reactions of life will not work properly if cell
conditions change too much.
The ability or tendency of organisms and cells to maintain stable internal conditions is
called homeostasis. The
term homeostasis comes from the Greek words homeo (same, alike)
and stasis (standing). It describes how life stands in one place
despite many changes in the surrounding world.
Environmental conditions can also affect cellular homeostasis. If the cell’s surroundings
change quickly, conditions inside the cell may be temporarily disturbed. Organisms react
to these changes in a corrective way: they detect changes and do something to oppose
them. For example, when you get cold, your muscles start to contract in rapid bursts,
causing you to shiver. The process of shivering then generates heat that warms you back
up again. As a result of this and other adjustments, your temperature is maintained
close to 99 degrees F (Fahrenheit) [37 degrees C (Celsius)]. At this temperature, your enzymes work very
efficiently.
Homeostasis is an important theme in biology. All living systems use resources to
maintain homeostasis. When cells fail to maintain homeostasis, disease results.
Ultimately, if homeostasis is not restored, an organism will die.
Matter
Matter is traditionally
defined as anything that has mass and takes up space. Matter is made of atoms. Matter is reused and
recycled in living systems. To live and grow, organisms and cells must take in
(or absorb, or ingest) certain forms of matter. Any matter an organism needs but
cannot make for itself is considered a nutrient for that
organism. Not all matter can be used by an organism, which is why all living
systems release other forms of matter. When an organism or cell releases (or
excretes) matter, the excreted matter is considered waste for that organism.
Wolves Fighting a Grizzly Bear
 By Adolph Murie, 1944, National Park Service. Source: Wikipedia.
By Adolph Murie, 1944, National Park Service. Source: Wikipedia.
Both nutrients and
wastes are made of atoms; they occupy space and have mass. The atoms retain their identity
through the processes of life, even though they can be combined with other atoms
in different ways. Consider the picture above. When a wolf is eaten by a bear,
the atoms that made up the wolf become part of the bear. The matter in the wolf
that is not absorbed or used for growth by the bear becomes waste. The bear
excretes this waste in urine, in feces, and in its exhaled breath. Atom for
atom, all the matter that was the wolf can be accounted for, and it is recycled
through the ecosystem. The waste produced by one organism can provide nutrients
to another.
Energy
Energy can be defined as
the capacity to do work or to make a change in the location, temperature, or
structure of matter. Energy does not have mass and it does not take up space,
but it can be measured in terms of what it does. Energy comes in many forms,
including heat, chemical potential energy, kinetic energy of motion, and light.
Energy is required for all organisms to maintain homeostasis, grow, and
reproduce.
Living Organisms Emit Heat
 Human leaking heat energy into his environment. Photo on left was taken
with a heat-sensitive camera; photo on right with a normal camera sensitive
to visible light. On left, warmer regions are brighter yellow or orange. The
plastic bag draped over the man’s arm is transparent to heat radiation. His
eyeglasses, however, tend to absorb or deflect heat.
Human leaking heat energy into his environment. Photo on left was taken
with a heat-sensitive camera; photo on right with a normal camera sensitive
to visible light. On left, warmer regions are brighter yellow or orange. The
plastic bag draped over the man’s arm is transparent to heat radiation. His
eyeglasses, however, tend to absorb or deflect heat.
It is important at this point to clarify the difference between
matter and energy and to
highlight a form of energy that is very important in biology. Food contains
nutrients that are useful to humans. These nutrients take up space and can be
weighed. Imagine a serving of breakfast cereal. You can weigh and measure the
volume of its nutrients, and on food labels nutrient content (the amount of fat,
carbohydrates, protein, etc.) is reported in grams. But the same serving of
cereal also has a property called chemical potential
energy. This is energy stored in the structure of molecules that can be
converted to other forms of energy by a chemical reaction. If the cereal is
burned (a chemical reaction), its molecules will react with oxygen gas. Atoms
will change partners and the molecules will become much simpler. In the process,
energy will be released as heat and light. We can determine the amount of energy
in the cereal by burning it and measuring how much heat is released in the
process.
Food Nutrition Label
 Source: The U.S. Food and Drug Administration
Source: The U.S. Food and Drug Administration
In biology, chemical potential energy is a key form of
energy. It is measured in units called calories. When we’re talking about
energy, we’ll say “the calories stored in ...” or “the chemical potential energy
of ...” a substance. We are talking about what the substance can do if it is put
through a chemical reaction, like burning, that will release its stored energy.
Returning to the breakfast cereal example, nutrition labels indicate the
chemical potential energy of food by listing the calories per serving.
Energy and Matter Behave Differently
Energy and matter move through living systems in different ways. Energy flows through
living systems, changing forms as it goes. For example, the energy in sunlight
is captured by green plants, which use this energy to build sugar molecules. The
energy from the sun is now stored in the sugar and when an organism eats the
sugar, the stored energy can be harvested and used to do work. The energy flows
through the system; it is never recycled. Matter, on the other hand, cycles within
living systems. For example, the atoms in the sugar molecule start out as
nutrients, and will ultimately become waste. The waste might become nutrients
for something else. Those same atoms will be used over and over again. Energy
flow and nutrient cycling are themes in biology at every level.
Interdependence and Interconnectedness of Life
|
Have you ever played a game of Jenga, where you try to remove one block
at a time from a tower structure without causing the entire tower to
collapse? In this game, each block depends on the other blocks for
stability, and if you’re not careful, the removal of a single block can
cause the destruction of the entire structure. Life is much the same. At
levels from the individual to the biosphere, the various parts of living
systems are interdependent.
Your trillions of cells are intimately dependent on each other for
survival. Your cells are specialized, and you exist because of a massive
team effort from all these different cells. If any one of your major
organs were to suddenly fail, you might die very quickly. Moreover, your
health also depends on trillions upon trillions of bacterial cells that
live in and on your body. They provide your cells with vitamins, help
keep out invaders, and may even influence your mood. So your body itself
is a community of interdependent cells.
|
Jenga Game
 Source: Jorge Barrios, 2007; Wikipedia Source: Jorge Barrios, 2007; Wikipedia
|
An ecosystem consists of all the organisms living within a defined area along
with the abiotic
components of that particular environment. Within an ecosystem, organisms
interact with each other in helpful and harmful ways. Some types of organisms
play overlapping roles with other species (e.g., six species of oak tree may
have similar, if not identical, roles in a forest). Others, however, play unique
and essential roles that other organisms depend upon for their survival. For
example, in a Colorado forest, researchers found that a species of sapsucker (a
bird similar to a woodpecker) played a vital role in providing nesting holes and
food for many other species.
To learn more: Gretchen Daily and others, 1993. Double keystone bird in
a keystone species complex.
All organisms grow and develop. Growth is just an increase in size. In development, structure and function change in an
orderly way as an organism passes through its life cycle. An individual’s pattern of
development is partly determined by genetic instructions. DNA, the molecule of
inheritance, encodes proteins and other molecules that build cells and make them work.
You can think of genes as “recipes” for proteins. Each cell has a huge library of
thousands of recipes in its DNA. But most of the recipes don’t get used in any given
cell. Chemical controls tell the “cooks” whether to make a given protein, or ignore its
recipe and make something else. Therefore, even though your cells share the same DNA,
their activities change radically in different parts of your body and at different
stages of development.
Used by permission from R.O. Karlstrom and D.A. Kane. Published:
Development, 1996, Dec;123:1-461.
In this time-lapse video, a few days of development are sped up for your viewing
pleasure. In the earliest frames you can see large cells dividing. With each division
the individual cells get smaller. Chemical signals in each cell are passed to its
descendants and to nearby cells. As a result, DNA is turned “on” or “off” in each cell,
leading to different shapes and structures. Toward the middle and end of the video,
individual cells are much too tiny to see. Specialized cell types form. Cells move from
place to place, grow, die to create gaps, and divide to create bulges. In this way, body
structures begin to emerge.
Reproduction occurs when an individual organism passes on its genetic information to a
newly independent organism, or offspring. Individual organisms have a limited life span.
All are subject to extreme events that bring death, such as being eaten by a predator.
Even if they avoid such a fate, most organisms decline in health and die toward the end
of their typical life span. Reproduction maintains genetic information by passing it to
new individuals. Offspring resemble their parent(s) and reproduction maintains the
continuity of life over time.
Evolution is a scientific
theory that explains how and why life changes over time. Evolution provides the
explanation for why all living organisms share profound similarities, and yet, the life
forms on our planet are so incredibly diverse. The two fundamental tenets of evolution
are shared ancestry and natural selection.
Shared Ancestry
As you learned previously in this module, reproduction results in the passing of
characteristics from parents to offspring and maintains the continuity of life.
You can see this in a family photograph: offspring resemble their parents and
siblings resemble each other. Biologists look at all life on the planet and see
the same patterns.
According to evolutionary thinking, life forms are similar because of their
shared ancestry. All cells have DNA as the molecule of inheritance and they also
share many other detailed features. Organisms and cells always come from
parents, and this is where they get their genetic information. Trace this
process back in time, and it is reasonable to suppose that all life forms
inherited DNA and many other features from a long-ago common ancestor. The unity
of life is very striking when we examine molecules, which can be almost
identical in species as different as bacteria and whales. This unity of
structure and function is also evident when we compare skeletons, kidneys, or
hearts among animals.
Charles Darwin’s Sketch of the Tree of Life
 Sketching in his notebook in 1837, Charles Darwin created the first
diagram of a phylogenetic tree. It shows several life forms related to each
other by ancestry. The neighboring “twigs” in the lettered groups are
similar species. Eventually Darwin would propose that ALL life forms find a
place on one tree, and that it began with one or just a few very simple life
forms long ago.
Sketching in his notebook in 1837, Charles Darwin created the first
diagram of a phylogenetic tree. It shows several life forms related to each
other by ancestry. The neighboring “twigs” in the lettered groups are
similar species. Eventually Darwin would propose that ALL life forms find a
place on one tree, and that it began with one or just a few very simple life
forms long ago.
Natural Selection
The second major idea of evolution is that of natural selection. Natural selection helps
explain how groups of organisms become well-suited, or adapted, to their
surroundings. Individuals are always a bit different from their parents and from
each other, partly because of changes to their genes. These differences may be
helpful or harmful to the individuals that inherit them. In nature, individuals
often have very low odds of surviving to reproduce. Individuals with slightly
harmful or even average characteristics might be less likely to make it, and
those with traits that fit in very well with the local habitat will have the
greatest chance to survive and reproduce. This sorting process goes on
generation after generation. Each time only a tiny fraction of those born are
well-suited and lucky enough to pass their genes along; the others die, leaving
no descendants. As generations of time pass, inherited features that help
organisms produce offspring become more common within a population. Harmful
features that reduce reproduction become less common. Many experiments have
demonstrated the effects of natural selection on populations in the laboratory
and in nature. The process of natural selection is one way that scientists have
explained the vast diversity of life on our planet.
Dandelions Illustrate Features of Natural Selection
 This photo shows a crowd of dandelions, all striving to reproduce. Each
plant may produce hundreds of seeds, but only a few of them are likely to
grow up to produce seeds of their own. In each generation there is a great
sorting process, with most offspring (in this case, seeds and seedlings)
dying young. Only a few survive to reproduce themselves. These survivors are
probably quite well-suited to local conditions, and they will produce
offspring with similar traits.
This photo shows a crowd of dandelions, all striving to reproduce. Each
plant may produce hundreds of seeds, but only a few of them are likely to
grow up to produce seeds of their own. In each generation there is a great
sorting process, with most offspring (in this case, seeds and seedlings)
dying young. Only a few survive to reproduce themselves. These survivors are
probably quite well-suited to local conditions, and they will produce
offspring with similar traits.
Science is a powerful tool used to understand the natural world. It is the process that
has resulted in the knowledge we are exploring in this course. However, the process of
science does have limitations. In other words, there are some questions that science
cannot be used to answer. For example, science cannot answer questions about
supernatural things. It also cannot be used to make moral or aesthetic judgments. While
questions of these types may be important for humans to explore, the process of science
cannot be used to study them.
In this module, the process of science will be discussed in more detail. Then you will
learn about how to design a quality scientific experiment. Finally, you will have the
opportunity to practice identifying examples of science and to compare those to examples
of pseudoscience, or things that claim to be scientific, but are not.
Science: What Is It?
Science is a process that helps us to understand how the natural world works.
When we use the term “natural” in this context, we mean all that can be observed
with our senses or with instruments that extend our senses. The “natural” world
studied by science can be reliably observed and measured, from the far reaches
of outer space to the man-made chemicals in our air and water. This module will
examine the process of science and explore how science has led to an increased
understanding of living organisms.
Biology: A Branch of Science
Biology is an example of a scientific field that deals with understanding living
organisms. Chemistry is a scientific field that deals with understanding atoms
and molecules. Overall, scientific fields can be broken down into two main
branches: natural sciences, and social and behavioral sciences. Social and
behavioral sciences focus on human cultures and the behaviors of humans in
groups and as individuals. Biology is a natural science that includes many
related sub-branches, such as ecology, biochemistry, and microbiology. Each
sub-branch of biology examines different aspects of living organisms. Other
natural sciences are physical sciences like chemistry and physics. It is
important to remember that even though scientific knowledge is broken into
branches and sub-branches of study, the knowledge gained from the various
scientific disciplines is interconnected. For instance, to understand how a cell
responds to a certain environmental signal, it is necessary to know about the
chemical composition of that signal, so the science of chemistry is important to
understand the science of biology. Likewise, understanding how the brain
functions (neuroscience) can aid in understanding the human behaviors studied in
the social and behavioral sciences.
Breakdown of Scientific Disciplines
 By University of Maryland University College CC-BY-NC. This
diagram shows the organization of the branches of science. Notice how
biology is broken down into many sub-branches, and is closely related to
physical sciences such as physics, chemistry, and geology.
By University of Maryland University College CC-BY-NC. This
diagram shows the organization of the branches of science. Notice how
biology is broken down into many sub-branches, and is closely related to
physical sciences such as physics, chemistry, and geology.
Science deals with testable knowledge about physical phenomena in the universe. The goal of
science is to understand how the universe works. Biology focuses on
understanding living things. To gain knowledge about nature and physical
phenomena, scientists use a particular approach called “scientific inquiry.”
Scientific inquiry is the best approach we have to understanding the natural world and
predicting natural phenomena. Evidence for this claim can be found in the
successes of science-based technologies. Take medicine, for example. Prior to
the 1700s, most medical practices were based on folk traditions or on ideas
promoted by religious leaders. Some of these prescientific remedies worked, but
the process for discovering new treatments was a slow and haphazard system of
trial and error. Ineffective treatments were often accepted simply because there
was no clear procedure for evaluating them. Today, with science-based medicine
and public health practices, we have gained unprecedented control over threats
to our health. According to the Centers for Disease Control, the average life
expectancy in the United States has increased by more than 30 years since 1900.
Scientific inquiry has not displaced faith, intuition, and dreams. These
traditions and ways of knowing have emotional value and provide moral guidance
to many people. But hunches, feelings, deep convictions, old traditions, or
dreams cannot be accepted directly as scientifically valid. Instead, science
limits itself to ideas that can be tested through verifiable observations.
Supernatural claims that events are caused by ghosts, devils, God, or other
spiritual entities cannot be tested in this way.
Scientific Methods
The rest of this module will focus on the methods of scientific inquiry. Science often
involves making observations and developing hypotheses. Experiments and/or further
observations are often used to test the hypotheses, and the data gathered are
carefully interpreted. Methods and results are then communicated to other
scientists within peer-reviewed scientific journals.
A scientific experiment is a carefully organized procedure in which the scientist
intervenes in a system to change something, then observes the result of the
change. Scientific inquiry often involves doing experiments, though not always.
For example, a scientist studying the mating behaviors of ladybugs might begin
with detailed observations of ladybugs mating in their natural habitats. While
this research may not be experimental, it is scientific: it involves careful and
verifiable observation of the natural world. The same scientist might then treat
some of the ladybugs with a hormone hypothesized to trigger mating and observe
whether these ladybugs mated sooner or more often than untreated ones. This
would qualify as an experiment because the scientist is now making a change in
the system and observing the effects.
When conducting scientific experiments, researchers develop hypotheses to guide
experimental design. A hypothesis offers a testable and falsifiable explanation
of observations. For example, a scientist might observe that maple trees lose
their leaves in the fall. She might then propose a possible explanation for this
observation: “cold weather causes maple trees to lose their leaves in the fall.”
This statement is testable. The scientist could grow maple trees in a warm
enclosed environment such as a greenhouse and see if their leaves still dropped
in the fall. The hypothesis is also falsifiable. If the leaves still dropped in
the warm environment, then clearly temperature was not the main factor in
causing maple leaves to drop in autumn.
In the activity below, you can practice recognizing scientific hypotheses. As you
consider each statement, try to think as a scientist would: can I test this
hypothesis with observations or experiments? Is the statement falsifiable? In
other words, is it possible to gather evidence that clearly indicates that the
statement is not true? If the answer is “no,” the statement is not a valid
scientific hypothesis.
Testing a vaccine
Throughout the rest of this module, we examine the scientific process by discussing an actual
scientific experiment conducted by researchers at the University of Washington
to investigate whether a vaccine may reduce the incidence of the human
papillomavirus (HPV). The experimental process and results were published in an
article titled, "A controlled trial of a human papillomavirus type 16 vaccine"
[1] , available for viewing online at the National Institutes of Health's online
database of publications: PubMed.gov
Preliminary observations made by the researchers who conducted the HPV experiment
are listed below:
- Human papillomavirus (HPV) is the most common sexually transmitted virus in the United
States.
- There are about 40 different types of HPV. A significant number of people that have HPV are
unaware of it because many of these viruses cause no symptoms.
- Some types of HPV can cause cervical cancer.
- About 4,000 women a year die of cervical cancer in the United States.
References
- Koutsky, L.A., Ault, K.A., Wheeler, C.M., Brown, D.R., Barr, E.,
Alvarez, F.B., Chiacchierini, L.M., Jansen, K.U.
(2002).
"A controlled trial of a human papillomavirus type 16 vaccine." New England Journal of Medicine. Volume 347(21).
You’ve successfully identified a hypothesis for the University of Washington’s study on
HPV: People who get the HPV vaccine will not get HPV.
The next step is to design an experiment that will test this hypothesis. There are
several important factors to consider when designing a scientific experiment. First,
scientific experiments must have an experimental group. This is the group that
receives the experimental treatment necessary to address the hypothesis.
The experimental group receives the vaccine, but how can we know if the vaccine made a
difference? Many things may change HPV infection rates in a group of people over time.
To clearly show that the vaccine was effective in helping the experimental group, we
need to include in our study an otherwise similar control group that does not get the
treatment. We can then compare the two groups and determine if the vaccine made a
difference. The control group shows us what happens in the absence of the
factor under study.
However, the control group cannot get “nothing.” Instead, the control group often receives a
placebo. A placebo is a procedure that has no expected therapeutic effect —
such as giving a person a sugar pill or a shot containing only plain saline solution
with no drug. Scientific studies have shown that the “placebo effect” can alter
experimental results because when individuals are told that they are or are not being
treated, this knowledge can alter their actions or their emotions, which can then alter
the results of the experiment.
Moreover, if the doctor knows which group a patient is in, this can also influence the results
of the experiment. Without saying so directly, the doctor may show — through body
language or other subtle cues — his or her views about whether the patient is likely to
get well. These errors can then alter the patient’s experience and change the results of
the experiment. Therefore, many clinical studies are “double blind.” In these studies,
neither the doctor nor the patient knows which group the patient is in until all
experimental results have been collected.
Both placebo treatments and double-blind procedures are designed to prevent bias. Bias is any
systematic error that makes a particular experimental outcome more or less likely.
Errors can happen in any experiment: people make mistakes in measurement, instruments
fail, computer glitches can alter data. But most such errors are random and don’t favor
one outcome over another. Patients’ belief in a treatment can make it more likely to
appear to “work.” Placebos and double-blind procedures are used to level the playing
field so that both groups of study subjects are treated equally and share similar
beliefs about their treatment.
A variable is a characteristic
of a subject (in this case, of a person in the study) that can vary over time or among
individuals. Sometimes a variable takes the form of a category, such as male or female;
often a variable can be measured precisely, such as body height. Ideally, only one
variable is different between the control group and the experimental group in a
scientific experiment. Otherwise, the researchers will not be able to determine which
variable caused any differences seen in the results. For example, imagine that the
people in the control group were, on average, much more sexually active than the people
in the experimental group. If, at the end of the experiment, the control group had a
higher rate of HPV infection, could you confidently determine why? Maybe the
experimental subjects were protected by the vaccine, but maybe they were protected by
their low level of sexual contact.
To avoid this situation, experimenters make sure that their subject groups are as similar
as possible in all variables except for the variable that is being tested in the
experiment. This variable, or factor, will be deliberately changed in the experimental
group. The one variable that is different between the two groups is called the
independent variable. An independent variable is known or hypothesized to cause some outcome. Imagine
an educational researcher investigating the effectiveness of a new teaching strategy in
a classroom. The experimental group receives the new teaching strategy, while the
control group receives the traditional strategy. It is the teaching strategy that is the
independent variable in this scenario. In an experiment, the independent variable is the
variable that the scientist deliberately changes or imposes on the subjects.
Dependent variables
are known or hypothesized consequences; they are the effects that result from changes or
differences in an independent variable. In an experiment, the dependent variables are
those that the scientist measures before, during, and particularly at the end of the
experiment to see if they have changed as expected. The dependent variable must be
stated so that it is clear how it will be observed or measured. Rather than comparing
“learning” among students (which is a vague and difficult to measure concept), an
educational researcher might choose to compare test scores, which are very specific and
easy to measure.
In any real-world example, many, many variables MIGHT affect the outcome of an
experiment, yet only one or a few independent variables can be tested. Other variables
must be kept as similar as possible between the study groups and are called control
variables. For our educational research example, if the control group consisted
only of people between the ages of 18 and 20 and the experimental group contained people
between the ages of 30 and 35, we would not know if it was the teaching strategy or the
students' ages that played a larger role in the results. To avoid this problem, a good
study will be set up so that each group contains students with a similar age profile. In
a well-designed educational research study, student age will be a controlled variable,
along with other possibly-important factors like gender, past educational achievement,
and pre-existing knowledge of the subject area.
Gathering Data
After the experiment is completed, results are compiled and interpreted. This
involves the measurement of the dependent variable. In the case of our HPV
experiment, remember, the dependent variable is the rate of HPV infection.
Significance
Although the HPV study suggests that the vaccine protects against infection by HPV, is the
finding significant? In science, as in life, things can happen for many
different reasons. A convincing study will rule out “luck” (random chance) as an
explanation for the results. Strong results are said to be significant: very
unlikely to occur by chance or random events.
Whether the outcome is significant often depends on the size of study; the larger the number
of individuals enrolled, the more convincing the results are likely to be. For
example, imagine only 10 women were enrolled in the study. In the control group,
2 in 5 of the women became infected. In the experimental group, 0 in 5 were
infected. At first you might think this proves the vaccine’s effectiveness, but
it is NOT a convincing or significant result. Why not? Random events could
easily explain the difference between the groups. For example, perhaps none of
the five women in the experimental group were sexually active over the study
period. They therefore stood no chance of acquiring HPV. The vaccine might
appear to work, but a skeptical reader could account for the results by
proposing many other scenarios.
However, imagine if the same study were done with 10,000 women, and the infection rates were
2,000 of 5,000 in the control group and zero of 5,000 in the experimental group.
Random events would be spread out among a very large group of people in this
study; on average, the two big groups should have similar sexual behavior and
other factors influencing infection rates. If there is a big difference at the
end of the study, it is very unlikely that this result
occurred by random chance.
Statistical analyses did support the significance of the HPV vaccine result.
After the results are interpreted and conclusions are drawn, researchers often
return to their work and begin asking further questions. In this way, scientific
inquiry is a powerful tool for exploration.
Now that you have a pretty good idea about the process of science, you’ll have a
chance to identify examples of science and compare those to examples of
pseudoscience.
Pseudoscience is any claim that purports or pretends to be scientific in nature,
but does not actually have the characteristics of true scientific inquiry.
Pseudoscientific ideas often involve the supernatural. Sometimes they involve
claims about forces or processes that cannot be measured using traditional tools
or instruments employed by scientists. Finally, pseudoscientific claims are
often quite dramatic. They are “amazing” ideas that would seem strange or
unlikely to most scientists working in a related field.
The clearest line separating pseudoscience from “real” science is publication in
peer-reviewed scientific journals. These are publications, usually run by
scientific societies or academic publishing companies, in which scientists
publish their findings according to a well-established system of oversight.
Before it gets published in such a journal, a piece of research is carefully
reviewed by two or more researchers in the same field of study. The methods and
logic of the paper are evaluated carefully, and if it makes bold or unusual
claims, the study is subject to especially close scrutiny. Reviewers and editors
may demand not just rewrites, but also additional evidence if a claim is weakly
supported.
Truly scientific research is published in reputable peer-reviewed journals. These
journals exclude pseudoscience rigorously. If you hear that some idea is
“scientifically proven,” check the source to see if there’s any reference to a
scientific journal. Track down the article to see if it really supports the
claim. Finally, double check to make sure that the publication is a respected
peer-reviewed journal. One way to get this information is to ask a scientist at
a research university, consult with a librarian, or do a careful Internet
search. Your ability to distinguish between science and pseudoscience will help
you be a scientifically literate citizen.
Matter is anything that has mass and takes up space. The chair you are sitting in is made of
atoms. The food you ate for lunch was built from atoms. Even the air you breathe is made
of atoms. In this unit, we will learn more about atoms, the fundamental unit of matter.
 All matter is made of atoms. There are 92 different kinds of atoms that can be
put together in unique ways, resulting in all the diverse things you see around you.
All matter is made of atoms. There are 92 different kinds of atoms that can be
put together in unique ways, resulting in all the diverse things you see around you.
The cell is the fundamental unit of life;
therefore, you might think that your study of biology should begin with the cell. In
fact, before you can truly understand how a cell functions, you must understand the
building blocks from which cells are made. In the Introduction to
Biology module, you learned that all life exhibits a hierarchical organization.
While cells are the first level of organization that displays all the properties of
life, their component parts (atoms and molecules) are not alive, as illustrated in the
inverted pyramid below.

To make sense of how cells work, you must constantly return to their parts (atoms and
molecules) and the interactions among them. This is why a clear understanding of some
chemistry is essential to understanding how life functions. This unit will focus on the
atom. You will learn how atoms combine to form different molecules, making up all the
diverse matter you see around you. In this unit, you will explore only nonliving
components of the hierarchy of life.
In this module, you will learn about the basic structure of the atom, the fundamental unit of
matter. Living things
are made up of atoms arranged in a complex and nonrandom way. This is one of the common
features of all living organisms. The atom is the smallest level in the hierarchy of life that we will
explore in this course. Understanding the properties of atoms allows us to predict and
understand how atoms interact with one another to build molecules, such as hormones and
DNA. In addition, an understanding of atoms allows us to predict how cells will react to
different therapeutic drugs and toxins in the environment.
The Atom
All living and nonliving things are composed of matter. Matter can be defined as anything that
occupies space and has mass. The mass of an object is a measure of how much
matter it has (that is, how much “stuff” is in it). Mass is not exactly the same
as weight, but here on Earth we can measure and compare the masses of different
objects by weighing them.
When we explore matter scientifically, we find that it takes on many different
structures as we zoom in at smaller and smaller scales. Everyday objects are
mostly mixtures of molecules, which in turn are made up of atoms. Even air is a
mixture of molecules. The atom is a good focal point for understanding matter;
all matter is composed of atoms.
Atoms are unimaginably small. Even within a single microscopic cell, there is
room for not just billions, but trillions or even hundreds of trillions of
atoms. Amazingly, however, physicists now understand that most of the volume of
an atom is actually made up of empty space. The atoms themselves are made of
even smaller subatomic particles called protons, neutrons, and
electrons. We cannot look at the parts of atoms with a microscope;
they are simply too small. However, physicists have learned a great deal about
atoms and subatomic particles through indirect methods. One model of the atom is
shown in the diagram below.
Diagram of an Atom
 Atoms contain protons and neutrons, which are found in the nucleus (center) of the
atom. Atoms also contain electrons, which are found outside the nucleus.
This is a model of a lithium atom.
Atoms contain protons and neutrons, which are found in the nucleus (center) of the
atom. Atoms also contain electrons, which are found outside the nucleus.
This is a model of a lithium atom.
Elements
There are 92 different kinds of atoms that are naturally occurring on Earth. These different
types of atoms are called elements. Each element has its
own set of properties that are unique to atoms of its kind. Atoms differ from
one another in their number of protons, electrons, and
neutrons. Atoms are the smallest unit of an element that retains
all of the properties of that element. So, an element is a substance that is
composed of a single type of atom. For example, a hydrogen atom contains one
proton and one electron. In contrast, a carbon atom contains six protons, six
electrons, and six neutrons. Elements are designated by either one- or
two-letter abbreviations and they can be organized into a chart called the
periodic table. We will take a closer look at the periodic table (also called
the periodic chart) later in this unit.
In biological systems, the major elements are carbon (C), hydrogen (H), nitrogen (N),
oxygen (O), phosphorus (P), and sulfur (S). These elements represent
more than 95% of the mass of a cell. Carbon is a major component of nearly all
biological molecules. Some elements are found in relatively small amounts and
are called “trace elements.” Examples include sodium (Na), potassium (K),
chlorine (Cl), manganese (Mn), and Zinc (Zn). Throughout the course you will see
how atoms of these elements are very important to the functioning of a cell.
Elements (atoms) are characterized by their atomic structure, which is made up of subatomic
particles: protons, neutrons, and electrons. Protons and neutrons reside in the nucleus
(center) of the atom and have a mass of one atomic mass unit (amu) each. Electrons are
found outside of the nucleus, in zones that are called “shells.” Electrons have almost
no mass.
Diagram of atom
 Atoms contain protons and neutrons, which are found in the nucleus (center) of the atom.
Atoms also contain electrons, which are found outside the nucleus. This is a model
of a lithium atom.
Atoms contain protons and neutrons, which are found in the nucleus (center) of the atom.
Atoms also contain electrons, which are found outside the nucleus. This is a model
of a lithium atom.
The mass of an atom is called the atomic mass. When
calculating atomic mass, we pay attention only to the protons and neutrons; the
electrons have almost no mass. The atomic mass is the sum of the number of protons
and the number of neutrons. By summing the atomic mass of all the atoms in a molecule,
one can estimate the molecular mass of the molecule, which is expressed in atomic mass
units (called Daltons). Each of the heavy particles (neutron,
proton) weighs one atomic mass unit, so a Helium (He) atom, which has two protons, two
neutrons, and two electrons, weighs about four atomic mass units; that is, two protons
plus two neutrons.
| Particle |
Charge |
Location in Atom |
Relative Mass |
| proton |
positive |
nucleus |
1.0 |
| neutron |
no charge |
nucleus |
1.0 |
| electron |
negative |
orbit outside nucleus |
negligible |
In addition to location and mass, each subatomic particle has a property called “charge.”
Charge can be “positive” or “negative.” Items with the same charge tend to repel each
other and items with opposite charges tend to attract each other. Protons have a
positive charge and neutrons have no charge, giving the nucleus a positive overall
charge. Each electron has a negative charge that is equal in strength to the positive
charge of a proton. Electrons and the protons of the nucleus attract each other, and
this is the force that keeps the atom together, much like the force of gravity keeps the
moon in orbit around Earth.
Atomic Number
Atoms of different elements have many different features, including different
sizes and levels of reactivity. For example, sodium is an incredibly reactive
element, especially when it combines with water. Lead, on the other hand, is
relatively inert. Yet all elements share some regular patterns that make it
easier for us to categorize them and understand why they behave as they do.
The first key characteristic that truly identifies an element is its atomic number,
which is the number of protons in each atom. The atomic number is constant and
identical for all atoms of an element. For example, hydrogen (H) atoms always
have only one proton and have an atomic number of one. If an atom has two
protons, it has an atomic number of two, and it is helium (He). For this reason,
if you started with one hydrogen atom and added a proton, the original hydrogen
would now be helium. If an atom has three protons in its nucleus, it is a
lithium (Li) atom. Beryllium (Be) has four protons in its nucleus, and so on.
Based on their atomic numbers, elements can be organized into a periodic table
of elements like the one pictured below. The number at the top of each box in
the table is the atomic number of the element.
Periodic Table of Elements
 The periodic table organizes elements based on atomic number, which is
the number at the top of each square. Each element has a chemical symbol,
which is an abbreviation, shown in the center of each square.
The periodic table organizes elements based on atomic number, which is
the number at the top of each square. Each element has a chemical symbol,
which is an abbreviation, shown in the center of each square.
Atomic Mass
In addition to providing information about each element’s atomic number, most
periodic tables also provide an atomic mass for each element. The atomic mass, also
known as the atomic weight, reports the mass of the nucleus. The mass of the
nucleus is the sum of all protons and neutrons found in the nucleus. A hydrogen
atom has one proton and would therefore have an atomic mass of one. A carbon
atom, which has six protons and six neutrons, would have an atomic mass of 12.
The units of atomic mass are Daltons, abbreviated Da,
named after the British scientist John Dalton. One Da is equal to 1.66 x
10-27 kg, which is the mass of a single hydrogen (H) atom. Helium
(He) has a mass of 4 Da or 6.67 x 10-27 kg. Because the mass of a
single atom is so small, it is not a convenient unit for everyday use.
Typically, the atomic mass is multiplied by the number of atoms in a mole to
give the atomic weight in grams. A mole contains 6.022 x 1023
particles and is defined as the number of particles of carbon (C) that give an
atomic weight of 12 grams.
Periodic Table of Elements
 The atomic masses or atomic weights can also be added to the periodic
table of elements. The atomic mass of an element is written below the
chemical symbol.
The atomic masses or atomic weights can also be added to the periodic
table of elements. The atomic mass of an element is written below the
chemical symbol.
Isotopes
Notice that the atomic
mass or atomic weight on the periodic table is not generally a whole
number. For example, the atomic mass of carbon (C) is 12.01. How is that
possible? Atoms cannot have fractions of protons or neutrons. The reason for
this is that not all atoms of an element have the same number of neutrons. For
example, carbon atoms always have six protons. But some carbon atoms have six
neutrons, while others have seven or even eight neutrons. A carbon atom that has
six neutrons would have an atomic mass of 12; a carbon atom with eight neutrons
would have an atomic mass of 14. Two atoms with the same atomic number
but a different atomic mass are called isotopes. For example, most atoms of carbon
have an atomic mass of 12. There are some atoms of carbon with an atomic mass of
13 (carbon 13), and some with 14 (carbon 14). These are isotopes of the carbon
atom. Carbon 12 is the most abundant or prevalent isotopic form of carbon.
Because carbon 12 is the most abundant form and taking into account all of
carbon's different isotopes, the average value for the atomic mass for carbon is
near 12: it's listed at 12.01.
Scientists have learned that isotopes have many useful properties. Some isotopes
can be used to trace chemical reactions. If a special isotope is placed in
fertilizer, for instance, that same isotope will later show up in the tissues of
plants, then animals and decomposers as the nutrient moves through the food web.
Some isotopes break down into others at a constant rate, allowing us to
determine the age of fossils or artifacts. When an isotope is radioactive, this
means that it emits some energy (radiation) when it breaks down to a different
isotope. Radioactive isotopes can be used to visualize certain tissues for
medical diagnosis. For example, radioactive iodine tends to concentrate in the
thyroid gland. It emits radiation as it breaks down to another isotope of
iodine. Special cameras can pick up this radiation and use it to create an image
of the thyroid gland. This can help determine if the patient’s thyroid is
normally active or to detect thyroid cancer.
Electrons
The electron is the reactive part of the atom. The number and location of
electrons determines the interactions between atoms. As you recall, negatively
charged electrons are pulled toward the positively charged nucleus. But
electrons are kept in orbit by kinetic energy. Electrons that are close to the
nucleus are less energetic than those electrons farther from the nucleus.
Electrons reside in the space outside the nucleus in regions called shells. There are
specific rules for filling up the shells of the atom. The first shell can hold
two electrons; the second and third shells can hold up to eight electrons.
Electrons fill up lower shells before moving to the next higher shell. The electrons that
occupy the outermost shell are called valence electrons and are the
electrons that are involved in chemical bonding. The chemical properties of an
element depend mostly on the number of valence electrons.
The valence (outermost) electron shells are shown. Click on the button to show or hide
the inner orbital shells.
A key characteristic of atoms is that they are most stable when they have full
outer electron shells. Helium (He) has a full outer shell with two electrons;
directly below it in the periodic table is Neon. Neon (Ne) has an inner shell with
two electrons and a full second shell with eight electrons. In fact, all of the
elements in that column of the periodic table have full outer shells, are
stable, and do not react with other elements.
Ions
Opposite charges cancel each other out when they are close together. So what would you
predict about the overall charge of an atom with an equal number of protons and
electrons? That’s right — it is neutral. There is no charge; the atom will not
be attracted to or repelled by charged objects. All atoms, in their elemental
state, have equal numbers of protons and electrons, and for this reason they
have no net charge.
As you recall, an atom is most stable when it has a full outer shell. Some atoms achieve this
endpoint by taking on extra electrons, or giving them up. When this happens, the
atom becomes an ion and it takes on an
overall charge.
Some elements readily take on one or more extra electrons. They become anions
that carry a negative charge, because they have more electrons than protons. On
the periodic table, elements to the right (with the exception of the last
column) are likely to take on extra electrons. For example, chlorine (Cl) has
seven electrons in its valence shell. It is likely to take on one extra electron
to fill its outer shell, becoming an anion with a charge of -1. The same can be
said for other elements in the same column with chlorine. Conversely, elements
on the left side of the periodic table tend to give up one or more electrons and
become cations with a positive net charge. For example, sodium (Na)
has one electron in its valence shell. It readily gives up this electron,
becoming a cation with a charge of +1. The same can be said for lithium (Li) and
other elements in this column.
In the next section, we will explore how these electron transfers occur, and will look at
some of the other ways that atoms interact to achieve stable, full outer
electron shells.
Scientists have learned to use isotopes in many different ways. For example, stable isotopes
can be used to trace chemical reactions through a food web. For example, if a stable
isotope is used in fertilizer, that same isotope will later show up in the tissues of
plants, then in animals, and finally in decomposers as the nutrient moves through the
food web. Other isotopes are unstable and they tend to decay (or break down into other
isotopes) at a constant rate. Scientists have learned how to use unstable isotopes to
determine the age of fossils or artifacts. Finally, some isotopes are radioactive.
Radioactive isotopes emit energy in the form of radiation when they decay into different
isotopes.
Radioactive isotopes can be used to visualize certain tissues for medical diagnosis. One
example of this is radioactive iodine, which tends to concentrate in the thyroid gland.
It emits radiation as it breaks down to another isotope of iodine. Special cameras can
pick up this radiation and use it to create an image of the thyroid gland to determine
if the patient's thyroid is functioning normally. If there is abnormal activity in the
thyroid gland, this can indicate cancer.
Another example of radioactive isotopes is positron-emission tomography (PET). In PET, a
patient ingests sugar that is marked with a radioactive isotope. Cells that are using a
lot of sugar (or need a lot of energy) will absorb more of the radioactive isotope. The
patient is then moved into a PET scanner, where the radioactive isotopes are visualized
and the machine translates the data into an image. This can help in a variety of
applications, from cancer and Alzheimer’s disease diagnosis to addiction research (see
image).
Positron-Emission Tomography (PET)Images
 PET brain scans show chemical differences in the brain between addicts and nonaddicts.
The normal images in the bottom row come from nonaddicts; the abnormal images in the
top row come from patients with addiction disorders. These PET brain scans show that
addicts have fewer than average dopamine receptors in their brains, so that weaker
dopamine signals are sent between cells. Source: Nora Volkow, March 2001,
Wikipedia.
PET brain scans show chemical differences in the brain between addicts and nonaddicts.
The normal images in the bottom row come from nonaddicts; the abnormal images in the
top row come from patients with addiction disorders. These PET brain scans show that
addicts have fewer than average dopamine receptors in their brains, so that weaker
dopamine signals are sent between cells. Source: Nora Volkow, March 2001,
Wikipedia.
Atoms are the smallest units of an element that retain all the properties of the element. Atoms combine to form a larger and
more complex entity called a molecule. Molecules are composed of two or more atoms held
together by covalent bonds.
Chemical bonds are attractions between atoms that hold atoms and molecules together. There are
three types of chemical bonds that are important in biology: covalent bonds, ionic
bonds, and hydrogen bonds. Covalent bonds are very stable, while ionic and hydrogen bonds are less
stable. The relatively weaker ionic bonds and hydrogen bonds allow reversible interactions between different molecules in
biological systems.
Joining atoms together builds molecules that are more complex and larger than the individual
atoms that compose them. The table below illustrates some similarities and differences
among ionic, covalent and hydrogen bonds.
| Covalent bond |
Ionic bond |
Hydrogen bond |
| strongest |
moderate strength |
weak |
| between atoms |
between ions |
between different molecules or parts of molecules |
| sharing of electron pair, creating a strong bond between atoms |
moderately strong electrostatic attraction between oppositely charged ions |
weak electrostatic attraction between areas of molecules with opposite partial
charges |
The most stable situation for an atom is to have its outer shell completely filled with
electrons. It is not easy to explain why this is true, but it is a rule of thumb that
predicts how atoms will react with each other. Recall from the discussion on electrons, in the
Atoms module,
that the first electron shell is full with two electrons, and the second and third
shells are full with eight electrons. Atoms tend to bond to other atoms in such a way
that both atoms have filled outer shells as a result of the interaction.
Ionic bonds are the interactions between ions of opposite charges. Atoms form ions
when they either take up or release electrons in order to fill their outer shell.
Elements in the outer columns of the periodic table often react in this manner; elements
like sodium tend to lose electrons and become cations (positively charged ions), whereas
elements like chlorine tend to gain electrons and become anions (negatively charged
ions).
In fact, the reaction between sodium and chlorine is a great example of ionic bonding, and
produces a compound you have in your kitchen — table salt. Chlorine (Cl) has an atomic
number of 17, so it has 7 electrons in its outermost shell. Chlorine needs one more
electron to have a full outer shell.
Sodium (Na) has an atomic number of 11, with one electron in its outermost shell. Sodium needs
to get rid of an electron, and then it will have a full outer shell.
By losing an electron, sodium becomes a cation with a positive charge (+1). By gaining an
electron, chlorine becomes an anion with a negative charge (-1). Now each ion has a net
charge and the two charges are opposite. The ions attract one another. The electrostatic
interaction between the sodium ion and the chlorine ion is an ionic bond .
Instead of transferring their electrons completely, atoms may remain in very close
contact and share electrons so that their outer shells are filled. In essence, a shared
electron is counted “twice” and participates in a larger shell that joins the two atoms.
A single pair of shared electrons makes a single covalent bond. Atoms can share two
pairs of electrons (in a double bond), or even three pairs of electrons (in a triple
bond).
This sharing of electrons is called a covalent
bond.
Carbon, for example, has an atomic number of 6 (see the figure below). The outer shell of
carbon has 4 electrons. Carbon can share an electron with four other atoms. Hydrogen has
an atomic number of 1. It has a single electron in its outermost shell, and can share
this electron with one other atom. A carbon atom can form a covalent bond with four
hydrogen atoms to form a molecule called methane, CH4 . In a
methane molecule, carbon effectively has a “full” second shell (8 electrons) and each
hydrogen has a “full” second shell (two electrons).
 Example 1: Carbon and hydrogen react to form methane (CH4). Each
hydrogen requires one covalent bond to fill its first electron shell. Each carbon
requires four bonds to fill its second shell. Exaample 2: Nitrogen and
hydrogen form ammonium (NH3). The three unpaired electrons on the
nitrogen atom (N) in ammonia, represented as single dots, form bonds with three
hydrogen atoms.
Example 1: Carbon and hydrogen react to form methane (CH4). Each
hydrogen requires one covalent bond to fill its first electron shell. Each carbon
requires four bonds to fill its second shell. Exaample 2: Nitrogen and
hydrogen form ammonium (NH3). The three unpaired electrons on the
nitrogen atom (N) in ammonia, represented as single dots, form bonds with three
hydrogen atoms.
Nitrogen, another example, has an atomic number of 7 (see the figure above). The outer
shell of carbon has 5 electrons. Nitrogen can share an electron with three other atoms.
Hydrogen has an atomic number of 1. It has a single electron in its outermost shell, and
can share this electron with one other atom. A nitrogen atom can form a covalent bond
with three hydrogen atoms to form a molecule called ammonia, NH3 . In an
ammonia molecule, nitrogen effectively has a “full” second shell (8 electrons) and each
hydrogen has a “full” second shell (two electrons).
Molecular Formulas
When two atoms are joined by a covalent bond, the new structure that forms is
called a molecule. This is in contrast to the structure formed when two atoms
are joined by an ionic bond, which is called an ionic compound. When drawing a
molecule on paper, covalent bonds are often drawn as lines between atoms. A
single covalent bond is drawn as one line; a double covalent bond is drawn as 2
lines. Each atom is represented by its element symbol. Thus a structural formula
of methane (CH4) would be drawn like this:
Notice that the carbon in methane has formed four covalent bonds with four
hydrogen atoms. Because carbon has four electrons in its outer shell, it can
always form four covalent bonds with other elements.
The molecular mass or weight of a molecule is the sum of the individual atomic weights. As
with atomic weights, it is convenient to use the weight of a mole of molecules.
For example, the molecular mass of a single methane molecule is 16 Da (12 from
the carbon, 4 from the hydrogens). The weight of a mole of methane molecules is
16 grams.
Drawing Molecules
|
Structural Formulas: There are many different ways to draw
molecules. For example,
look at the glucose molecule shown on the right in a structural formula.
Notice that the structure consists of a carbon backbone running down the
middle of the molecule. Each carbon has formed a
covalent bond with four
other atoms. (The first carbon actually formed two bonds with the oxygen
atom; this is called a double bond. This carbon still formed a total of
four bonds, even though two of the bonds are with the same oxygen atom.)
Skeletal Formulas: Chains of carbon atoms are very common in carbon-based
molecules. Sometimes such molecules are drawn using skeletal formulas,
also known as shorthand formulas. In these
diagrams, the carbon atom, typically indicated with the letter “C,” is
not shown. Instead, each C atom is drawn simply as a corner on the
diagram.
|
|
Below are skeletal diagrams of glucose. In these examples, the carbons are located at each
angle in the diagram.
Glucose Molecule: Linear Skeletal Diagram
 Carbon atoms are indicated at each corner or angle, as highlighted in Figure 1B with
red circles.
Carbon atoms are indicated at each corner or angle, as highlighted in Figure 1B with
red circles.
Glucose Molecule: Ring Structure Diagram
 The six carbons of glucose are numbered in the ring structure and
highlighted in Figure 2B with red circles.
The six carbons of glucose are numbered in the ring structure and
highlighted in Figure 2B with red circles.
You may have another question about the skeletal diagrams: what happened to the hydrogen
atoms attached to the carbon atoms? It looks like some of the carbons only have
two or three covalent bonds!
The skeletal diagrams are often drawn to be simple,
not to show every atom. It is understood that carbon must have four bonds, and
in any carbon-based molecule there are often one, two, or even three hydrogen
atoms bonded to each carbon. To clean up the diagram, the H atoms are not drawn.
It is assumed you will understand that any “missing” bond is actually provided
by a hydrogen atom.
These conventions simplify diagrams of molecular structures. The cholesterol molecule, shown
below, looks much cleaner than if we had to draw each carbon and hydrogen atom.
You may also notice that this image has different-looking bonds. These solid and
striped triangle-shaped bonds describe the three-dimensional shape of the
molecule.
Recall that in a covalent bond, the electrons are shared between two atoms. However, the two
atoms don’t necessarily share the electrons equally. Some atoms are more likely to draw
the shared electrons closer to themselves. Atoms have a high electronegativity if they
tend to draw the electrons towards them. Electronegativity increases as one moves from the
left to the right across the periodic table. Hydrogen is moderately electronegative,
with a value of 2.1, carbon is somewhat more electronegative, with a value of 2.5, and
fluorine is the most electronegative atom, with a value of 4.0.
Electronegativities of Biologically Important Atoms
 Image modified from Chart of Each Element's
Electronegativity, UC Davis ChemWiki by University of California.
Image modified from Chart of Each Element's
Electronegativity, UC Davis ChemWiki by University of California.
The degree of unequal electron sharing depends on the difference in electronegativity of the
atoms involved in the bond. For example, in carbon-carbon bonds, both atoms have the
same electronegativity, so the electrons are equally shared between the two carbons. In
contrast, a carbon-oxygen bond involves two atoms that have different
electronegativities. The less electronegative atom (carbon) will donate part of its
electrons to the more electronegative atom (oxygen), resulting in a partial positive
charge on the carbon (indicated by δ+) and a partial negative charge
on the oxygen (indicated by δ-). The size of the partial charges is
proportional to the difference between the electronegativities of the two bonded atoms.
Bonds in which electrons are unequally shared between the atoms are called polar covalent
bonds.
Throughout this course, you will be studying many different molecules. Many of the
important molecules of life, like DNA, proteins, and even ordinary water, share a key
characteristic: they all form hydrogen bonds.
Hydrogen bonds are not like the covalent bonds you just learned about. They do not join atoms
into molecules. Instead, they are the attraction of an electronegative atom to a
hydrogen that is covalently bonded to another electronegative atom. This involves the
attraction of the hydrogen with a partial positive charge to the electronegative atom
with a partial negative charge. Only hydrogen covalently bonded to an electronegative
atom can participate in hydrogen bonding.
Hydrogen bonding has a significant effect on the properties of molecules. For example,
the structure of the DNA molecule is in part held together by hydrogen bonds. Hydrogen
bonds also create coils and other structures within the complex protein molecules that
are essential to life’s diversity. Finally, water behaves the way it does because of the
hydrogen bonds that attract water molecules to each other.
Water
The water molecule is a very important example of a molecule that can form hydrogen bonds.
It is the hydrogen bonding of the water molecules that gives water many of its
unique and life-sustaining properties. One water molecule consists of two
hydrogen atoms
covalently bonded to a oxygen atom.
Recall that in a covalent bond, the electrons are shared between two atoms.
However, the two atoms don’t necessarily share the electrons equally. Some atoms
are more likely to draw the shared electrons closer to themselves. These atoms
have a high
electronegativity. Both oxygen and nitrogen are molecules with a high
electronegativity.
In a water molecule, oxygen is more electronegative than hydrogen. This means that oxygen has
a greater affinity or attraction for the shared electron pair than hydrogen
does. Because of this, the electrons tend to spend more time close to the oxygen
atom and they spend less time close to the hydrogen atom. As a result, the
oxygen becomes slightly negative and each hydrogen atom develops a slightly
positive charge. Whenever two atoms with different electronegativities form a
covalent bond, we say that the bond between the atoms is
polar, with each atom carrying a partial charge.
Oxygen and nitrogen are the two highly electronegative elements that are often
bonded to hydrogen in biological molecules. O-H and N-H bonds are strongly
polar, and this sets the stage for hydrogen bonding.
 δ- and δ+ represent a partial negative and partial
positive charge, respectively.
δ- and δ+ represent a partial negative and partial
positive charge, respectively.
Hydrogen bonding is the attraction of an electronegative atom for a hydrogen that is
covalently bonded to another electronegative atom. This involves the attraction
of a hydrogen with a partial positive charge to an atom with a partial negative
charge. However, only hydrogen covalently bonded to an electronegative atom can
participate in hydrogen bonding.
In water, the partially positive hydrogen atoms are attracted to the partially
negative oxygen atoms of neighboring water molecules. Hydrogen bonds are
responsible for many of the unique properties of water. We’ll explore this in
more detail in the next module. Watch the following animation that illustrates
hydrogen bonding.
Adjust the volume on your computer and click the play button.
Biologists have different ways of representing chemical structures. Each type conveys
different information.
Have you ever wondered why scientists spend time looking for water on other planets? It is
because, at least here on Earth, water is essential to life. Evidence of water on Mars,
and some of the moons of Saturn and Jupiter, increases the odds that life may exist
there. Here on Earth, water is one of the most abundant molecules. The water content of
our bodies and our cells ranges from 70 to 95 percent. All of life’s chemical reactions
take place in watery fluid. Without water, life as we know it simply would not
exist.
There are four properties of water that make it such a unique and important molecule:
- Water is an excellent solvent and can dissolve a wide range of substances.
- Water is cohesive.
- Water’s temperature tends to remain stable.
- Solid water (ice) is less dense than liquid water.
These properties of water are due to the hydrogen bonds formed between water molecules.
Hydrogen bonds are discussed in the Chemical Bonds
module.
Solutions are homogeneous mixtures. This means that you can sample
any part of the solution and the composition of the solution will be the same.
Solutions have two components:
-
solvent: the component of the solution in the greatest
quantity.
-
solutes: the component(s) present in lower quantities.
If you add some salt to water, you are making a solution. Water is the solvent and the salt is the
solute. Solutions can
have more than one solute. If you add sugar to your salt solution, both sugar and salt
would be the solutes of the solution. Solutions in which water is the solvent are called
aqueous solutions. The inside of our cells and
our body fluids are examples of aqueous solutions. When a solute is added to a solvent
and a solution is formed; the
solute is described as “dissolving” in the solvent.
Substances that will dissolve in water are hydrophilic or water-loving. What kinds of molecules are hydrophilic?
Ionic substances like table salt (NaCl) are hydrophilic. They
split into positive and negative ions and dissolve in water. Polar water molecules
surround the charged particles, breaking them away and pulling them into the fluid.
Polar molecules also are hydrophilic. Polar water molecules readily
surround and dissolve polar molecules or molecules with polar functional groups.
Examples include sugars and alcohols, which have hydroxyl groups. Molecules that do not
dissolve in water are
hydrophobic (from the Greek word meaning water-fearing or water-hating). Nonpolar molecules are
hydrophobic. Examples include hydrocarbons and fatty acids with their abundant nonpolar
C-H bonds. Have you ever tried to mix water and oil? Oils and fats are nonpolar and will
not form a solution with water.
Oil Spill in San Francisco Bay
 About 58,000 gallons of oil spilled from a South Korea-bound container ship
when it struck a tower supporting the San Francisco-Oakland Bay Bridge in dense fog
on 11/07/07. Brocken Inaglory, Nov, 2007; Wikimedia Commons.
About 58,000 gallons of oil spilled from a South Korea-bound container ship
when it struck a tower supporting the San Francisco-Oakland Bay Bridge in dense fog
on 11/07/07. Brocken Inaglory, Nov, 2007; Wikimedia Commons.
Next we will examine hydrophobic molecules more closely. Substances with
hydrophobic molecules will not dissolve in water and instead will tend to separate from
water.
Some molecules are hydrophobic, which literally means fear (phobia) of water (hydro). These molecules do not like
to dissolve in water. When hydrophobic molecules are mixed with
water, they will tend to separate into distinct phases (or layers), one containing water
and the other containing the hydrophobic molecules. This makes it very difficult, for
example, to “wash” oil off of waterfowl after an oil spill.
 Birds killed as a result of oil from the Exxon Valdez spill. Photo in the
public domain courtesy of the Exxon
Valdez Oil Spill Trustee Council.
Birds killed as a result of oil from the Exxon Valdez spill. Photo in the
public domain courtesy of the Exxon
Valdez Oil Spill Trustee Council.
Things composed of hydrophobic molecules generally include oils, fats, and greasy
substances. Materials containing hydrophobic substances are often used for removal of
oil from water and management of oil spills. Other molecules are
hydrophilic, which means love (philic) of water, and readily dissolve in water.
Chemical Structures
Now that you know some common hydrophobic and hydrophilic molecules, let’s look
at their structures to understand why they interact with water in different
ways.
The additional atoms that are found only on glucose are
electronegative, meaning that they will withdraw
some of the electrons from the atoms that form bonds with them. The
electronegative atom will have a slight negative charge, and the atom that it is
bonded to it will have a slight positive charge.
The unequal distribution of electrons makes the bond a polar
bond.
 Water is a polar molecule. The electronegative
oxygen draws the electron from hydrogen toward it, causing the hydrogens to
have slight positive charge and the oxygen to have a slight negative
charge.
Water is a polar molecule. The electronegative
oxygen draws the electron from hydrogen toward it, causing the hydrogens to
have slight positive charge and the oxygen to have a slight negative
charge.
The interaction between a polar bond on water and polar bonds on hydrophilic
molecules is given a special name — the hydrogen bond, because it involves a
hydrogen that forms a bridge between the two molecules. Hydrogen bonds are
fairly stable, so quite a bit of energy is released when they are formed. The
release of energy helps hydrophilic molecules like glucose dissolve in water.
Since hydrophilic molecules contain polar bonds, they are often referred to as
polar molecules.
Nonpolar Molecules
Hydrophobic molecules lack the electronegative atoms that
are required to generate a polar bond. Thus, hydrophobic molecules are also
referred to as nonpolar.
The fact that nonpolar molecules cannot form hydrogen bonds in one reason why
they have low solubility in water; however, there is another far more important
force that drives nonpolar molecules from water, called the hydrophobic
effect.
Hydrophobic Effect
When a non-polar molecule dissolves in water it becomes completely surrounded by
water molecules. The water molecules cannot form hydrogen bond with the
non-polar molecule, however they do form hydrogen bonds with the other water
molecules that surround the non-polar molecule, forming a layer of hydrogen
bonded water molecules that cover, or form a cage, around the dissolved
non-polar molecule. A representation of these water molecules organized around
dissolved butane is shown in the following Jmol:
The dissolved butane is highlighted in yellow. It is surrounded by a cage of
water molecules, forming hydrogen bonds (purple) with each other. Place your
cursor over the structure left-click, hold, and move your pointer to
rotate the structure. Right-click to display a pop-up menu and select
zoom-in or zoom-out to examine the chemical bonds. (Source: pdb file modified from Udachin et al., J. Chem. Phys, 134,
121104 (2011).
The formation of the water cage is unfavorable, because it requires water
molecules to become ordered. Ordering anything requires energy, whether it is a
cage of water molecules surrounding a nonpolar molecule, or your messy dorm
room. The energy cost of ordering water molecules around nonpolar compounds is
so high that they are forced out of the water, leading to a separation of
phases; oil and water don’t mix because of the hydrophobic effect. Most
biological molecules contain both polar and nonpolar regions. Their behavior in
water depends on the relative number and type of polar groups versus nonpolar
groups. For example, consider this series of simple alcohols.
Amphipathic Molecules
Molecules that contain a very polar part and a very nonpolar part are called
amphipathic. The polar part interacts with water,
forming strong interactions, while the nonpolar part doesn’t interact with water
because of the hydrophobic effect. In order to accomplish this, amphipathic
molecules usually undergo spontaneous self-assembly into structures that expose
the polar part to water and keep the nonpolar section away from water. One
example of amphipathic molecules are fatty acids.
Fatty Acids Molecule

The carboxylate group (COOH) on the left interacts strongly with water, while the
remaining part of the molecule is very hydrophobic and is forced away from
water. Fatty acids form structures in solution called
micelles. These spherical structures have the
hydrophilic part exposed to water on the surface
of the sphere and bury the hydrophobic part in the center
of the sphere.
 Schematic of a spherical micelle.
Schematic of a spherical micelle.
You might be wondering why triglycerides are not amphipathic, given that they are
similar to fatty acids, with a polar group of atoms and a nonpolar group. The
reason is that the polar region of triglycerides interacts weakly with water
because there is no free -OH group.
Have you ever filled up a glass of water to the very top and then slowly added a few more
drops? Before it overflows, the water forms a dome-like shape above the rim of the
glass. This water can stay above the edges of the glass because of the property of
cohesion. In cohesion, water molecules are attracted to each other
(because of hydrogen bonding), keeping the molecules together. Cohesion allows
surface tension, the capacity of a liquid’s surface to resist being
ruptured when placed under tension or stress. When water is sprinkled onto a solid
surface, surface tension causes the water to remain in compact droplets instead of
spreading out into a thin film.
 Water drops exhibit cohesion. The water molecules attract each other
strongly, and this force counteracts the force of gravity pulling water down
against the leaf.
Water drops exhibit cohesion. The water molecules attract each other
strongly, and this force counteracts the force of gravity pulling water down
against the leaf.
When you drop a small scrap of paper onto a droplet of water, the paper floats on top of the
water droplet, even though the object is denser (heavier) than the water. This occurs
because of the surface tension that is created by the water molecules. Cohesion and
surface tension keep the water molecules intact and the item floating on the top. Many
insects are specially adapted to exploit surface tension, which allows them to literally
“walk on water.”
Water Strider
 The surface tension of water helps insects, such as this water strider,
remain afloat.
The surface tension of water helps insects, such as this water strider,
remain afloat.
These cohesive forces are related to water’s property of adhesion, or the
attraction between water molecules and other molecules. This is observed when water
“climbs” up a straw placed in a glass of water. You will notice that the water appears
to be higher on the sides of the straw than in the middle. This is because the water
molecules are attracted to the straw and therefore adhere to it.
Capillary Action
 If a thin glass tube is placed in water, the water moves up the tube in
a process called capillary action. Capillary action is the result of
adhesion of water to the sides of a glass tube and cohesion of water
molecules to each other.
If a thin glass tube is placed in water, the water moves up the tube in
a process called capillary action. Capillary action is the result of
adhesion of water to the sides of a glass tube and cohesion of water
molecules to each other.
Cohesive and adhesive forces are important for sustaining life. For example,
because of these
forces, water can flow up tubes within plants. These tubes connect the roots of
plants to their leaves, and carry water to plant tissues. Adhesion helps water
cling to the walls of the tubes, and cohesion keeps the water in an intact
column. Without these properties of water, tall plants would be unable to
receive the water and nutrients they require, and they would die.
Imagine you have placed a metal pan containing water on the stove. You transfer heat energy
to the pan. If you touch the metal pan after a few minutes, it is warm or even hot to
the touch, but the water does not yet feel warm. The metal’s temperature changes much
more quickly than that of the water, even though both substances are receiving heat from
the same source. Temperature is a measure of the vibrational energy of molecules within
a substance; it reflects how fast the molecules are jiggling around. If you add heat to
metal, the molecules respond quickly with an increase in their “jiggling” and the
temperature increases rapidly. If you add the same amount of heat to water, the
molecules respond much less quickly. Why is water’s temperature so resistant to
change?
Hydrogen Bonds in Water
 Water has many hydrogen bonds; each molecule can form hydrogen bonds with up to four
other molecules. It takes a lot of energy to break all of these bonds.
Water has many hydrogen bonds; each molecule can form hydrogen bonds with up to four
other molecules. It takes a lot of energy to break all of these bonds.
When water is heated, a large part of the heat energy goes into breaking the
hydrogen bonds between the water molecules. Only a small part actually increases
the kinetic energy of the water molecules. Imagine a rack of billiard (pool)
balls. When the cue ball strikes them, energy is transferred and the balls
“break,” rolling in every direction. What would happen if the balls were
connected by rubber bands? They would not move nearly as much. Similarly, the
hydrogen bonds among water molecules make it hard to increase their “jiggling.”
As heat is added, hydrogen bonds are broken and water warms up, but due to the
hydrogen bonding, the water’s temperature changes only slowly. When water cools
down, it releases a great deal of heat as hydrogen bonds are re-established.
This effect is particularly strong when water freezes; water molecules are
joined in a regular crystal structure by stable hydrogen bonds. As these bonds
form, heat is released to the surrounding environment. You may have noticed that
snowy days are often not quite as cold as the dry clear days of winter. This is
yet another example of the way that water moderates temperature.
The Solid State of Water Is Less Dense Than Its Liquid State
When water freezes, the water molecules become arranged into a regular crystal. Each water
molecule is bound by four hydrogen bonds to its neighbors. In this arrangement,
the water molecules are further apart than they are in liquid water. Thus, the
density of ice is less than the density of liquid water. Ice, the solid state of
water, can float in the liquid state. This is important for lakes and ponds that
contain fish and plants. When the temperature goes below freezing, ice is
formed. The ice is less dense than the liquid, so it floats on the top of the
lake or pond. The surface ice insulates the pond, helping it to retain heat, and
keeps the pond from freezing solid.
Solid water is less dense than liquid water.
 Ice floats on top of a glass of water because ice is less dense than
water.
Ice floats on top of a glass of water because ice is less dense than
water.
Note...The three dimensional structure of ice is shown above. Place your cursor
over the structure, left-click, hold, and move your pointer to rotate the
molecule. Click on “Highlight Void” to show the empty volume generated due
to the hydrogen bonds in ice. Click on the "Spin on/off" checkbox to
automatically spin or stop spinning the molecule.
Solid water is less dense than liquid water because in ice, the regular pattern of hydrogen
bonds pushes the molecules further apart.
We use detergents to remove oily dirt from things. We use dish detergent to remove the
grease on dishes, laundry detergent for oils on our clothes, and shampoo for oils in our
hair. Detergents make the hydrophobic oils soluble so that the dirt can be rinsed away.
How does this happen?
All detergents are amphipathic molecules; they have a polar, water-loving (hydrophilic) part and a
nonpolar, water-hating (hydrophobic) part, which allows them to dissolve in both water and oils. The
chemical structure of a common detergent, sodium dodecyl sulfate (SDS), is shown below.
The hydrophilic part of DS interacts favorably with water by hydrogen bonding and
electrostatic (charge-charge) interactions between the negative charge on the DS and
the partial positive charges on the polar water molecules. The hydrophobic part has no
polar atoms to form favorable interactions with the water.
 The molecular structure of sodium dodecyl sulfate (SDS), a common
detergent.
The molecular structure of sodium dodecyl sulfate (SDS), a common
detergent.
When placed in water, detergents spontaneously form organized spherical structures called
micelles. In a micelle, the hydrophilic part of the detergent is on the
surface of the sphere and interacts with the water. The center of the sphere contains
the hydrophobic part of the detergent, hidden from the water. A cross section image and
a three-dimensional structure of a micelle are shown below. When a micelle comes in
contact with oily (hydrophobic) compounds, the oils dissolve into the interior of the
micelle and can be washed away with the micelle.
This course has looked closely at the water molecule because it is vital to life.
Water covers 70 percent of the Earth’s surface and the cell, the fundamental unit of life, consists
of 70 to 95 percent water. In this module, we will examine one very small (and
simple) substance that, when dissolved in water, can have an enormous impact on
life: the hydrogen ion (H+). Hydrogen ions are hydrogen atoms that
have had their electrons removed. What remains is only a single proton. The
simplicity of this ion, however, is quite misleading. In this module, we will
investigate the dynamics of H+ and learn more about the effects
H+ can have on solutions.
Acids and Bases
The story of acids and bases begins with water (H2O). Water in the
liquid state is highly dynamic. Not only are hydrogen bonds constantly forming
and breaking between water molecules, but individual water molecules are
breaking apart and then reforming again to make water. When they break apart, a
hydrogen ion (H+ ) is transferred to another water molecule to make a
hydronium ion (H3O+), leaving a hydroxide ion
(OH-) from the original water molecule. This dynamic reaction can
be represented by this chemical equation: H2O + H2O
[double arrow] H3O+ + OH-. To simply things we
will represent the hydronium ion as a hydrogen ion
(H3O+=H+) in the following discussion.
To simply things we will represent the hydronium ion as a hydrogen ion
(H3O+ = H+) in the following discussion.
Notice that the two arrows point in opposite directions. This simply means that
the equation can move in either direction. In other words, hydrogen ions and
hydroxide ions can combine to form water, or water can break down into hydrogen
ions and hydroxide ions. These two reactions are in equilibrium, so at any
instant in a sample of pure water there are equal concentrations of H+
and OH-.
Pure water is said to be “neutral.” This means it is neither acidic nor basic
because it has equal concentrations of H+ and OH-. Some
substances can dissolve in water and they will not disturb the balance between
H+ and OH-. However, other compounds disturb this
balance. Some compounds, when added to water, cause an increase of hydrogen ions
(H+) in the solution. These compounds are called acids. Other
compounds, when added to water, cause a decrease in hydrogen ions
(H+) in the solution. These compounds are called bases. Some bases
accept H+ directly, but others release hydroxide ions
(OH-) that then combine with H+ to produce water. The end
result is the same. When the base is dissolved in water, the concentration of
H+ ions goes down. A compound that does not result in a net gain
or loss of hydrogen ions (H+) when in aqueous solution is said to be
neutral; it does not alter the acidity of the water.
Acids and Bases in Solution
 This figure shows what acids and bases look like in aqueous solution.
Notice that the concentration of hydrogen ions is greater than the
concentration of hydroxide ions in an acid, the concentration of the
hydrogen ions equals that of the hydroxide ions in the neutral solution, and
the concentration of the hydrogen ions is less than the concentration of
hydroxide ions in the base.
This figure shows what acids and bases look like in aqueous solution.
Notice that the concentration of hydrogen ions is greater than the
concentration of hydroxide ions in an acid, the concentration of the
hydrogen ions equals that of the hydroxide ions in the neutral solution, and
the concentration of the hydrogen ions is less than the concentration of
hydroxide ions in the base.
This table compares and contrasts the features of acids and bases.
| Acids |
Bases |
| Readily give hydrogen ions (H+) when dissolved in
water |
Readily take hydrogen ions (H+) when dissolved in
water; may donate hydroxide ions (OH-) |
| Acidic foods often taste sour |
Basic foods often taste bitter |
| Many foods and beverages are acidic |
Bases often make your skin feel slimy or slippery because they release
soap-like molecules from your lipids. |
| Strong acids can cause burns and are caustic |
Strong bases can cause burns and are caustic |
| Acids commonly induce damage to living organisms by denaturing proteins:
changing their shape so they do not function normally |
Bases commonly induce damage to living organisms by breaking down fats
and denaturing proteins |
Understanding acids and bases is important to biology because living organisms
must maintain homeostasis (balance) and cannot tolerate drastic changes in the
acidity of their body fluids or cytoplasm. Cellular functions are disrupted if
these fluids become too acidic or basic.
The pH Scale
|
The acidity of a solution is measured on the pH scale. pH is a
measurement of the concentration of hydrogen ions (H+) in a
solution. You can think of pH as “parts Hydrogen ion,” but remember that the pH scale is
“backwards.” The pH scale ranges from 0 to 14,
with zero being the most acidic (highest concentration of H+)
and 14 being the most basic. Neutral solutions (like pure water) have a
pH of 7. Solutions with pH measurements below 7 are acidic, while
solutions with pH measurement above 7 are basic. A solution at pH 7 is
neutral because at that pH the number of hydrogen ions (H+)
equals the number of hydroxide ions (OH-), just as they are
balanced in pure water.
Hydrogen ion concentration can vary
over many orders of magnitude. To represent very large differences in
concentration levels, a logarithmic mathematical function is used to
denote the pH scale.
|
Acids and Bases in Solution
 A pH scale with annotated examples of chemicals at various pH values. On the left
are biological compounds and on the right are some foods and
cleaning products. A pH scale with annotated examples of chemicals at various pH values. On the left
are biological compounds and on the right are some foods and
cleaning products.
|
The pH scale is the -log of the hydrogen ion concentration; the minus
sign changes the negative numbers that would be obtained from log[H+]
to positive ones:
The log conversion reduces a tenfold change in hydrogen ion concentration to a one-unit
change in pH. Thus, starting at pH 7, a solution at pH 6 would have 10 times
more H+ than a neutral solution. On the other hand, a solution at pH
8 would have 10 times fewer H+ than the solution with pH 7. If you
skip a few units, the differences between solutions become very great indeed. Lemon juice (pH 2) has one million times more
H+ ions per unit volume than seawater, which has a pH of about 8.
One of the ways that scientists can measure the pH of a solution is to use indicator paper.
This is special paper that is infused with dyes that change color when placed in an acid
or a base. The most simple indicator paper is called litmus paper. Litmus paper comes in
two colors — red and blue.
- Red litmus paper turns blue in the presence of a base (it does not change color in the
presence of an acid).
- Blue litmus paper turns red in the presence of an acid (it does not change color in the
presence of a base).
In the presence of a neutral solution, red litmus paper remains red, and blue litmus paper
remains blue.
If an acid gives a hydrogen ion (H+) in solution and a base accepts a hydrogen ion
by giving a hydroxide ion (OH-), you may be wondering what will happen when
an acid and a base are combined. Let’s consider the combination of equal amounts of
hydrochloric acid (HCl), a strong acid, and sodium hydroxide (NaOH), a strong base. When
the hydrogen ion (H+) is released from hydrochloric acid, and the hydroxide
ion (OH-) is released from sodium hydroxide, the two ions combine to form
water (HOH). Water, as you know, has a neutral pH, so the process of combining an acid
and a base is called neutralization. Remember, in a neutral solution (like water) the
number of hydrogen ions equals the number of hydroxide ions. The remaining sodium ion
(Na+) from the sodium hydroxide and the remaining chloride ion
(Cl-) from the hydrochloric acid also stay in solution as dissolved table
salt (NaCl). This process can be written as it is below:
Notice that the same four atoms (H, Cl, Na, and OH) are found on each side of the
equation. Using this example we can generalize the process of neutralization as
follows:
The process of neutralization also gives off heat, indicating that chemical potential energy
is being released during the course of the reaction. Neutralization has many useful
applications. One such application in the laboratory is to neutralize strong acids or
bases so that they can safely be disposed of. As you will learn later in this course,
the addition of acids and bases to the environment leads to ecosystem damage, so before
a strong acid or base can be disposed of, it must be neutralized (to make water and
salt) to prevent injuries or environmental damage. In your everyday life you may be
familiar with acid and base neutralization through your lawn care and gardening
activities. Grass grows best in a very mildly acidic soil (pH 6.5 to 7). So if your soil
is too acidic (less than pH 6.5), you would need to add a compound like limestone (a
basic mineral) to your soil to neutralize the excess acidity and correct the pH level.
Likewise, if your soil is too basic (pH above 7), you would need to add sulfur, which
interacts with water in the soil to form sulfuric acid, to help neutralize the excess
base in the soil.
Another common application of neutralization is the standard volcano science fair project,
where a mixture of vinegar (an acid) and baking soda (a base) are combined to make the
volcano "erupt." In this case, the reaction releases some carbon dioxide gas, generating
fizz and fun.
If you ever come into contact with a strong acid or base and receive a chemical
burn, DO NOT attempt your own science experiment to try and neutralize the
compound. The damage to your skin is already occurring and can be exacerbated by
adding more chemicals; a vigorous neutralization reaction could cause further
harm through the release of heat, causing a physical burn on top of the chemical
burn already suffered. Your safest option is to wash the affected area under a
heavy stream of running water, and to seek medical attention for your burn. The
goal is to remove the agent causing the burn to prevent further damage.
Living organisms are quite sensitive to even small changes in pH. The chemical reactions of
life are tuned to a specific and often narrow pH range; outside this range, the
reactions will not proceed normally. Therefore, organisms have mechanisms that work to
maintain a constant pH level. This is true both at the cellular level and at the level
of the whole organism. Maintaining a stable pH in a living organism is an important part
of homeostasis. Homeostasis refers to the ability of an organism (or cell) to maintain
stable internal conditions despite constantly changing environmental conditions.
Buffers
One way in which changes in pH are moderated is through the use of buffers.
Buffers are aqueous solutions that can resist changes in pH. When an acid or a
base is added to a solution containing a buffer, the pH of the solution will
only exhibit a very minor change. Blood is a buffered solution. The liquid
portion of blood contains carbonic acid (H2CO3). It
dissociates (breaks apart) to produce bicarbonate ions
(HCO3-) and hydrogen ions (H+). This
reaction is easily reversible. If acid enters the blood (H+
concentration goes up), most of the excess hydrogen ions will bond with
bicarbonate, restoring carbonic acid. If a base enters the blood, the H+
concentration will initially go down. But then carbonic acid will
dissociate to replace the “missing” hydrogen ions. Thus the easily reversible
reaction works to oppose any pH change in the blood. A buffered solution cannot
absorb an unlimited amount of acid or base. As acid or base is added, any
buffered solution will eventually reach a limit called the “buffering capacity.”
At this point, no additional hydrogen ions can be absorbed or produced, and the
buffer stops working. The solution’s pH will change rapidly if further acid or
base is added.
While maintaining a pH close to neutral is usually the goal of homeostasis, there are certain
conditions and parts of organisms that are maintained at a lower (more acidic) pH. For
instance, the process of digestion is aided by the presence of stomach acid (pH 2). Not
only does stomach acid help to break down the compounds in our food, it also helps to
prevent disease by killing many of the bacteria and viruses found in food and water.
Lysosomes, digestive organelles found in eukaryotic cells, have an internal pH of about
5. Again this acidic environment is used to break down cellular food, waste, and even
invading bacteria. Likewise, the surface of our skin is acidic (pH of 4.5 to 6), which
helps to support the growth of our normal bacterial flora, as well as to help prevent
the growth of pathogenic bacteria.
When the normal pH levels of the body are disrupted, there are detriments to the health of
the organism. For instance, the female vaginal tract is moderately acidic, with a pH
between 3.8 and 4.5. When the pH increases in this area of the body (becomes more
basic), women are more prone to bacterial infections of the vagina. Conversely, if the
pH decreases (becomes more acidic), women are more prone to yeast infections.
Example
Diabetic Ketoacidosis
A higher-stakes example of loss of pH regulation occurs in diabetic ketoacidosis. In people
with diabetes, cells cannot take up glucose (sugar) from the blood efficiently. As a
result, cells switch from using glucose (sugar) as a fuel source and use fatty acids
(fats) instead. When fatty acids are broken down, ketone acids are produced as a
by-product. In healthy individuals, a small amount of ketone acids are released by
normal metabolic processes; for example, if you are losing weight, fat breakdown
will add some ketone acids to your bloodstream. This poses no problem because your
blood is buffered, and your liver and kidneys are able to remove the excess acids
before they cause problems. However, in people with diabetes, chronic release of
ketone acids can overwhelm these systems. Ketone acids build up in the blood and
urine, leading to a condition called ketoacidosis. The presence of excess ketone
acids lowers the body’s pH, leading to several health problems as detailed on the
figure below. If the pH balance is not restored, diabetics in ketoacidosis can face
serious harm and even death. Treatment consists of restoring proper insulin levels
in the body (so that carbohydrates can be absorbed by cells and used as a fuel
source) and ensuring proper hydration (to help the kidneys flush out the excess
ketones).
Symptoms of Acidosis
 This figure shows the symptoms of acidosis in the body broken
down by organ system. Notice that the symptoms range from mild to severe. In the
long term, these symptoms can become life threatening.
This figure shows the symptoms of acidosis in the body broken
down by organ system. Notice that the symptoms range from mild to severe. In the
long term, these symptoms can become life threatening.
While it is clear that the regulation of pH in living organisms is crucial to
their survival, the pH in the environment is just as important to maintaining
life on this planet. Different environments have different pH levels, and
organisms that live in those locations have adapted to those conditions. When
environmental pH levels are disrupted, the health and vitality of the ecosystem
becomes threatened.
Example
Seawater
As you have learned, seawater is slightly basic at pH 8. The oceans and the organisms that
live in them play a critical role in maintaining the balance of oxygen and carbon
dioxide on this planet. You will learn more about this in the Photosynthesis /
Cellular Respiration module in the Metabolism unit. With the increased burning of
fossil fuels in the modern industrial society, more man-made carbon dioxide
(CO2) is being released into the environment than ever before. Much
of this carbon dioxide is absorbed by the oceans. When carbon dioxide is absorbed
into water, carbonic acid is produced. This then dissociates to produce bicarbonate
ions and hydrogen ions, and the pH of the ocean is lowered. Acidification of the
ocean threatens the health of the organisms that call the ocean home. Many marine
life forms, including reef-building corals, are harmed or killed when ocean water is
acidified. As carbon dioxide levels in the atmosphere continue to climb, there is
great concern about the worsening impact of ocean acidification.
Effects of Acid on Coral Reefs
 Figure A shows a healthy vibrant coral reef. Notice the bright colors and water
clarity. Figure B shows a dying coral reef. Notice the dull, black color of the
reef and the poor water quality. Coral reefs are made up of millions of tiny
living organisms and provide shelter, food, and nesting grounds to other marine
animals. The death of coral reefs due to ocean acidification and other factors
is a matter of grave concern to marine biologists and to those who depend on
ocean ecosystems.
Figure A shows a healthy vibrant coral reef. Notice the bright colors and water
clarity. Figure B shows a dying coral reef. Notice the dull, black color of the
reef and the poor water quality. Coral reefs are made up of millions of tiny
living organisms and provide shelter, food, and nesting grounds to other marine
animals. The death of coral reefs due to ocean acidification and other factors
is a matter of grave concern to marine biologists and to those who depend on
ocean ecosystems.
Example
Acid Rain
Another environmental problem involving pH balance is acid rain. When nitrogen oxides and
sulfur dioxide, two common by-products of burning fossil fuels, combine with water
in the Earth’s atmosphere, acid rain is produced. In some regions, acid rain reduces
the pH of fresh water sources like streams, rivers, and lakes. It also may change
soil chemistry and harm plants. Some regions have rocks and soils that contain
buffers, and they are less susceptible to damage from acid rain. However, when soil
buffering capacity is exhausted (buffers cannot accept any more hydrogen ions), pH
may decline very quickly. Tighter regulations on coal-burning power plants have
helped reduce the acid rain problem in recent decades, but it remains a threat to
some forest and aquatic ecosystems and the organisms living within them. We will
learn more about acid rain in the Ecology unit.
In the Introduction to Chemistry
unit, you learned that atoms are the building blocks of all matter. You also learned
that atoms can be linked together
with chemical bonds, to form
molecules that have their own unique properties. In this unit, you will take
a closer look at a special group of molecules that form the backbone of living
structures: the biological macromolecules. Biological macromolecules are
special molecules that contain carbon atoms covalently bonded with hydrogen atoms.
 Atoms are the building blocks of all matter. Biological macromolecules are
formed when atoms of carbon, hydrogen, oxygen, nitrogen, phosphorus, and other
elements bond with each other in unique and varied ways. Biological macromolecules
are the raw materials used to build living organisms.
Atoms are the building blocks of all matter. Biological macromolecules are
formed when atoms of carbon, hydrogen, oxygen, nitrogen, phosphorus, and other
elements bond with each other in unique and varied ways. Biological macromolecules
are the raw materials used to build living organisms.
There are four classes of biological macromolecules that we will study in this course:
carbohydrates, lipids, proteins
and nucleic acids. These macromolecules are probably already
familiar to you, because they make up the nutrients you ingest every time you eat. In
this way, you provide your cells with the building materials and energy necessary to
sustain life. In the next unit, we will use these fundamental building blocks to form
the cell, the first level of organization that shows all the characteristics of life.
In chemistry, the word “organic” has a special meaning. It is different from the grocery-store
meaning, where “organic” refers to foods that are grown in a particular way and are free
of pesticides. In fact, many of the chemical pesticides that an organic farmer would
never use are actually organic molecules.
An organic molecule is any molecule that contains a carbon to
hydrogen (C-H) covalent
bond. They are often complex and many store a lot of chemical potential
energy. Examples of organic molecules include glucose, methane, DNA, protein, and fat.
All the molecules discussed in the "Introduction to Chemistry"
unit were inorganic molecules. Molecules like water, oxygen gas,
carbon dioxide, and ionic salts like sodium chloride fall into this category. Most
inorganic substances are relatively stable, simple, and store little chemical potential
energy. What exactly are organic molecules? All organic molecules have several
common properties that help distinguish them from inorganic molecules:
- All organic molecules contain carbon atoms bonded to hydrogen (C-H bonds). Organic
molecules often contain oxygen, nitrogen, phosphorus, or sulfur as well.
- Atoms within organic molecules are connected by covalent bonds.
- Organic molecules are modular. Smaller organic molecules (monomers) can be linked together to make larger organic molecules (polymers). Larger organic molecules consist of a
carbon/oxygen/nitrogen/phosphorus skeleton (backbone) with other atoms branching off from this
structure.
- Organic molecules are typically produced by living cells and are found in large
amounts only in living things or in their remains. However, it is important to
remember that some molecules produced by living things are inorganic. Humans have
developed ways to synthesize organic chemicals artificially.
In this module, you will learn more about how to recognize organic molecules. You’ll also
explore in more detail the important characteristics of organic molecules.
All organic molecules contain carbon atoms covalently bonded to hydrogen (C-H bonds). They
can also contain oxygen, nitrogen, or sulfur. In the next activity, you will practice
determining whether or not a chemical structure is an organic molecule.
Carbon's Role
Why are organic molecules so diverse and flexible in their structure? The
characteristics of carbon are essential for building the complex and diverse
structures needed for life. A single carbon atom is able to bond with up to four
other atoms, allowing the formation of chains, branched chains, and even rings.
Diversity of Carbon Skeletons
 Organic molecules have a diversity of shapes due to carbon’s ability to form four
covalent bonds. Carbon can form long chains (such as the fatty acid seen in
a); branched chains (as seen in b); rings (such as the cholesterol seen in
c); or even branched chains of rings (such as the glycerol seen in
d).
Organic molecules have a diversity of shapes due to carbon’s ability to form four
covalent bonds. Carbon can form long chains (such as the fatty acid seen in
a); branched chains (as seen in b); rings (such as the cholesterol seen in
c); or even branched chains of rings (such as the glycerol seen in
d).
Carbon forms covalent
bonds with many other elements; these strong bonds make organic
molecules durable.
DNA
 DNA is made of a carbon skeleton that is bound to nitrogen, oxygen, and phosphorus and
hydrogen.
DNA is made of a carbon skeleton that is bound to nitrogen, oxygen, and phosphorus and
hydrogen.
Modularity
Organic molecules come in all shapes and sizes. One of the key features of organic molecules
is their modularity: a limited set of monomers can be
connected in different ways to form a vast array of
polymers. It may help to consider an analogy: with a
few dozen different kinds of Lego bricks, you can make an almost limitless
diversity of structures. In organic molecules, monomers can be linked together
by bonds between different atoms, different monomers can be used, and they can
be strung together in many different arrangements. Therefore, organic molecules
are virtually limitless in their diversity.
Biological Macromolecules
The four major classes of biological macromolecules are carbohydrates, proteins, nucleic
acids, and lipids. These molecules carry out a diverse set of essential
functions. Carbohydrates are essential for energy storage
and cellular communication. Nucleic acids (such as DNA)
are essential for information storage within a cell and passing on this
information to the next generation. Lipids are essential
for energy storage and maintaining a boundary between the living organism and
its environment. Proteins are essential for carrying out
most of the necessary functions of life.
Each major class of organic molecules represents a diverse assortment of
polymers that are built from a handful of possible
monomers. The monomers, smaller molecules bound together,
are also called subunits. The table below lists the subunits for each class of
organic molecule. Different carbohydrates, for example, are polymers made up of
sugars (the monomers). Proteins are polymers made up of amino acids (the
monomers). Nucleic acids are polymers made up of nucleotides (subunits or
monomers). Even lipids are generated by combining separate fatty acid chemical
components.
| Macromolecules and Their Subunits |
|---|
| Large Macromolecule |
Small Subunit Molecule |
| proteins |
amino acids |
| carbohydrates |
sugars |
| lipids |
fatty acids |
| nucleic acids |
nucleotides |
|
There are many different types of proteins, carbohydrates, lipids, and nucleic
acids. Each has a different function and purpose in living organisms. There are
also many different types of subunit amino acids, sugars, fatty acids, and
nucleotides. The combination of these different types of subunits is what
determines the properties and function of the macromolecule. For example, the
function of a particular protein is determined by the amino acids in it.
Macromolecules and Their Subunits
Perform the following activity to review the relationship between polymers
(macromolecules) and monomers (smaller subunits). Indicate the macromolecule
composed of each subunit.
In the remainder of this unit, you will be exploring the chemical structures of the four
major types of biological macromolecules. You will see molecules represented in
a variety of ways. The following activity will help you practice interpreting
the different ways molecules can be illustrated.
Different representations of methane, ammonia, and albuterol are shown in the table below.
Formula gives the chemical formula, Molecular indicates how the atoms are bonded together,
2D-Structural provides some information about the
three-dimensional structure using a two-dimensional drawing. The solid wedges
indicate that the atoms are above the plane of the page and the dashed wedges
indicate that the atoms are below the page.
3D-Structural images are seen in the Jmol images at the right of each
row. You can manipulate the 3D-structures by placing the cursor in the window
and moving the mouse. You should understand the relationship between the
2D-structural representation and the 3D-structural representation. You should
also take note of the standard color coding in 3D representations: usually
carbon is gray, hydrogen is white, oxygen is red, nitrogen is blue, and sulfur
is yellow.
Functional groups are parts of organic molecules that have specific properties or functions.
Because organic molecules can contain more than one type of functional group, a
particular molecule may have multiple properties. Identifying functional groups in
molecules is an important skill, because once you identify a molecule’s functional
groups, you can predict many aspects of its biological behavior.
Functional groups can be divided into three groups based on their
physical properties. There are the nonpolar groups, the polar groups, and the charged
groups.
Nonpolar Functional Groups
Functional groups in this category are also referred to as hydrophobic
(water-hating) groups. They only contain carbon and hydrogen, and lack
electronegative atoms such as nitrogen, oxygen,
and sulfur. Nonpolar functional groups are often found on amino acid side chains
of proteins, and they also make up a major part of most lipid molecules. The
hydrophobic nature of nonpolar functional groups often affects the shape of
molecules containing these groups. For example, proteins will fold so that
nonpolar groups are clustered together and are not in contact with water. Some
lipids bury the nonpolar section of the molecule by forming lipid bilayers,
which shape the boundaries of all cells.
The key nonpolar functional groups are:

Also, long chain alkanes, (CH2)n, found in lipids, are among the
nonpolar functional groups.
Polar Functional Groups
Polar functional groups contain electronegative atoms like nitrogen (N), oxygen
(O), and sulfur (S). The presence of electronegative atoms in a functional group
results in an unequal distribution of charges on the atoms, causing the bonds to
become polar. Because polar bonds interact favorably with water, compounds with
polar functional groups also interact favorably with water, making them
hydrophilic, or water-loving. In addition to interacting favorably with water,
the polar atoms can also participate in chemical reactions and polar functional
groups are usually responsible for the catalytic properties of enzymes.
The key polar functional groups are:

Some compounds contain both nonpolar and polar functional groups; molecules of
this type are referred to as amphipathic molecules.
Phospholipids and soaps are examples of amphipathic molecules.
Charged Functional Groups
Charged functional groups are acids, meaning that they form ions by the
release of hydrogen ions (H+), which are also called
protons. Depending on the specific functional group, these groups of molecules
lose a hydrogen ion (or deprotonate) and become either
charged or neutral as a result. Charged functional groups play key roles in
biological systems. For example, many proteins bind to
DNA (or RNA) by utilizing
the electrostatic interaction between positive charges on
the protein and negative charges on the DNA or RNA. Note
that when these groups are in their uncharged state, they can be considered to
be polar functional groups.
The key charged functional groups are:

A special case of the phosphate group is a phosphate
diester, which links together nucleotides in DNA and RNA. The phosphate diester
is always negatively charged at neutral pH.
Functional Group Tutorial
If you need a reminder of chemical structures or of how to view molecules in 3D, review
Viewing
Chemical Structures in the Introduction to
Chemistry unit.
Carbohydrates are organic molecules that consist of carbon, hydrogen, and oxygen atoms in a
1:2:1 ratio. The most abundant class of macromolecules found in living systems,
carbohydrates are the primary source of energy in living systems. Large complex
carbohydrates can be used to store energy. For example, a potato is full of starch,
which is a complex carbohydrate that the potato plant uses to store energy. When you eat
the complex carbohydrate, your body breaks the large molecules into their smaller
subunits (sugars), which you will then use to fuel your own body’s energy needs.
Carbohydrates can also be used as structural building materials. Cellulose is an example of a
complex carbohydrate used in plants for structural support. Within plant cell walls,
cellulose molecules form chains that provide high tensile strength. In some plants,
cellulose is also included in a secondary cell wall, which adds rigidity and
waterproofing. This helps tree bark, plant leaf stalks, and other structures resist wind
and other physical forces in the environment.
Cellulose, while indigestible to humans, is an important part of our diets because it makes up
dietary fiber, which has been linked to lowered risk of diabetes and heart disease. In
this module, you will take a closer look at the structure and function of these
important macromolecules.
The paper you write on, the bowl of cereal you eat for breakfast, and the energy you use to
walk up a flight of stairs all come from carbohydrates. Rice, wheat, and corn are some
of humanity’s most important crops; these foods are the primary source of energy for
much of our population. All three of these foods are high in carbohydrates.
A carbohydrate is an organic molecule that contains
carbon, hydrogen, and oxygen. Carbohydrates are either simple (often referred to as
sugars) or complex. Simple carbohydrates (sugars) are made up of only one or two sugar
monomers. Each monomer has the proportion of carbon to hydrogen to
oxygen in the ratio of 1:2:1, or (CH2O). You can see why
these compounds are called carbohydrates; in a monomer, each carbon is “hydrated.”
Complex carbohydrates are made up of more than two sugar monomers linked together.
Carbohydrates can be further subclassified, again on the basis of structure, depending
on the number of monomers in each molecule: monosaccharides and
disaccharides (simple carbohydrates) and
polysaccharides (complex carbohydrates).
Simple carbohydrates are quickly and easily accessed to generate energy
the cell can use, while complex carbohydrates are used to store energy for a longer
period of time. Some complex carbohydrates are also used as
structural components. Carbohydrates also play a role in cell signaling and recognition
within multicellular organisms.
Monosaccharides
Monosaccharides are the simplest sugars. The root “mono” means "one," and “saccharide” refers
to an organic molecule where the ratio of carbon:hydrogen:oxygen is 1:2:1 (i.e.,
CNH2NON). The more common
monosaccharides contain six carbons and have a molecular formula of
C6H12O6. Glucose, fructose (fruit sugar),
and galactose are examples of six-carbon monosaccharides. A common five-carbon
monosaccharide is ribose (the sugar component of RNA),
which has a molecular formula of C5H10O5.
DNA contains a modified ribose where one of the
oxygen atoms has been removed, hence the name deoxyribonucleic
acid. Shorter monosaccharides exist as linear molecules while five-
and six-carbon monosaccharides form ring-like structures.
Sample Monosaccharides
 Glucose (a) and fructose (b) are monosaccharides
containing six carbons. Ribose (c) is a monosaccharide containing five
carbons.
Glucose (a) and fructose (b) are monosaccharides
containing six carbons. Ribose (c) is a monosaccharide containing five
carbons.
Disaccharides
Disaccharides are made of two monosaccharides linked together by a covalent bond (the root
“di” means "two").
- glucose + fructose = sucrose (table sugar)
- glucose + galactose = lactose (milk sugar)
Disaccharides
 Sucrose is composed of one glucose and one fructose linked together.
Sucrose is composed of one glucose and one fructose linked together.
Polysaccharides
Polysaccharides are long chains of monosaccharides (“poly” means "many").
Glycogen, starch (amylose and amylopectin), and cellulose are all made of many
linked glucose monomers. Glycogen is mainly used for energy storage in animals.
Starch is mainly used for energy storage in plants. Cellulose is mainly used for
maintaining plant structure. These three molecules are all made of glucose, so
why do they have such different functions? The main difference is how the
glucose monomers are linked together. This is a prime example of one of the
central themes of biology: form affects function.
These differences are explained in more detail below.
Chitin, a modified structural polysaccharide, is best known as a major component of the
exoskeleton (hard outer shell) of arthropods (e.g., beetles, crabs, lobsters)
and mollusks (e.g., snails, clams, scallops). However, chitin also plays a minor
role in the cell structure of some fungi, algae, and yeasts. Chitin
(C8H13NO5)n is comprised of
slightly-modified glucose monomers.
Source of Stored Energy
Digestible carbohydrates provide energy in a form that is easily accessible.
Glucose, with the chemical formula C6H12O6, is
a simple sugar and a monosaccharide. It is one of the most abundant and
important energy molecules for living things. The energy stored in covalent
bonds between atoms (within a glucose molecule, in this case) is released during
cellular respiration, when glucose is broken down and converted to simpler, more
stable molecules. This energy can be captured to make ATP, which can then be
used to power cellular processes. This will be covered in greater detail in the
metabolism unit.
In animals, excess glucose molecules are linked together (through an anabolic
pathway) to make a long branching polysaccharide called glycogen. Glycogen is primarily stored in the liver, with small
amounts being stored in the muscles. Once glycogen stores are filled, the body
begins storing excess food calories as fat. Conversely, when food intake is
insufficient to keep up with energy requirements, the body will break down its
glycogen stores to release individual glucose monosaccharides.
Glycogen Can be Broken Down into Glucose
 When energy is needed, glycogen stores can be
broken down into individual glucose molecules. The glucose can then be used to
make ATP (a usable form of energy for the cell).
When energy is needed, glycogen stores can be
broken down into individual glucose molecules. The glucose can then be used to
make ATP (a usable form of energy for the cell).
Starch
Starch, another branching polysaccharide, is the primary
form in which excess glucose is stored in plants (and other producers). Starch,
just like glycogen, is composed of individual glucose monomers joined together.
And, like glycogen, starch is broken down to release individual glucose
molecules that can be used to build ATP. The difference between these two energy
storage polysaccharides lies in the organization of the glucose
monosaccharides.
Starch Can Be Broken Down into Glucose
 When energy is needed, starch stores can be broken
down into individual glucose molecules. The glucose can then be used to make ATP
(a usable form of energy for the cell).
When energy is needed, starch stores can be broken
down into individual glucose molecules. The glucose can then be used to make ATP
(a usable form of energy for the cell).
Carbohydrates as a Structural Component
Cellulose, like glycogen and starch, is a polysaccharide that is made up of many
glucose monosaccharides linked together. Cellulose is an important structural
carbohydrate that provides support within plant cell walls. This carbohydrate is
indigestible by humans and most animals. Some animals (e.g. cows, horses, and
termites) can digest this carbohydrate. These animals have symbiotic (“living
together”) bacteria that inhabit their digestive tract. The bacteria produce
enzymes that break down cellulose, making sugar available to their hosts.
Deoxyribonucleic acid (DNA) and ribonucleic acid (RNA) are the molecules involved
with storing our genetic information (DNA) or the conversion of that information
into proteins (RNA). Sugars (deoxyribose in DNA, ribose in RNA) play a part in
the structure of these nucleic acid molecules. They alternate with phosphate
groups to make up the long backbone of nucleic acids, as shown below.
Carbohydrates as Cell Recognition and Signaling Molecules
Although we will not delve into the specifics of this topic, carbohydrates play a variety of
roles in identification and signaling. One of the ways your immune system is
able to identify foreign invaders is through detection of the different
carbohydrates displayed on the surface of cells. Additionally, the first step in
fertilization between a sperm and egg is generally believed to involve
carbohydrate-to-carbohydrate interactions. As a final example, the specific
carbohydrates attached to the surface of your red blood cells determine your
“blood group” (A,B,O) and predict what kind of blood you can safely receive in a
transfusion.
Indigestible carbohydrates, which cannot be degraded by human digestive enzymes, are referred
to as dietary fiber. Cellulose, mentioned above as a major
component of plant cell walls, is one of the largest contributors of dietary fiber.
Pectin is another structural carbohydrate found in most plants, especially apples and
citrus fruits, and is commonly used as a gelling agent to make jams and jellies. A diet
high in fiber has several benefits. Dietary fiber plays a role in maintaining regular
digestive functioning, slowing the absorption of sugar into the bloodstream, and
reducing bad cholesterol. So the old saying “an apple a day keeps the doctor away” does
have some truth to it, since there are proven health benefits associated with the
consumption of foods that are high in fiber, like apples. Other foods that are high in
fiber are oatmeal, popcorn, raspberries, black beans, lentils, and peas, to name a
few.
For a quick boost of energy, simple sugars are the carbohydrate of choice; diabetics will
oftentimes carry a sugary food or drink with them in case their blood sugar level drops
too low. However, excessively high blood sugar levels can be equally dangerous.
Accordingly, doctors routinely suggest that diabetics eat a diet high in fiber to help
manage their diabetes, since fiber helps to slow the absorption of sugar into the
bloodstream, which helps diabetics to prevent spikes in blood sugar. In contrast with
simple sugars, complex carbohydrates are broken down by the body more slowly and energy
is released in a stepwise fashion.
Lipids are a diverse group of macromolecules united by their hydrophobic, nonpolar nature. We are most
familiar with the lipids known as fats. Fats are used to store energy for later use.
They also provide structural support and cushioning for many animals. Some dietary fats
are healthier than others. In this module, you will learn about the differences between
saturated, unsaturated, and trans fats.
People are most familiar with fats, but there are other types of molecules that are not fats,
but are lipids. Cholesterol is a familiar example of a lipid that is not actually a fat.
You will learn more about cholesterol in this module as well.
Lipids include a diverse group of compounds that are united by two common
features. First, they are largely nonpolar in nature. This is because they are
hydrocarbons that include many nonpolar carbon-carbon or carbon-hydrogen bonds. Second,
because lipids are nonpolar, they are also hydrophobic (water-hating), or insoluble in
water.
Lipids perform many different functions in a cell. Cells store energy for long-term use
in the form of fats. Lipids also provide insulation from the environment for plants and
animals. For example, they help keep aquatic birds and mammals dry because of their
hydrophobic nature. Lipids are also the building blocks of many hormones and are an
important constituent of the cell’s plasma membrane. Lipids include fats, oils, waxes,
phospholipids, and steroids.
Summary of Lipid Structures and Functions
Because lipids are such a diverse group of biomolecules, we will study them in four
categories. Examine the following table for a general understanding of lipid
structure and function.
Waxes are nonpolar lipids that form protective layers on plants and
animals. For example, waxes cover the feathers of some aquatic birds to keep the
feathers dry. Plants, on the other hand, often have leaves coated with waxes to prevent
water from evaporating off the plant surface. Because of their hydrophobic nature, waxes
prevent water from sticking on the surface of these structures.
Wax: "Esterified" Fatty Acid Chain
 Chemical structure of cetyl palmitate, a typical wax ester.
Chemical structure of cetyl palmitate, a typical wax ester.
The chemical structure of a wax is linked to its function. Waxes are the simplest lipids
in nature, consisting of two long hydrocarbon chains linked in the middle by an ester
group. It is this structure that enables waxes to function the way they do in living
systems.
Steroids are a family of lipids based on a molecular structure with four fused carbon rings.
This family of lipids includes many hormones and cholesterol. Hormones (such as estrogen
and testosterone) are used by some animals as long-distance messengers. This means that
they are produced by cells in one part of the body and affect cells in a different part
of the body.
 Steroids — including cholesterol, testosterone, vitamin D2, and cortisol —
are characterized by four fused hydrocarbon rings. The chemical groups attached to
these carbon rings are what distinguishes different types of steroids: (A) shows a
molecule of cholesterol; (B) shows a molecule of testosterone; (C) shows cortisol;
and ( D) shows vitamin D2.
Steroids — including cholesterol, testosterone, vitamin D2, and cortisol —
are characterized by four fused hydrocarbon rings. The chemical groups attached to
these carbon rings are what distinguishes different types of steroids: (A) shows a
molecule of cholesterol; (B) shows a molecule of testosterone; (C) shows cortisol;
and ( D) shows vitamin D2.
Cholesterol is an example of a familiar steroid that plays many important roles in your
body. While most people are familiar with cholesterol, they often don’t realize how
important it is for healthy function. In fact, most of the cholesterol in your body is
synthesized by your liver. Cholesterol has many functions. Cholesterol is used to build
steroid hormones, including testosterone and estradiol, which are secreted by the sex
organs. Cholesterol is also the precursor to vitamins D and K. Some cholesterol is
converted to bile salts, which help in the absorption of fats from the digestive system
into the body. Cholesterol is also used by animals to maintain the proper consistency of
the cell membrane, which is the structure that surrounds every cell. Other organisms use
different steroids for this function. For example, plants use a steroid called
stigmasterol, while fungi use ergosterol.
Structure and Function of Triglycerides
Fats and oils are called triglycerides because they are made of three (“tri”) fatty acids
attached to one glycerol. A fatty acid is a carboxylic acid that contains a long
hydrocarbon chain. The fatty acids are usually 16 to 22 carbons long, but can
range from 4 to 36 carbons in length.
 In one triglyceride there are three fatty acid tails (shown on the
right). Each is connected by a covalent bond to one of the three oxygen
atoms of a glycerol group.
In one triglyceride there are three fatty acid tails (shown on the
right). Each is connected by a covalent bond to one of the three oxygen
atoms of a glycerol group.
Fats are mainly energy storage and insulating molecules. Per gram, fats contain
twice as much energy as carbohydrates. Layers of fat also surround the vital
organs of animals to help cushion and protect them. In some animals, layers of
fat under the skin provide insulation. This is particularly true of marine
endotherms (i.e., organisms that maintain internal body temperature using their
own metabolism) that live in cold polar regions, like penguins, whales, and seals.
These are all examples of animals with thick insulating “blubber” beneath the skin.
Saturated and Unsaturated Fats
In one triglyceride there are three fatty acids. All of these can be the same, or
there can be two or three different types of fatty acids in a single
triglyceride. The fat’s properties depend on the types of fatty acids that are
present.
In saturated fatty acids, all of the carbon-carbon bonds are single bonds and each carbon is
bonded to two or three H atoms; each carbon is “saturated” with hydrogen.
Because all the bonds are single, the entire fatty acid can adopt a linear
shape. Unsaturated fatty acids have one, two, or even three double bonds along
the carbon “backbone.” Notice in the diagram below that at each double bond, the
carbons involved are bonded to only one instead of two hydrogen atoms. Thus
these fatty acids have less hydrogen; they are “unsaturated” with respect to
hydrogen. The double bonds found in the unsaturated fatty acids have an effect
on the overall shape of a triglyceride: unsaturated fatty acids are normally
“kinked,” because the double bond prevents free rotation between the two carbons
involved.
 Three 12-carbon fatty acids are shown. The top structure, lauric acid, is fully
saturated. The two lower structures are unsaturated fatty acids, each with a
double bond. The cis (left) form is
typically found in biological lipids. In cis unsaturated fatty acids, the
hydrocarbon chain is kinked at each double bond. The trans (right) form is generated artificially by a
process that is used to convert liquid vegetable oil to solid margarine. In
trans fatty acids, the double bond is rotated so that the fatty acid is
relatively straight.
Three 12-carbon fatty acids are shown. The top structure, lauric acid, is fully
saturated. The two lower structures are unsaturated fatty acids, each with a
double bond. The cis (left) form is
typically found in biological lipids. In cis unsaturated fatty acids, the
hydrocarbon chain is kinked at each double bond. The trans (right) form is generated artificially by a
process that is used to convert liquid vegetable oil to solid margarine. In
trans fatty acids, the double bond is rotated so that the fatty acid is
relatively straight.
Saturated fats have three saturated fatty acid “tails” — all of which are linear in shape.
With their compact shape, saturated fat molecules pack together efficiently and
form a solid at room temperature. These are usually produced by animals;
everyday examples of saturated fats include lard and real butter. Unsaturated
fats have at least one unsaturated fatty acid. With their “kinky” fatty acid(s),
unsaturated fats will not pack into a regular structure and thus remain fluid at
room temperature. They are called oils, and are commonly produced by plants;
everyday examples include olive oil, corn oil, and canola oil.
A diet rich in saturated fats may contribute to formation of plaques in the arteries
(atherosclerosis) and increase your risk of heart disease. To reduce this risk, it is
recommended that you replace some foods rich in saturated fats (e.g. fatty cuts of pork,
beef, and high-fat dairy products like butter) with foods that provide unsaturated fats
(available in foods like olive oil, canola oil, seafood, and walnuts). Such a shift is
believed to help improve blood cholesterol levels and may reduce your risk of
cardiovascular disease.
Physical Properties of Saturated and Unsaturated Fats

In the diagram above, you see the physical behavior of two different triglycerides (with
saturated and unsaturated fatty acids) at three distinct temperatures. Figure 1 shows
that at a temperature of 0oC (freezing), both types of fatty acids stack
neatly. At 16oC (Fig. 2), the unsaturated fatty acids lose the tightly
stacked formation and become more mobile. At 70oC, the saturated fatty acids
also become mobile (Fig.3). At 27oC (room temperature) and at 37oC
(body temperature), triglycerides with unsaturated fatty acids are liquid oils, whereas
saturated fats remain solid.
Phospholipids are an important class of lipids found in the membranes of all cells and
organelles. A phospholipid contains only two fatty acids attached to a glycerol, which
in turn is bound to a phosphate group. Together, the phosphate and the glycerol make up
the “head” of the phospholipid. The fatty acids make up the molecule’s “tail.” The
phosphate group carries a negative charge and is therefore hydrophilic. The tail, on the
other hand, is made up of nonpolar fatty acids and, like other lipids, is hydrophobic.
Thus phospholipids, like fatty acids, are amphipathic. An amphipathic molecule has both
a hydrophilic end and a hydrophobic end.
 A phospholipid is made of two fatty acids and a phosphate group attached to
glycerol.
A phospholipid is made of two fatty acids and a phosphate group attached to
glycerol.
 For simplicity, phospholipids are often drawn as a circle to indicate the
phosphate group and 2 chains to indicate the fatty acids.
For simplicity, phospholipids are often drawn as a circle to indicate the
phosphate group and 2 chains to indicate the fatty acids.
Remember that hydrophilic
molecules dissolve in water and hydrophobic ones do not. But phospholipids have a “split personality” in
this regard. How do they behave in water? When small numbers of phospholipids are in an
aqueous solution they will self-assemble into micelles, structures that exclude water
molecules from the hydrophobic tails while keeping the hydrophilic head in contact with
the aqueous solution. If enough phospholipids are present, they will form a bilayer.
This is the favored formation because it is the most stable orientation for
phospholipids in a water solution. View the animation that demonstrates the formation of
micelles and bilayers.
Click the green arrow to play the animation.
With their “split personality,” phospholipids are able to play a very important role in
biology. Phospholipids, together with other molecules in smaller quantities, form
membranes that surround the cell and intracellular organelles such as mitochondria. The
cell membrane is a fluid, semipermeable bilayer that separates the cell's contents from
the environment. See animation below.
A closer view of a Lipid Bilayer forming a membrane
Although some cholesterol is essential for healthy physiological functioning, excess
cholesterol can lead to health problems. Because cholesterol is hydrophobic, it cannot
be easily transported through the body in the blood stream. A carrier is required to
transport cholesterol around the body to the cells that need it. These carriers are
called lipoproteins. You can think of lipoproteins as cholesterol
boats that carry cholesterol to the body’s cells (where it can be used to build or
repair cell membranes or synthesize steroid hormones). Lipoproteins that carry
cholesterol to the cell for use are called low-density
lipoproteins (or LDL). LDL is often referred to as “bad” cholesterol, because
excess LDL levels have been linked to plaque deposition in the arteries, which can
result in heart disease. Another type of lipoprotein, known as high-density lipoprotein
(or HDL) transports cholesterol to the liver, where it is often
turned into bile salts and excreted. HDL is often referred to as “good” cholesterol,
because high blood concentrations of HDL have been linked to a decreased risk of heart
disease. Exercise and proper diet can increase HDL levels. Increasing intake of
unsaturated fats and decreasing intake of saturated fats is also a good strategy for
increasing HDL levels.
Proteins are the most functionally diverse group of biomolecules we will examine in this
unit. Critical to our diet, protein can be found in animal products like meats and
cheeses, as well as in plant products like beans and grains. Kwashiorkor, which causes a
distinct swelling of the abdomen, is often seen in malnourished children who lack
sufficient protein in their diets. Proteins are also found in many toxins, such as the
incredibly poisonous toxin produced by the bacterial species Clostridium botulinum.
Studies have shown that just one teaspoon of this poison, which is a protein, would be
enough to kill 20 percent of the world’s population! This module will take a closer look
at the structure of a protein and examine how protein structure enables such a wide
range of diverse functions.
Proteins are macromolecules built from amino acids. There are 20 different amino acids
that can be joined in a myriad of ways to produce molecules with an enormous variety of
possible structures that can perform a huge number of critical cellular functions. The
following list represents just a sampling of the many things proteins can do in living
systems.
- Proteins can catalyze chemical reactions by accelerating the rate at which chemical
reactions take place in the cell. Proteins that catalyze reactions are called
enzymes.
- Proteins play a role in the storage, replication, transmission, and regulation of
genetic information (DNA). Some proteins bind to DNA and either reduce the
expression of a gene, or activate the expression of a gene.
- Proteins can help move substances in and out of the cell. These proteins can be
embedded in the cell membrane, where they act as transporters.
- Some soluble proteins can transport materials throughout the body. Hemoglobin is a
protein that is found in high concentrations in red blood cells. Hemoglobin carries
oxygen from our lungs to our tissues.
- Proteins can recognize specific molecules. Protein receptors found in the lining of
your nose recognize and bind to chemicals in the air, which triggers a message to
the brain indicating the presence of a certain smell.
- Proteins can facilitate mechanical movement. Special proteins found in muscle cells
use the energy in ATP to flex your muscles.
- Proteins can help maintain structure in an organism. The cellular cytoskeleton
consists of proteins that form long fibrous scaffolding in cells that helps the cell
maintain its shape.
Take a look at this diagram to see even more ways that proteins are used in your
body.
 Source: The Structures of Life,
National
Institute of General Medical Sciences.
Source: The Structures of Life,
National
Institute of General Medical Sciences.
Amino acids are the building blocks of proteins. A protein is composed of a series
of amino acids attached end-to-end via covalent bonds. Consequently, a protein looks
like a string of beads, with each bead representing an amino acid. The bond between the
amino acids is referred to as the peptide bond.
 Amino acids, represented here by circles, are the building blocks of proteins.
When amino acids are attached to each other via peptide bonds, they form a protein.
Proteins can be made up of a number of different amino acids, represented in this
figure by the open and filled circles.
Amino acids, represented here by circles, are the building blocks of proteins.
When amino acids are attached to each other via peptide bonds, they form a protein.
Proteins can be made up of a number of different amino acids, represented in this
figure by the open and filled circles.
An amino acid is a small organic chemical that is made up of four parts. There is a
nitrogen-containing amino group on one end of an amino acid. The other end of an amino
acid has a carboxylic acid group. These two groups (the amino group and the carboxylic
acid group) are the reason for the name “amino acid.” The amino and carboxylic acid
groups are linked by a single carbon atom called the alpha carbon. Finally, there is a
variable “R group” also attached to the alpha carbon. The amino acids differ in the
nature of the R group that is attached to the central alpha carbon. There are 20
different R groups commonly found in nature. In this way, all amino acids are identical
except for the different R groups (also called side chains) attached to the alpha
carbon. The properties of different proteins depend entirely on the sequence, or
arrangement, of the amino acids.
There are many ways to represent an amino acid. Take a look at some of the representations
below.
 This is a building block diagram. This is a building block diagram.
|
 This image reminds you that the blocks are representing chemical structures. This image reminds you that the blocks are representing chemical structures.
|
 Two amino acids are shown: alanine and serine. The building block diagram for each amino
acid is on the left and the chemical structure is on the right. Note that only the
side chain (R group) differs between the two: in alanine, it consists of a nonpolar
CH3 group; in serine, one of the hydrogens has been replaced by a polar -OH group
Two amino acids are shown: alanine and serine. The building block diagram for each amino
acid is on the left and the chemical structure is on the right. Note that only the
side chain (R group) differs between the two: in alanine, it consists of a nonpolar
CH3 group; in serine, one of the hydrogens has been replaced by a polar -OH group
Proteins are built when amino acids are linked end-to-end by covalent bonds. The covalent
bonds that link amino acids are called peptide bonds. A peptide bond is formed when the
amino group of one amino acid reacts with the carboxylic acid of another amino acid.
After a peptide bond forms, the three conserved parts of the two amino acids (the
nitrogen group, the alpha carbon and the carboxylic acid) are all linked, forming the
main chain, or backbone, of the protein. The variable side chains of each amino acid
(the R groups) project out from the main chain.
Two amino acids join to form a dipeptide. Longer chains of connected amino acids are
often called polypeptides. When polypeptides are synthesized, new amino acids are added
only to the carboxylic acid end of the existing chain. A completed polypeptide is
directional; it has two different ends. One end has a free amino group, while the other
end has a free carboxylic acid group. When amino acids in a protein are counted, the
numbering starts with the amino acid that has the free amino group. The last amino acid
is also the last one that was added when the chain was built: it has a free carboxylic
acid group.
 Peptide bond formation. The left side shows a building block representation; the right
side shows chemical structures. Note that the serine is flipped upside down in the
right diagram for ease of presentation. The amino group of the second amino acid
(serine) forms a peptide bond with the carbon that is part of the carboxylic acid
group of the first amino acid (alanine), releasing a water molecule. The atoms that
become the water molecule are highlighted in yellow. There is now a dipeptide ("di"
means "two"). The resultant dipeptide consists of a continuous chain of main-chain
atoms (pink highlight), from which the side chains project. When building a
dipeptide, any pair of amino acids can be linked together in any order. This
variability and the different chemical properties of each amino acid result in a
vast number of very different proteins with very different functions.
Peptide bond formation. The left side shows a building block representation; the right
side shows chemical structures. Note that the serine is flipped upside down in the
right diagram for ease of presentation. The amino group of the second amino acid
(serine) forms a peptide bond with the carbon that is part of the carboxylic acid
group of the first amino acid (alanine), releasing a water molecule. The atoms that
become the water molecule are highlighted in yellow. There is now a dipeptide ("di"
means "two"). The resultant dipeptide consists of a continuous chain of main-chain
atoms (pink highlight), from which the side chains project. When building a
dipeptide, any pair of amino acids can be linked together in any order. This
variability and the different chemical properties of each amino acid result in a
vast number of very different proteins with very different functions.
The order of the amino acids in a particular protein is determined by information encoded in
the cell's genes, and the order of amino acids is referred to as the sequence of the
protein. An example of a protein sequence is shown below where the one-letter
abbreviations are used for each of the 20 amino acids used in cellular protein
synthesis. By convention, the first amino acid is at the end with the free amino group
and the last amino acid is at the end with the carboxylic acid group.
Example
Human Myoglobin
The linear chain of amino acids will spontaneously fold into a three-dimensional shape, which
is usually the active form of the protein. For example, look at the drawing of the
three-dimensional structure of myoglobin (shown on the left). You can manipulate the
3D structure using the Jmol image on the right.
Many folded proteins bind small organic molecules that assist the protein in performing its
function. For example, the heme group in myoglobin (colored gray in the right image)
is not part of the protein chain, but fits within a pocket in the myoglobin protein.
Myoglobin is responsible for binding oxygen in muscles. Heme groups also are present
in the oxygen transport protein, hemoglobin.
Protein Folding
Proteins spontaneously fold to form their functional three-dimensional shape, reaching the
lowest energy state, because this is the most stable state. The folding process
can be reversible, meaning that a folded protein can unfold and then refold.
However, unfolding can also be irreversible, where the unfolded protein chains
tangle with each other, forming an aggregate and precipitating out of solution.
This is often referred to as a denatured state. Conditions that
cause proteins to unfold and denature are extremes of temperature and pH.
Cooking denatures proteins by heating so they unfold and denature. The same
effect occurs when proteins are exposed to the low pH in your stomach. This
helps your body digest the proteins found in your food, and it helps kill
ingested bacteria and viruses.
 The folded structure of one particular protein is similar for all molecules in
solution. Heating the sample can cause the protein to unfold. In the
unfolded state, each molecule has a different shape. The unfolded protein
can either refold, or the chains can aggregate or tangle, forming the
insoluble denatured form. The polypeptide sequence is the same for all three
forms of the protein.
The folded structure of one particular protein is similar for all molecules in
solution. Heating the sample can cause the protein to unfold. In the
unfolded state, each molecule has a different shape. The unfolded protein
can either refold, or the chains can aggregate or tangle, forming the
insoluble denatured form. The polypeptide sequence is the same for all three
forms of the protein.
The Hydrophobic Effect on Folding
Although many factors stabilize the final shape of a protein, the most important factor is
the hydrophobic effect. Amino acids with nonpolar (hydrophobic) side chains are
driven into the central core of the protein because they are repelled by the
water. This is known as the hydrophobic effect, and it results in proteins that
have amino acids with hydrophilic side chains on the surface of the protein. The
folded protein reaches the lowest energy state, which is the most stable, by
folding in a way that will optimize the burial of nonpolar amino acid side
chains while still leaving the polar groups on the surface. Therefore, the shape
of the folded form of the protein depends on the order of the
hydrophobic amino acids in the protein.
Example
Consider a short 12 amino acid protein consisting of polar (white) and nonpolar (black)
amino acids. This polypeptide will fold to bury most of the nonpolar amino
acids, removing them from contact with water, giving the lowest energy
state. Other structures are possible, but these will be higher energy (and
consequently less stable) because they expose more nonpolar amino acid side
chains to water.
 The unfolded form of a 12 amino acid peptide is shown on the left. Notice that the
first amino acid is polar, followed by a nonpolar one, and then two
polar ones. Two possible folded structures are shown on the right. The
top structure exposes four nonpolar side chains to the water, while the
lower structure only exposes three nonpolar side chains to the water.
This indicates that the lower structure would be the most stable folded
structure. The red line shows the path of the main-chain
atoms.
The unfolded form of a 12 amino acid peptide is shown on the left. Notice that the
first amino acid is polar, followed by a nonpolar one, and then two
polar ones. Two possible folded structures are shown on the right. The
top structure exposes four nonpolar side chains to the water, while the
lower structure only exposes three nonpolar side chains to the water.
This indicates that the lower structure would be the most stable folded
structure. The red line shows the path of the main-chain
atoms.
The biological function of most proteins involves binding to something else. The binding
event may be the first step in transport, signaling, regulation, or an enzyme-catalyzed
reaction. Molecules that bind to proteins without being modified are called
ligands. Although ligands are usually small molecules, they can also be
larger than the protein to which they are binding. For example, when proteins bind to
DNA, it is the DNA that is the ligand. Oxygen is a ligand when it binds to hemoglobin (a
protein) during oxygen transport to the tissues. Molecules found on the surface of
bacterial cells are ligands when antibodies (proteins) in your blood bind to them during
an immune response. Sometimes ligands are given special names to remind us of their
function. For example: enzyme inhibitors are ligands that bind to and inhibit enzymes;
antigens are ligands that are recognized by antibodies (which are proteins).
The ligand binds to the protein by interacting with amino acids in the protein’s
binding site. Binding proteins have binding sites for their ligand (L).
Binding proteins have binding sites for their ligand (L).
Binding proteins have amino acids in their binding site that are complementary to
the ligand. Generally, a higher degree of complementarity leads to tighter
binding and a more specific interaction. The molecules can be complementary in
these different ways:
- The shape of the ligand matches the shape of the ligand binding pocket on
the protein. The better the match, the stronger the bond between the ligand
and the protein.
- Any charges on the ligand molecule can be aligned close to opposite charges on the
protein's binding site. Remember, opposite charges attract each other.
- Hydrogen bonds often form between the ligand and the protein binding site.
- Nonpolar ligands bind more favorably to nonpolar surfaces on the protein.
The interactions between proteins and their ligands are incredibly diverse, but they all
share some basic ground rules. Protein-ligand binding is:
- Reversible — bound ligands can be released by the protein.
- Concentration dependent — the level of binding depends on the ligand concentration. As the
ligand concentration increases, so does the amount of protein bound.
- Limited — once all of the proteins are ligand bound, no additional ligand can bind and the
protein is said to be saturated.
Enzymes are proteins that have the ability to bind substrate in their active site
and then chemically modify the bound substrate, converting it to a different molecule —
the product of the reaction. Substrates bind to enzymes just like ligands bind to
proteins. However, when substrates bind to enzymes, they undergo an enzyme-induced
chemical change, and are converted to products.
The substrate binds to the enzyme by interacting with amino acids in the binding site. The binding site on enzymes is often referred
to as the active site because it contains amino acids
that both bind the substrate and aid in its conversion to product.
 Compare the protein-ligand interaction to the enzyme-substrate interaction. Notice that
both binding proteins and enzymes have binding sites for their ligands (L) and
substrates (S), respectively. This area of the enzyme is called the active site
because it also contains amino acids that are important for the conversion of
substrate to product.
Compare the protein-ligand interaction to the enzyme-substrate interaction. Notice that
both binding proteins and enzymes have binding sites for their ligands (L) and
substrates (S), respectively. This area of the enzyme is called the active site
because it also contains amino acids that are important for the conversion of
substrate to product.
You can often recognize that a protein is an enzyme by its name. Many enzyme names end with
“-ase.” For example, the enzyme lactase is used to break down the sugar lactose, found
in mammalian milk. Other enzymes are known by a common name, such as pepsin, which is an
enzyme that aids in the digestion of proteins in your stomach by breaking the peptide
bonds in the proteins.
Enzymes are catalysts, meaning that they make a reaction go faster, but the
enzymes themselves are not altered by the overall reaction. Examine this image
to see how enzymes work.
 Simplified enzymatic reaction. The substrate reversibly binds to the active
site of the enzyme, forming the enzyme-substrate (ES) complex. The bound
substrate is converted to product by catalytic groups in the active site,
forming the enzyme-product complex (EP). The bound products are released,
returning the enzyme to its unbound form, ready to catalyze another round of
converting substrate to product.
Simplified enzymatic reaction. The substrate reversibly binds to the active
site of the enzyme, forming the enzyme-substrate (ES) complex. The bound
substrate is converted to product by catalytic groups in the active site,
forming the enzyme-product complex (EP). The bound products are released,
returning the enzyme to its unbound form, ready to catalyze another round of
converting substrate to product.
The amino acids in the active site of enzymes play two roles, and sometimes those roles
overlap. Some of the amino acids in the active site are responsible for binding of the
substrate and others are responsible for facilitating the chemical reaction. Enzymes are
generally quite specific for their substrates. Although lactase and pepsin both catalyze
the same type of reaction, breaking a bond using water (hydrolysis: "hydro" means
"water" and "lysis" means "to break"), lactase only functions when lactose is its
substrate and pepsin can only break peptide bonds.
Enzymes catalyze many different types of chemical reactions. Some of the
reactions are synthetic and result in products that are more complex than the
original substrates. This is often done by binding two substrates together.
Synthetic metabolic pathways like this are called anabolic pathways.
Other enzymes catalyze reactions that reduce the substrate to simpler products.
These enzymes catalyze reactions in catabolic pathways.
Example
An example of an enzyme that is involved in catabolism is lactase. Lactase is produced in the
intestinal tract of mammals and breaks the sugar in milk, lactose, down into the
monosaccharides glucose and galactose so that they can be metabolized to produce
energy.
 The enzyme lactase breaks lactose into the monosaccharides galactose and glucose by adding
a water molecule to the bond between the two sugars.
The enzyme lactase breaks lactose into the monosaccharides galactose and glucose by adding
a water molecule to the bond between the two sugars.Unfortunately, in many adults the ability to produce lactase is diminished. Without adequate
lactase, ingested lactose from milk and cheese is not broken down and absorbed in
the small intestine. Instead, the lactose goes to the large intestine, where it is
converted into large volumes of carbon dioxide (CO2) gas by the bacteria in the
large intestine. These individuals are lactose intolerant and should avoid eating
foods with high milk content.
In all chemical reactions, there is an initial input of energy that is required before the
reaction can occur. If this initial energy requirement (called the activation energy or
energy barrier) is small, then the reaction will happen quickly and easily. If the
activation energy is large, then the reaction will take longer to occur. Enzymes
function to reduce the activation energy required for a chemical reaction to occur.
First, the enzyme binds to the substrate and slightly distorts its shape. The change in
shape activates the substrate molecule and decreases the total activation energy
required for the substrate to be turned into product. As the number of activated
substrate molecules increases, so does the conversion of substrate to product. An
analogy for this effect is a ski hill, with skiers at the bottom of one side of the hill
representing substrates, skiers on the top of the hill representing activated
substrates, and the products being the number of skiers that ski down the other side. If
the height of the hill is lowered (due to the presence of the enzyme), then more skiers
can make it to the top, increasing the number that ski down to become products.
 A noncatalyzed reaction is shown on the left and an enzyme-catalyzed reaction is shown on
the right. The enzyme reduces the energy barrier required to activate the substrate,
allowing more substrates to become activated, which increases the rate of product
formation. Note that the energy difference between the substrate and the product is
not changed by the enzyme.
A noncatalyzed reaction is shown on the left and an enzyme-catalyzed reaction is shown on
the right. The enzyme reduces the energy barrier required to activate the substrate,
allowing more substrates to become activated, which increases the rate of product
formation. Note that the energy difference between the substrate and the product is
not changed by the enzyme.
The activity of an enzyme (its ability to convert substrate to product), depends
on a number of parameters that are listed below. Many of these parameters can
help control the activities of enzymes to optimize the utilization of cellular
resources.
-
Temperature: As the temperature increases, the kinetic energy of the substrate
molecules increases, allowing more substrate molecules to become activated and
increasing the reaction rate. This is equivalent to more skiers having the energy to
surmount the activation energy and reach the top of the hill. Many enzymes have
optimal activity at the temperature of the organism. However, there is a limit to how much you can increase the rate of the reaction by
changing the temperature. If the temperature is too high, the enzyme unfolds,
denatures, and becomes inactive.
-
pH: Protein structure can be affected by the pH of the solution surrounding it. If
a protein group that is important for substrate binding or catalysis can be
protonated or deprotonated, then changing the pH is likely to affect the enzyme
activity. Different enzymes are functional at different pH levels. Pepsin is a
digestive enzyme secreted by the stomach lining that is activated by the low pH in
the stomach. Salivary amylase, on the other hand, is denatured and nonfunctional in
the stomach environment.
-
Substrate concentration: As the substrate concentration increases, the
number of substrate molecules that bind to the enzyme also increases. This
leads to increased substrate activation.
-
Presence of inhibitors: Inhibitors can reduce the activity of enzymes through two
different mechanisms. Competitive inhibitors bind to the active site
and prevent the substrate from attaching to the binding site. Since less substrate
can bind to the enzyme, the activity is reduced. Noncompetitive
inhibitors (also called mixed-type) do not bind to the active site, but
bind elsewhere on the enzyme. However, the bound inhibitor changes the shape of the
active site, reducing the activity of the enzyme. Drugs to treat disease often
inhibit enzyme activity. For example, one of the drugs used to treat HIV is a
competitive inhibitor of a specific viral enzyme, while another anti-HIV drug is a
noncompetitive inhibitor of a different viral enzyme.
-
Presence of activators: Activators, like noncompetitive inhibitors, also change
the shape of the active site by binding elsewhere on the enzyme, but in this case
the enzyme is converted from an inactive form to an active form. In this way,
activators increase enzyme activity.
Lactase is an example of an enzyme that breaks large molecules down into smaller
ones. Lactase is produced in the intestinal tract of mammals and breaks the
sugar in milk, lactose, into the monosaccharides glucose and galactose. The
monosaccharides can then be metabolized to produce energy.
Lactase breaks lactose into galactose and glucose by adding a water molecule to
the bond between the two sugars. Without adequate lactase, ingested lactose from
milk and cheese is not broken down, and therefore cannot be absorbed in the
small intestine. Instead, the lactose goes to the large intestine, where it is
eaten by bacteria that live there. After metabolizing the lactose, the bacteria
produce large volumes of carbon dioxide (CO2) gas, which results in significant
discomfort for the individual lacking lactase.
Unfortunately, as many individuals age, their ability to produce lactase is
diminished. This is especially true for individuals from Asian, African, Native
American, or Mediterranean descent. The incidence of lactose intolerance is
lower for those of European descent. Approximately one in seven American adults
suffer from lactose intolerance, and African Americans can show signs of lactose
intolerance as early as two years of age.
These individuals are lactose intolerant and should avoid eating foods with high
lactose content, such as milk. Milk products, such as buttermilk, yogurt, and
cheese, cause less of a problem because the amount of lactose in these products
is reduced by the microorganisms that are used to make them. Lactose intolerant
individuals can consume milk under certain conditions.
In 1953, a group of scientists contributed to one of the most significant scientific
discoveries in history when they determined the structure of DNA, a nucleic acid that is
the hereditary material in a cell.
Nucleic acids are macromolecules that carry out two main functions in the cell: storage
of genetic information and synthesis of proteins. Two types of nucleic acids specialize
in these functions: deoxyribonucleic acid (DNA) and ribonucleic acid (RNA). DNA is the
genetic material that stores information for making proteins in all living organisms.
Some viruses store their genetic information in RNA instead of DNA. This may seem like
an exception to the universal use of DNA as genetic material; however, recall that
viruses are not
cellular, and are not considered living organisms.
A nucleic acid consists of a chain of nucleotides. There are different kinds of
nucleotides that can be linked to build the different nucleic acids. DNA is probably the
most familiar nucleic acid, but in this module, you will also learn about RNA. The
nucleotides that are used to build RNA molecules are different from the nucleotides that
are used to build DNA. You'll also take a look at a very special nucleotide — ATP, which
acts as the energy currency of the cell.
Nucleic Acid Building Blocks
Like any polymer, nucleic acids are made up of repeating subunits or
monomers. The subunits of nucleic acids are called
nucleotides. Each nucleotide contains three
building blocks: a phosphate, a sugar, and a
nitrogenous base. The nitrogenous
base is a type of organic molecule that consists of one or two ring structures.
Note that the term “base” is used here to refer to a specific part of the
nucleic acid structure; the meaning is very different from the use of the term
“base” in the discussion of pH and acid-base chemistry.
There are five different nitrogenous bases that can be found in various nucleotides. In DNA,
you will find these nitrogenous bases: adenine (A), guanine
(G), cytosine (C), and thymine (T). In RNA, thymine
is replaced by uracil (U).
Nucleotides can also differ in the type of sugar they contain. All sugars found in
nucleotides are pentose sugars, which means they have five carbons; however,
they can be different pentose sugars. For example, DNA contains the sugar
deoxyribose. RNA, on the other hand, contains ribose.
Finally, nucleotides can differ in the number of phosphate groups they contain. DNA and RNA
nucleotides contain just one phosphate. But a very common nucleotide used for
energy (adenosine triphosphate) contains three phosphates. We will look at this
molecule in greater detail in the Metabolism unit.
Nucleic Acid Polymers
Let’s examine the structure of a nucleic acid polymer. How are nucleotide building blocks
connected to each other? The alternating "phosphate - sugar - phosphate"
building blocks form a backbone of the linear polymer. Bases are attached to the
backbone via the sugars and are equivalent to the “side chains” of amino acids
in proteins.
 When nucleotides are linked end to end, they form a sugar-phosphate backbone. The
nitrogenous bases are attached to the backbone via the sugar.
When nucleotides are linked end to end, they form a sugar-phosphate backbone. The
nitrogenous bases are attached to the backbone via the sugar.
Just as with proteins, a DNA (or RNA) strand has directionality: one end is different than the
other. In the case of proteins, an amino group is found on one end and a
carboxylate group is found on the other end. Since it is the order of bases that
carries out the function of DNA (information storage), we often represent DNA as
just a sequence of bases (GAGGCT) and do not bother representing the backbone.
By convention, the first letter is the base at the 5’ (five prime) end of the
DNA strand. Thus, the sequence GAGGCT is shorthand for 5’-GAGGCT-3’. Determine
how this directionally occurs in DNA in the following learn by doing.
All DNA found in living organisms comes in sets of two polymers or strands, usually referred to
as double-stranded DNA. Some viruses are an exception to this rule and contain
single-stranded DNA as their genetic material. The discovery that DNA structure is a
double helix (two strands wound around each other) is considered one of the greatest
discoveries in science. Understanding of the structure of DNA opened up a whole new
realm of biological and biomedical research (molecular biology) and led to the
development of new technologies in science and medicine. Let’s examine the structure of
DNA using the activity below.
DNA structure is an antiparallel double helix: the two DNA strands run in opposite directions.
The sugar-phosphate backbone is on the outside, and the bases are on the inside of the
helix. The two strands are held together by base pairing: hydrogen bonding between
specific bases. Adenine (a purine) always pairs with thymine (a pyrimidine); guanine (a
purine) always pairs with cytosine (a pyrimidine). These base pairing rules (A-T, G-C)
are very important to the structure and function of DNA.
Two of the most important nucleic acids are DNA and RNA. DNA contains the instructions
for building proteins. RNA, on the other hand, is involved in actually building the
proteins. Because of these different functions, the structures of the two molecules are
very different.
Compare DNA and RNA and answer the questions about these structures.
In this module you learned that nucleotides are the monomers that make up the nucleic acid
polymers. Adenosine triphosphate (ATP) is a nucleotide. It consists of a single
adenosine (the base adenine and the sugar ribose), linked to three phosphate ions.
However, ATP has another essential function: it acts as a general energy source for most
cellular activities. You will learn in detail about ATP in the unit dedicated to
metabolism.
ATP is a relatively unstable molecule; consequently, it is never used for the long-term storage
of energy in the cell. This job goes to other more stable compounds, like fats and
sugars. However, ATP is specialized for direct and rapid transfers of energy. The bond
between the second and the third phosphates can be broken in a reaction producing ADP
(adenosine diphosphate). The energy released in this reaction can
be used for chemical reactions or cellular work. Conversely, if there is a surplus of
energy, specialized reactions can produce ATP from ADP and phosphate, storing the energy
temporarily before being used for other processes.
The ADP generated when energy is released is recycled back to ATP using energy gained from the
metabolic process. Large amounts of ATP are consumed while providing energy for
biological functions.
The cell is the first level of organization that exhibits all the
properties of life. Made up of biological macromolecules, the
cell’s unique structure enables it to carry out the functions of life.
In the "Biological
Macromolecules" unit, you explored matter and learned how
atoms can be combined to form molecules that, through their own unique structures, are
able to carry out specific functions. You learned that proteins,
such as enzymes, are able to function like little molecular
machines. However, enzymes and other biological macromolecules
made of matter do not possess the properties of life. In fact, it is only after we
combine these molecular building blocks to form a cell that we finally see the emergent
property of life. Take a moment to review examples of each level of organization forming
these building blocks using the activity below.
One of the hallmarks of living systems is the ability to maintain
homeostasis, or a relatively constant internal state. The
cell is the first level of complexity able to maintain homeostasis, and it is the unique
structure of the cell that enables this critical function.
In this unit, you will learn about the cell and all the parts that
make it functional. You will also focus on the cell membrane, which is the structure
that surrounds the cell and separates its internal environment from the external
environment. This separation enables the cell to maintain homeostasis and exhibit the
emergent property of life.
The microscopes we use today are far more advanced than those used in the 1600s by Antony van
Leeuwenhoek, a Dutch shopkeeper who had great skill in crafting lenses. Despite the
limitations of his now-ancient lenses, van Leeuwenhoek observed the movements of
bacteria, other single-celled organisms, and sperm. He labeled these moving microbes
“animalcules.”
In a 1665 publication called Micrographia, experimental scientist
Robert Hooke coined the term “cell” for the box-like structures he observed when viewing
cork tissue through a lens. Later, he confirmed van Leeuwenhoek’s 1678 discovery of
bacteria and protozoa. Later advances in lenses and microscope construction enabled
other scientists to see some components inside cells.
By the late 1830s, scientists had closely examined many plant and animal tissues under the
microscope. Comparing notes, botanist Matthias Schleiden and zoologist Theodor Schwann
realized that cells were found in every tissue they had studied. They proposed the Unified Cell Theory, which states that all living things are
composed of one or more cells, and that the cell is the basic unit of life. You, for
instance, are made of approximately 60 trillion cells, all of which originated from one
single cell, the fertilized cell produced when an egg from your mother was fertilized by
the sperm cell from your father.
However, there were still controversies between those who believed in the existence of a vital
force able to “create” life (spontaneous generation) and those who supported biogenesis,
which claims that living cells can arise only from pre-existing cells. A series of
experiments by Louis Pasteur and Rudolf Virchow showed that living organisms could only
come from other living organisms. The currently accepted tenets of Cell Theory are:
- All known living things are composed of one or more cells.
- All new cells are created by pre-existing cells dividing in two and reproducing.
- The cell is the most basic unit of structure and function in all living
organisms.
Modern cell theorists assert that all functions essential to life occur within the cell and
that during cell division the cell contains and transmits to the next generation the
information necessary to conduct and regulate cell functioning.
 Using special technology, biologists can capture images of living cells. The
yellow and blue fibers in these cells are made of proteins and the green circles in
the middle are nuclei (singular: nucleus), which hold the cell’s DNA. Image by:
Torsten Wittmann, NIGMS Image Gallery.
Using special technology, biologists can capture images of living cells. The
yellow and blue fibers in these cells are made of proteins and the green circles in
the middle are nuclei (singular: nucleus), which hold the cell’s DNA. Image by:
Torsten Wittmann, NIGMS Image Gallery.
In spite of the fact that all cells share certain characteristics, there is incredible
diversity in structure and function among different cells. The human body alone contains
trillions of cells of more than 200 different types, each with a unique structure and
function. Cells are categorized into two types: Prokaryotes are
small, simple, single-cell organisms; bacteria are the most prevalent kind.
Eukaryotes are larger, and most often they are
multicellular organisms, including plants, animals, and fungi. Eukaryotic cells are
about 15 times wider than the typical prokaryotic cell, and up to 1,000 times greater in
volume. The images below show examples of a prokaryote and single-celled eukaryotic
organisms.
Prokaryotic MRSA Bacteria Cells
 Methicillin-resistant Staphylococcus aureus (commonly known as MRSA) is an
antibiotic-resistant of bacteria, shown here in yellow. These bacteria are
being ingested by a white blood cell, shown here in purplish blue. Source:
National Institute of Allergy and Infectious Diseases /National Institutes
of Health (NIAID/NIH) Methicillin-resistant Staphylococcus aureus (commonly known as MRSA) is an
antibiotic-resistant of bacteria, shown here in yellow. These bacteria are
being ingested by a white blood cell, shown here in purplish blue. Source:
National Institute of Allergy and Infectious Diseases /National Institutes
of Health (NIAID/NIH)
|
Eukaryotic Single-Celled Organisms
 These two cells are both single-celled organisms, also known as protists. The Didinium
(bottom right) is stalking the Paramecium (top left), and will eventually
catch and eat the larger cell. Image by: Gregory Antipa (San Francisco State
University). These two cells are both single-celled organisms, also known as protists. The Didinium
(bottom right) is stalking the Paramecium (top left), and will eventually
catch and eat the larger cell. Image by: Gregory Antipa (San Francisco State
University).
|
You have already learned that cells are made up of organelles, molecules, atoms, and subatomic
particles. These parts assemble into various structures to perform specific functions
within the cell. Organelles are specialized structures formed when
a specific set of molecules bonds, providing a subunit within a membrane-like enclosure
that performs particular functions within the cell. Some structures are the same for
both prokaryotic and eukaryotic cell types
and some structures are different. The remainder of this page will focus on a handful of
structures that all cells have in common. Then, later in this module, you will learn
about the structures and characteristics of each cell type in more detail.
Structures Common to All Cells
There are several parts (referred to as structures) common to all
cells regardless of the cell type. All cells are surrounded by a cell membrane.
The cell membrane provides a barrier between the interior
and exterior of the cell and it regulates the flow of substances in and out of
the cell. All cells also have cytoplasm, which is the
fluid that occupies the space inside the cell. Cytoplasm is the space in which
the chemical reactions that enable life take place. All cells also contain
DNA, which is often called the “master molecule”
of the cell because it contains the instructions for synthesizing all of the
cell’s proteins. As you already know, proteins are the raw
materials used to build many important structures in living systems. Finally,
both prokaryotes and eukaryotes contain ribosomes.
Ribosomes are the molecular machines that use the instructions contained in the
DNA to build all the proteins needed by the cell.
The following table summarizes the major structures found in cells and the primary function
of each structure. In addition, it lists the types of cells in which each
structure is found. (There are many other important structures and features of
cells. The table below shows only the most important structures.)
The Most Important Structures Found in Prokaryotic and Eukaryotic Cells
 By University of Maryland University College CC-BY-NC
By University of Maryland University College CC-BY-NC
The essential differences and similarities among prokaryotic and eukaryotic cells
are:
- All cells contain DNA (chromosomes), membranes, cytoplasm, and
ribosomes.
- Prokaryotes do NOT contain a nucleus or any other organelle.
- Chloroplasts exist only in eukaryotic plant cells.
Check your understanding of cell structures with the following activity and then learn more
about the structures and characteristics of each cell type on the next page.
Every cell on Earth belongs to one of two categories:
-
Prokaryotic cells
-
Eukaryotic cells
Prokaryotic cells were the first cells to appear on our planet. All prokaryotes alive today
are unicellular (one-celled), and include bacteria (singular form is "bacterium") and
archaea (singular form is "archaean"). Prokaryotes are small cells that don't have a
nucleus or membrane-bound organelles.
Eukaryotic cells appeared 1.5 billion years after prokaryotes. The main difference between
the two is that eukaryotes have a central control structure, called the
nucleus (plural form is "nuclei"), where DNA is housed. In prokaryotes,
the main DNA molecule (bacterial chromosome) is present in a region called the
nucleoid, but the nucleoid lacks a surrounding membrane. Smaller DNA
molecules called plasmids can be also found in prokaryotes. Prokaryotic DNA
is circular, in contrast to the linear structure of eukaryotic DNA.
Both eukaryotic and prokaryotic cells have a cell or plasma membrane, which
surrounds and defines the inner environment of the cell. The cell membrane is made of a
phospholipid bilayer containing a variety of proteins and additional components. The
cell membrane is responsible for mediating interactions between the cell and its
environment. The Cell Membrane module contains a more detailed discussion of the
structure and function of the cell membrane.
Typical Animal Cell (Eukaryotic)

|
Bacteria Cell (Prokaryotic)
 Note: these images are not drawn to scale. A typical eukaryotic cell is 10 times
bigger than the typical prokaryotic cell. Note: these images are not drawn to scale. A typical eukaryotic cell is 10 times
bigger than the typical prokaryotic cell.
|
Prokaryotic cells have a simpler structure than eukaryotic cells, and they range in diameter
from 0.1 to 5.0 µm (micrometers). Most prokaryotes have a protective layer called the
cell wall that is made of peptidoglycan, which is a
combination of polysaccharides and amino acids. Prokaryotes also have a cell membrane
and cytoplasm. Many prokaryotes also have external appendages such as a flagellum. The cytoplasm contains the DNA and the ribosomes, where protein synthesis takes place. Several types of RNA are
involved in the process of protein synthesis, and ribosomal RNA (rRNA) is the main
component of ribosomes. Both prokaryotes and eukaryotes have ribosomes, but they are
different. Prokaryotic ribosomes are smaller and lighter than their eukaryotic
counterparts.
Comparison of cell sizes
 Relative sizes of cells and their contents. Notice that the scale shown
is logarithmic.
Relative sizes of cells and their contents. Notice that the scale shown
is logarithmic.
Note that certain abiotic entities such as viruses and prions
(infectious proteins causing diseases such as mad cow disease) are also studied in
biology. However, they are not cells, and while they may exhibit
certain characteristics of life, they do so only in certain conditions.
All eukaryotes contain a nucleus. Animals and plants are familiar
eukaryotes; in fact, all large complex organisms are eukaryotes.
Fungi (the singular form is "fungus"), which include molds and
mushrooms, are also eukaryotes. There are even single-celled eukaryotes, called
protists. All eukaryotes have a nucleus, but they can also
have other cell structures in common.
One simplified but useful analogy of a cell is that of a factory. Just as in a factory,
cells have a wall or membrane providing a protective enclosure, a planning center where
the product blueprints are stored, a source of energy, an assembly line for production,
packaging and shipping facilities, storage facilities, etc.
The Plant Cell as a Factory
 In this visual, a plant cell is compared to a factory. Each functional unit of
the factory is compared to a cellular organelle. Even though cells can have many
different functions, the function often relies on the production of different types
of proteins. In this way, a cell is like a protein-producing factory. We will refer
back to this analogy as we discuss the functions of different cellular organelles.
In this visual, a plant cell is compared to a factory. Each functional unit of
the factory is compared to a cellular organelle. Even though cells can have many
different functions, the function often relies on the production of different types
of proteins. In this way, a cell is like a protein-producing factory. We will refer
back to this analogy as we discuss the functions of different cellular organelles.
Organelles
Eukaryotic cells contain compartments with specialized functions called
organelles. Organelles are surrounded by membranes.
Organelles are similar to the specialized work areas in the factory above.
Because a cell is a protein-producing factory, we can take a closer look at the
different organelles and see how they function toward this goal.
Nucleus: Control Center

|
The nucleus is the control center of the cell and
it stores the DNA, which contains the instructions
for how to build all the protein products required by the cell. The
nucleus is like the factory command center, which stores the
instructions needed to build its product. A single molecule of DNA is
called a chromosome. The chromosomes are like the
different books in the factory’s control center.
The nucleus is surrounded by a double-layered membrane called the
nuclear envelope. The nuclear envelope is
studded with pores that allow information from inside the nucleus to
enter the cytoplasm. You can imagine that a
factory command center would not be very effective if it did not have
doors or windows through which to pass information to the rest of the
factory.
|
Ribosome: Protein Production

|
There are several important structures found within the nucleus. The most
visible of these is the nucleolus. In contrast to
other organelles, the nucleolus is not bound by a membrane. Instead, it
is an aggregate of molecules where ribosomes,
another type of nonmembranous organelle, are assembled.
Most organelles, including ribosomes (after they
are built in the nucleus), are found in the
cytoplasm, which is the substance found
between the nucleus and the cell membrane (number eight in the cell
factory diagram). The cytoplasm is analogous to the factory floor, where
all the work takes place.
|
Mitochondria: Power Plant

|
All this work requires energy. Most factories need some sort of power
plant that converts fuel into a form of energy that can be captured to
do work. In the cell, this job is accomplished by organelles called
mitochondria (singular form is
"mitochondrion"), which take fuel in the
form of sugar (glucose) and convert it to usable energy —
ATP.
|
Chloroplasts: Sugar Production

|
Plant cells have an additional type of organelle —
chloroplasts, which exist only in plant
cells — involved in energy transfer. The chloroplasts provide sugar.
Chloroplasts capture energy from the sun and use that energy to build
sugar molecules. Mitochondria then harvest the
energy stored in the sugar molecules and use it to do work. The
chloroplasts and mitochondria are the organelles responsible for
providing energy for all cellular functions.
|
Endoplasmic Reticulum: Product Assembly

|
Factories often have assembly lines that put together the company’s
product. In the cell, proteins and other cellular
components are put together, or assembled, by the endoplasmic
reticulum (ER), a series of sacs and tubes. In
eukaryotes, ribosomes are associated with the
"rough ER," which gets its name from the beaded appearance that the
ribosomes give it. The smooth ER (without ribosomes) can have different
functions depending on the cell type, but it is often the site for the
synthesis of lipids.
|
Vacuoles: Storage

|
The Golgi apparatus is the packaging and shipping
center of the cell, where the proteins that were built by the
ER assembly line are delivered to
different parts of the cell, or in multicellular organisms, to different
parts of the body. Often the Golgi apparatus packages proteins in
vesicles and
vacuoles, which are membrane-bound sacs that
function in storage and transport. Vesicles are specialized for
transport and some other functions. Their membranes can fuse with the
plasma membrane, allowing them to empty their contents into the
extracellular space. Vesicles also may fuse with the membranes of the
endoplasmic reticulum and Golgi apparatus, allowing them to empty their
contents into those organelles. Lysosomes are
specialized vesicles found only in animal cells. Lysosomes contain
powerful digestive enzymes that can recycle cellular parts or destroy
external invaders. Vacuoles are specialized mainly for storage. Their
membranes do not fuse with the membranes of other cellular
components.
|
Other Structures in Eukaryotes
Eukaryotic cells include other important structures not illustrated in our
factory diagram; they are the cytoskeleton, actin, centrioles, microtubules,
flagellum, and cilia.
The cytoskeleton is formed by a series of protein
filaments, and is both a scaffold for the cell structure and a framework for
many cellular activities, including movement and cell division. In our factory
analogy, the cytoskeleton is represented by structural beams, as well as any
transport infrastructure, like hallways, elevator tracks, or even small
railroads. In the cell, the cytoskeleton is made up of many different protein
filaments. One important filament is actin, which has a
prominent role in cell movement, maintaining cell shape, and connection to other
cells, as well as intracellular transport. A barrel-shaped structure only
present in animal cells is the centriole, which plays a
role in the spatial organization of the cell and cell division. Centrioles are
formed by microtubules, another filament type of the
cytoskeleton. Microtubules also form appendages such as the
flagellum of the sperm cell and the
cilia of the cells of the respiratory system.
Both animal and plant cells are eukaryotic cells. However, they both contain some specialized
structures. Plants have chloroplasts and a rigid cell
wall. Chloroplasts are unique organelles able to harvest solar
energy to make sugars from carbon dioxide. This process, called photosynthesis, is the
basis of life as we know it on our planet. This process is possible due to the presence
of special pigments, called chlorophylls, which are found in the chloroplasts.
The cell wall is a porous structure that protects, supports, and gives
shape to the cell. The plant cell wall is different from that of prokaryotes, and it is
mainly formed by polysaccharides, particularly cellulose. Plant
cells can also have a central vacuole, which can be a place of
storage, degradation, defense, and even physical support for the cell. Even though
plants have a cell wall, this does not mean they don’t have a cell membrane. All cells
have a cell membrane. Some, like plant cells, just have a cell
wall as well.
Eukaryotic Plant Cell
 A typical eukaryotic plant cell. Compare this to the image of the animal cell. Notice
that each plant cell has a cell wall, chloroplasts, and a central vacuole, but lacks
cilia, lysosomes, and a centrosome.
A typical eukaryotic plant cell. Compare this to the image of the animal cell. Notice
that each plant cell has a cell wall, chloroplasts, and a central vacuole, but lacks
cilia, lysosomes, and a centrosome.
Eukaryotic Animal Cell
 A typical eukaryotic animal cell. No cell looks exactly like this one, but this figure
orients you to the organelles and other components discussed. Cilia are not present
in all animal cells, but are in some.
A typical eukaryotic animal cell. No cell looks exactly like this one, but this figure
orients you to the organelles and other components discussed. Cilia are not present
in all animal cells, but are in some.
The structures shown above are parts of a “generic” eukaryotic cell. While most eukaryotic
cells will present these structures, variations occur depending on the function of the
cell. Think about cars — while most cars have the same parts, there will be differences
between a sedan and an off-road vehicle. Among animal cells, extreme examples of
specialization include red blood cells (containers of hemoglobin to transport oxygen;
see picture on the left) and nerve cells (dedicated to transmission and integration of
signals; picture on the right).
Blood Cells
 Human red blood cell, platelet, and white blood cell. Observe the flattened disk shape
of the red blood cell, which allows it to easily pass through small blood
vessels. Human red blood cell, platelet, and white blood cell. Observe the flattened disk shape
of the red blood cell, which allows it to easily pass through small blood
vessels.
|
Nerve Cell
 Mouse neurons (nerve cells). Observe the many projections connecting
cells with each other, allowing communication and transmission of
signals. Mouse neurons (nerve cells). Observe the many projections connecting
cells with each other, allowing communication and transmission of
signals.
|
Bacteria
Until the late 1600s, only large life forms such as plants and animals were known to science.
Humans were completely ignorant of the teeming masses of microscopic life forms
that inhabit our world. In fact, they didn’t even know that plants and animals
are composed of cells.
The invention and refinement of the microscope changed all that. Today we are aware of a vast
diversity of single-celled, microscopic life forms that interact with us every
day. In fact, in and on your body, bacterial cells outnumber your own human
cells 10 to one. The bacteria that live on and in you are often critically
important to your own health and well being. Bacteria have mutually beneficial
relationships with every large organism on Earth and they also cleanse the water
we drink and renew the air we breathe. While bacteria can be invaluable partners
in the quest for healthy living, it is also well known that bacteria cause
disease. Interestingly, this fact was not fully demonstrated until the late
1800s. The earliest measures taken to control bacterial diseases involved
improving sanitation using procedures such as sterile surgical techniques, water
purification, and sewage treatment. While these strategies helped reduce
infections caused by bacteria, it didn’t change the fact that once bacterial
infections took hold, they were often fatal.
E. coli Under a Microscope
 These Escherichia coli (E. coli) are seen under a light
microscope at a magnification of 1,000x (at this level, a grain of rice
would appear to be the size of a bus). Microscopic organisms such as E. coli are essential for keeping us healthy. E. coli and other microbes living in our gut help
with proper digestive health. Although some E. coli
can be harmful, most are not.
These Escherichia coli (E. coli) are seen under a light
microscope at a magnification of 1,000x (at this level, a grain of rice
would appear to be the size of a bus). Microscopic organisms such as E. coli are essential for keeping us healthy. E. coli and other microbes living in our gut help
with proper digestive health. Although some E. coli
can be harmful, most are not.
Antibiotics
In 1928, Alexander Fleming serendipitously discovered the first antibiotic, Penicillin.
Fleming was studying bacteria in his lab and was growing different cultures on
Petri dishes. He wasn’t very tidy and had accidentally forgotten to clean some
Petri dishes before leaving his lab for a monthlong vacation. When Fleming
returned to the lab, he noticed that a mold had grown on one of the plates.
Looking closely, Fleming saw that his bacteria had not grown well in a zone
surrounding the moldy spots. Following up on a hunch, he deliberately added mold
to some Petri dishes seeded with bacteria and found that all bacteria were
killed near the mold colonies. By the mid-1940s, just in time to help wounded
soldiers in World War II, scientists were able to mass-produce a drug derived
from the mold discovered by Fleming.
Testing Antibiotics
 Examine this image of a petri dish filled with a light-colored bacterial culture. Each
black dot is a spot of antibiotic. Notice the area surrounding the
antibiotic in which the bacteria are unable to grow.
Examine this image of a petri dish filled with a light-colored bacterial culture. Each
black dot is a spot of antibiotic. Notice the area surrounding the
antibiotic in which the bacteria are unable to grow.
Fleming had discovered the first antibiotic. Antibiotics are
substances that are produced by one type of organism (usually bacteria or mold)
and used to kill or suppress other organisms (usually bacteria). Antibiotics
have a very specific way of working, which is called their “mode of action.”
Penicillin works by interfering with cell wall construction in bacterial cells.
The cell wall is a somewhat rigid “shell” that encloses a bacterial cell. In the
presence of penicillin, a bacterium’s cell wall cannot be built (or rebuilt) and
the cell wall eventually collapses, killing the cell. Cell walls are not present
around human cells, or those of any other animal. Therefore, penicillin does not
harm our cells — only those of bacteria. This is a general feature of
antibiotics. When taken in prescribed doses, antibiotics are usually harmless to
humans.
During and just after World War II, penicillin was touted as a wonder drug, and
many believed the battle against pathogenic (harmful) bacteria would be won in a
matter of years. However, the initial success of this antibiotic was relatively
short-lived, as bacteria began to evolve resistance to the drug. In any group of
bacteria, individuals can have variations in their genetic makeup that help them
survive in the presence of specific antibiotic compounds. Over time, if the
antibiotic is used, vulnerable types of bacteria die out and the “resistant”
types of bacteria reproduce much better than average. Eventually most or all
bacteria in the environment are resistant, making the antibiotic useless.
Antibiotic Resistance
 A poster produced by the Chicago Department of Health warning about
antibiotic resistant gonorrhea. Chicago, Il
A poster produced by the Chicago Department of Health warning about
antibiotic resistant gonorrhea. Chicago, Il
Presently, we are facing a growing threat to human health; the overuse and misuse of
antibiotics has led to the evolution of “superbugs” — bacterial strains that are
resistant to many different types of antibiotics. Such infections are very hard
to treat, and can be deadly. Perhaps you have heard about methycillin-resistant
Staphylococcus aureus (MRSA), which can be picked up
in hospitals and places of close body contact (locker rooms, retirement homes).
It has evolved a resistance to the antibiotic methycillin. If it penetrates the
body, it may dissolve the skin and underlying muscle.
One way to reduce the development of antibiotic resistance is to use antibiotics
only when necessary, so that there are many antibiotic-free people and places in
the environment. This makes it easier for vulnerable strains of bacteria to
reproduce, and keeps these strains more common. Within a sick patient, however,
the goal of antibiotic therapy is to keep reducing the numbers of harmful
bacteria until your immune system can kill off the last (and probably most
resistant) holdouts. Therefore it is important to take antibiotics at full
dosage and to complete the round of treatment as directed, continuing until it
is certain that your bacterial foes have been eliminated.
We are not helpless against the rising tide of antibiotic resistance. Today, with our great
knowledge of microscopic life and nonliving — but equally dangerous — viruses,
we have an unprecedented ability to understand and address health
challenges.
Plasma Membrane
The cell membrane, also called the plasma membrane, is the boundary of the cell; it
determines what enters and exits the cell, and it is how the cell interacts with
its environment. Have you ever looked closely at the colors swirling in a soap
bubble? This may give you a feel for the fluid nature of a cell's membrane. A
membrane's components are in constant motion, as if they were flowing in a
river. A variety of different proteins, carbohydrates, sterols, and other
molecules are embedded in the phospholipid bilayer. This
gives the impression of a tile mosaic, which has variously shaped and colored
tiles embedded in grout. Because of its fluidity and its variety, biologists
currently describe the cell membrane as a fluid mosaic.
The phospholipid bilayer is the main fabric of the membrane. The
bilayer's structure causes the membrane to be semipermeable. The hydrophobic
core blocks the diffusion of hydrophilic ions and
polar molecules. Small
hydrophobic molecules and gases, which can
dissolve in the membrane's core, cross it with ease.
Other molecules require proteins to transport them across
the membrane. Proteins determine most of the membrane's
specific functions. The plasma membrane and the membranes
of the various organelles each have unique collections of proteins. For example,
to date more than 50 kinds of proteins have been found in the plasma membrane of
red blood cells.
Importance of Phospholipid Membrane Structure
What is important about the structure of a phospholipid membrane? First, it is
fluid. This allows cells to change shape, permitting growth and movement. The
fluidity of the membrane is regulated by the types of phospholipids and the
presence of cholesterol. Second, the phospholipid membrane is selectively
permeable.
The ability of a molecule to pass through the membrane depends on its
polarity and to some extent its size. Many nonpolar
molecules such as oxygen, carbon dioxide, and small hydrocarbons
can flow easily through cell membranes. This feature of membranes is very
important because hemoglobin, the protein that carries oxygen in your blood, is
contained within red blood cells. Oxygen must be able to freely cross the
membrane so that hemoglobin can get fully loaded with oxygen in your lungs, and
deliver it effectively to your tissues. Most polar substances are stopped by a
cell membrane, except perhaps for small polar compounds
like one-carbon alcohol, methanol, and water. Glucose is too large to pass
through the membrane unassisted and a special transporter protein ferries it
across. Certain types of diabetes are caused by misregulation of the glucose
transporter. Charged ions, such as sodium (Na+) or
potassium (K+) ions seldom go through a membrane; consequently, they also need
special transporter molecules to pass through the membrane. The inability of Na+
and K+ to pass through the membrane allows the cell to regulate the
concentrations of these ions on the inside or outside of the cell. The
conduction of electrical signals in your nerves is based on the ability of cells
to control Na+ and K+ levels.
Selectively permeable membranes allow cells to keep the chemistry of the
cytoplasm different from that of the external environment. It also allows them
to maintain chemically unique conditions inside their organelles.
The cell membrane must be a dynamic structure if the cell is to grow and respond to
environmental changes. The fluidity of the membrane is demonstrated in the following
animation.
Click the green arrow to play the animation.
Maintaining Proper Fluidity of the Membrane
To keep their membranes fluid across a range of temperatures, cells alter the composition of
their membranes. Phospholipids with differing fatty acid
tails have different levels of mobility in the membrane. The right ratio of
saturated to unsaturated fatty
acids keeps the membrane fluid at any temperature conducive
to life. For example, winter wheat responds to decreasing temperatures by
increasing the amount of unsaturated fatty acids in cell membranes. The
unsaturated fatty acid tails keep membranes fluid because they are kinked and
resistant to packing. In animal cells, the membrane is made up of mostly
saturated fatty acids, so it is relatively stable (not too fluid).
Cholesterol plays a key role in keeping animal
cell membranes fluid across a range of temperatures. At high temperatures,
cholesterol molecules interfere with phospholipid movement and reduce membrane
fluidity. At low temperatures, cholesterol keeps the saturated fatty acid tails
from packing and maintains adequate fluidity. Other
sterols play a similar role in the cell membranes of
plants, fungi, and even some prokaryotes. Fungi, for example, use ergosterol.
Structure of Cholesterol

|
Cholesterol in the membrane maintains the correct
fluidity.
|
The cellular or plasma membrane is a lipid bilayer composed of
phospholipids and associated
proteins, specialized lipids, and
carbohydrates. The composition of the plasma membrane
varies according to the type and function of the cell.
Components of the Membrane
 The plasma membrane is a complex structure containing many different
macromolecules. Wikicommons
The plasma membrane is a complex structure containing many different
macromolecules. Wikicommons
Sterols
Sterols are used by some cells to maintain proper membrane fluidity.
Carbohydrates
The extracellular surface of the cell membrane is decorated with carbohydrate groups attached
to lipids and proteins. These short carbohydrates play a role in giving a cell
its identity (i.e., distinguishing self from nonself) and are the distinguishing
factor in human blood types.
Proteins
Membranes also contain proteins, which carry out many of the functions of the
membrane. Some functions of membrane proteins are:
-
Transport. Because the plasma membrane is only semipermeable, the
cell needs a way to transport larger materials into and out of the
cell.
-
Communication. Because the plasma membrane is the border of the
cell, this is where the cell communicates with its environment. Membrane
proteins are able to receive signals from outside the cell and begin a chain
of events that cause the cell to respond to these signals.
-
Metabolism. Membrane proteins can be enzymes that are involved in
the chemical reactions of metabolism. These are the processes that allow the
cell to grow, obtain energy, and eliminate wastes.
-
Adhesion. Membrane proteins help cells bind to each other and form tissues. One
example of this is skin cells, which must form a tight surface if the skin
is to maintain proper integrity. Membrane proteins also bind to molecules
inside and outside the cell, which helps the cell maintain its
structure.
In order to carry out their functions, some proteins need to be embedded in the membrane.
These proteins are called integral proteins (“integral” because they are “integrated”
into the membrane). For example, a membrane protein that transports materials into or
out of the cell needs to completely span the membrane. On the other hand, a protein that
binds the cell to another can simply be attached to the outer surface of the membrane.
Proteins that are attached to the inner or outer surface of a membrane are called
peripheral proteins.
Membrane Proteins

Prokaryotes are an enormously diverse group of organisms. However,
they can be organized into two primary groups: bacteria and
archaea. While both bacteria and archaea are prokaryotes
(both groups lack nuclei), the archaeans have some interesting structural
characteristics in the cell membrane that have unique functional significance.
The cell membranes found in both eukaryotic and bacterial cells consist
of a phospholipid bilayer that separates the internal environment
of the cell from its external environment and regulates the materials that pass in and
out of the cell. This enables the cell to maintain internal
homeostasis, regardless of changing external conditions. You
already know that cell membranes can be structurally different, to enable different
functions. For example, some bacteria live in the frozen Arctic Circle. They are able to
maintain membrane fluidity because of an increased concentration of unsaturated fatty
acid tails found within the membrane phospholipids.
The Archaean Cell Membrane
Archaeans are often found living in extreme environments such as high temperature, pH, or
salinity, and as such, are often called “extremophiles” (loving extreme
conditions). How can their cell membranes stay intact in such conditions? The
cell membrane must have a unique structure to withstand these conditions.
Grand Prismatic Spring, Yellowstone National Park
 Archaea were first found in extreme environments, such as volcanic hot springs like
Grand Prismatic Spring, Hot Springs, Midway and Lower Geyser Basin,
Yellowstone National Park. The picture on the right shows an aerial view of
the spring. Photo by Jim Peaco, National Park Service, July, 2001, Public Domain.
Archaea were first found in extreme environments, such as volcanic hot springs like
Grand Prismatic Spring, Hot Springs, Midway and Lower Geyser Basin,
Yellowstone National Park. The picture on the right shows an aerial view of
the spring. Photo by Jim Peaco, National Park Service, July, 2001, Public Domain.
You will explore characteristics of the archaean cell membrane in the following activities.
First, you need to orient yourself to the phospholipid found in a bacterial
cell. You might want to review the structure of phospholipids.
You figured out that the structure of the archaean phospholipid is significantly
different from the structure of the bacterial phospholipid. These structural differences
lead to functional differences that enable archaeans to survive in extreme environments.
This is an excellent example of how structure determines function at the cellular level
of organization.
How Molecules Enter and Exit Cells
The cell membrane determines what enters and exits the cell, and it is
how the cell interacts with its environment. As you have already learned, the
cell membrane is a phospholipid bilayer structure that
provides a semipermeable barrier between the inside and the outside of the cell.
In this module, you will explore the following three ways molecular substances
enter and exit the cell:
- Molecules can pass across the membrane (diffusion and active
transport).
- Molecules can be transported into the cell without passing across the
membrane (endocytosis).
- Molecules can send signals for actions within the cell without actually
passing across the membrane themselves (signal transduction).
This module will discuss how the cell membrane controls the transport of nutrients, ions and
signals between the highly variable outside environment and the relatively
well-defined interior of the cell.
Passive/Simple Diffusion
Molecular substances enter and exit the cell so that: nutrients and waste can be exchanged;
the cell can perform its function; and, when required, the cell can send
appropriate signals to other cells. Transporting some substances may require the
cell to exert energy and other molecules may cross through
the membrane passively, requiring no use of energy by the cell. One way
molecules passively move through the cell membrane is a process called simple
diffusion.
In simple diffusion, both large and small molecules spontaneously move
from areas of high concentration to areas of low concentration following random
movements, referred to as Brownian motion. The classic example is the diffusion
of a drop of ink placed in a beaker of water. The concentrated drop of color
slowly disperses (diffuses) until at some point equilibrium is reached and the
water in the beaker appears to have a uniform color. The following animation
depicts this simple diffusion process. Add ink to the beaker and watch the
diffusion process. After a period of time, how has the distribution of the ink
changed in the beaker? Follow the yellow ink for some time. Does its behavior
change as time passes?
The cell membrane provides a semipermeable barrier between the
inside and the outside of the cell. The phospholipid bilayer
structure of the membrane allows selected ions and
organic molecules to pass through the plasma membrane and
regulates the movement of molecular substances. This characteristic of the membrane,
known as selective permeability, acts as a filter that allows only
selected substances that are needed for the survival and functioning of the cell in and
out. The movement of molecular substances across the membrane can occur passively
without the cell exerting energy or it can occur through the cell's use of energy to
transport substances. Selective permeability affects the energy required to transport
substances in and out of the cell. This page will explore the conditions under which
molecules can pass across the membrane passively through diffusion.
Diffusion Across the Membrane
Molecules can be divided into four categories with regard to their ability to
cross the plasma membrane. The first category is
nonpolar molecules. These hydrophobic
molecules can easily cross the membrane because they
interact favorably with the nonpolar lipids. Note that these molecules can
accumulate in the membrane because they interact so well with the
lipids. The second category is small
polar molecules. Although they don’t interact with the
lipids, their small size allows them to pass through small temporary holes in
the membrane. The third category is large polar molecules.
These have difficulty crossing the membrane because of their size and poor
interaction with the lipids. The last category is ionic
compounds. Their charge interacts very unfavorably with the
lipids, making it very difficult for them to cross the membrane.
The size, polarity, and charge of a substance will determine whether or not the substance
can cross the cell membrane by diffusion. The cholesterol was an example of a lipid, and
is highly soluble in the nonpolar environment of the lipid bilayer. You saw, in the
animation above, the cholesterol freely passing into the hydrophobic environment of the
membrane. Cholesterol distributes freely in the membrane and then some fraction will
dissolve in the aqueous environment of the cytoplasm. Water, on the other hand, while
polar, is small enough to cross the membrane at a slow rate. Note that specialized
transport proteins in certain cell membranes can provide a channel for the water,
greatly increasing its rate of crossing the membrane. The lipid bilayer is much less
permeable to the ion, because of its charge and larger size. As a general rule, charged
molecules are much less permeable to the lipid bilayer.
Cells must be able to move large polar and charged
molecules across the lipid bilayer of the membrane in order to carry
out life processes. To allow these molecules, which are not soluble in the
lipid bilayer, to pass across the
hydrophobic barrier, it is necessary to provide ports,
channels, or holes through the membrane. The molecules will still move spontaneously
down a concentration gradient from high to low concentration. These channels can either
remain open at all times, allowing the molecules to move freely according to the
concentration gradient, or they can be gated channels that open and close in response to
the needs of the cell. In most cases these channels are very discriminatory and will
only allow specific molecules to pass. The process of moving impermeable molecules
across a membrane (down their concentration gradients) using channels or pores is
referred to as facilitated diffusion. Because the molecules are
moving down a concentration gradient, the process is driven by simple
diffusion and does not require the input of additional energy from
the cell. The following simulation depicts the facilitated diffusion of glucose across
the membrane using the glucose permease transporter.
In some cases it is necessary to move molecules against their concentration gradient. The
eukaryotic cell has many compartments within it, each
surrounded by a membrane. In most cases, the environment within the compartment is
different from the environment in the cytoplasm. An example is the
lysosome, an organelle whose
function is to digest macromolecules delivered either from outside
the cell or from other compartments within the cell. To carry out this function, the
lysosome maintains a very low internal pH compared to that of the
cytoplasm. Thus, there is a steep pH gradient across the lysosome's membrane. This
contrasts with the equilibrium state, in which the concentration of hydrogen
ions would be the same inside and outside the lysosome.
To decrease the pH inside the lysosome, the concentration of protons will need to be greater
inside the lysosome than in the cytoplasm. To accomplish this,
protons will need to move from a low concentration to a high
concentration. This is a nonspontaneous process and requires the cell to do work to move
the ions "uphill" against the concentration gradient. To do work, the cell must expend
energy and actively move (pump) the ions. This process is referred to as
active transport. The source of energy for this process in
most biological systems is the hydrolysis of ATP.
The animation that follows illustrates an example of an active
transporter that uses energy from the molecule ATP
to transport sodium (Na+) ions out of the cell and potassium (K+) ions into the cell.
Both ions are moved against their concentration gradients. The
main stages of the process are:
- Three Na+ ions from inside the cell bind to the transporter.
- A molecule of ATP binds to the transporter, providing the energy needed to change
the shape of the transporter. This allows the Na+ to cross the membrane and exit the
cell, against its concentration gradient.
- Two K+ ions from outside the cell bind to the transporter.
- The transporter changes shape again, bringing the K+ into the cell.
Observe the active transport of sodium and potassium molecules using ATP.
Transport Proteins
Facilitated diffusion and active
transport both require transport proteins
that act as channels or ports in the membrane. Transport proteins are classified
both by structure and by function. The structure (shape) of each channel helps
determine what materials can pass through. Even within classes of transport
proteins that carry out similar functions (e.g. ion channels) there are many
different structures that can discriminate between specific substances. Dozens
of different transporters swirl around within the fluid membranes that enclose
your cells and organelles, contributing greatly to their "mosaic" quality.
Molecules can also be moved across the membrane in bulk. Additionally, larger
items (such as entire cells) can also be taken into a given cell. These
processes are types of endocytosis and
exoctyosis and will be discussed next.
Facilitated diffusion and active transport are not the only ways that materials can enter or
leave cells. Through the processes of endocytosis and
exocytosis, materials can be taken up or ejected in bulk, without
passing through the cell's plasma membrane.
In endocytosis, material is engulfed within an infolding of the plasma membrane
and then brought into the cell within a cytoplasmic vesicle. To begin endocytosis, a
particle encounters the cell surface and produces a dimple or pit in the membrane. The
pit deepens, invaginates further, and finally pinches off to form a vesicle in the
cytoplasm of the cell. Note that during the process the inside surface of the newly
formed vesicle is the same as the exterior surface of the cell. Thus the integrity of
the cytoplasm and the orientation of the plasma membrane are preserved. Once
internalized, a new vesicle containing solid materials may fuse with a lysosome so that
its solid contents are digested. The resulting molecules may be released to the
cytoplasm for use within the cell.
There are two general forms of endocytosis: phagocytosis and
pinocytosis. Phagocytosis is the uptake of large solid
particles such as bacteria or cellular debris. Pinocytosis is the uptake of
fluid and any small molecules dissolved within it. Cells are also capable of recognizing
specific particles and engulfing them in a more targeted way, a process called
receptor-mediated endocytosis. In this case, the particle first binds to a membrane
protein receptor on the surface of the cell. Binding of the target particle induces the
cell to engulf it.
Exocytosis is just the reverse of endocytosis. In exocytosis, an internal vesicle fuses
with the plasma membrane and releases its contents to the outside. The balance of
exocytosis and endocytosis preserves the size of the plasma membrane and keeps the
cell's size constant. The following animation depicts endocytosis.
You can use the magnifier in the lower righ-hand corner to zoom the
animation
How are endocytosis and exocytosis important to everyday life? Immune cells protect animals by
recognizing and destroying foreign objects such as bacteria. Disease-causing bacteria
are recognized by proteins called receptors on the surface of the immune cell. The
phagocytic immune cell will then engulf the bacterial cells (phagocytosis). The vesicle
that contains these bacterial cells is called a phagosome ("phago" means "eating" and
"-some" refers to "body"). The phagosome next fuses with lysosomes. Finally, the
digested bacterial products are excreted through the process of exocytosis.
Phagocytosis of a Bacterium

Cells continually encounter changes in their external environment. Most cells have a similar
blend of solutes within them, but external fluids can vary dramatically, from pure water
to brine or syrup. What will happen if there is a strong concentration gradient between
a cell's interior and the fluid outside? As you know, molecules will tend to move down
their concentration gradients until equilibrium is reached. You might think that solutes
will flow into our out of the cell until the solute concentrations are equal across the
membrane. However, not all molecules can pass through the cell membrane. The plasma
membrane (lipid bilayer) is significantly less permeable to most solutes than it is to
water. Therefore the WATER tends to flow in a way that establishes an equal
concentration of solutes on either side of the membrane. The water flows down its own
concentration gradient, with a net movement toward the region that has a higher
concentration of solutes. This movement of water across a semipermeable membrane in
response to an imbalance of solute is called osmosis.
Osmosis in an Animal Cell
 The figure shows red blood cells immersed in three different solutions. The black dots
represent sodium ions. Inside the red blood cell, the concentration of sodium is
equal under all three conditions (shown as four dots). In the hypertonic solution,
the concentration of sodium is higher outside (8 dots) than inside the cell. Water
tends to leave the cell, flowing down its own concentration gradient. In the
isotonic solution, the sodium concentration is the same inside and outside the cell.
Water molecules enter and leave the cell at the same rate and the system is in
equilibrium. In the hypotonic solution, there is a relatively low concentration of
sodium (two dots) on the outside of the cell. Water is more concentrated outside the
cell and tends to flow in. As water enters, sodium is diluted inside the cell,
bringing the cytoplasm's sodium concentration closer to that of the external
solution. But if too much water enters, the cell can burst (lyse).
The figure shows red blood cells immersed in three different solutions. The black dots
represent sodium ions. Inside the red blood cell, the concentration of sodium is
equal under all three conditions (shown as four dots). In the hypertonic solution,
the concentration of sodium is higher outside (8 dots) than inside the cell. Water
tends to leave the cell, flowing down its own concentration gradient. In the
isotonic solution, the sodium concentration is the same inside and outside the cell.
Water molecules enter and leave the cell at the same rate and the system is in
equilibrium. In the hypotonic solution, there is a relatively low concentration of
sodium (two dots) on the outside of the cell. Water is more concentrated outside the
cell and tends to flow in. As water enters, sodium is diluted inside the cell,
bringing the cytoplasm's sodium concentration closer to that of the external
solution. But if too much water enters, the cell can burst (lyse).
Cells may find themselves in three different sorts of solutions. The terms isotonic,
hypertonic, and hypotonic refer to the concentration of solutes outside the cell
relative to the solute concentration inside the cell. In an isotonic solution, solutes
and water are equally concentrated within and outside the cell. The cell is bathed in a
solution with a solute concentration that is similar to its own cytoplasm. Many medical
preparations (saline solutions for nasal sprays, eye drops, and intravenous drugs) are
designed to be isotonic to our cells. A hypotonic solution has a low solute
concentration and a high concentration of water compared to the cell's cytoplasm.
Distilled (pure) water is the ultimate hypotonic solution. If a cell is placed in a
hypotonic solution, it will tend to gain water. The solutes will "stay put" within the
cell, but water molecules will diffuse such that their net flow is toward the area with
a higher concentration of solutes. A hypertonic solution has a high solute concentration
(lower water concentration) compared to the cell cytoplasm. Very salty or sugary
solutions (brines or syrups) are hypertonic to living cells. If a cell is placed in such
a solution, water tends to flow spontaneously out of the cell.
Cystic fibrosis is an inherited condition that affects the respiratory and digestive
systems in children and adults. While there is no cure for the condition, in the 1950’s,
people diagnosed with cystic fibrosis were lucky if they lived long enough to go to
elementary school. Medical research has made an enormous difference in the life
expectancy of people with cystic fibrosis, and today, they routinely live into their
thirties and forties.
A diagnosis of cystic fibrosis (CF) is suspected if a patient has chronic weight loss
accompanied by problems with the respiratory system. Most people with the condition are
diagnosed by the time they are two years old. A century ago, cystic fibrosis was
diagnosed when a doctor licked the forehead of a patient and found it to be unusually
salty. While the medical equipment used to diagnose the condition today is much more
professional, the same symptoms are identified. People with CF exhibit a variety of
symptoms [1] that may include:
- persistent coughing often heavy with mucous;
- frequent respiratory infections;
- wheezing and shortness of breath;
- excessive appetite but poor weight gain;
- unusually salty-tasting skin; and
- greasy, bulky stools.
Cystic fibrosis is caused by a malfunctioning transport protein called Cystic
Fibrosis Transmembrane Conductance Regulator (CFTR). CFTR is a
channel that allows for the passage of chloride ions (Cl-) into and out of
the cell. CFTR is located in the cells that line the respiratory tract, the pancreas,
and sweat glands. It allows for the movement of Cl- into or out of a cell. CFTR is an
active transporter and requires
energy in the form of ATP to function.
Effect of Malfunctioning Membrane Transporters
People with cystic fibrosis have respiratory difficulties, usually caused by
unusually thick mucus in the respiratory tubes in the lungs. In the lungs, CFTR
transporters secrete chloride ions into the center of the respiratory tubes.
This increases the concentration of solutes in the mucus lining the tubes, which
in turn causes water to flow into the space inside the tubes (yellow). Under
normal conditions, this process allows for a runny mucus to line the tubes.
Human Lungs
 The lungs function by allowing air to flow through a series of tubes (yellow) that
culminate in tiny sacs where gas exchange occurs. The yellow tubes are lined
with special cells that have CFTR transporters in them that secrete chloride
ions into the air tubes.
The lungs function by allowing air to flow through a series of tubes (yellow) that
culminate in tiny sacs where gas exchange occurs. The yellow tubes are lined
with special cells that have CFTR transporters in them that secrete chloride
ions into the air tubes.
Treatments for Cystic Fibrosis
Most of the treatments for cystic fibrosis involve making sure the lungs remain clear of the
thick, sticky mucus. This can be done using drugs that thin the respiratory
mucus, like Pulmozyme. A more recently discovered treatment involves the
inhalation of hypertonic saline solution. This salty solution causes water to
move from the cells and into the airways (via osmosis), making the mucus more
watery and easier to cough up.
References
-
Cystic Fibrosis: Symptoms, Diagnosis and Treatment. American Lung Association,
http://www.lung.org/lung-disease/cystic-fibrosis/symptoms-diagnosis-and.html
.
- Frank E. Beddard
(1902).
The Cambridge Natural History, Volume X—Mammalia. Project Gutenberg.
The cell is the fundamental
unit of life. It is the first level of organization that presents all the
properties of life. In "The
Cell" unit, you learned about the different structures that
make up a cell. Implicit in that knowledge was the notion of cells as
continuously changing and dynamic entities; cells: grow, rebuild, repair,
reproduce, and react to the external environment. All of these
functions require energy.
 Energy provides the fuel needed to sustain living systems. This energy
enables organisms to carry out complex processes, including the maintenance
of homeostasis. Life captures, stores and uses energy through the process of
metabolism, which is the sum of all the chemical reactions that take place
in an organism.
Energy provides the fuel needed to sustain living systems. This energy
enables organisms to carry out complex processes, including the maintenance
of homeostasis. Life captures, stores and uses energy through the process of
metabolism, which is the sum of all the chemical reactions that take place
in an organism.
All living organisms — from bacteria to trees to humans — are composed of molecules. To make a
cell, many molecules must be combined, and it takes energy to build these
complex structures. Covalent bonds hold these molecules together, and the chemical bonds
contain energy associated with the force that holds two atoms together. As you know, some bonds are
relatively weak and unstable. When they are replaced by stronger, more stable
bonds, chemical potential energy is released that can be
captured by the cell and used to do work. In cells, certain high-energy
molecules contain many unstable bonds and are used for fuel. When these
molecules are broken down into simpler molecules with more stable bonds,
chemical potential energy is released. In this unit, you will learn how cells
manage to capture this energy and use it to do work (e.g.,
power movement or build new macromolecules).
Energy and carbon flow through the biosphere in a tightly coupled manner. The coupling
between energy and carbon is accomplished within an organism through the process
known as metabolism. Metabolism is the sum of all of the
metabolic pathways within an organism. A metabolic pathway
is a series of chemical conversions, each of which are catalyzed by an enzyme
(protein catalyst). The compounds that are internal to the pathway are referred
to as intermediates in the pathway. A number of pathways,
such as those related to energy production, are essential to life and are found
in all cells. Although specialized cells may possess different pathways, there
are common characteristics that apply to most pathways. These will be covered in
the discussion on "Common Characteristics of Metabolic
Pathways." In the Energy module, you will learn
about ATP, the universal energy carrier
in cells, and about how energy is transformed and transferred during
metabolic reactions.
Metabolic pathways are either anabolic or catabolic. Anabolic pathways
involve the use of energy and simple organic building blocks to create more
complex molecules. Catabolic pathways convert complex
molecules to simpler ones, releasing energy for use by the organism. In the Pathways and Regulation module, you will learn the
differences between catabolic and anabolic pathways.
The Common Pathway: Photosynthesis / Cell Respiration
The principle source of energy for all organisms on earth is the sun. This energy is absorbed
by photosynthetic organisms such as plants and algae and used to convert carbon
dioxide (CO2) to glucose and oxygen during
photosynthesis. The end result is that the energy
from the sun has been stored in glucose, a small six-carbon carbohydrate. The
oxygen and glucose are then available to other living organisms. Humans (and all
other organisms, including plants) use glucose as food, and release the energy
in glucose through a process called respiration. The
figure below illustrates this process of photosynthesis and respiration. During
this process, the carbon atoms in glucose combine with oxygen to produce
CO2; the glucose is oxidized, releasing energy. The
energy from the oxidation of glucose is stored in a small chemical called
ATP (adenosine triphosphate) for immediate use by
the cell. ATP is used for almost all of the energy needs
of the cell, from the synthesis of other complex molecules to doing mechanical
work, such as running. You will learn more about these two pathways in the
section about “Anabolic and Catabolic Reactions.”
 The source of almost all energy on the planet is the sun. This energy is harvested by
plants and certain microbes and is stored in the simple sugar glucose, in a
process called photosynthesis. All living organisms consume glucose and
combine it with oxygen to produce energy and carbon dioxide. The energy
released is temporarily stored by the synthesis of the high-energy compound
ATP. The energy released when ATP is broken down to ADP can be used to power
many biological functions, such as muscle contraction. Many organisms, such
as yeast, can utilize the energy stored in glucose without using oxygen.
Fermentation produces less ATP then cellular respiration and can produce a
variety of other end products. Yeasts, for example, produce ethanol (a
useful biofuel) when they ferment.
The source of almost all energy on the planet is the sun. This energy is harvested by
plants and certain microbes and is stored in the simple sugar glucose, in a
process called photosynthesis. All living organisms consume glucose and
combine it with oxygen to produce energy and carbon dioxide. The energy
released is temporarily stored by the synthesis of the high-energy compound
ATP. The energy released when ATP is broken down to ADP can be used to power
many biological functions, such as muscle contraction. Many organisms, such
as yeast, can utilize the energy stored in glucose without using oxygen.
Fermentation produces less ATP then cellular respiration and can produce a
variety of other end products. Yeasts, for example, produce ethanol (a
useful biofuel) when they ferment.
Many microorganisms, such as yeast, can utilize the energy stored in glucose in the absence
of oxygen (anaerobic growth); the most common form of this process is fermentation. In the absence of oxygen, yeasts still
produce ATP by the partial oxidation of glucose, releasing smaller amounts of
CO2. The remaining carbon atoms in the glucose are converted to
ethanol. The energy stored in ethanol can be used as fuel for our internal
combustion engines. Humans also undergo anaerobic metabolism during vigorous
exercise, but in humans, lactic acid is produced instead of ethanol. When
sufficient oxygen becomes available, the carbon atoms in lactate are converted
to CO2. Other organisms that perform fermentation produce a variety
of other end products. Alternative pathways such as
fermentation are addressed in a separate module.
Regulation of Pathways
All metabolic pathways are regulated such that they are only active when the products of the
pathway are required by the cell. In this way, the organism is able to optimize
the use of its carbon and energy resources.
Example
The Glycolysis Pathway
The first part of the process of respiration is called glycolysis. It consists basically of
the breakdown of glucose into a smaller compound called pyruvate. Pyruvate
can then go on to either respiration or fermentation, depending on the
availability of oxygen. Glycolysis will occur if the cell requires energy.
The glycolysis pathway is regulated to turn glycolysis on or off, depending
on the energy needs of the cell. There would be two dire consequences if the
energy that is stored in food were to be released immediately after
consumption.
First, the organism would run out of energy quickly and would therefore have to consume food
all the time, which isn’t possible for most organisms, especially mammals,
which need to sleep.
Secondly, the heat that would be released by the production of energy would raise the
temperature of the organism to intolerable levels. Misregulation of
metabolic pathways can cause disease. For example, in diabetes, the
metabolism of glucose is incorrectly regulated.
All living things need energy to run the processes required for life. Energy is
defined as the capacity to do work. You can think of “work” as any change that
won’t happen on its own. Work can involve movement, building larger molecules,
increasing the concentration of chemicals, increasing the temperature of an
object, making a sound, or even glowing (bioluminescence).
Energy is recognized by what it DOES: it makes “work” happen. It makes
things change. Energy exists in many forms. Some biologically important forms of
energy are light energy, electrical energy,
sound energy, and thermal or heat
energy. Kinetic energy is the energy of motion.
Potential energy is stored energy. Energy can
change forms and often transforms from potential to kinetic energy, and back. In
biology, a key form of potential energy is chemical
energy: the energy stored in chemical bonds. It can be released when
certain bonds are broken. Chemical energy is released when wood is burned: the
bonds in the wood are broken, releasing light and heat energy.
Example
Types of Work
The first example below shows a single-celled organism — an amoeba — using energy to move. The
second example illustrates the chemical reaction resulting in urea, a molecule found
in urine. The third example shows bioluminescence — the emission of light by living
organisms; in this case, the aurelia aurita jelly fish.
Example 1: Cell movement. Double-click on the above image to observe an
amoeba using energy to move.
|
 Example 2: Chemical Reaction. This chemical reaction is building urea (a
molecule found in urine). Example 2: Chemical Reaction. This chemical reaction is building urea (a
molecule found in urine).
|
Example 3: Light Emission. Double-click on the image to observe the jellyfish
(Aurelia aurita) showing bioluminescence.
Energy can be converted from one form to another. In the image below, the chemical energy in
the wood is converted to light and heat. After the fire dies, the heat and light have
dissipated and are no longer available for living organisms. Energy in our biosphere is
a one-way system: It comes from the sun, is captured by living organisms, and eventually
is released back out as heat.

Biological Energy Transformations
Energy cannot be created or destroyed. Instead, energy is transformed from one form to
another. Imagine that you climb a mountain trail ending in a steep cliff. Your
body’s movement (kinetic energy) is fueled by chemical energy from your food. As
you move uphill, your body’s chemical potential energy decreases (you break down
molecules and use up stored food energy). At the same time, your body’s gravitational potential energy increases. This kind of potential energy can be released by letting an
object drop from a height. A fall from the top of the cliff would do a great
deal of “work,” so watch your step!
Chemical to Gravitational Energy
 Converting chemical energy to gravitational energy. © Copyright
Iain Lees
and licensed for reuse under the
CC BY-SA 2.0 licence.
Converting chemical energy to gravitational energy. © Copyright
Iain Lees
and licensed for reuse under the
CC BY-SA 2.0 licence.
Where does chemical energy in food come from? The sun provides solar energy, the energy
source for most living things. Plants and other photosynthetic organisms can use
solar energy to build sugar molecules from simpler raw materials (carbon dioxide
and water). A sugar molecule stores chemical energy in the bonds that join its
atoms. The energy stored in sugar can be released and used to build other types
of biological molecules (proteins, lipids, etc.), which also contain stored
chemical energy in their complex structures.
 Energy from the sun can be converted into chemical energy (in sugars)
by photosynthetic organisms. This chemical energy can then be used to do
other work like building the components needed for growth.
Energy from the sun can be converted into chemical energy (in sugars)
by photosynthetic organisms. This chemical energy can then be used to do
other work like building the components needed for growth.
To us, it seems that the sun has burned forever and will always keep shining.
However, the sun is fueled by nuclear energy generated by atoms colliding in its
incredibly hot core. Eventually, the supply of fuel in the sun will be depleted
and our sun’s long life will end. This illustrates an inescapable fact about
energy: it tends to lose quality over time. It dissipates, spreading out in
space, and loses its intensity.

Heat is the energy possessed by any substance because of the random jiggling of
its molecules and atoms. It is a low form of energy, disorderly, and spreads out
rapidly through most materials. Every kind of energy conversion generates at
least some heat energy as a byproduct. For example, the breakdown and use of
chemical energy in food also releases heat. Heat can be helpful in keeping our
bodies warm, but for the most part heat energy is a loss: an energy waste that
cannot be recovered. No organism can capture heat and use it to do work or to
make food. Instead, heat seeps out of organisms and eventually into space,
leaving the biosphere forever.
Adenosine triphosphate, or ATP, is an organic molecule that acts as
the direct energy source for almost all cellular activities. ATP consists of a single
adenosine molecule (composed of an adenine bound to a ribose sugar) linked to three
phosphate ions.
 ATP consists of a single adenosine molecule (green rectangle) linked to three
phosphate ions (orange circles).
ATP consists of a single adenosine molecule (green rectangle) linked to three
phosphate ions (orange circles).
ATP is a relatively unstable molecule. Consequently it is never used for the long-term storage
of energy in the cell. This job goes to other more stable compounds, like fats and
sugars. ATP is specialized for direct and rapid transfers of energy. It is because of
this instability that ATP is such a good energy currency for the cell (it’s easy to
“spend” this energy). ATP is like cash, while long-term energy storage molecules (such
as fats and sugars) are more like a savings account.
Hydrolysis of ATP Releases Energy
ATP is an important molecule in biological systems because the chemical bond between the last
two phosphates is unstable, and reactions that involve the removal of the
terminal (last) phosphate release energy. This bond can be broken in a reaction
involving water. This reaction is called a hydrolysis
reaction ("hydro" means "water" and "lysis" means "separation"; together they
mean "using water to separate"). The products of this reaction are inorganic
phosphate (P) and adenosine diphosphate (ADP), which has
only two phosphate groups. Taken together, ADP and P are more stable than ATP.
The net result of ATP hydrolysis is the release of energy. This process is
illustrated in the animation below.
Hydrolysis of ATP releases energy by breaking down ATP into ADP and an
inorganic phosphate. Building ATP from ATP and an inorganic phosphate requires
the input of energy in a condensation reaction.
ATP, the molecule with the higher energy content, can react to form ADP + P. This
chemical reaction can also be reversed. ADP + P can combine to form ATP, a reaction
referred to as a condensation reaction since two molecules are
condensed into one. We know the first reaction (ATP → ADP + P) releases energy.
Therefore, the second reaction (ADP + P → ATP) requires energy. The opposing reactions
are like using and charging a rechargeable battery. When you use the energy stored in
the rechargeable battery, it is like using up ATP (ATP hydrolysis). When you recharge
the battery, you must put energy in (by plugging it into the electrical socket). This is
like ATP formation, which is usually fueled by chemical energy extracted from sugar or
fats.
Virtually all the activities of the cell are powered by the energy released when
ATP loses its terminal phosphate. For example, ATP hydrolysis provides the
energy needed to form complex molecules from simpler ones (synthesis). ATP can
also transfer energy by making proteins change shape when ATP is converted to
ADP. When proteins change shape, their microscopic movements can add up to
macroscopic motion, such as occurs when entire muscles contract. Similarly, ATP
can transfer energy to specialized transport proteins embedded in the cell
membrane and enable materials to be pumped in or out of the cell, against their
concentration gradients (active transport).
Change in Potential Energy with the Formation and Breakdown of ATP
The energy difference between ATP and ADP is largely due to the interaction between the
negatively charged phosphate groups in each molecule. You may remember that
unlike charges (+ and -) attract each other, while like charges (+ and +; or -
and -) repel each other. Energy is therefore required to move two negative
charges close to each other, which is what happens when ATP is made from ADP and
phosphate. This is similar to the way in which energy is required to bring the
two north poles of a bar magnet together.
Examine the following figure, which illustrates the change in energy found within a chemical
system as a phosphate ion is slowly brought closer to an ADP molecule. As the
negatively charged phosphate gets closer to the negatively charged ADP molecule,
more energy is required to overcome the particles' natural tendency to repel
each other.
 These diagrams illustrate the change in energy as a negatively charged phosphate
approaches negatively charged ADP during ATP synthesis. As the phosphate
moves closer to the ADP (from diagram 1 to diagram 4), the energy rises
because like charges try to repel each other. When the phosphate is close
(4), a large amount of potential energy has been stored in the ATP molecule.
This energy is released when ATP is hydrolyzed and the newly formed
phosphate moves away. This process is similar to rolling a ball up a hill.
Energy is required to get the ball to the top of the hill and this energy
exists as potential energy. However, when the ball is released, it quickly
rolls down the hill. The energy that was used to push the ball up the hill
is released as kinetic energy.
These diagrams illustrate the change in energy as a negatively charged phosphate
approaches negatively charged ADP during ATP synthesis. As the phosphate
moves closer to the ADP (from diagram 1 to diagram 4), the energy rises
because like charges try to repel each other. When the phosphate is close
(4), a large amount of potential energy has been stored in the ATP molecule.
This energy is released when ATP is hydrolyzed and the newly formed
phosphate moves away. This process is similar to rolling a ball up a hill.
Energy is required to get the ball to the top of the hill and this energy
exists as potential energy. However, when the ball is released, it quickly
rolls down the hill. The energy that was used to push the ball up the hill
is released as kinetic energy.
Most life on Earth is fueled by solar energy through the process of photosynthesis.
Photosynthetic organisms use sunlight to make organic molecules from simple raw
materials (carbon dioxide and water). Cellular respiration and other processes break
down organic molecules and use the energy released to build ATP molecules. ATP then
transfers energy to drive many important processes in cells including movement,
transport, and synthesis. In this way, the energy from the sun is transformed to
chemical energy in molecules such as glucose and ATP. Eventually energy is released in
forms like motion, heat, sound, or light.
What is Metabolism?
Metabolism is the sum of all chemical activity within a living organism. Reactions that
release energy are called exergonic (“exer” refers to
“out” and “gonic” refers to “energy,” so these are “energy out” reactions).
Reactions that require energy are called endergonic
(“energy in”). Exergonic reactions can be used to power endergonic reactions.
For example, building ATP from ADP and phosphate requires energy (it is an
endergonic reaction). Exergonic reactions can provide the necessary energy to
build ATP.
Catabolic reactions (also called “catabolism”) break down
larger, more complex molecules into smaller molecules and release energy in the
process. The smaller end products of a catabolic reaction may be released as
waste or they may be fed into other reactions. The energy that is released by
catabolic reactions can be captured and used in many ways. Some of the energy is
released as heat and increases the temperature of the cell. Sometimes the energy
is stored in the chemical bonds of another molecule. And sometimes it can be
used to do work, such as movement of cellular machinery to power the active
transport of materials across cell membranes. Catabolic reactions are central to
biological processes such as cellular respiration and the digestion of food
molecules.
Cellular respiration is catabolic because it takes glucose (a complex
molecule with 6 carbons) and reduces it to carbon dioxide (each with only one
carbon) and water (oxygen joined to two hydrogens). Some of the energy released
by this process is captured in ATP, which can be stored for later use.
Digestion of protein is also a catabolic reaction. It takes a very large protein molecule and
breaks it down into several smaller polypeptides, then dismantles the
polypeptides to yield individual amino acids.
Catabolic Reactions Release Energy and Reduce Complexity
 In the figure above, a larger molecule on the left is broken down into smaller and
simpler components. As high-energy bonds are broken and replaced by lower-energy
bonds, energy is released. Some of this energy may be captured to do cellular
work.
In the figure above, a larger molecule on the left is broken down into smaller and
simpler components. As high-energy bonds are broken and replaced by lower-energy
bonds, energy is released. Some of this energy may be captured to do cellular
work.
Anabolic reactions use energy to build more complex molecules from
relatively simple raw materials. “Anabolic” and “catabolic” sound
similar but are opposites. To remember the difference, it may help to think about how
“anabolic steroids” promote the buildup of muscle mass. All of the complex molecules of
life — carbohydrates, lipids, proteins, nucleic acids — are generated by anabolic
reactions. Anabolic reactions are central to processes like photosynthesis, protein
synthesis, and DNA replication.
At this point, you may wonder why the cell has to break down complex
molecules in order to build them up again. Different cells use and require different
biomolecules for their specialized functions. For example,
carbohydrates are good sources of energy. In plants,
carbohydrates are usually stored as starch. In animals, they are stored as glycogen.
Both are polymers of glucose, but they have different structures,
and an animal cell cannot readily store or access starch. When an athlete “carbo-loads”
the evening before a race, starches from foods like pasta are digested to simple sugars
in a catabolic reaction. They are then rebuilt as glycogen (in an anabolic reaction) in
the muscles and liver. That way, there is some extra energy stored and easily accessible
for the muscle cells to use for the big race. Biomolecules are broken down to raw
materials, then rebuilt in a different form to meet the needs of
the organism. One molecule that is unique to your cells is DNA. No other organism
(except an identical twin) has the same DNA as you, so your cells need to build it anew
in order to pass it on to the next generation
Photosynthesis is an anabolic process you’ll learn more about in this unit.
Protein synthesis is an amazing feat of anabolism. Protein chains (polypeptides) are produced by
linking together relatively simple amino acid monomers. In one polypeptide, thousands of
amino acids may be strung together, and several different polypeptides may fold and bind
to each other to form a large and complex protein molecule.
Anabolic Reactions Use Energy to Build Complex Molecules
 In the figure above, several smaller components are joined by bonds to form
larger, more complex molecules. Energy inputs are required to do this
work.
In the figure above, several smaller components are joined by bonds to form
larger, more complex molecules. Energy inputs are required to do this
work.
ATP Carries Energy from Catabolic Reactions to Anabolic Reactions
Life requires energy to accomplish its anabolic reactions. This energy cannot be “made” from
nothing, because energy cannot be created or destroyed. But energy can be
transferred and transformed. Energy that is available to the cell must somehow
be packaged in useful form and delivered where it is needed. This problem is
solved through chemical transfers of energy from catabolic reactions to energy
carriers and then from the energy carriers to the substrates that are joined in
anabolic reactions.
Life’s universal energy carrier is adenosine
triphosphate (ATP). ATP acts as a shuttle that
transfers energy from catabolic reactions that release energy from complex
molecules (such as cellular respiration) to the anabolic reactions that consume
energy (such as protein synthesis). The energy released from catabolic reactions
can be stored for later use through the formation of ATP by combining ADP plus a
phosphate group. Then, when energy is required for anabolic reactions, ATP can
be broken down into ADP and a phosphate group, releasing energy that was stored
in the phosphate bond.
Plants, algae, and some bacteria can use light energy to turn carbon dioxide and water into
simple sugars through the process of photosynthesis. These sugars can act as “building
blocks” for the synthesis of other organic molecules, or they can store energy for later
use. While the process of photosynthesis stores chemical energy for later use, most
photosynthetic organisms access the stored energy the same way consumers do: they break
down the sugars to build ATP using the process of cellular respiration, which occurs in
subcellular organelles called mitochondria.
Photosynthetic producers have evolved an effective system for absorbing light and converting it
into chemical energy. This biochemical solar energy system begins with a diverse array
of (mostly green) pigments that are embedded in membranes. In plants and algae, these
pigments are contained within specialized subcellular organelles called
chloroplasts.
You may want to review the Cell Structures page.
The main purpose of photosynthesis is to convert energy from sunlight and store it as bond
energy within sugars. Photosynthesis uses pigments (such as chlorophyll) in the
chloroplasts to absorb light energy. This energy is used to produce sugars from carbon
dioxide, while oxygen is given off as a byproduct. You will examine the function of
pigments in more detail later.
Photosynthesis Transforms Light to Chemical Energy in Sugar
 Light energy enables photosynthesis. This process requires the participation
of chlorophyll pigment; in plants it occurs mainly in leaves.
Light energy enables photosynthesis. This process requires the participation
of chlorophyll pigment; in plants it occurs mainly in leaves.
Some photosynthetic organisms (such as most algae and cyanobacteria) live in water. Their
cells are equipped with pigments to absorb light, and they absorb water and other
nutrients directly across the cell membrane. They are faced with a challenge involving
the attenuation (loss) of light energy with increasing depth. As a result, many algae
and cyanobacteria have adaptations that keep them floating near the water’s surface.
Kelp Float to Reach Light
 These kelp are anchored below and use air bladders for the top of the plant to reach the
water’s surface.
These kelp are anchored below and use air bladders for the top of the plant to reach the
water’s surface.
Land plants face a different set of challenges. Plant leaves are the main location of
photosynthesis. They are often large, flat structures that are adapted for maximum light
absorption. In many plants, leaves also are held high above the ground by tall stems.
Growing tall is an adaptation that helps a plant get high-intensity sunlight, because
short plants are more likely to be shaded by taller ones.
Plants Grow Tall to Compete for Light
 Land plant leaves are often broad and flat, maximizing the surface area for light
absorption. Many species also grow upward to gain access to high-intensity sunlight.
Note also how the leaves are arranged: few gaps are left unfilled in this tree’s
canopy.
Land plant leaves are often broad and flat, maximizing the surface area for light
absorption. Many species also grow upward to gain access to high-intensity sunlight.
Note also how the leaves are arranged: few gaps are left unfilled in this tree’s
canopy.
Land plants also face the risk of drying out. Plants have evolved traits that protect their
above-ground portions from excess water loss. For example, plant leaves are sealed with
a layer of waxy material called cuticle. Protected in this way, leaves cannot
efficiently absorb water when it rains. Instead, land plants absorb water from the
ground (through their roots).
Plants must then transport water upward to leaves and other tissues. This is quite a challenge
for a tall plant. Plants have no moving parts that could power a pump, so their
circulatory systems must work on different principles. Plants use specialized cells to
move water. These cells are essentially long, thin tubes that transport water from the
roots all the way up to hollow cavities in the leaves. Evaporation of water from leaves
provides negative pressure that sucks water up the tubes. The thick cell wall that
allows the tube cells to function without collapsing also provides the plant with
structural stability. “Wood” is mainly the structural material that remains after these
cells have died. Ultimately, an adaptation for moving water helps woody plants grow even
taller than their less sturdy cousins, further enhancing their access to light.
Microscopic image of wood
 Under a microscope, you can see the individual transport cells that make up the
wood.
Under a microscope, you can see the individual transport cells that make up the
wood.
The adaptations of plants have long been a subject of biological study. One of the first
questions asked by early scientists was, “How do plants get their resources for
growth?”
Photosynthesis: A Summary
 Photosynthesis is summarized in the diagram above. The sun provides energy that enables
carbon dioxide and water to react to form glucose. Oxygen gas is a byproduct of this
process.
Photosynthesis is summarized in the diagram above. The sun provides energy that enables
carbon dioxide and water to react to form glucose. Oxygen gas is a byproduct of this
process.
We know that plants require light. But “light” is a complex form of energy. Visible light
is just a small part of a much broader spectrum including many forms of electromagnetic
radiation. In many ways, light behaves as a wave. Different colors of light have
different wavelengths. In a given period of time, short wavelengths deliver more energy
to a surface than longer wavelengths. Thus blue light is higher in energy than red
light.
Sunlight Includes All Colors of Visible Light
 A rainbow vividly demonstrates that sunlight includes a range of light colors
and wavelengths, from blue (shorter wavelengths) to red (longer wavelengths).
Raindrops act as prisms, separating the wavelengths and making the colors apparent.
© Copyright Rod Trevaskus and licensed for reuse under this Creative
Commons Licence.
A rainbow vividly demonstrates that sunlight includes a range of light colors
and wavelengths, from blue (shorter wavelengths) to red (longer wavelengths).
Raindrops act as prisms, separating the wavelengths and making the colors apparent.
© Copyright Rod Trevaskus and licensed for reuse under this Creative
Commons Licence.
Are all wavelengths of light equally useful for photosynthesis? In 1883, a scientist named
George Engelmann designed an experiment to answer this question. He shined a light
through a prism to separate the different wavelengths so that they landed on different
zones along the length of filaments of Spirogyra, a type of
green algae. Examine the following image depicting Engelmann’s results.
Engelmann's Action Spectrum Experiment

Pigments are colored substances that absorb light energy. Why does a pigment look red,
green, purple, or blue? A given pigment absorbs only a limited set of light wavelengths.
For example, a red pigment absorbs green and blue wavelengths. Red light, by contrast,
is NOT absorbed: it is either reflected or transmitted through a solution containing the
pigment.
Pigments Absorb Some Wavelengths and Reflect Others
 The green chlorophyll pigment appears green because it reflects and transmits
light in the green wavelength range. Blue and red light, by contrast, are
absorbed.
The green chlorophyll pigment appears green because it reflects and transmits
light in the green wavelength range. Blue and red light, by contrast, are
absorbed.
What happens to light energy that is absorbed by a pigment? In keeping with the law of
conservation of energy, this energy does not disappear. Instead, it excites electrons in
the pigment, boosting them to higher energy levels. In plants, the excited electrons
from some pigments are transferred to other molecules, where they start the
transformation of light energy into chemical potential energy.
If excited electrons are not removed from a pigment molecule, they will eventually “fall” back
to their starting point. At this point, the pigment will release energy. In some
pigments, a portion of the released energy is emitted as light. If you expose these
fluorescent pigments to light and then place them in a dark place, they will glow. All
pigments release at least some of the energy they absorbed from light as heat.
O2 is a product of photosynthesis. This product is essential for many living
organisms, including humans and any other organisms that go through cellular
respiration. When photosynthesis became widespread in the early Earth’s oceans, it
generated excess oxygen gas that changed the Earth’s atmosphere. This increase in
atmospheric oxygen concentration eventually changed the face of our planet as organisms
that couldn’t adapt died off and new organisms evolved.
As we have emphasized thus far, cells juggle energy through opposing reactions. Photosynthesis
is an anabolic pathway fueled by solar energy that allows the synthesis of organic
molecules from simple raw materials. Catabolic pathways reverse this process. They break
molecules down into simpler components. The centrally important catabolic pathway that
is complementary to photosynthesis is cellular respiration. Although there are may other
catabolic reactions occurring in any cell, cellular respiration supplies the vast
majority of ATP molecules required for cellular work in aerobic organisms.
If you compare the summary reactions of photosynthesis and cellular respiration, you will
see that cellular respiration is photosynthesis “running in reverse”:
Cellular Respiration Breaks Down Sugar and Captures Energy within ATP
 Sugar and oxygen gas are converted to carbon dioxide and water in cellular
respiration. In the process, heat is released and ADP is phosphorylated to produce
ATP.
Sugar and oxygen gas are converted to carbon dioxide and water in cellular
respiration. In the process, heat is released and ADP is phosphorylated to produce
ATP.
Cellular respiration is a key pathway in the metabolism of all aerobic organisms. On the macro
scale, respiration refers to breathing: taking in oxygen and removing CO2.
But ultimately, the reason we need to breathe is to provide the oxygen needed to carry
out cellular respiration in our cells and to remove the carbon dioxide produced as a
byproduct.
Three important things happen during cellular respiration:
- The carbon-containing molecules used as cellular fuel are broken down and
converted to CO2.
- Electrons and hydrogen ions (H+) are produced as sugar is broken down and energy is
harvested; oxygen (O2) combines with these byproducts to produce water
(H2O).
- The energy released when carbon-containing molecules are broken down is
captured and used to generate ATP molecules; some energy is also lost as
heat.
In eukaryotes, the breakdown of sugar begins in the cytoplasm (cytosol), while the consumption
of oxygen and the generation of CO2 and ATP synthesis happen inside
specialized membrane-bound organelles called mitochondria.
Combustion vs. Respiration
Energy is released in small portions, so that
some of the released energy can be captured in chemical bonds, ultimately as
ATP.
The process can be regulated at different steps, allowing cells more control over
the process.
Combustion vs. Respiration
 Both combustion and respiration release the same amount of energy. However, because
combustion happens all at once, much of that energy is released as heat and
light and cannot be captured by the cells. The stepwise process of
respiration releases energy slowly so cells can capture the energy in
ATP.
Both combustion and respiration release the same amount of energy. However, because
combustion happens all at once, much of that energy is released as heat and
light and cannot be captured by the cells. The stepwise process of
respiration releases energy slowly so cells can capture the energy in
ATP.
Use of Dietary Nutrients and Stored Fats in Cellular Respiration
Cellular respiration is a complex, multistep process. Dozens of different enzymes and
intermediates are involved. Initial steps are accomplished in the cytoplasm, and
additional steps occur in the mitochondria. At various points along the way,
intermediates may be removed and used to synthesize fats and other molecules.
Similarly, different types of food molecules may “feed in” to cell respiration
at specific junctions in the process.
Even though glucose is the starting substance used in cellular respiration,
organisms do not consume pure glucose as an energy source. Instead, many
different kinds of fuel molecules must be partly broken down and then fed into
various stages of the cellular respiration pathway. For example, complex
carbohydrates are readily converted to glucose or similar sugars. Fats and
proteins can also be used in cellular respiration, but they must be modified
before they can feed into the process.
Many Fuels Feed into Cellular Respiration
 In addition to carbohydrates, fats and proteins can also be used as fuels for cellular
respiration. However, these fuels must first be partially broken down, and they feed
in at intermediate steps within the pathway.
In addition to carbohydrates, fats and proteins can also be used as fuels for cellular
respiration. However, these fuels must first be partially broken down, and they feed
in at intermediate steps within the pathway.
As you may recall, photosynthesis occurs in some bacteria; in eukaryotes it occurs in
cells that contain chloroplasts. Such cells are found in algae and in the leaves and
stems of plants. Photosynthetic organisms use light energy and simple building blocks
(carbon dioxide and water) to make their own food. Cellular respiration is very
widespread. It is completed in mitochondria, bacteria-like organelles that are found in
protists, fungi, plants, and animals. Although the details of the two pathways are
different, the overall reaction of cellular respiration is photosynthesis running in
reverse. Cellular respiration extracts the stored energy from food molecules, uses it to
“charge up” ATP, and releases carbon dioxide and water as wastes.
Photosynthesis and Cellular Respiration Recycle Carbon and Transfer
Energy
In the last two sections, the topics of photosynthesis and cellular respiration have been
introduced and discussed as independent processes. The focus of this module is
on how the two processes are part of one larger cycle. There is a yin-yang
relationship between the two processes — the product of one process is the
starting material for the other.
In the image below, you see a summary of photosynthesis. But photosynthesis does not occur in
a vacuum. In fact, it is inevitably PAIRED WITH cellular respiration in most
producers. They take most of the glucose they have produced and break it right
down again in their own cells.
Photosynthesis Summary Reaction: CO2 and H2O to Glucose Using
Light Energy
 In the diagram above, photosynthesis is summarized. Carbon dioxide and water are
joined to form glucose using light energy. Oxygen gas is also a byproduct of
this process.
In the diagram above, photosynthesis is summarized. Carbon dioxide and water are
joined to form glucose using light energy. Oxygen gas is also a byproduct of
this process.
A full representation joins photosynthesis to cellular respiration in a cycle. The products
of one reaction are the starting materials for the other.
 Cellular respiration and photosynthesis are interdependent. The
glucose and oxygen produced by photosynthesis are used up in cellular
respiration. Energy is transferred to “charge up” ATP, and heat, carbon
dioxide, and water are released as waste products. The carbon dioxide and
water are then available as raw materials for photosynthesis.
Cellular respiration and photosynthesis are interdependent. The
glucose and oxygen produced by photosynthesis are used up in cellular
respiration. Energy is transferred to “charge up” ATP, and heat, carbon
dioxide, and water are released as waste products. The carbon dioxide and
water are then available as raw materials for photosynthesis.
Cycling Between Photosynthesis and Cellular Respiration
This is how the cycling between photosynthesis and cellular respiration occurs: in
photosynthesis, carbon dioxide and water, in the presence of light energy, are
converted to make glucose and oxygen; while in cellular respiration, the
products of photosynthesis (glucose and oxygen) are metabolized to make energy
in the form of ATP and heat, releasing carbon dioxide and water. Because each
process starts where the other ends, they form a cycle.
The photosynthesis / cellular respiration cycle isn’t restricted to the cells of an
individual plant. To the contrary, it is a global cycle that makes all life on
Earth interdependent. A growing photosynthetic producer carries out more
photosynthesis than cellular respiration. Thus, it releases excess oxygen into
the atmosphere and stores carbohydrates and other molecules in its body as
growth. These materials are essential to virtually all other life forms on
Earth. This interdependence is depicted in the diagram below.
Photosynthesis -Cellular Respiration Cycle
 This image shows the cycling between the products of
photosynthesis and cellular respiration. The two processes are intimately
linked.
This image shows the cycling between the products of
photosynthesis and cellular respiration. The two processes are intimately
linked.
The cycling that occurs between photosynthesis and cellular respiration is vital to the
health of planet Earth. If there was no way for the carbon dioxide produced through
cellular respiration to be utilized, respiring organisms (like humans, dogs, and even
grass) would soon die of asphyxiation. Additionally, photosynthetic organisms are the
base of almost every food chain on the planet, so without these organisms, mass
starvation would ensue. Luckily, this planet is full of photosynthetic organisms. All of
the breathable oxygen on Earth comes from photosynthesis. Just over half of the oxygen
is produced by phytoplankton — drifting photosynthetic algae and bacteria — in the
oceans. The rest comes from plants (trees, grass, etc.) on the land. Without this vital
connection between photosynthesis and cellular respiration, life as we know it would
cease to exist.
Cycling Between Photosynthesis and Cellular Respiration

An understanding of this balance is important in the modern world, with global warming in the
headlines. Since the late 1700's, the amount of carbon dioxide in the Earth’s atmosphere
has been rising. This indicates that the natural recycling of carbon has been upset. The
main source of excess carbon dioxide in our atmosphere is the burning of fossil fuels,
which were created by photosynthesis millions of years ago. Meanwhile, deforestation
removes photosynthetic organisms (trees) from the surface of the planet. Taken together,
these human activities have changed Earth’s atmosphere. The carbon dioxide concentration
of Earth’s air has increased by more than 35 percent since the 1700's. Such changes are
very likely changing Earth’s climate, and pollution and deforestation also have other
detrimental effects on environmental health. We will return to explore these topics
further in the Ecology unit. You will need to use your understanding of photosynthesis
and respiration to fully grasp these issues.
Metabolic pathways constitute a complex network of chemical reactions, with some pathways
functioning like central “freeways” to which many other pathways connect.
Pathways related to the harvesting of energy (chemical or solar) and
biosynthesis of the major cellular components are conserved in many types of
cells and organisms.
Many organisms use energy harvesting pathways other than photosynthesis and
cellular respiration. Bacteria, in particular, have an astonishing array of
metabolic options. The variety of metabolic options in the bacterial domain
helps scientists classify evolutionary relationships between these
organisms.
Many of these metabolic options do not require oxygen and are called anaerobic (“an-” means
without and “aerobic” refers to oxygen). Fermentation breaks down organic
molecules and stores energy as ATP. Although fermentation is the only
ATP-producing pathway for some microbes, it is also commonly used by many
organisms as a special-purpose pathway. For example, yeasts that decompose fruit
can switch between aerobic cellular respiration (used when oxygen is abundant)
to a form of fermentation that produces ethanol (used when oxygen is depleted).
This allows yeast to continue to produce ATP even in rotten, oxygen-poor
fruit.
Some human tissues also use fermentation under certain conditions. Sprinters and
weightlifters have well-developed fast-twitch muscles. Fast-twitch fibers have
fewer mitochondria and are not able to renew their supply of oxygen rapidly.
Therefore, they have relatively poor endurance. However, fast-twitch fibers
excel at producing strong contractions very quickly. They do this using the ATP
created through a form of fermentation. This pathway does not break sugar all
the way down to CO2, but stops at an intermediate (lactic acid).
Lactic Acid Fermentation is a Partial Breakdown of
Glucose
 Fermentation reactions do not require oxygen, and they do not break all
glucose down fully to carbon dioxide. Instead, they end with organic molecules that
still contain considerable chemical potential energy. Such pathways produce only a
tiny amount of ATP compared to aerobic cellular respiration.
Fermentation reactions do not require oxygen, and they do not break all
glucose down fully to carbon dioxide. Instead, they end with organic molecules that
still contain considerable chemical potential energy. Such pathways produce only a
tiny amount of ATP compared to aerobic cellular respiration.
Oxygen is not used in fermentation, and although some CO2 may be produced, glucose
is not fully broken down. Instead, fermentation ends with complex products
(lactate, ethanol) that still contain quite a bit of chemical potential energy.
The breakdown process is incomplete, and relatively little energy is available
to drive the production of ATP. In addition, the byproducts of fermentation can
be toxic. For example, a buildup of lactic acid may cause stiffness in an
overworked muscle.
Fermentation is a very common metabolic pathway in microorganisms such as bacteria and yeast,
resulting in alcoholic beverages, fermented milk products, and bread. In
fermentation of alcoholic beverages, yeast is added to sugary juices or malt
syrups. The container is sealed to exclude oxygen. Under these conditions, the
yeast switches to fermentation and generates ethanol, the intoxicating “active
ingredient” of alcoholic beverages. Eventually, however, ethanol concentrations
reach a point where the yeasts themselves are inhibited and fermentation grinds
to a halt. In this way, wine and beer are naturally limited in their alcohol
content. High-alcohol liquors can be produced only by distillation, a chemical
process that concentrates the alcohol.
Fermentation tank
 Cellular respiration and fermentation both break down organic molecules to build ATP.
However, cellular respiration is aerobic, while fermentation is anaerobic.
Cellular respiration produces more ATP.
Cellular respiration and fermentation both break down organic molecules to build ATP.
However, cellular respiration is aerobic, while fermentation is anaerobic.
Cellular respiration produces more ATP.
| *Some bacteria can carry out forms of respiration that do not require oxygen. |
| Characteristic |
Cellular Respiration |
Fermentation |
| Energy source |
organic molecules |
organic molecules |
| ATP production |
36-38 ATP produced |
2 ATP produced |
| Oxygen |
required (aerobic)* |
not required (anaerobic) |
| End products |
CO2 and H2O |
variety of end products including: alcohols, acids, acetone |
|
Cellular respiration and fermentation both break down organic molecules to build ATP. However,
cellular respiration is aerobic while fermentation is anaerobic; cellular respiration produces
more ATP. The ATP yield in the table originates from one glucose molecule.
Products of fermentation
 Fermentation can produce a variety of end products including: a) cheese, b) yogurt, c)
soy sauce, d) vinegar, e) acetone (nail polish remover), and f) chocolate.
Fermentation can produce a variety of end products including: a) cheese, b) yogurt, c)
soy sauce, d) vinegar, e) acetone (nail polish remover), and f) chocolate.
In the previous modules, you learned about metabolic pathways in cells — those “freeways” that
shuttle energy and carbon in different directions. Metabolic pathways can be either
anabolic or catabolic. Anabolic pathways build things up and catabolic pathways break
them back down again, sometimes as a source of energy, other times to obtain building
materials. Among the main pathways of the cell are photosynthesis and cellular
respiration, although there are a variety of alternative pathways such as
fermentation.
Metabolic Pathways
Metabolic pathways consist of an ordered set of chemical reactions that are catalyzed by
enzymes. At the heart of metabolism are enzymes. These proteins embrace
substrates, quickly generating products. One or more substrates bind to an
enzyme’s active site. As a result, the activation energy is reduced and the
reaction proceeds much more quickly than it otherwise would. Without enzymes,
metabolism would grind to a halt. Furthermore, the structural characteristics of
enzymes allow the regulation of their function, thus allowing the regulation of
the metabolic pathways they participate in. A huge diversity of enzymes is
required to run the metabolic reactions necessary to maintain even a single
cell.
Regardless of their purpose, all metabolic pathways share four important
features:
-
Many pathways are universal among living organisms. When you look at life,
you may see a great deal of diversity. Those who study metabolism, by contrast,
see a huge degree of overlap among the cells of all living things. Many of the
fundamental enzymes that keep our cells working are found in only slightly
different forms in creatures as varied as zebrafish, fruit flies, yeast, and
nematode worms. This is partly why studies on model organisms can teach us so
much about our own biology.
Example
These organisms all use very similar metabolic pathways
Metabolic pathways (such as cellular respiration) are nearly universal.
These organisms all use similar pathways.
-
Each pathway contains multiple intermediate products, and
there are small molecular differences between the intermediates.
Pathways proceed in “baby steps.” A chemical change that can be written and
balanced as a single reaction may, in a real pathway, require dozens of
reaction steps!
A sample metabolic pathway
 This pathway shows the production of the end product “D” from the starting substrate
“A.” In this reaction, A is the substrate of enzyme 1, which produces B.
Enzyme 2 then uses B as its substrate to produce C. Enzyme 3 then uses C as
its substrate to produce D.
This pathway shows the production of the end product “D” from the starting substrate
“A.” In this reaction, A is the substrate of enzyme 1, which produces B.
Enzyme 2 then uses B as its substrate to produce C. Enzyme 3 then uses C as
its substrate to produce D.
-
Each step within the pathway, or the conversion from one
intermediate to the next, is catalyzed by an enzyme. Thousands of
enzymes catalyze reactions in human cells. Each enzyme conducts a single
chemical reaction. The coordination of many enzymes working together can
produce a variety of outcomes.
Another sample metabolic pathway
 Each enzyme within the pathway is specific to
one reaction. The coordinated effort of many enzymes can produce a variety
of final products.
Each enzyme within the pathway is specific to
one reaction. The coordinated effort of many enzymes can produce a variety
of final products.
-
Each pathway is regulated to ensure the optimal use of
resources and to maintain the health of the cell. For example, if
there is plenty of ATP in a cell, the cellular respiration pathway (which
produces ATP as its final product) will slow down. In a complex web of cause
and effect, pathways influence themselves and each other. The net effect in
a healthy cell is the maintenance of homeostasis. Stockpiles of raw
materials, intermediates, and finished products are maintained at optimal
levels, and the chemistry of the cell cytosol is also regulated, as are extracellular fluids.
Many metabolic pathways are reversible, which means that certain chemical
reactions can go “either way,” depending on the needs of the cell. For
example, some of the reactions that are part of cellular respiration (which
is a catabolic pathway) can become anabolic when there is a surplus of
energy. A small number of steps utilize different enzymes in the forward
versus the reverse direction. These enzymes are regulated in a coordinated
fashion such that a pathway operates in only direction at time.
Catabolic and Anabolic Reactions
 Animals use fats and complex carbohydrates such as glycogen for long-term energy
storage. When energy is needed, catabolic pathways degrade lipids and
glycogen to glucose or other intermediates of the cellular respiration
pathway, resulting in ATP production. When there is excess ATP (for example
after eating a meal rich in fats and sugars), parts of the cellular
respiration pathway go “in reverse” to provide building blocks for the
anabolic reactions building up lipids and glycogen.
Animals use fats and complex carbohydrates such as glycogen for long-term energy
storage. When energy is needed, catabolic pathways degrade lipids and
glycogen to glucose or other intermediates of the cellular respiration
pathway, resulting in ATP production. When there is excess ATP (for example
after eating a meal rich in fats and sugars), parts of the cellular
respiration pathway go “in reverse” to provide building blocks for the
anabolic reactions building up lipids and glycogen.
At the heart of metabolism are enzymes. These proteins embrace substrates, quickly
generating products. One or more substrates bind to an enzyme’s active site. As a
result, activation energy is reduced and the reaction proceeds much more quickly than it
otherwise would. Without enzymes, metabolism would grind to a halt. Furthermore, the
structural characteristics of enzymes allow the regulation of
their function, thus allowing the regulation of the metabolic pathways they participate
in. You may want to review the functions of
enzyme proteins.
Metabolic pathways are regulated in order to maintain maximum efficiency or in response
to environmental changes.
There are two major methods of pathway regulation. The first method involves changing the
amount of the enzymes in the pathway. Since the reactions are catalyzed by the enzymes,
if the enzyme is not present, the pathway is effectively shut off. Enzyme levels are
usually altered by controlling the amount of mRNA produced from the gene that encodes
the enzyme. You will explore how enzyme levels are regulated in the section on
transcription.
Regulation of pathways by altering the amount of enzymes in the pathway is usually too slow to
meet the second-by-second regulation needs of the organism. Consequently, many pathways
are regulated by increasing or decreasing the activity of an enzyme due to the binding
of a small regulatory compound. Typically, only a few steps in the pathway are
regulated, and the regulated steps typically occur near the beginning of the pathway to
prevent the accumulation of intermediates, which are seldom of use to the cell. Think of
an assembly line: the speed of production will change depending on how much of the
starting material is available, how quickly each of the workers completes the task, and
how much of the final product is needed. Similarly, pathways are influenced by the
availability of the starting materials, the activity of each enzyme in the pathway, and
the concentration of product already present in the cell.
Example
Glucose and Cellular Respiration
Let’s look at an example of a metabolic pathway and explore one mechanism that regulates it.
You may remember that cellular respiration is an essential catabolic pathway.
Cellular respiration starts with a pathway called glycolysis, which
degrades three-carbon glucose into a three-carbon molecule called
pyruvate. Glucose can come from ingested carbohydrates, or from
degradation of glycogen, a polysaccharide. When there is an excess of carbohydrates,
they are stored as glycogen in an anabolic pathway.
 Glycolysis is the first stage of cellular respiration, in which glucose is degraded to
a three-carbon compound called pyruvate. In this process, ATP is formed. As with
all pathways, glycolysis has several steps. The on-off switch of the pathway is
found at the third enzyme (represented by a traffic light), which is inhibited
by high levels of ATP. Synthesis and degradation of glycogen, a polymer of
glucose commonly found in animal cells, occurs through an early intermediate of
glycolysis.
Glycolysis is the first stage of cellular respiration, in which glucose is degraded to
a three-carbon compound called pyruvate. In this process, ATP is formed. As with
all pathways, glycolysis has several steps. The on-off switch of the pathway is
found at the third enzyme (represented by a traffic light), which is inhibited
by high levels of ATP. Synthesis and degradation of glycogen, a polymer of
glucose commonly found in animal cells, occurs through an early intermediate of
glycolysis.
Six general mechanisms can regulate the rate of each step in a pathway. The mechanisms
differ in how rapidly they can respond to changes in the environment. Each of them is
discussed below, with the more rapid forms of regulation at the top of the list.
-
Substrate availability. If the substrate concentration increases, the
rate of a reaction will increase. Put simply, substrates must collide with enzymes
to initiate binding. Such collisions will occur more often if the substrate is
highly concentrated. Note that too much of the substrate can saturate the enzyme, so
above a certain amount of substrate, the reaction speed will not increase
anymore.
-
Competitive inhibition. An inhibitor “competes” with the substrate for
the active site. If the inhibitor binds first, the substrate is blocked from
entering and the enzyme is inhibited (cannot complete any reactions). Competitive
inhibitors are often used as drugs to block an undesirable metabolic pathway. For
example, sulfa antibiotics are competitive inhibitors of the bacterial pathway that
produces folic acid, an essential molecule for nucleic acid synthesis. Products of a
reaction are often competitive inhibitors, because they bind to the active
site.
-
Noncompetitive control. This mechanism is similar to competitive
control, except in this case substances bind to a site away
from the active site. Binding can either enhance or inhibit the enzyme’s function by
changing the shape of the active site. This is the example that you saw above with
glycolysis.
-
Feedback inhibition. Both competitive and noncompetitive controls are often
set up so that a product inhibits its own production by inhibiting enzymes at an
early step in the synthesis process. This regulates the pathway: the product “turns
off” its own production by inhibiting an enzyme on its own “assembly line.” This
prevents the overproduction of a substance and also prevents the waste of resources
on unnecessary intermediate products. Feedback inhibition is observed
when a product inhibits an earlier step in the pathway. Product inhibition occurs
when the product inhibits the enzyme that was directly involved in making that
product.
-
Modification of the enzyme. Chemical modification of enzymes (such as
adding a phosphate group) can cause a change in the shape of the active site of the
enzyme. The change may either increase or decrease enzyme activity. This is similar
to noncompetitive control, except in this case the enzyme is chemically modified and
control does not involve the binding of a large molecule to the enzyme.
-
Changing enzyme concentrations. Enzyme levels can be increased by 1)
conversion of inactive forms of the enzyme to active forms, or 2) regulating the
synthesis of the enzyme. An example of the former is blood clotting, where inactive
precursors of clotting enzymes become activated, in a cascade, by blood vessel
damage. This permits a very quick response to bleeding: all the necessary factors
are present and require only an activating signal. Similarly, many digestive enzymes
are activated only when they reach their destination (for example, gastric fluid of
low pH). Elsewhere they are inactive — and thus do not digest the organ that
secretes them. It takes longer to adjust enzyme levels by regulating the activity of
genes that produce them. Such changes are most often seen in response to longer-term
changes in the environment. For example, bacteria turn genes for digestive enzymes
on and off depending on the nutrients that are available to them. Many animal genes
are produced only during certain stages of development.
In summary, metabolic pathways are dynamic processes, continuously changing in response
to environmental changes and cellular (or organismal) needs, while avoiding waste of
resources. How much substrate or enzyme is available will determine the rate of
reactions. Moreover, extreme “fine-tuning” of metabolism is possible through changes in
enzyme activity due to the binding of inhibitors. This is a prime example of the
relationship between structure and function.
To this point, you have learned much about how pathways work. They proceed as a series of
steps catalyzed by enzymes. They are regulated by factors that modify enzymes or alter
the expression of genes.
In living organisms, metabolic processes are tightly regulated under normal conditions.
The cell, and the organism as a whole (e.g., the human body), tend to respond to
external influences in ways that maintain a relatively stable internal environment. This
ability or tendency is called homeostasis and depends on a complex set of
stabilizing responses.
Cells live in dynamic environments. Therefore, it takes work to keep conditions stable in a
cell. Precise regulation enables the cell (or body) to establish consistent internal
conditions. Factors like pH, ion concentrations, and levels of various substrates and
products are held within narrow bounds. This unique environment allows a diverse set of
reactions to take place. Many of these chemical reactions are essential for life and all
of them help maintain overall health.
Applications of Metabolic Regulation to Human Health
You had to work at staying upright because your body was in motion. In the cell
or inside a body, countless dynamic processes are running at once. Many of them
could easily disturb internal chemistry and throw things out of whack. So could
changes in the external environment. As a result, many levels of regulation are
constantly at work within your body, keeping internal processes balanced and
compensating for external changes.
These concepts are not just academic, textbook issues. To the contrary! Many of
today’s most challenging health problems center on the regulation of metabolism.
The loss of proper regulation can result in a number of diseases or disorders.
Substances that inhibit enzymes in a central pathway can have deadly effects for
the cell or organism. For instance, the potent poisons cyanide and arsenic are
inhibitors of cellular respiration. Lack of regulation, or dysregulation, of
metabolic pathways can lead to serious diseases. Examples include
phenylketonuria (PKU), Tay-Sachs disease, galactosemia, and maple syrup urine
disease. Each of these is an inherited condition in which an altered gene
produces an enzyme that does not function normally. As a result, metabolism is
disrupted and health problems occur.
On the other hand, drugs often target metabolic pathways to correct diseases. For instance,
angiotensin-converting enzyme (ACE) inhibitors are drugs that are commonly used
to control high blood pressure. These drugs inhibit ACE; the result is reduced
production of angiotensin, a molecule that increases blood pressure.
Many humans are able to maintain a stable adult body weight over a large number of years.
Although it may seem perfectly normal, this is an amazing feat of metabolic regulation.
As you eat, foods are broken down and metabolized. But the energy stored in the food’s
chemical bonds cannot be destroyed. Simply put, if more calories are consumed than are
required for growth, activity, and maintenance, the excess energy is stored within the
body. This energy is stored when enzymes catalyze the formation of new chemical bonds to
create specific kinds of macromolecules (i.e., glycogen, fat, and protein), which tends
to increase overall body mass. On the other hand, if not enough food calories are
consumed, the body will begin to break down its own tissues as a source of energy, and
will decline in mass as a result.
Note that when “calories” are being discussed in reference to food consumption, the word
"calorie" actually refers to a kilocalorie. One kilocalorie is the amount of energy
required to raise the temperature of one kilogram of water by one degree Celsius. It is
the unit typically used when discussing human nutrition and energy balance. For your
reference, a typical adult male requires about 2,500 calories per day; a female of
average size might require 2,000 calories daily. The body’s calorie requirement declines
with age, and depends on many factors, including body size, sex, and physical
activity.
As you have seen, the balance between caloric intake and output must be held within
narrow limits to maintain a steady body weight. Yet some humans do this without
conscious effort. How does this remarkable balancing act work?
First, consider what happens over the course of a typical day. After a meal, extra calories are
initially stored in the liver and muscles as glycogen (a complex carbohydrate). Glycogen
is broken down and used to supply glucose for intense exercise, and to provide glucose
while we sleep. Breakfast provides fuel to rebuild some of the body’s glycogen stores
that were depleted overnight. Thus, over short time scales, glycogen storage is an
efficient way to provide glucose when it’s needed between meals.
Over longer time periods, body fat is used to store excess energy. When glycogen stores are
full, the body switches over to storing the excess energy as fat. Remember that energy
is stored within chemical bonds, and so it is the chemical bonds within glycogen and fat
molecules that contain energy. Fat is an efficient way for the body to store extra
calories, because it is able to pack more calories per unit mass when compared with
carbohydrates or proteins (see Figure 8.2 below). You can think of body fat as a
long-term, highly compacted energy reserve.
Fat Stores Maximum Energy per Unit of Mass
 At 9 kilocalories per gram, fat stores more than twice as much energy
per unit mass than proteins or carbohydrates.
At 9 kilocalories per gram, fat stores more than twice as much energy
per unit mass than proteins or carbohydrates.
Regulation and Human Health
How are caloric intake and energy output balanced? Your levels of hunger and
overall metabolic rate change in response to your nutritional status. When your
stomach is empty, a hormone called ghrelin is secreted. This acts on receptors
in the brain to stimulate feelings of hunger. When the stomach is full, ghrelin
secretion stops and so do your cravings for food.
If a person takes in less calories than required for maintenance and activity,
glycogen reserves are broken down first. This leads to rapid weight loss early
on, because each gram of glycogen associates with up to four grams of water. As
glycogen is broken down, water is released in urine. Most of the initial weight
loss is actually “water weight.”
Later weight loss comes more slowly, because body fat stores a great deal of energy and is
associated with much less water. Importantly, body fat is not just a storage
bin. It also has a role as an endocrine (hormone-secreting) organ. For example,
body fat secretes a hormone called leptin. This acts on target cells in the
brain to produce feelings of “fullness.” Loss of body fat leads to decreases in
leptin and increasing feelings of hunger. Second, loss of weight also has
effects on a person’s energy output. As a person loses weight, total metabolism
goes down simply because the body is getting smaller. More significantly, the
per-pound rate of metabolism is turned down to conserve
energy and resist what the body perceives as “starvation.” A person in this
state will feel sluggish and reluctant to exercise. Taken together, these and
other mechanisms tend to automatically adjust our hunger and activity to
maintain our weight.
When Regulation Goes Haywire: Obesity
Obesity is a condition in which body fat is excessive and interferes with normal function or
impairs health. Obesity can make many physical activities difficult or
impossible. It is associated with many increased health risks; type II diabetes
(see below), hypertension, and heart disease are three serious conditions that
are clearly more common among obese people than their normal-weight peers. Obese
people also suffer socially and professionally because of weight-related bias
and discrimination.
Why don’t the normal regulatory mechanisms work to limit weight in people who
become obese? This is a question that has fueled considerable research and
debate. Findings suggest that there are many contributing factors. For example,
many (but not all) obese individuals have very high circulating levels of leptin
in keeping with their high body fat reserves. Yet the target cells in their
brains do not respond to leptin in the normal way; they do not perceive
satisfaction or fullness.
Obesity may result from a mismatch between our evolutionary adaptations and the realities of
the modern world. We expend less calories each day on physical tasks than did
previous generations of humans. More than 100 years ago, the average person may
have expended 30 percent to 50 percent more calories each day than a typical
modern American. In addition, today we have continuous access to an
unprecedented array of calorie-rich foods. In times past, when food was scarce
and could not be preserved easily, it was adaptive to feast on rich foods when
they were available. Those who did so could build up fat and glycogen reserves,
and thus were more likely to survive famines. Today, in a changed environment,
the same behaviors predispose us to obesity.
Solutions to Obesity?
Our society’s main effort to overcome obesity has come in the form of dieting. Diet fads
constantly come and go — Atkins, South Beach, Acai Berry, the Hollywood diet,
and pills, drinks, or even machines that purportedly melt away fat. In fact, the
total sales of weight loss services and products were estimated at over $55
billion in 2009. Unfortunately, all of this effort and expense does not appear
to do much good. Surveys, clinical trials, and literature reviews have
repeatedly turned up a depressing pattern: about 80 percent of dieters regain
lost weight within one to five years — and very often shoot past their prediet
weight with each cycle.
If crash dieting is a bad idea, and we are “hardwired” to overeat, is there any
hope for solving the obesity problem? Yes, there are many efforts in this
direction.
-
Medical approaches: For the extremely obese, surgical options that
reduce the size of the stomach are often effective. These procedures may
work partly by reducing the stomach’s output of ghrelin, thus reducing the
hunger pangs associated with an empty stomach. Some drugs also show
promise.
-
Behavior change: Much research is now exploring how different
practices — emotional support groups, healthy cooking classes, and more —
can help obese people make small, sustainable changes to their lifestyles
for weight control and better health.
-
Societal change: Many are trying to reduce obesity by building parks
and bike lanes, taxing snack foods and sugary sodas, changing school lunch
menus, expanding physical education classes, posting calorie counts in
restaurants, and much more. These efforts are meant to change the overall
social and physical environment to encourage more physical activity and less
intake of calorie-rich foods.
In this unit [1] , you will learn about another major cell process — cell division, or
cell reproduction. The word "reproduction" is used in many different scientific and
nonscientific settings. Regardless of the setting, though, reproduction has the same
basic meaning. Reproduction is defined as "the act of making a copy of the original."
With this in mind, the word reproduction can be applied to many different situations.
Some of these include parents having a baby, you photocopying a page in your textbook,
and a museum staff member making print copies of a famous oil painting.
In each case, a relatively close copy of the original has been made. The same principle
applies in cell reproduction—making new cells that closely resemble the original cell.
Cell reproduction is a complex process that involves many intricate, highly regulated
steps. Like metabolism, each of these steps must occur in a
particular order.
Cell reproduction is important for three reasons:
- It provides new cells for growth, the replacement of dead cells, and healing.
- In cells, it ensures the inheritance of genetic information from parent cell to
offspring cell.
- In organisms, it ensures the inheritance of genetic information from one generation
to the next.
In this unit, you will learn about how cells carry out these critical processes. Your
understanding of the information this unit will lay the foundation for understanding
heredity and molecular genetics.
References
-
. Course materials for the "Cell Division" unit provided courtesy of
the University of Maryland University College under the CC-BY-NC license.
Somatic Cells, Germ Cells, and Gametes
Why do cells divide? Cells undergo different phases, during which they grow, duplicate their
genetic material, and then divide. In single-celled organisms, cell division results in two new
individuals. Cell division in multicellular organisms is more complex. Most
cells in multicellular organisms are somatic cells.
Somatic cells consist of all the nonreproductive cells in an organism; for
example, tissue cells, nerve cells, and blood cells. When somatic cells divide,
they go through the process of mitosis, which is a type of
cell division that results in two identical daughter cells.
Meiosis, on the other hand, is a type of cell division that
prepares an organism for sexual reproduction. Meiosis begins with germ
cells. Be careful not to confuse “germ cells” with the
common use of the word “germ,” which refers to any infectious microorganism. In
humans, germ cells are found in the ovaries and testes. These germ cells go
through the process of meiosis to produce gametes, which
in animals are sperm and egg cells. When two gametes from different individuals
combine, a unique new cell is produced, called a zygote.
This single cell then goes through the process of mitosis to grow into a new
individual.

You might be wondering how a single cell can grow into a complex adult organism
containing many different cell types simply by mitosis. This happens through a
process known as differentiation, in which certain genes found in a
cell’s nucleus are turned on or off. Even though every single somatic cell in
your body contains identical DNA, these cells were able to differentiate into
specific cell types (such as blood cell, liver cells, etc.) simply by turning
certain genes on or off. Throughout our lives, we continue to produce more
genetically identical cells through the process of mitosis. These somatic cells
are essential for growth and replacement of worn-out cells and tissues.
Mitosis and Meiosis: Role in Human Growth
 By University of Maryland University College CC-BY-NC.
By University of Maryland University College CC-BY-NC.
Mitosis and meiosis are the processes by which cells divide and grow; their role
in human growth is summarized in the diagram above.
References
-
. Graphics and text on this page provided by the University of Maryland
University College under a CC-BY-NC license.
Chromosomes are thread-like structures located inside cells. In eukaryotic
cells, the chromosomes are contained inside an organelle called a
nucleus . In
prokaryotic cells, they are located in a particular area
of the cytoplasm. Chromosomes are made up of two major parts:
DNA and proteins. Both DNA and proteins are
large molecules. Envision the general makeup of a
chromosome, as shown in the following diagram.
 By University of Maryland University College CC-BY-NC.
By University of Maryland University College CC-BY-NC.
DNA is the molecule that stores and transmits inherited genetic
information. This information includes the directions that tell a cell how to make
proteins. Information is stored in DNA in segments called genes.
In the diagram above, the ruler represents the entire DNA molecule. The genes are
represented as short segments of the ruler. You will learn more about the structure and
function of genes in the Molecular Genetics unit.
The blobs of clay in the diagram above represent histone protein
molecules. These proteins associate with DNA in a very precise way.
First, they couple with DNA at regularly spaced intervals. Notice in the diagram above
that the blobs of clay (histones) are located at equally spaced intervals along the
ruler. Second, they help to wind the DNA molecule into an organized and compact
structure. The following diagram shows how histones wind DNA into a compact structure
called a chromosome.
The winding function of histones plays a very important role in cells. It allows the DNA to be
condensed into organized bundles (chromosomes) that can easily be moved around the cell.
Because the DNA is wound around the histones in such an organized way, the DNA can be
easily wound up and unwound at various points during the cell cycle. For example,
chromosomes must unwind slightly when a new copy of DNA is made. Then, the chromosomes
become very tightly wound as the cell gets ready to divide during mitosis or meiosis.
Without an organized compaction system, the long pieces of DNA in chromosomes could
easily become "knotted" and tangled. Think of a long piece of string. Knots can easily
form in the string if it is not carefully wound up into a ball. Keeping the DNA
organized is critical, especially when you consider that the DNA in one human cell is
three feet long when it is stretched out straight. This is quite amazing when you
realize that this must fit into a cell so small that it cannot be seen with the naked
eye. This feat is achieved by two different winding processes. One of these is the
winding of DNA around histone molecules. As a result of this winding, the DNA molecule
becomes shorter than before it was wound around the histone molecules.
Winding DNA into Condensed Chromosomes
The videos below are two illustrations of the winding of DNA around histones. The left video
shows the DNA strand coiling and condensing to form chromosomes; on the right, a
model depicts the structure of DNA.
Now look at an image of the relationship between DNA and histones in
chromosomes that is more realistic than what is shown in our ruler-and-clay diagram
above. When the DNA becomes tightly wound around the histone
proteins, imagine that the chromosome looks as illustrated below.
References
-
. Graphics and text on this page provided by the University of Maryland
University College under a CC-BY-NC license.
The chromosomes in somatic cells and germ cells
are present in pairs. One chromosome in each pair is descended from the organism's
father. The other chromosome in the pair is descended from the organism's mother. Each
member of a chromosome pair is called a homologue. Together, these
two chromosomes make up a pair of homologous chromosomes. The
words homologue and homologous both begin with the prefix "homo-," which means "the same
or similar." So the two chromosomes in each pair contain the same set of instructions.
The following diagram shows the relationship between homologues and homologous
chromosomes.

Somatic cells produced through mitosis are diploid.
“Di-” means “two,” and diploid cells contain two copies of every chromosome.
Chromosomes are the condensed form of
chromatin, the combination of DNA and proteins that fill
the eukaryotic nucleus. Humans have a total of 46 chromosomes in their diploid cells.
One way to write this is "2n = 46." Humans who have more or less than 46
chromosomes sometimes survive, but usually have life-altering conditions, such as Down
syndrome. Down syndrome is caused by having three copies of chromosome 21, instead of
the usual two copies.
Gametes are haploid cells. They contain only one copy of each chromosome. In human
haploid gametes, there are 23 chromosomes. One way to write this is "1n = 23."
As you learned in the previous activity, two haploid cells can combine, through the
process of fertilization, to form a diploid zygote. The diploid zygote then goes through
mitosis to form the diploid somatic cells of the organism.
Remember that germ cells, found in the ovaries and testes, give rise to gametes. In
other words, germ cells go through meiosis to produce gametes. Germ cells are diploid
cells. When they go through meiosis, the end result is four unique haploid daughter
cells. These haploid cells can be fertilized by other haploid cells to produce diploid
cells again.
Number of Chromosomes in Diploid and Haploid Cells
 By University of Maryland University College CC-BY-NC.
By University of Maryland University College CC-BY-NC.
The table below summarizes the characteristics of somatic cells, germ cells, and gametes.
References
-
. Graphics and text on this page provided by the University of Maryland
University College under a CC-BY-NC license.
Every living organism goes through various stages of development. For example, human beings go
through these stages of development: fetus, infant, child, youth, teenager, young adult,
adult. Remember from earlier that cells are living things. They, too, go through a set
of programmed stages.
The cell cycle is the "life cycle" of a cell. It is the set of stages that a cell goes through
during its lifetime. Cells go through five major stages of development: G1, S, G2, M,
and cytokinesis. The events that occur during stages G1, S, and G2 are nearly the same
in all types of cells. Together, these three stages of the cell cycle are called
"interphase." The events that occur during stages M and cytokinesis are different,
depending upon the type of cell. The diagram below shows an overview of the stages in a
cell's life cycle:
Overview of the Cell Cycle
 By University of Maryland University College CC-BY-NC.
By University of Maryland University College CC-BY-NC.
Notice in the diagram above that we start with one cell on the left side. This is called the
parent cell. It is called this because, like a human parent, it reproduces—it makes new
cells that are copies of itself. The parent cell goes through the five stages of
development in this order—G1, S, G2, M, and cytokinesis.
At the end of the development process, two new cells are produced. These cells represent
the next generation of cells in this lineage (just as your parents represent one
generation and you represent the next generation). Each of the new cells is called a
daughter cell. Do not be confused by the use of the word daughter—it does not mean that
these are female cells. Regardless of whether they are male or female cells, the newly
produced cells are called daughter cells.
Notice that the parent cell no longer exists—but the parent cell did not die. Rather, the
contents of the parent cell have been split into two new cells. Each of the new cells
contains a portion of the original parent cell. Previously, we compared the cell cycle
to the phases of human development. Notice here a very important difference between the
two: The far end of human development is marked by the death of the individual. The end
of the cell cycle, however, results in the formation of new cells.
In the diagram "Overview of the Cell Cycle" above, look closely at the parent cell and the two
daughter cells. Notice that they look the same. Once again, we revisit the theme of
cycles in nature that we discussed above. The cycle generates cells that resemble the
cells we started with. In addition, the new cells undergo the same
development-and-division process that their parental cell did. For these two reasons, we
call this the cell cycle, and draw it like a circle. Similarly, human beings have
children, who then have children themselves. (You may have heard this called the circle
of life.) Cells do the same thing through the cell cycle. The following diagram shows
the cell cycle in circular form.
Overview of the Cell Cycle
 By University of Maryland University College CC-BY-NC.
By University of Maryland University College CC-BY-NC.
References
-
. Graphics and text on this page provided by University of Maryland
University College under a CC-BY-NC license.
In cell replication, chromosomes are moved to new locations. Like packing household materials
into a box before moving, condensing the chromosomes helps with this process.
Chromosomes are condensed by wrapping them more tightly around
histones (proteins found in the nucleus).
If a cell is going to reproduce, more DNA is needed. During
mitosis, one cell divides into two cells containing
identical genetic material. This requires twice as much DNA, because there must be one
complete set for each daughter cell. Meiosis also requires the DNA
to be replicated. DNA replication (or DNA synthesis) occurs in the synthesis
(S) stage of the cell cycle.
After a chromosome has replicated, the two copies remain attached
at a point called the centromere. Each copy of the chromosome is
called a chromatid.
Before cell division, DNA is copied and condensed.

During cell division, each chromatid moves to one of the two daughter
cells. Keeping the two copies of a single chromosome attached helps the sorting process.
In human cells, there are a total of 46 chromosomes. After the S
stage of the cell cycle, these chromosomes have replicated and there are now 92 total
pieces of DNA. The process of mitosis must sort these into 2 identical piles of 46
chromosomes. The cell keeps the matching pairs attached to keep track of which
chromosomes need to be sent to opposite poles.
This is rather like sorting a sock drawer. If all the socks are loose in the drawer, it
can be challenging to find the identical mate to a sock. But if the sock mates are
folded together, each bundle contains both mates in the set.
Overview of Mitosis
 By University of Maryland University College CC-BY-NC.
By University of Maryland University College CC-BY-NC.
Both mitosis and meiosis must keep track of the
chromatids on a chromosome. In the Meiosis module, you will learn that meiosis must also
keep track of homologous chromosomes. A diploid cell has two
copies of each chromosome — one copy from each parent. These chromosome pairs are called
homologous because they have the same genes, but may have
different versions of that gene. For example, a homologous pair of chromosomes may have
a gene for hair color. One chromosome in this homologue may contain a “blond” version of
that gene and the other homologue may contain the “brown” version. Each gamete that is
produced will get either the homologue with the brown version or the homologue with the
blond version.
References
-
. Graphics and text on this page provided by the University of Maryland
University College under a CC-BY-NC license..
Growing from a single fertilized egg to an adult organism requires many rounds of cell
division. Before cell division, a cell must copy its
genome so that each new daughter cell receives a full
set of DNA. This DNA replication occurs in the
synthesis (S) stage of the cell cycle just prior
to mitosis. The process of mitosis sorts the DNA equally
into two separate nuclei. The process of mitosis is divided into the following
steps or phases:
-
Prophase and Prometaphase: The cell prepares to
sort the chromosomes.
-
Metaphase: Chromosomes are moved to the center of the cell.
-
Anaphase: Chromosomes are sorted.
-
Telophase: The new nuclei are formed.
Each new cell gets one of these nuclei during the process of
cytokinesis. At the end of mitosis and
cytokinesis, each new daughter cell should have
the identical genetic makeup of the parent cell. Mitosis of a single
diploid cell will result in two diploid cells with
identical genomes, unless a mutation or other error occurred. Mitosis of a
haploid cell will result in two identical haploid
cells. These cells can go through the process again to reproduce.
Interphase: Duplicates DNA
Let’s begin with a diploid cell that is 2N = 4. This cell has two copies of each
of its two chromosomes. During the S phase of interphase, the cell
replicates its DNA. This results in two sister chromatids that are attached to
each other at the centromere. The chromosomes have not condensed enough at this
point to be visible with a microscope.
Centrosomes are also formed during interphase. Centrosomes are used to identify the poles of
the cell during the division process; these poles determine where the
chromosomes will be sent.
Prophase
Mitosis begins when DNA condenses into chromosomes visible under a light microscope. This
packaging of the chromosomes into condensed bundles makes them easier to sort,
but it inhibits protein synthesis. Therefore, it is essential that the cell has
produced all necessary proteins prior to the start of this process.
The nucleoli disappear and the nuclear envelope begins to disintegrate.
This allows cellular components to act upon the chromosomes (the chromosomes are
no longer tucked away inside the nucleus).
Centrioles, contained in the centrosomes formed during interphase, are areas where
microtubules originate in order to help sort and organize the sister chromatids.
The centrioles begin to move to the opposite poles of the cell. This will
determine where the chromosomes go when they are sorted.
Microtubules are disassembled from the cytoplasm and reassembled into the mitotic
spindle. This structure will move the chromosomes to the proper location.
This stage is called “prophase,” because it is a preparatory stage. “Pro-” means
"before;" “phase” means “stage.” So, this is the stage before the process gets
into full swing.
Prometaphase
Prometaphase is the stage between prophase and metaphase. During this stage, the nuclear
envelope is fully broken down. This allows the microtubules to attach to the
centromeres of the chromosomes.
The centromere is the region in the center of the X-shaped chromosomes. Each half of the X is
a copy of the same DNA strand. The centromere contains proteins that hold
together these two copies and can bind to the microtubules. The proteins on the
centromere are called the kinetochore, and the microtubules that attach to them
are called kinetochore microtubules. The microtubules that are not attached to
the kinetochores are called nonkinetochore microtubules.
Metaphase
Metaphase is so named because the chromosomes line up in the middle of the cell. The root
“meta-” means “middle.”
The kinetochore microtubules are used to orient the chromosomes in the center of
the cell. Each chromosome will be attached to two kinetochore microtubules. Each
of these kinetochore microtubules will be attached to one of the two
centrioles.
Anaphase
During anaphase, the kinetochore proteins break down the microtubules attached to them and
the connections between each copy of the chromosome will be broken down. This
causes the individual chromosomes to move to opposite poles of the cell. The
root “ana-” refers to “apart”; the chromosomes are moving apart from each
other.
The nonkinetochore microtubules from one pole also push on the nonkinetochore microtubules
from the other pole. This causes the cell to elongate. By the end of anaphase,
each pole of the cell contains an identical set of chromosomes.
Telophase
In telophase, the nuclei at each pole form again. The chromosomes are now separated into two
identical nuclei. This is the end of mitosis.
However, the two nuclei are still in a single cell. The next step will separate
the cytoplasm into two cells. “Telo” comes from the Greek word for “end.”
Cytokinesis
Cytokinesis is the separation of the cytoplasm into two new daughter cells.
Animal cells divide when proteins pinch in the center of the cell until it
separates into two. This region is called the cleavage furrow.
Plant cells divide when new cell wall components are laid down in the center of
the cell. This is called the cell plate.
Use the activities on this page to review the process of mitosis. Do the activities as
many times as you’d like, until you feel comfortable with the whole process.
The cell cycle is highly regulated. There are many checkpoints that are used to determine if
the cell should or should not continue through the stages of the cell cycle. Many
different environmental and internal signals are involved in determining whether or not
a cell will complete division.
 Checkpoints occur throughout the cell cycle. These checkpoints control whether
or not a cell will continue dividing. Image adapted from a diagram by
LadyofHats: Mariana Ruiz Villarreal in the public domain.
Checkpoints occur throughout the cell cycle. These checkpoints control whether
or not a cell will continue dividing. Image adapted from a diagram by
LadyofHats: Mariana Ruiz Villarreal in the public domain.
A healthy cell has many genes that produce proteins involved in the process of regulating cell
division. Some of these genes produce proteins that encourage cell division. These
proteins would be produced under circumstances where the cell should divide. For
example, if you scrape your knee, the cells in that area need to be replaced. Other
genes produce proteins that inhibit cell division. For example, healthy human cells
grown on a petri dish would stop growing when they filled the dish. This is also an
essential component of regulation. Cells that continue dividing when they should not can
cause cancer.
 Cancer cells do not respond to proper regulatory signals and divide when they
should not divide. Image from the
National Cancer Institute in the public domain.
Cancer cells do not respond to proper regulatory signals and divide when they
should not divide. Image from the
National Cancer Institute in the public domain.
Numerous research projects in the past and present are investigating cell cycle genes. Some of
these research projects are focused on cancer treatments and cures and others are
focused on understanding the biology of this process. Because much of this research is
focused on cancer, the terminology used is generally focused on relationship to the
disease.
For example, genes that inhibit cell division are classified as tumor suppressor genes. If
these genes are working properly, a cell will not divide uncontrollably because these
genes will stop the process. Genes that encourage cell division are called
proto-oncogenes. If these genes are working properly, a cell will not receive the
message to divide unless it should be dividing.
Mutations could cause these genes to stop working properly. Mutations are errors in DNA that
can result from genetic predisposition or environmental factors. Mutagens are chemicals
in the environment that produce mutations. Carcinogens are specifically those mutagens
that have shown that they can cause cancer. Cigarettes, for example, contain carcinogens
that can alter the DNA and disrupt proper regulation of the cell cycle.
 Current efforts to decrease the use of cigarettes are correlated with a
decrease in lung cancer. Image from the
National Cancer Institute in the public domain. Chart illustrates a correlation
between smoking and lung cancer in US males, showing a 20-year time lag between
increased smoking rates and increased incidence of lung cancer.
Current efforts to decrease the use of cigarettes are correlated with a
decrease in lung cancer. Image from the
National Cancer Institute in the public domain. Chart illustrates a correlation
between smoking and lung cancer in US males, showing a 20-year time lag between
increased smoking rates and increased incidence of lung cancer.
The development of cancer requires mutations in BOTH proto-oncogenes and tumor suppressor
genes. A malfunctioning proto-oncogene is called an oncogene because it promotes the
development of cancer. The root “proto-” refers to "before" and the root “onco-” refers
to "cancer." A defective tumor suppressor gene can no longer suppress tumors. Cancer is
the result of numerous mutations in multiple genes involved in regulating the cell
cycle.
There are two ways for organisms to reproduce: asexual and sexual. Many organisms, such as
bacteria, fungi, and even some plants and animals reproduce asexually. During asexual
reproduction, all of the genes in a cell are passed to its daughter cells. This means
that the resulting cells are
clones, or identical copies of the parental cell.
Asexual reproduction is efficient and fast. However, it only provides one
set of genes to adapt to the environment. Think about trying to guess a number. Do you
have a better chance of guessing the number if you get one guess or if you get two
guesses? Sexual reproduction, in which the genes of two parents
are combined, results in more genetic variability. This enables offspring to deal more
successfully with environmental change. However, sexual reproduction is a more complex
process and results in a smaller number of offspring. Interestingly, certain organisms
that can reproduce both asexually and sexually will choose sexual reproduction only when
environmental conditions are not optimal. That way, a smaller number of more variable,
and thus more adaptable, offspring is produced. In optimal conditions, however, asexual
reproduction is the favored mechanism.
As you learned, genetic information is contained in DNA, which in
eukaryotic cells is bound to special proteins called histones. The combination of DNA
and histone proteins is called chromatin. During the S phase of
the cell cycle, the chromatin is loose, to facilitate DNA replication. Chromatin can
condense to form chromosomes during nuclear division. Chromosomes
have a typical appearance and can be organized in a karyotype.
Human Karyotype of a Male

Humans have 23 pairs of chromosomes (2n = 46). Of those 23 pairs, 22 are autosomes, and
the 23rd pair are sex chromosomes. Sex chromosomes can be of two
types: X and Y. Males have one X and one Y chromosome (XY), while women have two copies
of the X chromosome (XX).
In sexual reproduction, two reproductive cells called gametes fuse in the
process of fertilization. In order to avoid the duplication of the
chromosome number, gametes are formed through a special form of cell division,
meiosis, which halves the number of chromosomes. Cells
with a single set of chromosomes are haploid (n), in contrast to
the somatic (body) cells, which are diploid (2n). The fusion of
the gametes during fertilization restores the diploid chromosome number in the first
cell of the new individual, the zygote.
 By University of Maryland University College CC-BY-NC
By University of Maryland University College CC-BY-NC
In the human life cycle, haploid gametes produced during meiosis fuse to form a diploid zygote,
which goes through the process of mitosis to grow into an adult human. When the adult
human produces haploid gametes, the process can be repeated.
What Is Meiosis?
Germ cells are diploid cells that go through the process of meiosis to
form haploid gametes. This process can happen at different times, depending on
the organism. For example, in humans, the male gametes (sperm cells) are formed
continuously from germ cells in the testes, starting in puberty. Female gametes
(eggs or oocytes), on the other hand, are formed in the ovaries during fetal
life. They remain in the ovaries, “stuck” in the final stages of meiosis, which
is not completed unless fertilization occurs.
Meiosis achieves more than just halving the chromosome number. It also introduces
variability in the way the genes are distributed in the gametes. In diploid
cells, there are 23 pairs of homologous chromosomes. Each pair of homologues has
the same set of genes, though they can have different alleles (or
forms) of each gene. One homologue comes from your mother and the other comes
from your father. You may have inherited an allele for straight hair from your
mother and an allele for wavy hair from your father. When meiosis takes place,
the homologous chromosomes will separate, so one gamete will carry the allele
for wavy hair and the other for straight hair. Each trait on each chromosome
will segregate its two alleles in a completely random way. There are also other
additional ways of “shuffling the cards” of genes, which explains why siblings
from the same parents can be so different.
The Process of Meiosis
Let’s learn more about meiosis. Meiosis consists of two consecutive cell divisions, called
meiosis I and meiosis II. Both stages of meiosis consist of prophase, metaphase,
anaphase and telophase, just like mitosis. The phases are labeled I in meiosis
I, and II in meiosis II.
Meiosis I is often referred to as the reduction division, because it is during this stage
that the number of chromosomes in the parent cell are divided in half. Meiosis
II is extremely similar to mitosis, except that there are half as many
chromosomes.
Meiosis I: Crossing Over
An important feature of meiosis is the process called crossing over.
Crossing over is responsible for generating much of the diversity that exists
within a species. Remember that diversity in a species is one of the hallmark
characteristics of living organisms. In future modules, you will see that this
diversity allows species to survive in changing environmental conditions. So,
crossing over is another process that brings variability in the offspring.
Crossing over is a process in which genes swap positions on matching
chromosomes. The result is a new combination of genes on each chromosome.
 By University of Maryland University College CC-BY-NC
By University of Maryland University College CC-BY-NC
During metaphase I, homologous pairs of chromosomes line up on the metaphase plate. This is
very different from mitosis, when sister chromatids line up, completely
independent of their homologues.
During anaphase I, homologous pairs are pulled apart, and they move toward the poles of the
cell.
In telophase I, cytokinesis occurs and two new daughter cells are formed.
Meiosis II begins with two haploid cells, each containing too much DNA. The
events in meiosis II are almost identical to the events of mitosis.
In Meiosis II (which is essentially like mitosis), the sister chromatids separate from
each other. Thus, as the result of meiosis, four haploid cells are produced. Note that
those four cells are not always viable. In humans, male germ cells will produce four
viable sperm cells. However, in the case of females, only one of the four will survive
as an egg.
The end result of meiosis is four unique haploid daughter cells. Genetic variability is
introduced in various ways during meiosis:
- Crossing over during prophase 1: crossing over introduces novel combinations of
traits among offspring.
- Segregation of chromosomes into gametes: the maternal and the paternal copy of each
chromosome pair will segregate to different gametes. However, which goes to which
cell is a random process. Thus, the possible number of combinations is astounding:
in the case of humans, with 23 chromosomes, it is 223 (8,388,608).
When you add that fertilization is also a random process, you can get an idea of the
incredible number of combinations of possible offspring showing up even in one
family.
Comparing Mitosis and Meiosis
|
Mitosis |
Meiosis |
| Overall purpose |
The purpose of mitosis is to produce new somatic cells and germ
cells. These new cells are needed to: (1) increase the number
of cells in an organism during growth and development; (2) replace
damaged cells during wound healing; and (3) produce replacement cells as
other cells undergo naturally preprogrammed death. Mitosis must preserve the same chromosome number in the
parent and daughter cells. This is necessary for the parent and daughter
cells to be identical to one another. |
The purpose of meiosis is to produce new gametes (eggs and sperm).
These cells are needed for reproduction. Meiosis must reduce the chromosome number in the daughter cells to half
that in the parent cell. This is necessary for reproduction. when an egg
and sperm (each with half the full chromosome set) fuse during
fertilization, they create a single new cell with the full chromosome
set. |
| Starting cells (parental cells) |
Somatic cells |
Germ Cells |
| New cells made (daughter cells) |
Somatic cells |
Gametes (eggs in female; sperm in male) |
| Chromosome content of the parent cells |
Diploid (2n) |
Diploid (2n) |
| Chromosome content of the daughter cells |
Diploid (2n) |
Haploid (1n) |
| Effect on the chromosome number of the daughter cells |
Preserves the chromosome number from parent to daughter cells |
Cuts the chromosome number in half from parent to daughter cell |
| Number of cell divisions that occur |
1 |
2 |
| Number of daughter cells made |
2 |
4 |
University of Maryland University College CC-BY-NC
When the Chromosome Number is Not Right
Aneuploidy is a chromosomal abnormality characterized by an abnormal number of chromosomes in
a cell. It is caused by nondisjunction, which occurs when
chromosomes fail to separate properly during anaphase. Genetic problems caused
by nondisjunction can be diagnosed prenatally by studying the fetus’
karyotype. A karyotype is a visual representation
of the chromosomes of an individual, obtained from a small sample of cells. In
fetuses, this is usually obtained from sampling either the amniotic liquid
(amniocentesis) or the placenta.
Karyotype of a Normal Human Male
 Courtesy of the National Human Genome Research Institute
Courtesy of the National Human Genome Research Institute
In nondisjunction, chromosomes are not separated correctly during
metaphase I or II, resulting in gametes with too few or too many chromosomes.
There are many genetic disorders associated with incorrect chromosome numbers.
One of the most well known condition caused by nondisjunction is Down
syndrome. Down syndrome results from nondisjunction of chromosome 21,
resulting in a child with 3 copies of this chromosome (trisomy 21). Down
syndrome appears in approximately 1 of every 1,000 children, and older women are
at a higher risk of having babies with the condition. Chromosomal abnormalities
can include sex chromosomes also. For example, males with Klinefelter syndrome
have an extra X chromosome (XXY), and females with Turner syndrome have only one
X chromosome (X_). Both these conditions are relatively benign and can be
corrected with hormone treatment. Note that nondisjunction due to lack of
separation of sister chromatids can occur also during mitosis.
Why do children look like their parents? How do rose growers get so many different colors
of roses — pink, red, white, yellow, purple, peach, striped, and many more? How can
there be different-colored puppies within one litter?
 Inheritance is the way that organisms pass traits to their offspring. Because
offspring possess some (or all) of the genetic information from their parents, they
also share many traits in common with their parents.
Inheritance is the way that organisms pass traits to their offspring. Because
offspring possess some (or all) of the genetic information from their parents, they
also share many traits in common with their parents.
In the Cell Division unit, you learned that cells pass on a complete set of
genetic information (contained in the DNA), which is transmitted from parent cells to
daughter cells. This genetic information helps determine many of the characteristics of
the offspring. In humans, for instance, DNA is responsible for a
child’s height and skin pigmentation. It also helps determine the overall health of the
child by regulating many physiological characteristics, such as the condition of the
heart and lungs, as well as brain and blood chemistry.
How much of our physiological makeup is determined by genetics, and
how much is determined by other factors, such as personal choice and environment? This
question is a source of ongoing debate in both scientific and philosophical communities.
Environmental factors can influence our DNA, and our DNA can influence how we react to
environmental factors. If we are ever able to answer this question, the answer will
likely be complex.
In this unit, you will focus on the direct links between genetic information and visible
traits. This will help you to learn how genetic information can be passed from one
generation to the next and how these genes affect the later generation. We will
introduce simple examples of traits that are clearly visible and have a direct
correlation to genetics.
The Cell unit discussed the
components of the cell. One of these components is the DNA, which is
arranged into one or more chromosomes. Each chromosome contains many genes. A
gene is a region of a chromosome that has a specific function. For example,
genes can contain information required to make a protein. How this happens will be
discussed in the Molecular Genetics Unit.
DNA carries the information about how proteins are built, and proteins carry out many of
the reactions necessary for living organisms. The Proteins module discussed the variety of roles
proteins can play in a living organism. Some proteins produced by living organisms
determine the traits we can observe. These visible traits are called the
phenotype of an organism.
For example, protein enzymes in plants catalyze production of the pigments, resulting in
flowers of different colors. The color of the flower is one of the observable traits, or
the phenotype of the plant. The genetic information that produces these traits
is called the genotype of an organism. Depending on the pigment production, the
flowers can have red, blue, or white color. Flower color is determined by specific genes
in the cells. The variations in the same gene are called alleles. In our
example, different alleles of the pigment-producing gene can result in more or less
pigment, and, consequently, in darker or light flower color.
In this unit, you will learn about the genotype and phenotype of diploid organisms.
Diploid cells have two copies of each chromosome; haploid cells have only one copy of
each chromosome. Because diploid cells have two copies of each chromosome, they also
have two copies of every gene. One set of chromosomes (and, therefore, one copy of each
gene) is from the mother (or egg) and one set is from the father (or sperm). Diploid
cells can have two of the same alleles of a gene, or they can have two different alleles
of a gene. Cells that have the same allele are called homozygous (“homo”
meaning "same," and “zygous” referring to the reproductive cells produced from meiosis).
These cells are called homozygous because all of their reproductive cells
(gametes) will have identical alleles. Cells with different alleles are
called heterozygous (“hetero” meaning "different") because they will produce
reproductive cells that have different alleles of this gene.
When you studied meiosis, you learned about how gametes were formed. But how are
alleles dispersed into gametes through the process of meiosis? This activity
will help you answer that question as you review the essential components of
meiosis needed to understand inheritance. You may wish to review the
Meiosis
module prior to continuing with this unit.
 By U.S. National Library of Medicine (Gregor Mendel) Public Domain By U.S. National Library of Medicine (Gregor Mendel) Public Domain
|
Gregor Mendel was a nineteenth-century Augustinian monk in Bohemia, a country in
Europe that is now part of the Czech Republic.
In 1853, Mendel left the monastery for two years to study at the University of
Vienna, where he learned about mathematics and botany. When he returned to the
monastery, he began investigating how plants passed on their characteristics to
their offspring. He was conducting this research only a few years before Charles
Darwin published On the Origin of Species.
|
Mendel set out to understand inheritance by breeding pea plants. By collecting peas from
pods produced after fertilizing two parent pea plants, Mendel could then grow those peas
into new pea plants and see how these offspring resemble or differ from the parent
plants. The heritable characteristics that Mendel studied included seed color and shape,
pod color and shape, flower color and position, and stem length. Each of the traits that
Mendel studied occurs only in two forms, or phenotypes. For instance, pea flower color
is a trait that can exhibit either the purple phenotype or the white phenotype.
So if we know the phenotype, and we know that those two varieties would always result in
same-color flowers, we can deduce that all individuals (plants) in that population
(purple or white) have the same alleles for the gene that determines flower color.
Next, Mendel crossed the purple variety with the white variety. He manipulated his plants
so he could control which plant pollinated which. In plants, pollen is the male gamete,
landing on the flower to fuse with the ovule—the female gamete. The resulting zygote
will give rise to the seed, or embryo.
When Mendel crossed purple and white flowers, the first generation of plants, which he
designated “F1,” were all purple. Somehow, purple was “stronger,” or dominant over the
white. So if the alleles of the purple flowers were symbolized by “B," then the allele
corresponding to white flowers was “weaker” and is symbolized by “b.” If the genotype of
the parent purple flower is BB, then the genotype of the parent white plant will be
bb.
Let’s see what happened during that first cross. You will use a tool called a Punnett
square, which graphically shows the possible combinations of the gametes of the parents.
In a Punnett square, you place the possible gametes from each parent along the top and
left side of the square. What you are representing here is the Law of
Segregation: during meiosis
I, the chromosome pair separates, resulting in haploid gametes. Each
gamete will have only one allele.
Then you combine the possible gametes with each other to see all possible combinations,
as shown in this example.
As you can see, 100 percent of the offspring have the Bb genotype, but 100 percent also
show the purple phenotype. You might expect the offspring to show a phenotype that
somehow blends the parental phenotypes. Sometimes this happens, but in the case of these
pea plants' flower color, the purple allele (B) is dominant over the white
allele (b). Stated another way, the white allele (b) is recessive to the purple
allele (B).
In many, but not all, cases it is possible to pinpoint a phenotype to one allele.
Remember, alleles are variants of genes, and genes code for proteins. In this example,
the purple color may be due to an enzyme that produces a purple pigment. If the allele
codes for a mutated enzyme that does not perform as expected, the resulting flower would
be white. A flower with BB or Bb genotype has the normal enzyme — purple pigment is
produced — and even the heterozygous flower, which has only one allele for the normal
enzyme, produces enough pigment for the flower to be purple. The bb flower, on the other
hand, has no functioning enzyme, so the flower remains white.
There are some easily observable human traits that follow the Mendelian inheritance
pattern, showing a dominant and a recessive allele. Examples include unattached earlobes
(dominant) versus attached earlobes (recessive). The widow’s peak hairline, a cleft
chin, rolling tongue, and hitchhiker’s thumb are others. Does the ability to roll your
tongue make you more fit for survival? Not really! One common misconception is that
dominant traits are more favorable from an evolutionary point of view. Another is that
dominant traits are more common. We cannot stress enough that traits, and particularly
human traits, are determined by complex interactions between genes and environment. In
the early days of genetics, simple observable traits were used to describe inheritance
patterns. Once the molecular basis of inheritance was established, scientists could
tackle more complex interactions. You will learn more about this in the Molecular Genetics unit.
Mendel’s next experiment involved crossing the heterozygous purple-flowered
offspring that resulted from his first cross. The crossing of two individuals
heterozygous for a single gene is called a monohybrid cross. Let’s see what
happened.
Albinism is a recessive disorder related to the deficiency of an enzyme
responsible for the synthesis of the pigment melanin. Only homozygous recessive
individuals present the albino phenotype.
 By Muntuwandi (Albino male)
CC-BY-SA-3.0
By Muntuwandi (Albino male)
CC-BY-SA-3.0
After his first experiment with crossing involving one trait, Mendel conducted
experiments looking at the inheritance of two traits. For example, he crossed
true-breeding plants that had yellow, round seeds with true-breeding plants that
had green, wrinkled seeds. The resulting F1 generation plants all produced
yellow, round seeds.
The story became much more complicated when Mendel crossed the F1 generation
plants with each other. This is called a dihybrid cross, as it is a
cross between two individuals, both of whom are heterozygous for two traits.
In the F2 generation, Mendel observed the original phenotypes (yellow/round,
green/wrinkled) and two additional phenotypes: green/round and yellow/wrinkled.
The four alleles had combined with each other, independently of each other. This
outcome demonstrates the law of independent assortment.
Mendel did not know of genes or alleles, he talked only of “units” specifying
traits. Let’s look in detail at what happens with the genotypes of a dihybrid
cross.
As you remember from the Meiosis module, during meiosis I, after
crossing-over, the chromosome pairs separate randomly. This means that Y and y
will separate, as will R and r. But which goes to which gamete is random. So the
Y allele in a chromosome can be associated with a chromosome containing the R
allele or the r allele, and the R allele can be paired with a chromosome
containing the Y allele or the y allele. Therefore, there are four possible
gametes in a dihybrid cross.
There are exceptions to the law of independent assortment. We know now that peas
have seven chromosomes, and Mendel happened to study traits coded by genes on
different chromosomes, or on distant positions of the same chromosome, which
assort independently due to frequent crossing-over. Genes that are very close
together on a chromosome do not assort independently, and are said to be
linked. The closer they are, the more probable that the gametes
will receive parental combinations of alleles of those genes. All the genes in a
chromosome are called a linkage group. Peas have seven linkage
groups.
An example of linked traits in humans is human hair and skin color. You may have
noticed that red hair and fair skin are often inherited together. This is
because the genes for these traits are very close to each other on the same
chromosome, and they rarely recombine.
Mendel published his results in 1866, but few read his work, and no one
understood it entirely. When he became abbot of the monastery in 1871, he
retired from science, and he died in 1884, unaware that his pioneering
experiments would form the foundation for the study of modern genetics.
Gregor Mendel’s experiments that you studied earlier involve simple dominance, in
which the offspring will show a trait from either one parent or the other, not a
blend of those traits. In a case of simple dominance, crossing a red flower and
a white one will produce a red flower, not a pink flower. If you think about
traits that children inherit from their parents, you will realize that this does
not always happen.
Continued genetic research has revealed that inheritance is usually more
complicated than simple dominance. Some genes follow Mendelian patterns of
inheritance, but many are governed instead by non-Mendelian
inheritance. Mendel himself realized this when he looked at species and
characteristics beyond the scope of his research. For example, although the
cross of a true-bred purple-flowered pea plant with a true-bred white-flowered
pea plant will result in purple flowers, the cross of true-bred red flower and
true-bred white flower snapdragons will result in offspring with pink flowers.
If the pink snapdragons are crossed with each other, pink, red, and white
flowers will appear in a 2:1:1 ratio, respectively. How can this happen?
 Snapdragons produce flowers with a variety of different colors.
By Off2riorob (talk) (Snapdragons) CC-BY-3.0
Snapdragons produce flowers with a variety of different colors.
By Off2riorob (talk) (Snapdragons) CC-BY-3.0
In this inheritance pattern, called incomplete dominance, the
heterozygous genotype exhibits an intermediate phenotype. In the snapdragon
example, the intermediate phenotype is pink. What is the difference between the
purple heterozygotes of the pea flowers and the pink heterozygotes of the
snapdragon flowers? Think about what an allele is: a variation of a gene
containing the recipe for a protein. In the flower color example, this protein
could be an enzyme involved in the synthesis of a pigment. In the case of the
pea plant, the presence of a single allele in the heterozygous plant was enough
to provide all the pigment needed to give the dominant purple color. However, in
the case of the snapdragon, the presence of only one allele does not provide
enough pigment to give the flower a fully red hue—but there is enough pigment to
tint it partially, thus providing the pink color of the heterozygous flower.
So far, You've only learned about genes with two alleles — that is, two options
for a gene coming from either parent — present in a chromosome pair. However,
more than two alleles may be present in a population, resulting in what is
referred to as a multiple-allele system. Human A, B, and O blood groups exist
due to three possible alleles of the ABO gene, which codes for an enzyme that
modifies carbohydrates present on red blood cells (Components of the
Membrane). The A and B alleles code for two versions of the
enzyme, while the O allele is mutated and does not code for a functional
protein.
A and B are codominant, which means that if the individual has both A
and B alleles, he will be of AB blood group, which expresses both enzymes. On
the other hand, O is recessive, so only the homozygous recessive individuals
will have an O phenotype (blood group O).
 On the left is a diagram of the allele combinations resulting in the
different ABO blood groups (middle and right columns). By Pr. Dr. Raynal (Wikipedia) (Allèles ABO)
CC-BY-SA-3.0
On the left is a diagram of the allele combinations resulting in the
different ABO blood groups (middle and right columns). By Pr. Dr. Raynal (Wikipedia) (Allèles ABO)
CC-BY-SA-3.0
When referring to human blood groups, you may have heard references to “A
negative” or “O positive.” The term “positive/negative” here refers to the
presence or absence of a membrane glycoprotein called Rh. The Rh glycoprotein
was named after Rhesus monkeys because some of the original studies on the Rh
factor were done on these animals. The expression of this protein presents a
simple dominance pattern, with the presence of the Rh molecule (Rh positive)
being dominant over the absence (Rh negative). So a person's blood is said to be
A positive (A+) if both A and Rh molecules are present on that person’s red
blood cells.
If the immune system of an Rh negative person is exposed to Rh positive red blood
cells, it will produce antibodies against the Rh molecule. The next time the
immune system meets Rh positive red blood cells, the antibodies will attack and
destroy them. This scenario is rather unusual, except when a mother who is Rh
negative is carrying an Rh positive baby. After the first pregnancy, her immune
system develops anti-Rh antibodies, and in subsequent pregnancies these
antibodies can cross the placenta and attack the red blood cells of the fetus.
This results in hemolytic anemia, and could seriously affect the fetus. Luckily,
Rh negative mothers today receive an anti-Rh antibody injection that prevents
development of the anti-Rh response.
Another example of codominance is sickle cell anemia and sickle cell
trait. In sickle cell anemia, hemoglobin — the protein that transports
oxygen in the blood — is defective, giving the red blood cells a characteristic
“sickled” appearance.
 Normal (round) and sickled (elongated) red blood cells in a blood
smear. By Dr Graham Beards (Sickle cells) CC BY-SA 3.0
Normal (round) and sickled (elongated) red blood cells in a blood
smear. By Dr Graham Beards (Sickle cells) CC BY-SA 3.0
A change in one amino acid in the structure of hemoglobin makes it defective: the
blood cells cannot transport oxygen effectively, and they accumulate in the
blood vessels.
Patients homozygous for the defective allele have sickle cell anemia.
Heterozygotes (having one “good” and one “bad” allele for hemoglobin) will
present both types of hemoglobin. That condition is called sickle cell trait,
where the individuals will present many red blood cells that become sickled
under conditions of extreme physical exertion or low atmospheric oxygen. So
while the phenotype can be considered intermediate, in fact it is actually a
case of codominance. Interestingly, the sickle cell trait protects against
malaria infection, and therefore remains prevalent in Sub-Saharan Africa, where
malaria is endemic.
Some traits, such as skin color and height, are determined by multiple genes. In
humans, skin color is determined by at least three different genes, and probably
more. This concept is called polygenic inheritance. Variation along a
continuum often indicates that a trait has polygenic inheritance. Most visible
traits are polygenic, and their genetics patterns are rather complicated.
In some instances the polygenic effect is rather straightforward. This situation
is called epistasis. In epistasis:
- The products of two or more genes result in a certain phenotype.
- The expression of one gene masks or changes the expected phenotype of one or
more other genes.
For instance, in Labrador retrievers, the allele for black fur color (B) is
dominant with regard to the allele for brown (“chocolate”) fur color (b).
However, there are also yellow Labs. The coats of yellow labs are created
through epistasis. Another gene, E/e, is in play.
The reason for this distinction is an interaction between the two genes. The B
gene is involved in the synthesis of the pigment melanin: B results in a black,
and b in a brown color. The E gene is related to melanin deposition in the fur:
E causes melanin to be deposited, and e suppresses melanin deposits. Being
homozygous for e — that is, having the ee genotype (no melanin deposition) —
results in fur with neither brown nor black pigment, which appears yellow,
independent of the black or chocolate allele (B or b).
Pleiotropy
Many single genes can have numerous different effects, rather than just
two. This capability is called pleiotropy. In the 1930s, for
instance, researchers found a gene in chickens that leads most obviously
to feathers that curl out, but that also (and less visibly) leads to
increased metabolism, blood flow, body temperature, and digestive
capacity, as well as fewer eggs laid. This pleiotropic gene is called
the “frizzle” gene because of its effect on the appearance of the
chickens.
 Chicken expressing the frizzle gene. By Just chaos (Leghorn Frizzle Chicken) CC-BY-2.0
Chicken expressing the frizzle gene. By Just chaos (Leghorn Frizzle Chicken) CC-BY-2.0
Another gene known to have pleiotropic effects in humans is fibrillin-1,
which codes for a connective tissue protein. Marfan syndrome is caused
by mutations in the fibrillin-1 gene. People with Marfan syndrome are
usually tall and thin with long arms and legs, and they are at risk for
heart disease and eye problems. The symptoms can be treated
individually, and people with Marfan syndrome may have normal life
spans.
Characteristics that are influenced by environmental as well as genetic factors
are called multifactorial. The idea of “nature versus nurture” — in
other words, the relative influence of genetics versus environmental factors —
has been and still is debated. Just looking at the genes of a given organism
will not determine how that organism will develop and act. Even identical twins
will show different characteristics, depending on the environment in which they
live. Everyone is a product of their environment as well as their genetics.
Even when influenced by the environment, phenotypes have a normal range of
expression. For instance, human height varies based on nutrition and genetics,
but not many people are shorter than 4½ feet or taller than 7 feet. The range of
phenotypic possibilities is called the norm of reaction. Hydrangeas,
for example, may be blue, pink, or purple, but they are never naturally orange.
Hydrangeas are blue in acidic soil with available aluminum, and they are pink in
alkaline soil without available aluminum.
Some human characteristics have a narrow norm of reaction, such as blood type.
Others have a wide norm of reaction, such as the number of blood cells in
humans, which varies depending on factors that include physical fitness,
presence or history of infections, and even the altitude at which a person
lives.
The environment also affects human genes. Serotonin, a neurotransmitter that acts
inside brain cells, lowers anxiety and depression during traumatic times.
Mutations in the serotonin transporter gene may cause a reduced ability to cope
with stress. That does not mean that the person is always depressed, but if the
environment produces stress, the person may become depressed more easily than a
person with unmutated serotonin transporter genes.
 Taking a newborn blood sample for PKU testing. By Staff Sgt Eric T. Sheler, U.S. Air Force (Phenylketonuria testing) Public Domain
Taking a newborn blood sample for PKU testing. By Staff Sgt Eric T. Sheler, U.S. Air Force (Phenylketonuria testing) Public Domain
You already learned about PKU, a pleiotropic disorder caused by defects in a
single gene coding for an enzyme that converts the amino acid phenylalanine to
tyrosine. Newborns are tested for this defect very early in life, so that if the
results are positive, they can be given a diet limiting phenylalanine ingestion.
That way, the toxic buildup is prevented and the children can develop normally.
PKU is an example in which environmental factors can modify gene expression.
There are around seven billion people on our planet, and everybody looks at least a
little different from everyone else. Siblings are different from each other, and even
identical twins—who are genetically identical—can show different traits over time.
However, when we look at families over several generations, it becomes obvious that
certain traits appear generation after generation. How can this extraordinary
variability be explained?
In the previous module you learned about the inheritance patterns (Mendelian and
non-Mendelian) that were studied using models such as peas, snapdragons, and dogs.
Another organism that is often used is the fruit fly Drosophila. Common to these
organisms is that they are relatively easy to breed and cross under controlled
conditions. They also have a relatively short lifespan, which allows the tracking of
traits for many generations. In the case of humans, genetic analysis is much more
complicated. We live under a variety of conditions, so the environmental influences are
much stronger. Humans choose their mates freely, families are usually smaller, and our
lifespan is the same as that of the geneticists. Much information about transmission of
human traits comes from the study of pedigrees, a chart of genetic connections similar
to a family tree. In this module, you’ll learn how to read pedigrees. You’ll also look
at the different patterns and factors that affect human inheritance.
Many human traits are clear-cut and easy to test. These include the ability to bend back
the thumb nearly 90 degrees (known as “hitchhiker’s thumb”), to roll the tongue into a
U-shape, and to taste a bitter chemical called phenylthiocarbamide. While these traits
do not have considerable implications on human health and species survival, many others
do. Some of them are related to disorders such as sickle cell anemia, hemophilia,
Tay-Sachs disease, and Down syndrome, to name a few.
 Left, a tongue-rolling girl. Tongue rolling is a dominant trait that follows
Mendelian inheritance. By Gideon Tsang (Rolled
tongue flikr) CC BY-SA 2.0
Right: Queen Victoria and the royal family. Hemophilia, a blood clotting disorder
transmitted by sex-linked inheritance, affected 18 of Queen Victoria’s 69
descendants. By M.W. Ridley (Queen Victoria and Royal Family) Public Domain
Left, a tongue-rolling girl. Tongue rolling is a dominant trait that follows
Mendelian inheritance. By Gideon Tsang (Rolled
tongue flikr) CC BY-SA 2.0
Right: Queen Victoria and the royal family. Hemophilia, a blood clotting disorder
transmitted by sex-linked inheritance, affected 18 of Queen Victoria’s 69
descendants. By M.W. Ridley (Queen Victoria and Royal Family) Public Domain
Some human traits (like the tongue-rolling ability) follow Mendelian patterns, which
means they are controlled by a single gene. One of the alleles is dominant, and
the other is recessive. Human genetic disorders following a Mendelian pattern
are the least common. Most of those tend to be recessive, meaning that the defective
allele causing the disorder is recessive. That means only homozygous recessive
individuals will show the disorder. The heterozygotes will be carriers, so
while they carry the defective allele (and sometimes even express it, as in the sickle
cell trait), they phenotypically do not present the full disorder. Other disorders may
be dominant, wherein the defective allele causing the disorder is dominant. In this
case, the presence of only one allele is enough to provoke the appearance of the
disorder, and only homozygous recessive individuals show the healthy phenotype.
As you remember from the Meiosis
module, of the 23 pairs of chromosomes found in a human
somatic cell, 22 are autosomes, and the 23rd pair are sex chromosomes. Sex chromosomes
are of two types: X and Y. Males have one X and one Y chromosome (XY), and females have
two copies of the X chromosome (XX). If the gene responsible for the disorder is present
on the autosomes, it is called an autosomal disorder. The term “autosomal” refers to
chromosomes that are not sex determining. On the other hand, if the responsible gene is
present on a sex chromosome, it is called a sex-linked disorder. Due to the fact that
the male Y chromosome is very small and contains only genes related to sex
determination, sex-linked disorders are due to defective alleles on the X chromosome.
The following table shows the inheritance patterns of some human genetic disorders and
abnormalities.
| Pattern |
Disorder |
Main symptoms |
| Mendelian: autosomal dominant |
Huntington’s disease; Progeria |
Degeneration of the nervous system; Premature aging |
| Mendelian: autosomal recessive |
Cystic fibrosis; Sickle cell anemia |
Abnormal glandular secretions provoking lung and digestive dysfunction; Anemia
causing effects on the whole body |
| Sex-linked |
Hemophilia; Red-green color blindness |
Inadequate blood clotting; Inability to distinguish red from green |
| Changes in chromosome number |
Down syndrome; Klinefelter syndrome; Turner syndrome |
Mental impairment, heart defects; Sterility, mild mental impairment; Sterility,
abnormal ovaries |
| Changes in chromosome structure |
Chronic myelogenous; Leukemia |
Overexpression of white blood cells; Organ dysfunction |
In humans, determination of sex is dependent on a special pair of chromosomes called the
sex chromosomes. The other 22 pairs are called autosomes.
There are two types of sex chromosomes — X and Y. The X chromosome is large and carries
many genes unrelated to sex. The Y chromosome, on the other hand, is much smaller and
carries only the genes containing the instructions for “maleness,” which are molecular
signals that instruct the fetal gonads (sex organs) to develop as testes and not
ovaries. In the absence of the Y chromosome, a fetus develops as female.
Females have two copies of the X chromosome (XX), while males carry one X and one Y (XY).
When gametes are formed, females will have only gametes that contain the X chromosome;
males will have some gametes with X and others with Y. For a male baby, a Y gamete from
the father has to meet the mother’s gamete. So the determination of a baby’s sex depends
on which gamete the father contributes.
About one out of every ten men is color-blind. People who are color-blind are unable to
distinguish between certain colors, especially green and red. On the other hand, only
about one out of every 200 women is color-blind. Why is there such a drastic difference
between the sexes?
In 1910, an American geneticist named Thomas Hunt Morgan made an observation that
began to shed some light on this question. One morning, when peering through a hand
lens at a male fruit fly, he noticed that it didn’t look right. Instead of having
the normally brilliant red eyes of wild-type Drosophila melanogaster, this fly had
white eyes. Morgan was particularly interested in how traits were inherited and
distributed in developing organisms, and he wondered what caused this fly's eyes to
deviate from the norm.
 A fruitfly (Drosophila melanogaster) displaying the normal red-eyed
phenotype. By André Karwath (Drosophila melanogaster - side)
CC-BY-SA-2.5
A fruitfly (Drosophila melanogaster) displaying the normal red-eyed
phenotype. By André Karwath (Drosophila melanogaster - side)
CC-BY-SA-2.5
He bred the white-eyed male with several true-bred, red-eyed females and obtained all
red-eyed flies in the first generation. (Remember, true-bred organisms have a
homozygous genotype.)
Morgan did crosses between the F1 hybrids, and he observed the following: 75 percent of
the offspring were red-eyed, and 25 percent were white-eyed. So far, the results
supported the Mendelian pattern of 3:1. But then he noticed something odd: all of the
white-eyed flies were male.
Morgan wondered why the white-eye trait was associated with the male sex. In Morgan’s
time, the idea that an additional pair of chromosomes was responsible for sex
determination had just emerged. There were two plausible possibilities: either the trait
was somehow linked to the sex chromosome, or the white-eyed trait was lethal for
females, meaning that females with the phenotype would not develop past the egg stage.
Morgan conducted a series of crosses using the F2 generation, and obtained some
white-eyed females also, showing that the white-eyed characteristic was not lethal for
females.
In a famous subsequent experiment, Morgan crossed white-eyed females with white-eyed
males, obtaining only white-eyed offspring. This cross confirmed that the eye color
trait was linked to the female sex chromosome. Because of this, the males are what is
called hemizygous for this trait: they have only one allele present, which is
in the X chromosome. The Y chromosome does not have the same genes as the X chromosome.
Males have no heterozygous option: they either have the dominant allele (red-eyed) or
the recessive allele (white-eyed).
The trait of white eyes in fruit flies is a sex-linked trait. It is located on a
sex chromosome, so it occurs at different rates in males and females. Because it is
located on the X chromosome, it is more specifically called an X-linked gene.
In humans, the trait of color blindness results from a gene on the X chromosome. So do
some more serious diseases, including Duchenne muscular dystrophy, which causes
progressive muscle weakness. People with this disorder rarely live past the age of 25. A
gene on the X chromosome codes for a muscle protein that is missing in people with
Duchenne muscular dystrophy.
Human chromosomes are numbered from largest to smallest. Each of the 22 pairs of
autosomal chromosomes have an identifying number, from 1 to 22; chromosome
1 is the biggest and chromosome 22 is the smallest. As you already know, the pair of sex
chromosomes are named either X or Y. The chromosomes of a cell can be visualized using a
process that takes a picture of the cell during mitosis, when chromosomes are easily
visible. The picture that is produced is called a karyotype.
 A karyotype visualizes the chromosomes of a cell. By National Human Genome Research Institute (Sky spectral karyotype) Public Domain
A karyotype visualizes the chromosomes of a cell. By National Human Genome Research Institute (Sky spectral karyotype) Public Domain
Karyotypes can be used to identify chromosomal abnormalities in cells or in developing
fetuses. Amniocentesis is a medical procedure used to sample fetal cells from a pregnant
mother. These cells, which are rapidly dividing, can be used to create a karyotype of
the fetus. This karyotype can then help identify potential chromosomal abnormalities in
the developing child. Abnormalities could include extra chromosomes, missing
chromosomes, and even extra or missing pieces of chromosomes.
 By National Human Genome Research Institute (Down Syndrome Karyotype) Public Domain
By National Human Genome Research Institute (Down Syndrome Karyotype) Public Domain
This karyotype has an extra chromosome 21. This condition is called “trisomy 21” because
the cell has three ("tri") of these chromosomes instead of the usual two. This condition
is more commonly called “Down syndrome.” There are relatively few examples of such
large-scale chromosomal anomalies. Down syndrome results from an extra copy of one of
the smallest chromosomes. Extra or missing copies of sex chromosomes can also result in
viable embryos. Embryos with extra or missing chromosomes are often nonviable, and other
chromosomal anomalies are not generally seen.
Aneuploidy is the condition of having too many or too few chromosomes, which results from
errors in meiosis. If crossing-over does not occur correctly, the chromosomes can have
extra pieces or missing pieces. If the chromosomes do not separate properly during
anaphase, the resulting cells can have extra or missing chromosomes. This improper
separation of chromosomes is called nondisjunction. Nondisjunction can occur in
either meiosis I or meiosis II.
The following activity looks at aneuploidy that results from nondisjunction in Meiosis
I.
Nondisjunction can also occur at Meiosis II. Complete the following activity to learn
more.
Pedigrees are maps that can be used to trace genetic traits through generations of
individuals. Pedigrees use the following symbols:
- Males are symbolized by squares.
- Females are symbolized by circles.
- Mated individuals are connected by a horizontal line, and children are connected to
them by vertical branches extending down from the line.
- Individuals expressing a genetic trait are shaded; individuals not expressing the
trait are not shaded.
Pedigrees can be used to determine if the trait being studied is dominant, recessive, or
X-linked. A trait is recessive if a child anywhere in the family has the trait and both
parents do not. This must be the case because if the child has the trait and the parents
do not, the only possible genotype option is:
It would not be possible for an affected individual to show a dominant trait that was not
expressed in his or her parents, because this sets up an impossible situation where the
child would have an allele that could not come from either parent:
If there is no case where a child expresses the trait but neither parent does, then the
pedigree is likely to be dominant. In a real-world situation, researchers would need to
look at hundreds of individuals to be sure that this conclusion is statistically
significant. But for the purposes of this activity, you will look at only a few
individuals.
A trait that is significantly more common in males than females is likely to be X-linked.
Again, in a real-world situation a much larger sample size would be needed to be sure of
these conclusions. The X-linked traits used here are also recessive, so you will notice
that they show both characteristics of being X-linked (mostly males) and characteristics
of being recessive (child demonstrating a trait that neither parent has).
Progeria (Hutchinson-Gilford Progeria Syndrome, HGPS)
 Child with progeria. HGPS is a childhood disorder caused by mutations in one of
the major architectural proteins of the cell nucleus. In HGPS patients, the cell
nucleus has dramatically aberrant morphology (bottom, right) rather than the uniform
shape typically found in healthy individuals (top, right). By P Scaffidi (Hutchinson-Gilford Progeria Syndrome) CC BY 2.5
Child with progeria. HGPS is a childhood disorder caused by mutations in one of
the major architectural proteins of the cell nucleus. In HGPS patients, the cell
nucleus has dramatically aberrant morphology (bottom, right) rather than the uniform
shape typically found in healthy individuals (top, right). By P Scaffidi (Hutchinson-Gilford Progeria Syndrome) CC BY 2.5
HGPS is an extremely rare (one case per eight million live births) autosomal dominant
disorder characterized by accelerated aging. The disorder is caused in the gene coding
for lamin A, a protein involved in chromosome organization. The defective protein
accumulates in the nuclear membrane of the cells, affecting many cellular processes.
Symptoms start before age two, with thinning skin and weak muscles and bones. Aging is
estimated to be eight to 10 times faster than normal. Patients die in their teens from
stroke or heart attack. How do people “get” progeria? It is important to remember that
because progeria patients die at a very young age, progeria is not inherited, but only
appears as a random mutation. This explains its fortunately very low incidence.
In the Classical
Genetics unit, you learned about the mechanisms of inheritance,
focusing mostly on the organism and population levels in the hierarchy of life. In the
Molecular Genetics unit, you will learn about the molecular basis of traits
that characterize the organisms. You will develop an understanding on the molecular
level of how genetic information is organized and used by living organisms.
 DNA carries all the information needed to build living organisms. Information
in DNA is used to build proteins, which cause the physical traits, or phenotypes, of
an organism. The central dogma describes how the information in the DNA is used to
build a molecule of mRNA, which provides instructions to the ribosome for building
the proteins that cause the physical traits.
DNA carries all the information needed to build living organisms. Information
in DNA is used to build proteins, which cause the physical traits, or phenotypes, of
an organism. The central dogma describes how the information in the DNA is used to
build a molecule of mRNA, which provides instructions to the ribosome for building
the proteins that cause the physical traits.
If we compare traits of individuals within species, we find that they share certain
traits, but they also show many differences among individuals. Fore example, rice
(pictured below) shows variation in shape and color of seeds/grains. People also come in
different shapes and sizes. What determines physical traits that characterize a person:
hair color, eye color, height, weight? How about behavior: some people are risk-takers,
others get easily anxious; some people love to be in large noisy crowds, others prefer
quiet and solitude. What is more important in determining physical and behavioral traits
— genetics or environment? This classic “nature vs. nurture” argument should not be
phrased as “either/or,” because the answer is “both.” The interactions between genes
and environment determine the traits.
 Rice seed collection. Source: BY Kleomarlo (Rice diversity) CC-BY-2.0
Rice seed collection. Source: BY Kleomarlo (Rice diversity) CC-BY-2.0
A better question to ask is “To what extent is each trait determined by genetics and to
what extent by environment?” The answer will vary by trait and is still being
researched. It is not a trivial question to answer, and the numbers below are only rough
estimates.
| Estimated Genetic Contribution |
|---|
| Height |
80% of variation due to genetics |
| Type I diabetes |
70-90% of variation due to genetics |
| Type II diabetes |
25% of variation due to genetics |
|
In Molecular Genetics, first you will learn about the storage, transmission,
and expression of genetic information (central dogma of molecular
biology), whereby the information content in
DNA sequences, called genes, is
ultimately converted to a protein. Then you will look at the structure of genes and
genomes and at the interactions between genes and the environment. Finally, you will
examine how humans are able to manipulate genes through
biotechnology.
If you look at people around you, you will probably notice a fairly large variation in
height. Some people are taller than you, while others are shorter than you. Consider
this trait as an example that you want to understand on the molecular level. What kinds
of molecules may be involved in determining a person’s height? If you and your parents
are relatively short (or tall), you may say that you inherited the short (or tall)
stature from your parents. What molecule is involved in the transmission of information
from one generation to the next? DNA. How does information contained in DNA affect your
height? One possible explanation is that your DNA contains a gene encoding a protein
called growth hormone. This protein is produced by the pituitary gland, travels to other
tissues, and delivers a signal for the cells to grow and divide. Changes in the amount
of protein produced or the sequence of amino acids in the protein can affect the
function. If bone and muscle cells receive only a small number of signal molecules, the
person will end up with a short stature. If they receive a large number of signal
molecules, the person may end up being very tall. For a signaling protein (hormone) to
deliver the signal, there must be a protein that can bind the hormone and receive the
signal (receptor protein). The variation in height will result from any of the
following:
- The amount of signaling protein produced.
- The amount of receptor produced in different tissues.
- How tightly the hormone and the receptor bind to each other; small variations in
specific amino acids of either molecule can change the binding interaction.
Note that a person who inherits “tall” genes may never grow very tall because of illness
or inadequate nutrition. Conversely, a person who inherits a faulty growth hormone gene
may grow relatively tall if he or she is treated with growth hormone. These are examples
of how environment and genes interact to produce traits and phenotypes.
In this module, you will learn about how genetic information is stored in DNA and copied
for the next generation. You will also look at a practical application of the process of
DNA replication called the polymerase chain reaction (PCR). In the next module, you will
learn how the genetic information stored in genes is expressed, resulting in the variety
of traits and phenotypes of all organisms.
Nucleic acids are macromolecules that carry out two main functions in the cell: storage of
genetic information and synthesis of proteins. Two types of nucleic acids specialize in
these functions: deoxyribonucleic acid (DNA) and ribonucleic acid (RNA). DNA is the
genetic material that stores information for making proteins in all living organisms.
Some viruses store their genetic information in RNA instead of DNA. This may seem as an
exception to the universal use of DNA as genetic material; however, viruses are not
cellular, and are not considered living organisms. DNA is found in the nucleus
of eukaryotes and in two cellular organelles: chloroplasts, and
mitochondria.
Location of DNA in Cells

Location of DNA in Prokaryotic Cells
In prokaryotes, DNA is not enclosed in a separate compartment, but found in the cytoplasm.
Bacteria Cell

Regardless of where DNA is stored in the cell, it contains instructions for building
proteins. For protein synthesis to occur, genetic information stored in DNA must first
be copied into RNA. In eukaryotic cells, RNA is transported to the cytoplasm, where
protein synthesis takes place. Thus, while both RNA and DNA can contain instructions for
making proteins, DNA is used for storage of this information, while RNA is directly
involved in making proteins.
To understand in more detail how nucleic acids function in transmission of genetic information
and in protein synthesis, you must first consider the structures of these molecules and
the relationship between structure and function.
The genetic information of an organism is stored in DNA molecules. How can one kind of
molecule contain all the instructions for making complicated living beings like
ourselves? What component or feature of DNA can contain this information? It has to come
from the nitrogen bases, because, as you already know, the backbone of all DNA molecules
is the same. But there are only four bases found in DNA : G, A, C, and T. The sequence
of these four bases can provide all the instructions needed to build any living
organism. It might be hard to imagine that 4 different “letters” can communicate so much
information. But think about the English language, which can represent a huge amount of
information using just 26 letters. Even more profound is the binary code used to write
computer programs. This code contains only ones and zeros, and think of all the things
your computer can do. The DNA alphabet can encode very complex instructions using just
four letters, though the messages end up being really long. For example, the E. coli bacterium carries its genetic instructions in a DNA
molecule that contains more than five million nucleotides. The human genome (all the DNA
of an organism) consists of around three billion nucleotides divided up between 23 DNA
molecules, or chromosomes.
The information stored in the order of bases is organized into genes: each gene contains
information for making a functional product. The genetic information is first copied to
another nucleic acid polymer, RNA (ribonucleic acid), preserving the order of the
nucleotide bases. Genes that contain instructions for making proteins are converted to
messenger RNA (mRNA). Some specialized genes contain instructions for making functional
RNA molecules that don’t make proteins. These RNA molecules function by affecting
cellular processes directly; for example some of these RNA molecules regulate the
expression of mRNA. Other genes produce RNA molecules that are required for protein
synthesis, transfer RNA (tRNA) and ribosomal RNA (rRNA).
In order for DNA to function effectively at storing information, two key processes are
required. First, information stored in the DNA molecule must be copied, with minimal
errors, every time a cell divides. This ensures that both daughter cells inherit the
complete set of genetic information from the parent cell. Second, the information stored
in the DNA molecule must be translated, or expressed. In order for the stored
information to be useful, cells must be able to access the instructions for making
specific proteins, so the correct proteins are made in the right place at the right
time.
Both copying and reading the information stored in DNA relies on base pairing between two
nucleic acid polymer strands. Recall that DNA structure is a double helix (see figure
below).
Structure of DNA double helix. On the left: Sugar-phosphate backbone is shown
in yellow, specific base pairings via hydrogen bonds (red lines) are colored in
green and purple (A-T pair) and red and blue (C-G). On the right: Three-dimensional
structure of DNA double helix. Click on the checkboxes to highight the A-T and C-G
basepairs. Click on 'Spin On' to automatically rotate the DNA helix structure.
Graphic by Madeleine Price Ball (DNA chemical
structure) CC-BY-SA-2.0
The sugar deoxyribose with the phosphate group forms the scaffold or backbone of the
molecule (highlighted in yellow in the figure above). Bases point inward. Complementary
bases form hydrogen bonds with each other within the double helix. See how the bigger
bases (purines) pair with the smaller ones (pyrimidines). This keeps the width of the
double helix constant. More specifically, A pairs with T and C pairs with G. As we
discuss the function of DNA in subsequent sections, keep in mind that there is a
chemical reason for specific pairing of bases.
To illustrate the connection between information in DNA and an observable characteristic
of an organism, let’s consider a gene that provides the instructions for building the
hormone insulin. Insulin is responsible for regulating blood sugar levels. The insulin
gene contains instructions for assembling the protein insulin from individual amino
acids. Changing the sequence of nucleotides in the DNA molecule can change the amino
acids in the final protein, leading to protein malfunction. If insulin does not function
correctly, it might be unable to bind to another protein (insulin receptor). On the
organismal level of organization, this molecular event (change of DNA sequence) can lead
to a disease state — in this case, diabetes.
Before a cell can divide, it must first make a copy or replica of
its DNA through a process called DNA replication. This process
occurs during the S
phase of the cell cycle, so by the time the cell enters the mitotic
phase, there are two copies of the DNA molecule. This process of DNA replication takes
place in the nucleus of the cell in eukaryotes, where the DNA molecule is found. It also
occurs in the mitochondria in animal cells and chloroplasts in plant cells.
Think about this: it is critical that the copies of the DNA are exactly like the
original, so the daughter cells are identical to the parent cells. There may be changes
to DNA sequence by mutations (as you will see in another section), and meiosis
introduces some genetic variability when gametes are produced. But for unicellular
organisms or for somatic cells, DNA replication is a process that requires high
fidelity.
The process of DNA replication is catalyzed by a type of enzyme called DNA polymerase (poly meaning many, mer meaning pieces, and ase meaning enzyme; so an
enzyme that attaches many pieces of DNA). Observe the figure below: the double helix of
the original DNA molecule separates (blue) and new strands are made to match the
separated strands. The result will be two DNA molecules, each containing an old and a
new strand. Therefore, DNA replication is called semiconservative. The term semiconservative refers to the fact that half of the original
molecule (one of the two strands in the double helix) is “conserved” in the new
molecule. The original strand is referred to as the template
strand because it provides the information, or template, for the newly
synthesized strand.
 By Madprime(wikipedia) (DNA replication split horizontal) CC BY-SA
2.0
By Madprime(wikipedia) (DNA replication split horizontal) CC BY-SA
2.0
DNA replication relies on the double-stranded nature of the molecule. One double stranded
DNA molecule, when replicated, will become two double-stranded molecules, each
containing one original strand and one newly synthesized strand. You remember that the
two strands of DNA run antiparallel: one from the 5’ to the 3’, and the other from the
3’ to the 5’. The synthesis of the new DNA strand can only happen in one direction: from
the 5’ to the 3’ end. In other words, the new bases are always added to the 3’ end of
the newly synthesized DNA strand. So if the new nucleotide is always added to the 3’ end
of an existing nucleotide, where does the first nucleotide come
from? In fact, DNA polymerase needs an “anchor” to start adding nucleotides: a short
sequence of DNA or RNA that is complementary to the template strand will work to provide
a free 3’ end. This sequence is called a primer.

How does DNA polymerase know in what order to add nucleotides? Specific base pairing in
DNA is the key to copying the DNA: if you know the sequence of one strand, you can use
base pairing rules to build the other strand. Bases form pairs (base pairs) in a very
specific way. The figure shows how A (adenine) pairs with T (thymine) and G (guanine)
pairs with C (cytosine). It is important to remember that this binding is specific: T
pairs with A, but not with C. The molecular recognition occurs because of the ability of
bases to form specific hydrogen bonds: atoms align just right to make hydrogen bonds
possible. Also note that a larger base (purine, A or G) always pairs with a smaller base
(pyrimidine, C or T).
 By Madeleine Price Ball (DNA chemical structure) CC-BY-SA-2.0
By Madeleine Price Ball (DNA chemical structure) CC-BY-SA-2.0
Now that you understand the basics of DNA replication, we can add a bit of complexity.
The two strands of DNA have to be temporarily separated from each other; this job is
done by a special enzyme, helicase, that helps unwind and separate the DNA
helices. Another issue is that the DNA polymerase only works in one direction along the
strand (5’ to 3’), but the double-stranded DNA has two strands oriented in opposite
directions. This problem is solved by synthesizing the two strands slightly differently:
one new strand grows continuously, the other in bits and pieces. Short fragments of RNA
are used as primers for the DNA polymerase.
 By Mariana Ruiz (DNA replication) Public Domain
By Mariana Ruiz (DNA replication) Public Domain
Polymerase Chain Reaction
You may remember from the movie Jurassic Park how the DNA of a dinosaur was
recreated from a tiny amount of blood from a mosquito trapped in amber. While
(so far) this is not possible in real life, the idea is based on one of the most
useful tools for the manipulation of DNA: the polymerase chain
reaction, or PCR. This technique was invented by Kary Mullis in 1983. PCR
uses repeated cycles of DNA polymerase activity to amplify, or make many copies
of, a small segment of DNA known as the target DNA. The target DNA resides
within a larger DNA molecule that acts as a template. The amplified DNA, or PCR
product, can also serve as a template, leading to a “chain reaction” that
doubles the amount of PCR product after each cycle. Consequently, PCR can be
used to amplify small amounts of DNA from forensic samples or historical
artifacts. When scientists have a larger sample of DNA, they can determine the
base sequence of the sample and use the data to compare the DNA sequences of
different individuals. This process can help forensic scientists figure out the
identity of a person who left blood at a crime scene. It can also help decide
paternity disputes.
 By Karlmumm(Wikipedia) (PCR
masina kasutamine) CC BY-SA
3.0
By Karlmumm(Wikipedia) (PCR
masina kasutamine) CC BY-SA
3.0
How does PCR work?
PCR is essentially DNA replication, and just like DNA replication, PCR relies on
the enzyme DNA polymerase. Because DNA polymerase requires a primer before it
can start building a new strand of DNA, this is the first thing scientists must
find (or design). These primers will provide a starting point for the DNA
polymerase. In DNA replication, the primers are made of RNA nucleotides. In PCR,
the primers are short DNA molecules consisting of a specific sequence that
flanks the right and left ends of the target DNA sequence. The PCR product will
contain the DNA sequences of the primers and the DNA between the primers.
 Overview of PCR. The target region is defined by the sequences of the
two primers. The final PCR product contains the sequences of the two
primers, plus any DNA sequences between the two.
Overview of PCR. The target region is defined by the sequences of the
two primers. The final PCR product contains the sequences of the two
primers, plus any DNA sequences between the two.
Steps of PCR
Step 1: The DNA template and primers must be converted to single-strand DNA. In
DNA replication, DNA is separated by helicase. In the lab, we can accomplish the
same thing by heating the DNA to 98oC (almost boiling temperature).
Step 2: In order for the DNA to be copied, the primers must bind. 98°C is too hot
for the hydrogen bonds between complementary bases to form. Therefore, the
reaction is cooled to ~55°C. This allows the hydrogen bonds between the primer
and the target DNA sequence to form.
Step 3: In step 3, the temperature is raised to ~78°C, which activates DNA
polymerase and stimulates copying of the DNA. The polymerase begins at the
primer and copies the DNA to the end of the template.
After this process is complete, the temperature is again raised to 980C and a new cycle begins.
At the end of each cycle, the sample contains double the amount of DNA template.
Watch the following video to review the steps of PCR.
Polymerase Chain Reaction
You might wonder how the DNA polymerase, as a protein, can resist such a high
temperature. In fact, the DNA polymerases used for PCR are derived from
organisms that can live at extremely high temperatures. The most common DNA
polymerase used for PCR is called Taq, and it is found in the microbe Thermus aquaticus, which was first discovered in the
Lower Geyser Basin at Yellowstone National Park.
Much of our DNA contains a number of short DNA segments that are repeated over and over
again at different locations in our genome. The number of these tandem repeats at each
location in the genome can differ from individual to individual, with 5 to 20 percent of
individuals having the same number of tandem repeats at the same location.
 Illustration of the variation in tandem repeats in the human population. Two
chromosomes are shown, and the tandem repeats in each chromosome are shown as yellow
(chromosome 1) or blue boxes (chromosome 2). The two individuals have the same
number of tandem repeats on chromosome 1, but a different number of repeats on
chromosome 2.
Illustration of the variation in tandem repeats in the human population. Two
chromosomes are shown, and the tandem repeats in each chromosome are shown as yellow
(chromosome 1) or blue boxes (chromosome 2). The two individuals have the same
number of tandem repeats on chromosome 1, but a different number of repeats on
chromosome 2.
Variations in the number of tandem repeats are detected by the polymerase chain reaction,
using primers that bind to unique sequences on the edges of the repeat.
 Amplification of repetitive DNA by PCR. The region of DNA containing the
repeats is shown on the top; the PCR product is on the bottom.
Amplification of repetitive DNA by PCR. The region of DNA containing the
repeats is shown on the top; the PCR product is on the bottom.
If the two DNA samples show a different number of repeats, then the samples must have
come from two different individuals. If two DNA samples show the same number of repeats
at one location, then there is a chance that the two DNA samples came from the same
individual. This is not a very reliable indication that the DNA samples came from the
same individual, since a significant fraction of people can have the same number of
tandem repeats at any one location in the chromosome. To increase the reliability of a
positive match between the two samples, a total of 13 different locations of tandem
repeats are amplified, and the number of repeats at each location are compared. If any
of the 13 locations differ in the number of repeats, the two DNA samples came from
different individuals. However, if all 13 agree, there is a greater than 99.99 percent
probability that the two DNA samples came from the same individual. There is still a
0.01 percent chance that the DNA came from two different people who just happened to
have the same number of tandem repeats at each of the 13 different locations.
In the previous module, you learned how genetic information is stored in DNA and how it
is passed in its totality to the next generation through the process of DNA replication.
You also read about PCR, a practical application of the DNA synthesis process. In this
module, we will focus on how this information is expressed. Information contained in DNA
is organized into genes, and each gene contains instructions for
making a functional product: an RNA molecule or a protein. This process of making the
functional gene product is gene expression. Different cells can
contain the same DNA, but they express different genes and produce different proteins
according to their function. For example, red blood cells produce the protein
hemoglobin, which is required for delivery of oxygen throughout the body. Nerve cells
contain the same DNA, but the hemoglobin gene is not expressed. Instead, nerve cells
make RNA copies of the genes that encode proteins required for signaling.
 Both a nerve cell (left) and a red blood cell (right) develop from cells that have
identical DNA, but the expression of different genes leads to structural and functional
differences between the cells.
Both a nerve cell (left) and a red blood cell (right) develop from cells that have
identical DNA, but the expression of different genes leads to structural and functional
differences between the cells.
Even cells of the same type may express different genes and therefore produce different
proteins, depending on their needs or environmental conditions. For example, pancreatic
beta cells produce insulin when blood sugar levels are increased. Weightlifting
increases muscle mass because it increases the production of proteins in the muscle
cell. Sex hormones are not produced until the beginning of puberty.
Multiple proteins expressed at specific levels at specific times in the cell determine
the phenotype. In this module, we will consider each of these processes in more detail,
and we will conclude by looking at how changes in DNA sequence can affect the proteins
encoded by DNA.
The flow of information in a cell is described by the central dogma of
molecular biology.
In eukaryotic cells, DNA stores the genetic information, which is passed from generation
to generation through the process of DNA replication. During replication, the whole
sequence of DNA is copied. In order for the information stored in DNA to be used by a
living cell, the information must be expressed (gene expression).
First, DNA is transcribed into one form of RNA called messenger RNA, or
mRNA, through the process of transcription; then mRNA can be translated
into an amino acid sequence forming a protein through the process of
translation. The ribosome translates the RNA sequence
into a protein sequence, using three nucleotide bases to encode each amino acid DNA also
encodes two other RNA molecules, transfer RNA (tRNA) and ribosomal RNA (rRNA). Although
these RNA molecules do not directly encode proteins, they are both required
for protein synthesis.
Transcription and translation are often confused. Transcription is copying the
information without changing the language. This word comes from the same root as scribe, a word that describes someone who made copies of books
in medieval times. DNA and RNA are considered the same chemical
“language” because their monomers are
nucleotides.
Now, compare transcription to translation. Just as translators of books change
information from one language to another, the cellular process of
translation changes information from the language of
nucleic acids (using nucleotides as the monomers) into the language of proteins (using
amino acids as monomers).
 A scribe copying information by Meister des Maréchal de Boucicaut; artwork in the public domain. On
right, a dictionary used to translate from the language of
English to Spanish.
A scribe copying information by Meister des Maréchal de Boucicaut; artwork in the public domain. On
right, a dictionary used to translate from the language of
English to Spanish.
Note that there are exceptions to the central dogma. It is thought that during the dawn
of life, RNA was the first molecule to store genetic information, and certain viruses
still have RNA as their nucleic acid component. In fact, certain viruses (among them the
human immunodeficiency virus, or HIV) have an enzyme capable of making DNA using RNA as
a template. However, you will recall that viruses are not cells, so it is safe to say
that cells use DNA as their genetic material, and the flow of information goes as
follows:

Gene expression, a process that is central to all living cells, can
be summarized as a list of the following steps:
- the DNA double helix is separated
- an enzyme called RNA polymerase moves along one strand and transcribes the
information from one strand of DNA into a strand of RNA
- the ribosome translates the RNA sequence into a protein sequence.
In eukaryotes, DNA and ribosomes reside in separate compartments, so an additional step
is required: the transportation of RNA out of the nucleus and into the cytoplasm.
The animation below illustrates the process of gene expression in
eukaryotes. Watch the animation, and then label still
frames of the animation in the Learn By Doing activity.
During gene expression, information stored in DNA is first copied (or transcribed) into
RNA in a process called transcription. Only one of the two DNA
strands is transcribed, and the order of bases in RNA is determined by the base pairing
of the ribonucleotides with the DNA. In RNA, the base T is absent and U is present
instead. As you know, A pairs with T, but because T is replaced by U in RNA, A pairs
with U in RNA. If the transcribed DNA strand has the sequence
and the bottom stand is used as a template to produce the RNA copy, the sequence of the
RNA will be
Note that it the transcribed RNA has exactly the same sequence as the upper DNA strand,
but with T replaced by U.
The goal of translation is to make proteins. The sequence of amino acids in a
protein is specified (or encoded) by the sequence of bases in the nucleic acid.
You will recall that originally, the information is stored in DNA, but during
transcription, an RNA copy of DNA is made. RNA molecules that contain
instructions for making a protein are called messenger RNA
(mRNA). The sequence of bases in the mRNA determines which amino acid
will be used in the protein. Every three bases encode for a single amino acid.
These three bases are called codons or triplets.
The genetic code table below shows all possible combinations of three bases and
the corresponding amino acids that the codons encode. For example, the mRNA
codon UGG encodes for the amino acid tryptophan. Note that there are 64 codons
and only 20 common amino acids. Three of the codons do not specify amino acids,
but instead signal the end of translation; these are called stop codons. The remaining 61 codons encode for 20 amino acids. Of
these, the codon for the amino acid methionine, AUG, has a dual role. It is used
to signal the start of most protein-coding regions in the mRNA; thus, it is the
start codon. The same codon is used if methionine
occurs at an internal position in the protein sequence.
The genetic code is redundant; some amino acids are specified by multiple codons. This
redundancy will become important when we try to predict how changes in
nucleotide sequences affect the amino acid sequences of proteins. Remarkably,
the genetic code table is almost universal, meaning that most organisms, from
bacteria to humans, specify the same amino acids using the same codons. As a
result, genes from one type of organism can be transferred to, and expressed in,
the cells of another organism. You will learn more about these kinds of
technologies later in this unit.
Examine the genetic code table and complete the Learn By Doing activity to make
sure you understand how to use the table.
Genetic Code Table
This table summarizes the amino acids that result from each codon on mRNA. The
first letter in the codon is on the left. The second is on the top, and the
third is on the right.
The genetic code table allows us to convert the information contained in a
nucleic acid into an amino acid sequence. How does the cell do this during
translation? Translation from one language to another requires a dictionary, a
book that connects words in two different languages. In the cell, we need a
molecule that connects codons and amino acids. That molecule is transfer RNA
(tRNA). Each tRNA contains three bases that can pair with a particular codon in
mRNA (complementary base pairing). Each tRNA also carries a specific amino acid.
The tRNA binds mRNA via base pairing and brings the correct amino acids to the
growing polypeptide chain.
 By Boumphreyfr(Wikipedia) (Peptide
syn) CC BY-SA
3.0
By Boumphreyfr(Wikipedia) (Peptide
syn) CC BY-SA
3.0
The last type of RNA molecule that is critical for translation is ribosomal RNA
(rRNA). rRNAs are components of the ribosome. The ribosome is a large
macromolecular complex composed of rRNA and ribosomal proteins. The ribosome
catalyzes the formation of peptide bonds between the amino acids. Some ribosomes
are located in the cytosol and translate cytosolic proteins. Some ribosomes are
attached to membranes; these ribosomes translate proteins destined to be
inserted into the membrane or secreted outside the cell.
To summarize, three types of RNA carry out distinct roles in translation: mRNA
encodes the protein, tRNA brings amino acids to mRNA, and rRNA is a component of
the ribosome required for catalysis.
In the exercise below, you will simulate the process of transcription and translation
and build a small protein. Complete the activity and then answer the questions below.
None of the processes discussed so far are free of errors. Errors can be made during
transcription if incorrect nucleotides are incorporated into the growing RNA strands.
Errors can happen during translation if incorrect amino acids are inserted into a
growing protein, or if translation is terminated too soon. Errors during gene expression
have generally short-lived effects and can be overcome by additional RNA or protein
synthesis.
Errors during DNA replication can have a much longer lasting effect. If incorrect
nucleotides are incorporated into a newly synthesized DNA strand, the error may be
passed on to future generations. Such heritable changes are referred to as mutations.
Some mutations happen due to large scale rearrangements of DNA molecules that involve
thousands or millions of nucleotides. We will limit our discussion here to small-scale
changes that involve one or a few nucleotides in the coding sequence of a gene. These
mutations include substitution of a single nucleotide base and insertion or deletion of
one or more bases.
Let us consider how different types of mutations affect the proteins encoded by DNA. The
sentence below represents a protein-coding gene. Each three letter word carries some
meaning – equivalent to each amino acid being encoded by a three-letter codon in
DNA.
-
Silent mutations. A silent mutation changes the letter, but not the
meaning. Recall that the genetic code is redundant: multiple combinations of three
bases can encode the same amino acid.
-
Missense mutations. A missense mutation changes a letter in DNA and also
changes the encoded amino acid. It changes the meaning of the message as below:
-
Nonsense mutations. A nonsense mutation changes an amino acid codon to a
stop codon, terminating transcription:
-
Frameshift mutations. A frameshift mutation occurs when one or two bases
are inserted into or deleted from a sequence. As a result, subsequent codons are
read incorrectly in new groupings of three bases each:
Deletion of one nucleotide: introduces frame shift
Deletion of three nucleotides removes information, but no frame shift.
There are many possible variations on the mutation types above. For example, three bases
may be deleted in a group corresponding to one existing codon. In this rare instance,
there would be no frame shift but a single amino acid would be missing from the encoded
protein:
Next, we apply the classification above to an actual mutation observed in human DNA.
The activity below deals with a mutation in the gene that encodes the oxygen transport
protein hemoglobin. The mutation causes hemoglobin to form long rods inside red blood
cells. As a result, it is difficult for the cells to pass through blood vessels. This
leads to a disease called sickle cell anemia in many of those who inherit the
mutation.
BRCA Gene Mutations in Breast Cancer
In this module you learned about the role of DNA as the molecule that stores genetic
information. Any damage to the DNA molecule can have serious consequences for the cell.
There are many different cellular mechanisms to repair DNA damage or to stop a cell with
errors in its DNA from dividing. The BRCA genes code for proteins involved in
detecting and repairing double strand breaks in the DNA molecule.
If there is a defect in either of the genes BRCA1 or BRCA2, that will result in increased
chances of DNA errors, which ultimately can increase the likelihood of cancer. BRCA
genes are therefore considered tumor suppressor genes. Mutations
in these genes produce a hereditary breast-ovarian cancer syndrome in affected
families.
Women with harmful mutations in either BRCA1 or BRCA2 have an increased risk of breast
cancer that is about five times the normal risk, and a risk of ovarian cancer that is
about 10 to 30 times normal. While mutations in BRCA1 and BRCA2 account for only five to
ten percent of all breast cancer cases in women, it is suggested that women with
familial breast or ovarian cancer (when several female close relatives have or had
cancer) be tested for BRCA mutations. Testing positive for BRCA mutations does not mean
the person will definitely get breast cancer, because there are many other genetic and
environmental factors involved. However, having this information may help those
individuals to take preventive measures, such as more frequent mammograms.
You have probably seen Siamese cats--those graceful creatures with darker fur on their
faces, tails, and paws. This is an example of a phenotype dependent on the interaction
between genes and environment. Modern Siamese cats have a defective tyrosinase enzyme;
tyrosinase is involved in the synthesis of melanin, the dark pigment of the skin. This
defective enzyme is inactive at normal body temperatures, but it becomes active in
cooler areas of the skin. This results in dark coloration in the coolest parts of the
body, including the extremities and the face, which is cooled by the passage of air
through the sinuses.
 By Cindy McCravey (Neighbor's Siamese) CC BY 2.0
By Cindy McCravey (Neighbor's Siamese) CC BY 2.0
In this module, we will explore the connection between DNA and phenotype on the molecular
level. We will start by clarifying the distinctions between genes, genomes, alleles, and
other related terms. We will compare prokaryotic and eukaryotic genes and genomes, and
we will look at how DNA is packaged into chromosomes with the help of specialized
proteins. We will consider how gene expression can be regulated in the cell by
interactions with other genes and environment.
Throughout the genetics unit, we have been using the terms gene, allele, and DNA, along
with several other related terms. Before we go on, we need to clarify the relationships
among these terms. First, we need to distinguish between terms that relate to actual
molecules and terms that relate to the information content of those molecules. The
macromolecule that carries genetic information is DNA, which in
the eukaryotic cell binds specialized proteins to create compact structures called chromosomes.
All the hereditary information contained within an organism is called a genome. The genome includes genes and noncoding DNA sequences. The human
genome, for example, contains the DNA sequence (information) of 22 autosomal
chromosomes, as well as the two sex chromosomes X and Y. The field of study that focuses
on the properties of genomes is called genomics, which is related
to but distinct from genetics, which focuses on individual genes
or a group of genes.
 By KES47 (Chromosome en) CC BY 3.0
By KES47 (Chromosome en) CC BY 3.0
Genes carry the information required to produce a functional
product (protein or RNA). The information is contained in the order of bases in the DNA.
This information is “read” by the cell to produce, first RNA, and then a protein, during
a process called gene expression. When a protein affects an
observable characteristic of an organism (remember, observable characteristics represent
an organism’s phenotype), the gene encoding that particular protein can be linked to
that characteristic or character (e.g.,
hair color, eye color, or height). Traits are specific
variations in characteristics (e.g., black hair or blue eyes). For example, the gene
encoding growth hormone (a protein) affects the height of an individual; in this case,
height is the characteristic, and tall or short stature are the traits. Some genes can
be linked to the development of diseases. Nearly all observable characteristics depend
upon multiple genes. Therefore, when we hear someone refer to the “obesity gene,”
“Alzheimer’s gene,” “breast cancer gene,” and so on, it is important to realize that
these labels imply (or should imply) one of the multiple genes that contribute to each
of these conditions.
What is the connection between genes and traits? We must now consider alleles, which are observed variations in the sequence of bases for a
particular gene. Two alleles of a gene may differ by a single base. On one end of the
spectrum, an allele may refer to a total deletion of a gene. A diploid organism has two
alleles of each gene, one from the organism’s mother and one from its father. The
combination of the two alleles of a particular gene is the genetic determinant of the
phenotypic traits of the organism. Note that in addition to genetic factors, environment
also contributes to traits. We will consider environmental effects in a later section.
 The arrows in the diagram show the relationships among the key terms gene, allele, trait, and character
(or characteristic). The characteristic of eye color is used
as an example to illustrate these relationships. Eye color depends upon production
of the pigment melanin. Pigment production depends upon transport of tyrosine (the
amino acid required to produce melanin) across the cell membrane. The transporter
protein is encoded by the gene OCA2. A person with brown eyes produces functional
transporter protein and plenty of pigment, leading to dark eye color. A mutation G
to A in position 1559 of the coding DNA sequence of OCA2 leads to amino acid change
in the transport protein; instead of alanine in position 481, threonine is present.
This leads to reduced function of the transporter, which in turn results in
decreased production of melanin. When the second allele is a deletion, an albino
phenotype results (pale blue eyes, pale skin and hair color).
The arrows in the diagram show the relationships among the key terms gene, allele, trait, and character
(or characteristic). The characteristic of eye color is used
as an example to illustrate these relationships. Eye color depends upon production
of the pigment melanin. Pigment production depends upon transport of tyrosine (the
amino acid required to produce melanin) across the cell membrane. The transporter
protein is encoded by the gene OCA2. A person with brown eyes produces functional
transporter protein and plenty of pigment, leading to dark eye color. A mutation G
to A in position 1559 of the coding DNA sequence of OCA2 leads to amino acid change
in the transport protein; instead of alanine in position 481, threonine is present.
This leads to reduced function of the transporter, which in turn results in
decreased production of melanin. When the second allele is a deletion, an albino
phenotype results (pale blue eyes, pale skin and hair color).
What is the difference between allele and mutation? Any change in
the DNA of an organism is called a mutation. Mutations can be
advantageous, harmful, or neutral (in which case they have no effect on the phenotype).
Mutations include large deletions and rearrangements in the DNA, but they can also be
changes in a single base. Mutation is a more general term than
allele because mutation does not necessarily involve a
specific gene, but can include deletion or rearrangement of multiple genes. Multiple
alleles of a gene arise by mutation, and they will be passed on to the offspring and
will persist in the population.
In the previous module, we mentioned different kinds of genes. Some genes produce
functional RNA (rRNA and tRNAs), but most genes code for proteins. Remember that a gene
is information residing in the order of bases in a DNA molecule. The general
organization of information of any gene can be represented as follows:
In this module, we will focus on the structure of the protein-coding genes. A
protein-coding gene contains information for making the mRNA that is translated into a
protein. First, let’s consider what kind of information in the mRNA is required to
produce a protein during translation, and then we will step back and look at the
information in the gene that is required for transcription.
To encode a protein, mRNA needs a protein-coding region and regulatory regions. The
coding region of the gene (and the coding region of mRNA) has to start with a start
codon: ATG in DNA and AUG in mRNA code for the amino acid methionine, Met. The coding
region of a gene always ends with a stop codon TAA, TAG, or TGA (in mRNA, these will
have a U instead of a T). The sequence between start and stop codons should contain
nucleotides in multiples of three, encoding the sequence of amino acids in the protein.
The untranslated regulatory regions (denoted by UTR) include a site for the ribosome to
bind before the start codon (5’ UTR) and a region after the stop codon (3’ UTR). Both 5’
and 3’ UTRs can bind specific proteins involved in regulation of translation (how fast
new protein product is built, how fast mRNA is degraded).

Note that mRNA in the figure above starts with 5’ UTR, not with the start codon. The
start codon signals the start of translation, not transcription. Next, we will consider
DNA regions required for transcription.
Genes include regulatory regions at the beginning and the end of the transcribed DNA:
- The promoter region of the gene “promotes” transcription by
binding RNA polymerase.
- The terminator region signals the end of transcription.
- Regulatory regions before and after the transcribed region bind regulatory proteins.
These proteins activate or inhibit transcription, depending on the signals from
within the cell or from the environment.
Putting the regulatory signals associated with RNA production together with those signals
on the mRNA, we can represent the central dogma of molecular biology with the following
diagram:
After considering individual genes, let’s zoom out and consider a more global view: how
genes are organized into genomes.
The prokaryotic genome resides on a circular piece of double-stranded DNA; there is no
membrane to separate DNA from the rest of the cell. Most bacterial genomes are several
million nucleotides long. The E. coli genome, for example, is
approximately 5 million nucleotides long. Although this is a relatively small genome,
the physical length of the DNA is longer than the length of the bacterial cell. In order
to condense the DNA into a smaller size, the DNA is supercoiled. In supercoiled DNA, the
double helix of the DNA contains additional turns beyond the normal one turn per 10 base
pairs. These additional twists introduce strain into the DNA that is relieved by
large-scale twists in the entire DNA molecule, or supercoils. A good model for
supercoiling is an old-fashioned spiral phone cord. If you form the cord into a circle,
and then rotate or twist one of the free ends relative to the other, you will introduce
supercoils into the cord.

Many bacteria contain smaller, circular DNA molecules, called plasmids, in addition to the large DNA molecule that is their chromosome.
Plasmids can replicate independently of the large DNA and can be transferred to other
cells. Some naturally occurring plasmids carry genes encoding toxins and proteins that
make bacteria resistant to antibiotics.
 By Spaully(Wikipedia) (Plasmid) CC BY-SA
2.5
By Spaully(Wikipedia) (Plasmid) CC BY-SA
2.5
Plasmids provide a very useful tool for biotechnology. Scientists use them to insert
“foreign” genes into bacteria so they can use the bacteria as “factories” to produce
desired proteins. For example, to study a human disease caused by a malfunction in a
specific protein, scientists need a large amount of the protein for experiments. Instead
of purifying protein from human cells, scientists can combine coding DNA from the human
genome with bacterial regulatory DNA regions on a plasmid, and introduce the plasmid
carrying human gene into the bacteria. Growing a large amount of bacterial cells is much
easier than obtaining large amounts of human cells. Combining DNA from different
organisms is called recombinant DNA technology.
A eukaryotic genome resides on multiple linear DNA molecules in the nucleus. Each of
these DNA molecules is called a chromosome. Eukaryotic cells
also contain DNA in mitochondria and chloroplasts; mitochondrial and chloroplast genomes
are circular like those of bacteria, and are typically considered separately from
eukaryotic genomes.
In general, eukaryotic genomes are much larger than prokaryotic genomes, and they contain
a lot more noncoding DNA. This presents a problem of packaging for eukaryotic -cells:
how are they to fit very large DNA into a small compartment? Although eukaryotic DNA is
supercoiled, this isn’t enough to solve the packaging problem. Eukaryotic cells use
special proteins (histones) to wind up DNA and fold it into nucleosomes, which are compact structures. DNA can be transcribed in this
state. Further packaging of DNA into highly compact fibers makes genes inaccessible for
transcription, leading to gene silencing. Gene silencing is an
important way of regulating gene expression.
 Packaging of DNA in Eukaryotes. Nucleosomes are formed by DNA looping around a
collection of proteins called histones. Genes that are
actively undergoing transcription can be found in nucleosomes. In the case of
inactive (silenced) genes, the DNA is further compacted into thick fibers of the
DNA-histone complex. By Richard Wheeler (Chromatin
Structures) CC BY-SA
3.0
Packaging of DNA in Eukaryotes. Nucleosomes are formed by DNA looping around a
collection of proteins called histones. Genes that are
actively undergoing transcription can be found in nucleosomes. In the case of
inactive (silenced) genes, the DNA is further compacted into thick fibers of the
DNA-histone complex. By Richard Wheeler (Chromatin
Structures) CC BY-SA
3.0
The shape of the chromosomes changes throughout the cell cycle. For example, when a cell
needs to divide, DNA is further compacted by the addition of scaffolding proteins that
help divide copies of the chromosomes equally. The most compact shape of the chromosomes
can be observed during cell division.
 The shape of the chromosomes changes throughout the cell cycle. For example,
when a cell needs to divide, DNA is further compacted by the addition of scaffolding
proteins that help divide copies of the chromosomes equally. The most compact shape
of the chromosomes can be observed during cell division. By Richard Wheeler (Chromatin
Structures) CC BY-SA
3.0
The shape of the chromosomes changes throughout the cell cycle. For example,
when a cell needs to divide, DNA is further compacted by the addition of scaffolding
proteins that help divide copies of the chromosomes equally. The most compact shape
of the chromosomes can be observed during cell division. By Richard Wheeler (Chromatin
Structures) CC BY-SA
3.0
How DNA is Packaged
In the previous sections of this module, we discussed the structure and organization of
genes and genomes. Throughout the molecular genetics module, we have been pointing out
the connections between genotype and phenotype. Here, we will discuss the other
important factor in determining the phenotype of an organism: environment. The effects
of environment on phenotype can be fairly subtle or pretty dramatic. In certain groups
of cold-blooded animals, such as Nile crocodiles, sex is determined by an environmental
factor: average temperature during the middle third of the incubation period. Males will
only hatch at temperatures between 89.1° and 94.1°F. Nests with higher or
lower temperatures will produce predominantly females.
How does environment exert its influence on phenotype? Recall that at the molecular and
cellular levels, phenotype depends on the molecules produced by the cell. Production of
all molecules is catalyzed by protein enzymes that are encoded by the genome of the
organism. Ultimately, if phenotype depends on protein function, then the environment
must have a way of modifying the amount and the activity of proteins. Using the central
dogma of molecular biology, we can deduce that environment may affect protein function
at the level of protein, mRNA, or DNA.
Changes in protein function
Cells and organisms have to respond to changes in their environment. An organism
that experiences a sudden increase in temperature will respond with increased
expression of genes coding for heat-shock proteins; these proteins protect cells
from damaged and unfolded proteins. A bacterial cell that depletes glucose in
its environment will not die of starvation if an alternative energy source is
available. In the presence of lactose, bacteria can "turn on" the lac operon
containing genes required for metabolism of lactose. Regulation of this operon
will be discussed in detail on the next page. The signaling occurs primarily
through binding interactions between molecules and modifications of the proteins
that often lead to changes in gene expression. These changes are short-lived and
are not heritable.
Changes in DNA sequence
Long-term heritable changes can be produced by the environment at the level of
DNA. Any environmental influence that can damage DNA has the potential to create
mutations that can result in changing amino acid sequence of a protein or
regulatory information. For example, high-energy radiation causes
double-stranded breaks in DNA that can lead to deletions. UV light causes single
nucleotide changes in DNA. Environmental toxins and viruses also cause
mutations. Cumulative DNA damage in somatic cells throughout an organism’s
lifetime contributes to the aging process. Only mutations in germ cells result
in heritable changes passed on to the next generation of offspring.
Heritable changes in gene expression can occur via changes in DNA sequence or in
DNA packaging. Mutations in regulatory regions of the gene can lead to increased
or decreased protein production without affecting the amino acid sequence of the
protein. One example of such mutation is found in the regulatory region of the
human LCT gene on chromosome 2. The LCT gene codes for the enzyme lactase,
required for breaking down lactose into glucose and galactose. In many adults,
expression of the LCT gene is turned off or turned down, resulting in little or
no lactase production. Lack of lactase in the intestines can lead to
gastrointestinal distress (bloating, cramps, diarrhea, etc.) after consumption
of moderate to large amounts of dairy products, giving rise to a condition
called lactose intolerance. Other people are able to
produce lactase well into adulthood. This ability has been linked to mutations
in the regulatory region of the lactase gene that allow gene expression to
continue after childhood.
Changes in DNA packing
Heritable changes in DNA packaging do not involve any changes in DNA sequence.
This type of inheritance is epigenetic (from the Greek
epi-, meaning over, above, or outside). You will recall from the previous page
that compact packaging of DNA leads to gene silencing (transcriptionally
inactive genes). Compact packaging of DNA requires modifications to DNA itself
and to histones, which are DNA-binding proteins involved in packaging. DNA
modification involves the addition of a methyl group (-CH3) to
specific bases on DNA (cytosine methylation), but does not change the sequence
of DNA bases. The methylation pattern can be preserved during DNA replication,
so the daughter cells will have the same methylation pattern as the parent cell.
In germ cells, the pattern of DNA methylation can be passed through the gametes
to the next generation of offspring.
One example of epigenetic silencing in somatic cells is common to all female
mammals. One of the two X chromosomes in females is inactivated by epigenetic
mechanisms (DNA methylation and histone modifications). The results of
X-inactivation can be observed in calico or tortoiseshell cats. These cats are
almost always female. The gene encoding the coat color resides on the X
chromosome. A female cat (with two X chromosomes) could potentially carry one
allele for a black coat and one allele for an orange coat. As a result, her
phenotype will end up with patches of two different colors. This is because
cells that inactivate the X chromosome with the black allele will express the
orange allele, and after multiple cell divisions, a patch of orange fur will
result. Cells that inactivate the X chromosome carrying the orange allele will
give rise to black patches. The specific pattern of black and orange patches is
not heritable because X-inactivation is random.
 By Michael Bodega (6-year old tortoise shell cat) Public Domain
By Michael Bodega (6-year old tortoise shell cat) Public Domain
Epigenetic regulation and inheritance has been linked to cancer and obesity, aging and
longevity, and other important processes. It is the key mechanism for interactions
between genes and environment. Unlike the genome, which remains fairly unchanged
throughout an organism’s life cycle, the epigenome (consisting of the pattern of DNA
methylation and histone modifications) is dynamic, responds to the environment, and can
be heritable.
In summary, environment can influence phenotype by interacting with the genome in the
following ways:
- Environmental signals can change gene expression by affecting regulatory
proteins.
- Environmental signals can change DNA packaging, which affects gene expression.
- Environmental mutagens can cause mutations in DNA.
In this spotlight, we will explore in more detail changes in gene expression
(transcription) due to changes in the environment. Eukaryotes have complex regulatory
mechanisms; consequently, we will focus on gene regulation in prokaryotes. However,
common principles of regulation are used by both prokaryotic and eukaryotic organisms,
and an understanding of regulation in prokaryotes will help you understand eukaryotic
regulation in future studies.
Many bacterial genes are expressed at the same time as part of an operon. The expression
of the genes in the operon is controlled by a repressor protein. The repressor protein
will bind to the regulatory region at a DNA sequence. This sequence is the
operator. When the repressor is bound to the DNA, RNA polymerase cannot
transcribe the structural genes because it is blocked by the repressor protein bound on
the DNA; under these conditions, none of the enzymes required for the pathway is
produced. Whether or not the repressor binds to the operator is controlled by the
binding of a small molecule to the repressor. The small molecule is either the compound
that enters the pathway (for catabolic, or degradative pathways) or the compound that is
produced by the pathway (for anabolic, or synthetic pathways). The compound binds to the
repressor protein and causes the repressor either to bind to the DNA (this is called
positive control), turning off transcription, or to be released from the operator site
on the DNA (this is called negative control), turning on transcription. You will explore
both of these control mechanisms in the spotlight below.
 The Bacterial Operon. The operon contains the promoter (green box), the
operator sequence (red box), and two or more structural genes that code for
structural proteins. If the operon is associated with metabolic pathways, the
structural proteins would be the enzymes in the pathway. In addition to the genes in
the operon, there is a separate gene that codes for the repressor protein, so its
transcription is independent of the transcription of the operon. The repressor
protein controls the expression of genes in the operon by binding to the operator
DNA sequence, blocking the ability of RNA polymerase to transcribe the structural
genes (A-C) for the operon. When the repressor is not bound to its operator, RNA
polymerase can transcribe the operon and it will produce one long mRNA transcript,
containing the coding information for the structural proteins.
The Bacterial Operon. The operon contains the promoter (green box), the
operator sequence (red box), and two or more structural genes that code for
structural proteins. If the operon is associated with metabolic pathways, the
structural proteins would be the enzymes in the pathway. In addition to the genes in
the operon, there is a separate gene that codes for the repressor protein, so its
transcription is independent of the transcription of the operon. The repressor
protein controls the expression of genes in the operon by binding to the operator
DNA sequence, blocking the ability of RNA polymerase to transcribe the structural
genes (A-C) for the operon. When the repressor is not bound to its operator, RNA
polymerase can transcribe the operon and it will produce one long mRNA transcript,
containing the coding information for the structural proteins.
Lac Operon
Bacteria can use a wide variety of carbon sources as fuel to extract energy for
growth. Two common carbon sources are the sugars glucose and lactose (milk
sugar). Glucose is a monosaccharide containing one six-membered ring, while
lactose is a disaccharide made of glucose linked to galactose.
It is less efficient for bacteria to use lactose as an energy source because they
must take additional steps to convert lactose into a form that can be used to
extract energy. Each of these steps requires the synthesis of an enzyme, which
is costly to the bacteria. Consequently, bacteria prefer to use glucose rather
than lactose as a fuel source when both sugars are present. However, when
lactose is present and glucose is not, the bacteria “turn on,” or synthesize,
the enzymes required for lactose metabolism, allowing the bacteria to use
lactose for energy.
The genes for lactose metabolism are contained in an operon known as the lac operon. The lac operon is controlled by the lac
repressor, which is produced from the lacI gene. The lacI gene has its own
promoter; consequently, low levels of the lac repressor protein are present all
of the time. Three structural genes in the operon, lacZ, lacY, and lacA, encode
enzymes required for lactose metabolism.
Thus far, we have described what happens when either glucose is present or
lactose is present. If both are present, glucose is used first by the bacteria,
and only very small amounts of the enzymes for lactose metabolism are made.
Complete the following Learn by Doing to understand how glucose turns off the
lac operon, even if lactose is present.
Regulation of Biosynthetic Pathways
The enzymes for the synthesis of the amino acid tryptophan are contained
in the Trp operon. The structure of this operon is shown below. The trp
repressor binds the amino acid tryptophan, the end product of the
biosynthesis of tryptophan (trp). As you can see, it has the same
structure as the lac operon, but it contains more genes for the
biosynthesis of trp.
The ability to manipulate DNA has led to dramatic changes in medicine, agriculture, and
many other aspects of society. For example, genes from other species are transferred
into crop plants and livestock to provide them with desired traits. And many drugs are
produced by bacteria, yeast, or other organisms that have been engineered to express
human genes.
In this module, you will learn about how biotechnology is used to produce human growth
hormone (huGH) for medical applications. HuGH is a protein made of 191 amino acids. It
is necessary for the normal growth and metabolism of an individual. Worldwide, one in
4,000 to 10,000 individuals is born without the ability to make sufficient human growth
hormone, causing a host of medical problems. These people can be helped with growth
hormone injections, but growth hormone from other species (pigs, cattle) cannot be used.
Only human growth hormone will produce the desired effects. Historically, the only
source of human growth hormone was a small amount that could be extracted from recently
deceased individuals (cadavers). this severely limited the supply that was available for
medical use.
You will also learn about how biotechnology has solved this problem and
decreased the cost of medical treatments that significantly improve the quality of life
for many people.
The basic steps in producing human growth hormone (HuGH) in bacteria are:
- generation of a synthetic gene
- inserting this gene into a bacterial expression plasmid,
- introducing the plasmid into bacteria,
- production and purification of the human growth hormone.
The synthetic gene provides the information that specifies the order of the amino acids
in HuGH. The expression plasmid is a large closed circular piece of DNA. Various DNA
sequences on the expression plasmid are required for maintenance of the plasmid in the
cells. These sequences are present on all plasmids, regardless of the type of protein
that is being made. The plasmid also contains DNA sequences (promoter for RNA
polymerase, lac operator) that are required for the production of the mRNA that encodes
HuGH. The bacterial cell provides the protein synthesizing machinery so that the mRNA
can be translated to a protein. In order for the protein to be correctly made the mRNA
must contain a ribosome binding site, a start codon, and a stop codon.
More recently, proteins used for medical treatment are produced in yeast or cultured
mammalian cells that are grown in synthetic growth media. Protein production in yeast or
mammalian cells avoids the possibility of having toxic bacterial impurities in the final
product. The overall steps in producing the protein in yeast or mammalian cells are very
similar to the steps described here, however the overall cost of producing the protein
may be somewhat higher.
 Growth of mammalian cells in tissue culture. The sterile plastic dish holds
synthetic media (red liquid) that supports the growth of mammalian cells
Growth of mammalian cells in tissue culture. The sterile plastic dish holds
synthetic media (red liquid) that supports the growth of mammalian cells
 Steps in the production of Human Growth Hormone in Bacteria.
Steps in the production of Human Growth Hormone in Bacteria.
- A synthetic gene is made that can be translated into the amino acid sequence of the
human growth hormone.
- This gene is inserted in the correct location in a closed circular piece of DNA (an
expression plasmid) by use of restriction sites.
- The expression plasmid is introduced into bacteria.
- The bacteria are grown to a high cell density, and then lactose is added to induce
the production of human growth hormone.
The first step in producing HuGH is to generate a synthetic gene whose nucleotide
sequence codes for the amino acid sequence of the growth hormone. This sequence would
contain the start codon, codons representing each amino acid in the growth hormone, and
a stop codon. To do this, the known amino acid sequence for human growth hormone must be
“back-translated” to a nucleic acid sequence. Since most amino acids can be coded for by
more than one mRNA codon, this process is ambiguous. Because the genetic code is
universal it would be possible to use the human codons to encode the sequence of amino
acids. However, the host organism (which is bacteria in this example) often prefer
certain codons over others, so the preferred codons must be used to optimize protein
expression.
We will synthesize our HuGH gene using a chemical method called solid-phase synthesis. In
this method, the first base of our DNA sequence is attached to a small glass bead. The
next base is then added to the first, and so on, until the sequence is completed at
which point the DNA is released from the glass bead. Any desired DNA sequence can be
generated by this method. Current technology limits this approach to about 200 bases. If
our gene is longer, we have to make it in segments and then join the individual segments
together.
 Chemical synthesis of DNA. The first base (A) is attached to a glass bead
(blue sphere). The next base (G) is added, followed by the third base (T). This
process is repeated until the entire DNA strand is completed. The linkage to the
glass bead is then broken, and the completed DNA molecule is released. In contrast
to the direction of synthesis by DNA polymerases (5’->3’), the chemical synthesis
of DNA is in the reverse direction, beginning at the 3’ end. The above diagram shows
the synthesis of 5’-TGA-3’.
Chemical synthesis of DNA. The first base (A) is attached to a glass bead
(blue sphere). The next base (G) is added, followed by the third base (T). This
process is repeated until the entire DNA strand is completed. The linkage to the
glass bead is then broken, and the completed DNA molecule is released. In contrast
to the direction of synthesis by DNA polymerases (5’->3’), the chemical synthesis
of DNA is in the reverse direction, beginning at the 3’ end. The above diagram shows
the synthesis of 5’-TGA-3’.
In addition to the codons, it is necessary to add additional sequences to the end of the
gene to facilitate the insertion of our synthetic gene into the expression plasmid.
These sequences are called restriction sites. Consequently the complete gene is:
After you have generated your synthetic gene, you must insert the gene into an expression
plasmid so it can be placed inside a living bacterial cell and translated into the HuGH
protein. We will look at that step in detail on the next page. For now, let’s assume
that has been accomplished. Here we want to focus on the properties of the expression
plasmid.
An expression plasmid is a closed circular molecule of DNA that has several unique
properties associated with its DNA sequences. There are three general types of sequences
that are found on expression vectors:
- Sequences involved in maintaining the plasmid in the cell.
- First, the expression plasmid contains a section of DNA that is an origin of
replication. This ensures that when it is placed into a bacterial host cell, it will
be successfully replicated. The origin of replication on the plasmid is similar to
the origin of replication that is found on the bacterial chromosome.
- The expression plasmid must also contain a section of DNA that encodes a protein
that will confer antibiotic resistance on the bacterial cells that contain the
plasmid. This provides a method to select the bacterial cells that contain the
plasmid, because if they have the plasmid, they will be able to grow in the presence
of an antibiotic while cells that do not have the plasmid will die.
- Sequences that allow the insertion of the synthetic DNA into the plasmid.
- These are short DNA sequences that are recognized by restriction endonucleases, in
the case of this plasmid they are the EcoR1 and BamH1 sites. Restriction
endonucleases cut the DNA at these sequences, allowing the insertion of the
synthetic gene between the sites. The actual mechanism is discussed in the next
section.
- Sequences involved in transcribing the DNA to mRNA.
- The expression plasmid must also contain a promoter that is recognized by RNA
polymerase. This promoter is adjacent to the growth hormone gene and will enable
the transcription of the growth hormone gene into mRNA.
- The expression plasmid must contain a DNA sequence that allows a repressor protein
to bind. The repressor protein can then act as an on-off switch for mRNA
production. An on/off switch is important because the production of growth
hormone can interfere with cell division and the production of the growth
hormone should be off until a sufficient number of cells are obtained. The
most common repressor protein that is used is the lac repressor. The lac
repressor binds to a specific DNA sequence called the lac operator. You may
want to review the properties of the lac
operon. The addition of an inducer molecule, such as
lactose, will cause the repressor to fall off of the DNA, allowing RNA
polymerase to produce mRNA. It is important that the operator sequence is
placed between the promoter and the DNA that encodes the mRNA so that mRNA
cannot be made unless an inducer is added.
- Sequences involved in translating the mRNA to Protein
- The expression plasmid must have a DNA sequence that will encode a ribosome binding
site on the mRNA. This sequence, which will be found at the beginning of the
mRNA, will allow the mRNA to bind to the bacterial ribosome, initiating the
process of protein synthesis. This segment must be part of the mRNA and it
has to occur just before the start codon to position the mRNA correctly on
the ribosome.
 Summary of DNA sequences in the expression plasmid and their role in mRNA and
protein production.
Summary of DNA sequences in the expression plasmid and their role in mRNA and
protein production.
The step of inserting our synthetic DNA into the plasmid use two very important enzymes,
restriction enzymes and DNA ligase. Restriction endonucleases are
enzymes that recognize specific DNA sequences, such as GAATTC, and cut
both strands of the DNA within these sequences. Typically four or six bases are
recognized. Restriction enzymes are isolated from a number of bacterial
species and the name of the enzyme reflects the original species. For example, the
restriction enzyme EcoR1 was isolated from Escherichia coli. The
normal biological function of restriction endonucleases is to protect the bacterial
species from viruses by digesting the viral DNA as it enters the cell. Of
course, the bacteria shouldn’t digest their own DNA. Consequently, they have companion
enzymes called DNA methylases, which add methyl groups to the bacterial
DNA, protecting it from digestion.
There are hundreds of different restriction enzymes, each of which recognizes and cleaves
a different DNA sequence or “restriction site”. Examples of two such enzymes are shown
below. A shorthand notation for the recognition site is given below each name. The “^”
symbol indicates the site of cleavage. The DNA sequence that they recognize is shown on
the left and the products of the digestion are shown on the right. The fragments that
are produced after cleavage can contain single stranded overhangs (e.g. EcoR1) or have
blunt ends, such as with PvuII.

The DNA sequences that are recognized by restriction endonucleases have a unique property
in that the sequence on the top strand is identical to the sequence on the bottom
strand, i.e. in the case of EcoR1 the sequence of the top strand is 5’-GAATTC. Taking
the complement of that sequence to generate the bottom strand gives: 5’ GAATTC. The
other notable feature is that the cutting position is in the same location on both
strands. Using EcoR1 as an example, the enzyme cuts between the G and the A. The
symmetry in the recognition sequence and the cutting location is due to the fact that
the active form of these enzymes contain two identical polypeptide chains. You can
imagine that one chain recognizes and cleaves the top strand. The second chain, because
it is identical to the first, recognizes the same sequence on the other strand and
cleaves in the same location.
 Cartoon diagram of EcoR1. The two blue rectangles represent the two identical
subunits of the enzyme. The red arrow marks the cleavage location.
Cartoon diagram of EcoR1. The two blue rectangles represent the two identical
subunits of the enzyme. The red arrow marks the cleavage location.
If the restriction enzyme does not cut at the center of its recognition sequence the
cleavage products will contain short single-stranded segments of DNA. These are often
called “sticky-ends” because they can stick to other DNA molecules that have
complementary sticky ends. Enzymes that cut in the middle of their recognition sequences
produce blunt end fragments.
Below, the formation of sticky ends after EcoR1 cleavage is illustrated.
Because cleavage does not occur in the middle of the recognition sequence, the products
have short single strand segments (highlighted). These sticky ends can “stick” to
complementary single-stranded DNA sequences using normal DNA basepairing (A-T, G-C).
The presence of sticky ends on DNA fragments makes it easy to join DNA fragments. If two
fragments are both cut with the same restriction enzyme, they will have complementary
sticky ends. These will align and bind loosely to each other: hydrogen bonds will form
between complementary bases.
At this point, the two fragments are not firmly held together by covalent bonds; the
sugar-phosphate backbone is still broken on both strands. DNA ligases can be used to
rejoin DNA after it has been cut with the restriction enzyme. This reaction requires
energy (usually ATP) and requires that the two pieces of DNA that are being
joined are close to each other. Since the sticky ends hold the two ends close together
it is easy for DNA ligase to join the fragments, reforming the phosphodiester bonds on
both strands.
Although most of the time DNA fragments are joined using sticky ends, it is possible to
join fragments that are blunt ended. This is more difficult however because there are no
hydrogen bonds to hold the DNA fragments together.
Insertion of the Human Growth Hormone Gene Into the Expression
plasmid
Restriction endonucleases and DNA ligase are used to insert the synthetic gene
into the correct location in the expression plasmid, just after the ribosome
binding site.
The expression plasmid would have two different restriction sites after the
ribosome binding site to facilitate the insertion of the synthetic gene. To
utilize these sites it would be necessary to include these restriction sites at
the end of our synthetic gene. The expression plasmid and the synthetic fragment
would be cut with the restriction enzymes, mixed, and then treated with DNA
ligase to re-seal the phosphodiester backbone:
 Detailed process of joining the huGH gene to the
expression plasmid. Both the plasmid and the huGH gene are cut with EcoR1
(G^AATTC) and BamHI (G^GATCC), generating sticky ends on both DNAs (bold text).
After mixing the cut plasmid and huGH gene, the sticky ends pair by hydrogen
bonding (highlight), bringing the DNA molecules close so that they can be
ligated by DNA ligase.
Detailed process of joining the huGH gene to the
expression plasmid. Both the plasmid and the huGH gene are cut with EcoR1
(G^AATTC) and BamHI (G^GATCC), generating sticky ends on both DNAs (bold text).
After mixing the cut plasmid and huGH gene, the sticky ends pair by hydrogen
bonding (highlight), bringing the DNA molecules close so that they can be
ligated by DNA ligase.
 Combined expression plasmid - synthetic gene
before ligation. The paired sticky ends are highlighted in yellow.
Combined expression plasmid - synthetic gene
before ligation. The paired sticky ends are highlighted in yellow.
Once the synthetic gene has been successfully spliced into the expression plasmid, the
complete expression plasmid must be taken into the bacterial cell. This is a delicate
process that must take place under special conditions. In these conditions, the
expression plasmid is mixed with bacterial cells, allowing some of the cells to take up
one circular DNA molecule. The origin of replication on the expression plasmid will
cause the bacteria to replicate the plasmid along with its own chromosomal DNA. It is
not possible to determine which cells have taken up the expression plasmid.
Consequently, the cells are grown in the presence of an antibiotic and only those cells
who have obtained the expression plasmid will live because of the gene for antibiotic
resistance that is also present on the expression plasmid.
Production of HuGH
The cells containing the plasmid would be grown in culture media to a high
density of cells to produce a high yield of huGH. Lactose would be added to the
culture to cause the lac repressor to come off the DNA. This allows RNA
polymerase to begin transcription of the growth hormone gene on the plasmid. The
mRNA would be translated on the bacterial ribosomes, producing human growth
hormone.
Thus far you have learned a great deal about how cells function. In the genetics units
you’ve learned how biological information is inherited and used. You are beginning to
appreciate that each cell and organism is a complex and highly integrated unit.
 Life changes and evolves over time. Evolution considers how life changes from
one generation to the next and how these changes accumulate over very long periods.
Life changes and evolves over time. Evolution considers how life changes from
one generation to the next and how these changes accumulate over very long periods.
Evolution builds on what you already know. It is a scientific theory that explores life
on a different scale and provides another layer of explanation (Table 1). First, it goes
beyond the brief lifetimes of individual organisms. Instead, evolution considers how
life changes from one generation to the next and how these changes accumulate over very
long time scales. Second, evolution is focused on collections of individuals:
populations, species, and larger taxonomic groups (for example, birds or flowering
plants). Evolution also adds another layer of explanation to biological thinking. So far
we have focused mainly on “how” questions. How does a cell maintain homeostasis? How is
information passed from parents to offspring, and how is that information used to
construct living cells? Evolution helps us answer “why” questions: Why do cells of very
different organisms have so much in common? Why are cave fish blind? Rather than taking
the features of life as a starting point, evolution asks why those features exist today
and how they originated in the past.
Characteristics of Evolutionary Theory
| Attribute |
Characteristics |
| Time scale |
Generations to much longer time scales |
| Level of hierarchy |
Populations to larger collections like taxonomic groups |
| Level of explanation |
Explores “why” questions. Why do features of life exist as they do?
What is their history? |
As a scientific theory, evolution is more than a mere opinion or guess. In science, a
“theory” is a broad explanation that is supported by a great deal of evidence and
continues to inspire productive research. Scientists accept and use evolutionary theory
because it is so strongly supported by evidence from many different sources. It fits our
observations of the diversity and variability of physical traits in animals in different
settings. The theory is now also supported by consistent and reproducible data gathered
from fossils, a detailed understanding of the skeletal and organ structure of living
organisms, and our twenty-first century abilities to examine and determine the structure
and function of proteins and DNA in living things. Since the theory of evolution was
first put forth in the 1850s and since some of the supporting evidence is based in
ancient fossils, you might get the impression that evolution occurred in the past and is
complete. That is not correct. In fact, evolution continues all around us today and
evolutionary ideas are being applied to solve a huge range of problems of both academic
and practical interest! Below are a few examples. You will learn about some of them in
this unit. Evolutionary theory and models are used to:
- Combat drug resistance in disease-causing pathogens
- Fight against fast-evolving insect pests and weeds
- Figure out the origins of modern languages
- Design better products and software
- Develop targeted vaccines against seasonal influenza
- Discover the genes underlying human diseases
Evolution is that and much more. In the first module, we will introduce and define the
biological theory of evolution. In the second module we will focus on relatively
fast and subtle changes that occur within populations (microevolution). In the
third module we will consider the much more dramatic changes that occur over
long time scales and generate the diversity of life (macroevolution). As you
learn, try to maintain an open mind and evaluate the evidence on its own merits.
You will gain a better understanding of a scientific theory that is very
influential in our society.
People have been grappling with questions about the origins of life for nearly as long as
we have been in existence. Every society has addressed these questions based on the
information that was available at that time and place. Before the Scientific Revolution,
people used many different sources of information to answer questions about the origins
of life. Some of their ideas were based on direct observations, but many of them
involved supernatural beings or spiritual forces. Stories were told to explain how the
world and humans were made, but also to address questions of meaning: why the world
exists and what human life is “for.” Ideas were passed down as oral tradition (myth and
folklore) or in the written documents of organized religions. Scientific study is much
more narrowly focused on close examination of processes and objects in the natural
world. In order for an explanation to be considered scientific, it must be based on
verifiable observations. It must be possible to test it through observations or
experiments. Ideas or explanations that do not meet these criteria are not necessarily
“bad” or “wrong,” but they are unscientific.
Scientific and non-scientific views are separate but potentially complementary ways of
knowing. Scientific methods can be used to answer direct, factual questions about “what
is” and “what probably was” through a clear procedure of observation and testing.
Through an ongoing process scientists select ideas that best fit the available data. No
religious tradition revealed the existence and function of DNA to humans: that was the
fruit of scientific study and reasoning. However, answers derived from science are
limited. They do not necessarily help with ultimate questions of meaning (why the
Universe exists in the first place, what humans should be or do). Non-scientific ways of
looking at the world (religion, philosophy) are more directly focused on these
questions. Many scientists embrace religious ideas about the meaning and ultimate
origins of life. However, they do not publish these ideas in scientific journals or used
them to explain their detailed observations of the natural world.
In this course, we will focus on how the scientific community understands evolution and
the origins of life. Like the community of science itself, we will restrict our scope to
fairly narrow questions of how and when things probably happened, based on what we can
observe today. Other explanations are better suited to philosophy or religion courses;
they help us explore broader questions about why the Universe exists and what our place
is within it.
Before defining the modern theory of evolution, we will consider its historic roots. You
probably know that the scholar most widely recognized as the author of the theory of
evolution was Charles Darwin. The first statement of modern evolutionary theory was his
book On the Origin of Species, published in 1859. But Darwin didn’t make up the theory
from nothing, and he wasn’t the first to ask questions about the ultimate origins of
life. How did science deal with life’s big “why” questions before evolutionary theory
developed? What clues led scientists to propose and embrace evolution? To gain some
insights into these questions, explore the Learn By Doing activity below.
After Darwin, science has continued to reinforce, refine, and modify the theory of
evolution. Two major developments were particularly important. In the early 1900s,
scientists rediscovered Mendel’s genetic principles and applied them to evolution.
Theorists developed models of how the gene pool of a population could change over time.
Field biologists observed such changes in fruit flies and other short-lived organisms.
Lab experiments also demonstrated the effects of natural selection. With a focus on
genetics, these advances reinforced the idea of natural selection. In 1953 James Watson
and Francis Crick discovered the structure of DNA. This laid the groundwork for an
explosion of information that continues today. Inherited information now can be analyzed
directly and in detail. Comparisons of DNA in different species support their common
ancestry. DNA analysis also pinpoints the genetic mutations that produce new adaptive
traits in organisms. To Learn More: A comprehensive database of Darwin-related
publications, images, commentary and more are available free online at http://darwin-online.org.uk/. A more
detailed history of evolutionary thought is available from the University of California
Museum of Paleontology at http://evolution.berkeley.edu/evolibrary/article/0_0_0/history_01.
Before we begin our exploration of microevolution, let’s review a few principles that we
have already covered in this course. The principles of evolution are based in genes;
therefore, it is important that we remember that genes are segments of DNA
that have "meaning." Genes are sequences of DNA that encode particular
RNA and protein molecules, which work together to give a
cell and an organism its characteristics and functions, whether they be physical,
chemical, or behavioral. Most genes have multiple forms, called alleles,, discussed
previously in the Heredity module of the Classical Genetics
unit. For example, pea plants have a gene that determines seed color, and the different
forms (alleles) of that gene are "green seed" and "yellow seed."
When you studied inheritance, you often were thinking about crosses: two individuals
mating to produce offspring. As we study microevolution, we will be backing up to think
about how inheritance works within larger groups. You will need to understand and use
the following terms: species, population, and gene pool. The illustration below shows an
example of how a species, population, and gene pool are related.
 All humans are members of the same species. A group of people on an island, as
shown on the left, make up a population. That same group of people also make up a gene
pool. A gene pool is the sum total of all alleles available within a
species at a specific location and time. By University
of Maryland University College
CC-BY-NC
All humans are members of the same species. A group of people on an island, as
shown on the left, make up a population. That same group of people also make up a gene
pool. A gene pool is the sum total of all alleles available within a
species at a specific location and time. By University
of Maryland University College
CC-BY-NC
In this course we will define a species as a group of organisms
whose members can and will breed with each other to produce fertile offspring. A population is all the individuals of the same species that occupy
the same area and are likely to breed with one another. Some examples of a population
might be all the people that live in your state, all of the frogs that live near a pond,
all of the grizzly bears that live in Denali National Park, or all the dandelions that
live in your hometown.
There are two defining aspects to a population. A population is strictly composed of
members of the same species. For example, a population would always consist of people
or of grizzly bears, but never of both people and grizzly bears. Second, the members of a population occupy
the same area. Scientists define the area based upon the problem they are studying. In
evolutionary studies, biologists try to define populations based on actual patterns of
breeding, so that individuals most often breed within their population groups; migration
and mixing between populations is less frequent.
You might wonder how a species and a population are different from one another.
Populations are subsets of a species. The dandelions in Boston, Massachusetts and those
in Annapolis, Maryland belong to separate populations. They are not likely to breed with
one another because their pollen doesn't travel that far. However, the Boston dandelions
and the Annapolis dandelions do belong to the same species. They could breed with one another if conditions allowed. For example, breeding
could occur if a human being carried dandelion pollen from Boston to Annapolis.
The gene pool is all of the genes and alleles present in a
population at some point in time. Just as the genotype is the genetic composition of an
individual, the gene pool is the genetic composition of a population.
The pea plant example only looks at one trait of the plants, seed color, but there are
many other genes present in this population. A gene pool includes all of the genes and alleles in a population, not just
those for a particular trait. So the gene pool for this pea plant population actually
contains genes and alleles that influence thousands of different traits. Some of these
traits are visible, such as plant height and flower color. Other genes may determine how
resistant the plants are to diseases and pests, how they respond to drought or freezing,
and many more features that are important to peas - and to gardeners.
What is microevolution?
The word evolution means change, and
things that change are said to "evolve." These terms are commonly used in our everyday
lives (a work project evolves from the original idea to a finished product, people
dealing with a tragedy evolve as they learn to cope), but in these settings they have a
very different meaning than in biology. In biology, the words evolution and evolve are used in a precise way. These
words apply to changes that occur in the gene pool of a population. Evolution occurs in
populations, not in individual organisms. In biological terms, for example, individual
people don't evolve, but the human race does. When evolution occurs in a population,
different alleles (and genotypes) become more or less frequent within the gene pool. As
a result, we observe a gradual change in the inherited characteristics of the population
as one generation succeeds another.
Evolution of corn
 Over time, a wild grass has evolved to modern corn. Initial corn varieties had
small ears with few kernels; modern corn has much larger, fuller ears. These changes
were guided by human breeders and are a form of evolution. Source: Nicolle Rager
Fuller, National Science Foundation. By Nicolle Rager Fuller, National Science
Foundation (Maize) Public Domain
Over time, a wild grass has evolved to modern corn. Initial corn varieties had
small ears with few kernels; modern corn has much larger, fuller ears. These changes
were guided by human breeders and are a form of evolution. Source: Nicolle Rager
Fuller, National Science Foundation. By Nicolle Rager Fuller, National Science
Foundation (Maize) Public Domain
Microevolution of an insect population
 Evolution occurs when an insect population is exposed to an insecticide. In the
first generation, one insect (red) contains an allele that makes it resistant to the
insecticide. This heritable variation is already present due to past random
mutations. When the insecticide is applied, selection occurs: the red insect
survives while the majority of the non-resistant insects die off (solid blue arrow).
Surviving insects reproduce and generations pass with continued selection due to
insecticide use. After generations of adaptation (dashed diagonal arrow) the
resistant insects (red) make up a larger portion of the population. The insecticide
is less effective against these insects because of the increased proportion of
resistant individuals within the population. By Delldot(Wikipedia) (Pest
resistance labelled light) CC BY-SA 3.0
Evolution occurs when an insect population is exposed to an insecticide. In the
first generation, one insect (red) contains an allele that makes it resistant to the
insecticide. This heritable variation is already present due to past random
mutations. When the insecticide is applied, selection occurs: the red insect
survives while the majority of the non-resistant insects die off (solid blue arrow).
Surviving insects reproduce and generations pass with continued selection due to
insecticide use. After generations of adaptation (dashed diagonal arrow) the
resistant insects (red) make up a larger portion of the population. The insecticide
is less effective against these insects because of the increased proportion of
resistant individuals within the population. By Delldot(Wikipedia) (Pest
resistance labelled light) CC BY-SA 3.0
Microevolution occurs when the type or
frequency of the alleles and genotypes in a population change over one to many
generations of time. But what does that actually mean? Let's
look at a hypothetical example. We’ll observe two different populations of foxes, one in
Maryland and one in Wisconsin. We’ll narrow our focus to a single gene with two alleles
that determine coat thickness. And we will visit the populations at two different
times.
As you can see from the Fox population example, evolution is not determined by the
increase or decrease in the number of individuals within a population. Both populations
saw an increase in the total number of foxes from 1962 to 2202. Microevolution occurs
when there are changes in the genetic makeup of the population: when the frequency
(percentage) of each genotype changes over time.
This example of microevolution covers a few hundred years, but in organisms that have
shorter generation times, like bacteria, microevolution can be observed on an even
smaller time scale. Antibiotic resistance has become a major problem for the medical
community worldwide.
Now that we have a better understanding of what microevolution is, we must consider in
more detail how microevolution happens. What are the mechanisms
that allow for changes in the gene pool over time? In this page we will learn about
selection, a central process in evolution. Selection occurs whenever some genetic types
in a population reproduce more than others in a given environment. We will discuss three
types of selection: natural, sexual, and artificial.
Natural Selection
Working independently of one another in the 1850s, Charles Darwin and Alfred
Wallace were the first scientists to posit the theory of evolution by natural
selection. Ideas about evolution had been proposed before, but Darwin and
Wallace added a crucial element to the theory: they provided a mechanism for how
evolution could work.
Natural selection is a process by which nature (i.e. the environment and all of
its components) impacts the evolution of a population. Individuals vary in their
inherited traits. Those with inherited phenotypes that are better suited to the
environment will have a greater likelihood of passing on their genes to
subsequent generations. To put it another way, the driving force behind
evolution is the interaction of genes and the environment.
Sometimes people use the phrase “survival of the fittest” to sum up natural
selection. This catchphrase may be helpful, but we encourage you to think
carefully. “Survival” is important, but only because it enables reproduction:
once they reach reproductive age, some animals and plants literally kill
themselves to reproduce. Examples include many salmon and annual plants, which
put all of their energy into a single reproductive effort.
Second, what do we mean by “fittest”? We don’t mean physical fitness. Evolutionary fitness is based on genes and inheritance
and is measured by lifetime reproductive success. The genes of an organism
determine many of its features, and these features help determine how likely an
organism is to reproduce in its particular environment. There are other factors
at work too, including luck: nature does not line up all the individuals in each
population and kill them off systematically, leaving only those with the fittest genes to reproduce. Instead, we say that on average the individuals with some phenotypes will
reproduce better than others in a given environment. These fitter individuals will be more likely to pass on their alleles
(through reproduction) to the next generation.
Selection occurs whenever some genetic types in a population reproduce more than
others in a given environment; in natural selection, the favored types do best
because:
- they survive well and are more likely to reach reproductive age
- they obtain resources that allow them to produce a large number or quality
of offspring
The genetic types that reproduce more than others are more likely to pass on
their alleles to the next generation. Traits that give an organism a
reproductive advantage in a particular environment are called adaptive traits.
For a white-footed mouse in a forest, a long tail could be adaptive because it
allows a mouse to escape from predators by climbing trees. It could also be
adaptive because it allows a mouse to obtain more food. In either case, the
result is that the long-tailed mice reproduce more, on average, than other types
in the population.
Each individual birth or death changes a population’s gene pool by a tiny
fraction: some individuals pass on their alleles through reproduction, others do
not. This filtering process affects the composition of the gene pool of the
population, and ultimately of the species as a whole.
Let's return now to our example of the Wisconsin foxes to see how genes and their
environment might interact to drive the evolution of a population. Remember that
this population evolved, showing a dramatic increase of ff
foxes with thin coats from 1962 to 2202:
In our fox example it is important to remember that the environment did not
change the alleles of individual foxes. The foxes did not all individually lose
their coats as the weather got warmer. Instead, the environmental conditions
changed the likelihood that a particular set of alleles would be passed from
individuals in one generation to their descendants. The environment increased
the odds that the f allele would be passed on to the next
generation, and decreased the odds that the F allele would
be passed on. As a result, the frequency of the FF
genotypes in the population's gene pool decreased while the frequency of
the ff types increased. We see this change in frequency
reflected in an increase in the percentage of foxes in the population that are born with genes for a thin coat (i.e., we
observe a change in the frequency of the thin coat phenotype). Evolution takes
longer than a lifetime. Second, the warmer climate did not cause a mutation to
occur so that thinner coats could exist. Instead,
selection is limited to filtering existing variation. Diversity already exists
within the alleles of a population and the environment places a selective
pressure on that population. The evolution of a population is a reactive and
automatic process, not a planned or deliberate one.
Sexual selection
Sexual selection is a subtype of natural selection. In natural selection, some
genetic types in a population reproduce more than others because they are more likely to survive or because
they obtain more resources. In sexual selection, some types reproduce more
than others because they have traits that allow them
to:
- find or attract more mates
- choose higher-quality mates
- win in competitions over mates
Can you think of some traits in animals or plants that would increase their
likelihood of mating? Here are some examples.
 Male peafowls (i.e. peacocks) have elaborate tail plumage to attract a
mate. By Pruneau(Wikipedia) (Peafowl) CC BY-SA 2.0
Male peafowls (i.e. peacocks) have elaborate tail plumage to attract a
mate. By Pruneau(Wikipedia) (Peafowl) CC BY-SA 2.0
Female peafowl are more likely to mate with males that have fuller, more
colorful, and more grandiose tail plumage. During mating season, males display
their plumage when females are in the area in the hopes of attracting the
females for mating. The males with the better tail feathers are more likely to
successfully mate and pass on their genes.
 Male elk grow antlers each year. As the elk age, their antlers get
larger and more full with each successive year. These antlers not only help
to attract mates, but also allow the elk to fight off rival males. This
image shows two male elk sparring during the rut. By FWS (Elk Fighting) Public Domain
Male elk grow antlers each year. As the elk age, their antlers get
larger and more full with each successive year. These antlers not only help
to attract mates, but also allow the elk to fight off rival males. This
image shows two male elk sparring during the rut. By FWS (Elk Fighting) Public Domain
These are just two examples of many thousands of traits that are driven by
natural selection in nature. Whenever the males and females of a species are
noticeably different in appearance, sexual selection is probably at work. Some
additional examples of sexually selected traits include:
- birds who perform dances and construct elaborate “bowers” to attract
mates
- male walruses and elephant seals that battle over access to females
- whales that “sing” haunting mating songs
The typical pattern in sexual selection is that males compete with each other for
mates; sometimes they do so through displays that are meant to attract females,
while in other cases they may battle each other directly. Females tend to choose
mates carefully.
The perplexing thing about sexual selection is that the showy traits that are
used to attract a mate can also interfere with survival. For instance, the
elaborate plumage of the peacock can make the males more likely targets for
predators. Elk with larger antlers may get them stuck in fences or brambles,
which can lead to the untimely death of the stuck elk. And fighting is never good for survival.
So why do these dangerous traits exist? First, survival is only a means to an
end: individuals that fail to mate have zero fitness, even if they are very good
survivors. The gene pool will contain traits of those who have survived, yes,
but also of those who have mated successfully. Second, many sexually selected
traits (e.g. elaborate plumage, bright colors, large antlers) are known to be
indicative of a healthier mate. Males who can “carry off” a good display and a
successful battle are also fit in other ways. Females who are choosy are doubly
successful in their own reproduction: they produce “sexy sons” who will
themselves be successful in mating, and they also produce offspring that are
generally healthy.
Sexual selection is a powerful force in evolution. To understand the impact of
sexual selection consider what happens to the genes of the individual who does
not mate.
 In this image consider twin brothers, Matt and Mark. Mark gets married
at the age of 24 while Matt does not. By the time the brothers are 45 years
old, Mark has mated and has children. His genes have been passed on to the
next generation. When the brothers are 72, Matt is still unmarried and has
no children while Mark has grandchildren.
In this image consider twin brothers, Matt and Mark. Mark gets married
at the age of 24 while Matt does not. By the time the brothers are 45 years
old, Mark has mated and has children. His genes have been passed on to the
next generation. When the brothers are 72, Matt is still unmarried and has
no children while Mark has grandchildren.
In the figure above, Mark’s genes have been passed down to a second generation
because his children have mated and have children of their own. Mark is
successful evolutionarily speaking and his alleles have become more common
through his reproduction and that of his offspring. The evolutionary success of
Matt’s genes is zero because he has no offspring. Sexual selection is a powerful
driving force within evolution.
Artificial Selection
Selection occurs whenever some genetic types in a population reproduce more than
others in a given environment. In natural selection, the types that succeed are
those that survive and/or grow the best. In sexual selection, mating success is
key. In artificial selection, humans
decide which types reproduce best: we deliberately breed certain
individuals with desired traits.
Artificial selection is sometimes referred to as selective breeding. It has been
in use for thousands of years as humans have domesticated plants and animals to
suit their needs. As we discussed at the beginning of this module, corn as we
know it today (with large, full ears) has been selectively bred by humans from
its wild grass ancestor (with small, sparse ears). In the same way, dairy cows
have been selectively bred to produce more milk; beef cattle have been bred to
have more muscle; horses have been bred to run faster; tomatoes have been bred
to produce larger fruit; and wild mustard has been bred to produce cabbage,
Brussels sprouts, kale, broccoli, cauliflower, and kohlrabi.
There is perhaps no better example of artificial selection than the domestic dog.
Dogs are descended from gray wolves, but after thousands of years of humans
directing the breeding of dogs, we have well over one hundred different breeds.
There are dogs with good noses that can track game and search for missing
persons. Some dogs have been bred to herd or protect domestic animals. Some dog
breeds are known for happy personalities and soft fur that make them great
companions while others are known for their strength and intelligence which
makes them good guard or police dogs. Consider the image below to get a sense of
the power of artificial selection.
 Examples of modern dog breeds all descended from the gray wolf
(center). The dogs range in size from less than 10 lb (4.5 kg) to over 100
lb (45 kg). Many of these breeds are now kept as family pets, but their body
structures and inherited behavior routines also suit them to many different
“jobs” including tracking game, pointing at game birds, retrieving ducks,
herding or guarding sheep or cattle, pulling sleds, racing, guarding the
home, or catching rats.
Examples of modern dog breeds all descended from the gray wolf
(center). The dogs range in size from less than 10 lb (4.5 kg) to over 100
lb (45 kg). Many of these breeds are now kept as family pets, but their body
structures and inherited behavior routines also suit them to many different
“jobs” including tracking game, pointing at game birds, retrieving ducks,
herding or guarding sheep or cattle, pulling sleds, racing, guarding the
home, or catching rats.
Selective breeding is not as simple as it may appear. Let’s say you take a dairy
cow who is a high milk producer. You mate her with a male who has the red
spotted coat you like. Unfortunately, you are not guaranteed to get a female
calf who is a high milk producer and has red spots. You are not just dealing
with the two traits you desire in a dairy cow (high milk yield and red spots),
but every trait (i.e. every allele) that each parent cow
has. When you breed these two animals, the offspring will have some combination
of all of the parents’ traits. Because of this, it often
takes many generations of artificial selection to consistently produce offspring
with the desired traits.
In the process of selecting for desired traits, undesirable traits often “tag
along”, and thus we see an increased likelihood of genetic disorders in many
domestic animals. This is a result of inbreeding (mating of individuals that are
closely related). For example, inbreeding among dalmatians has resulted in a
tendency toward aggressive behavior. Additionally, sometimes selective breeding
can magnify a desired trait to such an extreme that it interferes with survival
or reproduction. American domestic turkeys have been bred to have larger breast
muscles to satisfy consumers’ preference for white meat. As a result of
generations of selective breeding, today’s male turkeys are literally too
large-chested to mount and copulate with female turkeys. To produce more
turkeys, farmers must artificially inseminate females. In this and other
examples, selective breeding can produce plant and animal varieties that are
totally dependent on our care and intervention, exhibiting traits that would
never be adaptive in the wild.
Artificial selection is a powerful tool that drives the evolution of domesticated
plants and animals, but it is one that must be utilized with great thought and
consideration so as to avoid the problems that come with inbreeding. Does it
surprise you that farmers and animal breeders need to understand a good deal
about biology to be successful in their professions?
We have just learned how natural selection, sexual selection, and artificial selection
can change the gene pool of a population and result in evolution. In this section we
will consider other processes that can change the gene pool of a population: mutation,
gene flow, and genetic drift.
Remember from the gene expression module that a
mutation is a permanent, irreversible, and heritable change in DNA. We often think of
mutations as a “bad” thing, in part because of how they are portrayed in TV shows and
movies. Mutant creatures are often bizarre (three eyed fish in Lake Springfield of The
Simpsons) or dangerous (mutant dinosaurs of Jurassic Park). Even when the mutations
create superheros like the Teenage Mutant Ninja Turtles or Spider Man, the mutation is
never really portrayed as a good thing. While a certain amount of that bad reputation is
deserved, as some mutations do indeed have negative consequences for living organisms,
not all mutations are "bad." All of the following are true statements about
mutations:
- Mutations alter RNA and may alter protein molecules. If a protein molecule is
changed, the altered molecule may work just the same as the original, it may be
totally nonfunctional, or it may work more efficiently than before.
- Some mutations cause genetic disorders, abnormalities, and cancer, while others
merely contribute to normal variation of traits in a species (such as freckles,
widow’s peaks, and eye color variations).
- Some mutations are harmful because they encode a trait that decreases an organism's
chances of survival, while others are beneficial because they encode an adaptive
trait that increases an organism's chances of survival.
- The effect of a mutation upon an organism can depend upon the environment in which
the organism lives. In fact, some mutations that have no immediate effect on
survival can be maintained in a gene pool, and as conditions change become
advantageous or disadvantageous long after the initial mutation occurred.
Mutations in genes are random and have the potential to change the gene pool of a
population. When parents produce sperm or eggs, errors (mutations) can occur so that the
gametes carry new versions (alleles) of existing genes. Fertilization, growth, and
development can result in an adult individual that carries a new allele and is able to
pass it on to offspring. Technically, the birth of a single individual carrying a new
mutation qualifies as microevolution: as soon as the new allele appears, the gene pool
has been altered.
Let's consider for a moment the gene that encodes the alpha-amylase enzyme. This enzyme
is found in saliva and begins the process of digesting starches in your mouth. Assume
that you were born with a new mutant version of the alpha-amylase gene. You produce a
form of the enzyme that very efficiently digests starch. No one else in the world
carries this form of the alpha-amylase gene in their cells. So as a result of this
mutation, a new allele has been introduced in the gene pool of your population and of
the entire human race. The type and frequency of the alleles and genotypes in your
population has changed (ever so slightly)… so evolution has occurred. Will this change
have a meaningful effect on the entire population or species?
That depends on what happens next.
The alleles and genotypes in a gene pool can also change via two
processes that are sometimes confused with one another: gene flow
and genetic drift. Gene flow refers
to the movement of alleles from one population to another, as a result of migration
followed by breeding. Remember that when living organisms move from one place to
another, they take their alleles with them! Consider the average height difference
between people in East Asia (e.g. China) and those in Western nations (Europe and the
Americas). As westerners migrate to East Asia, the gene pool there changes to include
more alleles that confer tall height. Conversely, alleles characteristic of Asian
populations move along with immigrants to the United States. Gene flow involves breeding
between two or more populations and it tends to make them more similar to each
other.
Genetic drift refers to random events that change the frequency of
alleles and genotypes in a population. It is similar to selection in some ways. Recall
that in selection, certain genetic types become more frequent in the population because
they survive well, grow well, mate successfully, or even just because humans like them
and choose to breed them. In genetic drift, certain genetic types become more frequent
through dumb luck.
Genetic drift often reduces the diversity of a gene pool and has the biggest effect when
there is a low number of organisms in the population. In two different situations,
genetic drift can profoundly affect a gene pool. The first is known as the bottleneck effect. When events like fires, earthquakes,
hurricanes, and other disasters kill a large percent of the population, the surviving
population is unlikely to have the same gene pool as the original population. It is very
likely that some alleles will be underrepresented or overrepresented in the surviving
population as compared to the original. An analogy may help. Half the cards in a deck
are red (hearts and diamonds) and the other half are black (spades and clubs). But if
you draw six cards from the deck at random, will you always get 3 red and 3 black cards?
No. You might well draw six black or six red cards. Similarly, consider a grove of 1000
oak trees. If a flash flood washes away and kills 900 of the trees, the alleles of these
trees have been lost from the population gene pool. Compared to the original group, the
100 lucky survivors will have higher percentages of some genetic types, a lower
percentage of others, and some alleles might be entirely missing. The flood altered the
population’s gene pool in a random way.
Genetic drift can also occur through the founder effect. In the
founder effect, a small number of individuals from a population settle in a new area.
This small group is not likely to contain all of the alleles of the original population,
just as is seen with the survivors in the bottleneck effect. Imagine a field of
dandelions. Dandelions are self-fertile, so they do not require cross pollination from
other dandelions to produce offspring. If just one of the white fluffy dandelion seeds
is carried by the breeze to a new location that does not have dandelions, the plant from
this single seed could start a new population. As a result of the founder effect,
however, the gene pool of the new population would be very limited. It would have only
those alleles that were found in the original seed, drawn at random from a much larger
source population.
As you can see from the examples presented here, mutations, gene flow and genetic drift
are mechanisms that can alter the gene pool of a population leading to microevolution.
While these mechanisms of evolution have been presented separately from the mechanisms
of natural, artificial, and sexual selection, in reality it is likely that several or
all of these mechanisms are at work at any given time to drive evolution. Evolution is a
complicated process. It involves some relatively predictable elements (selection and
gene flow) but also has many unpredictable aspects (mutation, genetic drift).
Microevolution and Infectious Diseases
Many species have very short generation times ranging from minutes (some bacteria) to a
few weeks or months (many insects, some weeds). We can track evolutionary changes in
populations of these organisms. They may change in ways that are important to us. For
example, disease organisms may shift to human hosts, evolve to evade vaccines, or evolve
to resist drugs. Pests and weeds may also evolve in ways that make them more harmful or
harder to control. Scientists and doctors can use what we know about microevolution and
the mechanisms that drive evolution to help tackle these problems in the “real world”
not just in the realm of academia.
In our first example of microevolution and infectious disease, we will explore the Human
Immunodeficiency Virus (HIV), which causes Acquired Immune Deficiency Syndrome (AIDS).
In AIDS, HIV disables the human immune system by depleting CD4 T-cells. The HIV virus
prefers to infect these cells. HIV is an interesting virus in that it uses RNA to encode
its genetic material instead of DNA like most viruses.
 A schematic diagram of an HIV virus particle. By Daniel Beyer (multiplication of HIV) CC BY-SA 3.0
A schematic diagram of an HIV virus particle. By Daniel Beyer (multiplication of HIV) CC BY-SA 3.0
HIV has special enzymes to help it make copies of itself within the host cell. Some of
these are reverse transcriptase, integrase, and protease. Each one is essential to the
virus:
-
Reverse transcriptase converts the HIV virus RNA into DNA
that can be recognized by the infected human cell’s DNA replication machinery as
well as human RNA polymerase.
-
Integrase inserts the DNA made from the HIV RNA (using
reverse transcriptase) into one of the human chromosomes. In this way, the virus
(which is not living - see Application Spotlight: Viruses) tricks the human host cell into producing more viral RNA, which
the virus cannot do itself.
- HIV’s protease cuts the viral proteins that are manufactured
by the host cell into their functional forms.
AIDS was first recognized and tied to the HIV virus in the early 1980s. At that time a
diagnosis of HIV infection was considered a death sentence as there were no available
treatments. The first breakthrough in HIV treatment came about in 1986 when zidovudine
(also known as AZT) was introduced in the United States. AZT works by blocking the
activity of the HIV reverse transcriptase enzyme. AZT was hailed as a HUGE medical
breakthrough, and it worked well at keeping the viral infection in check. AZT would
remain the only treatment available for HIV until the early 1990s when other reverse
transcriptase inhibitor drugs as well as drugs that inhibited the HIV protease were
introduced. With AZT and the new drugs available the scientific and medical communities
thought that the struggles of managing this disease were over! Having HIV was no longer
a death sentence! Infected patients could simply be given any one of these drugs, and
live fairly normal lives as long as they continued treatment. However, by the mid 1990s,
it became apparent that there was a problem. Patients whose infections had been well
controlled (even for many years) started once again to exhibit symptoms of AIDS and
their health deteriorated rapidly. While this turn of events may seem perplexing, the
explanation has everything to do with microevolution.
By the late 1990s, doctors and scientists came to the conclusion that in order to
continue to treat HIV effectively, they needed to approach the problem from multiple
fronts - as you just discovered in the above Learn By Doing activity. New drugs were
developed that targeted different parts of the virus, current drugs were administered
together, and when it became clear that a drug was no longer working for a patient, the
patient was given a different one. The end result of all of this work was the
development of what is known today as Highly Active Antiretroviral Therapy or HAART. HAART generally consists of one protease
inhibitor given in concert with one or two other anti-HIV drugs that target different
aspects of the virus. To date, there are over 30 drugs approved for use in the treatment
of HIV.
HIV Viral Replication Cycle and HAART Drug Targets
 This figure shows the replication cycle of the HIV virus with the current drug
targets indicated with an X. By Daniel Beyer (multiplication of HIV) CC BY-SA 3.0
This figure shows the replication cycle of the HIV virus with the current drug
targets indicated with an X. By Daniel Beyer (multiplication of HIV) CC BY-SA 3.0
While doctors and scientists have made great strides in combating HIV, the “war” on this
virus is far from over. In 2010, there were approximately 34 million people infected
with HIV worldwide and 1.8 million deaths associated with HIV. Rates of HIV infection
and the death toll from AIDS are disproportionately high in Sub-Saharan Africa and in
other areas without access to HAART. Even in wealthier nations, the problem of drug
resistance continues. As of 2009 researchers were tracking 93 different common
drug-resistance mutations worldwide. Today the World Health Organization (WHO) and other
groups are working to raise HIV awareness, reduce infection rates, and increase access
to drugs among those already infected. Researchers are also working to develop new drugs
and vaccines.
Now that we have learned how our understanding of evolution can be used to help fight
HIV, let’s see if we can apply that knowledge to an even more complicated infectious
disease: malaria. Malaria is an ancient disease that has been around for over 50,000
years! Malaria is caused by four parasites of the Plasmodium
genus: Plasmodium falciparum, Plasmodium vivax, Plasmodium
ovale, and Plasmodium malariae. These protists (eukaryotes) have complicated
life-cycles that require both a mosquito host and a human host, and the parasite
undergoes many developmental stages within these two hosts. Humans become infected with
the malarial parasites when they are bitten by an infected mosquito. Similarly,
uninfected mosquitoes can pick up the parasites when they ingest blood from an infected
human.
Life Cycle of Malarial Parasites
 This diagram shows a detailed overview of the life cycle of the Plasmodium parasites that cause malaria. You need not learn
the details, but the diagram helps you to see the complexity of the Plasmodium life cycle. By CDC (Malaria) Public Domain
This diagram shows a detailed overview of the life cycle of the Plasmodium parasites that cause malaria. You need not learn
the details, but the diagram helps you to see the complexity of the Plasmodium life cycle. By CDC (Malaria) Public Domain
Because of its complex life cycle and the eukaryotic nature of this organism, malaria has
been a difficult disease to combat. However, this complexity also means that there are
more potential ways to intervene, prevent, and treat this disease. The parasite could be
targeted with anti-malarial drugs in the human host. Other methods could be used to
prevent the parasite from surviving in the mosquito host. Or measures can be taken to
prevent the human host from being bitten by mosquitoes.
 This diagram shows the interactions between the Plasmodium
parasite, the human host, and the insect host that all contribute to malaria
disease and serve as potential targets for preventive measures or
treatments.
This diagram shows the interactions between the Plasmodium
parasite, the human host, and the insect host that all contribute to malaria
disease and serve as potential targets for preventive measures or
treatments.
We have now explored two corners of the “Interactions in Malaria” triangle - the mosquito
vector and the malaria parasite. As you can see from the question above, there are
several ways in which malarial parasites can evolve resistance to anti-malarial
medications. This is a real world problem in the fight against malaria. Resistance to
almost every drug available to prevent or treat malaria has been reported, and the rates
of resistance are only increasing. Insecticide resistant mosquitoes are also
contributing to the problem because many areas where malaria is rampant rely heavily on
pesticide control of the mosquito populations to curtail the spread of malaria. If the
mosquitoes are no longer killed by the pesticide, then there will be more mosquitoes
around to transmit malaria.
The last corner of our triangle is the human host. The alleles of many human genes have
been determined to alter a person’s susceptibility to malarial infections. The most
famous and arguably the most important is the sickle cell allele. People homozygous for
the sickle-cell allele suffer from sickle cell anemia. Their red blood cells are
misshapen, resembling a sickle.
Images of Normal and Sickle Red Blood Cells
 Sickle-cell disease is indicated by the presence of sickle shaped red blood
cells. As shown here, normal, healthy red blood cells are round and plump while
sickle red blood cells are “C” shaped and somewhat flattened. By United States, National Human Genome Research Institute (Sickle Cell) Public Domain
Sickle-cell disease is indicated by the presence of sickle shaped red blood
cells. As shown here, normal, healthy red blood cells are round and plump while
sickle red blood cells are “C” shaped and somewhat flattened. By United States, National Human Genome Research Institute (Sickle Cell) Public Domain
 A sickle is a “C”-shaped farm tool that is used to help cut down crops. The
deformed red bloods cells in sickle cell anemia get their name from this
agricultural tool. By Thamizhpparithi Maari (Sickle) CC BY-SA 3.0
A sickle is a “C”-shaped farm tool that is used to help cut down crops. The
deformed red bloods cells in sickle cell anemia get their name from this
agricultural tool. By Thamizhpparithi Maari (Sickle) CC BY-SA 3.0
Sickle cell anemia is caused by a recessive allele (we will call it “a”). Three genotypes
are possible:
| AA |
Aa |
aa |
| homozygous dominant |
heterozygous carriers |
homozygous recessive |
| Normal red blood cells, with no sickled blood cells. No negative health effects
related to sickling of blood cells. |
Most blood cells normal, 20-40% are sickled; few negative health effects. |
Suffer from sickle-cell anemia, a condition in which sickled red blood cells are
abundant and cause pain, swelling, poor circulation, and many other negative
health effects. Without modern care, typically die without producing
offspring. |
Good work. You’ve cracked the mystery! There is a situation called heterozygote advantage
at work here. Why does a gene that alters red blood cells have anything to do with
malaria? The malaria parasite spends a large part of its life cycle in red blood cells.
The red blood cells of those with the Aa genotype are less
hospitable to Plasmodium than those of an average (AA) individual. For example, in an Aa person
the red blood cells may sickle in response to being invaded by Plasmodium. This will lead to the death of the newly invaded red blood cell,
and the parasites will die with it.
|
AA |
Aa |
aa |
| Without malaria |
Highest fitness; no sickle cell anemia symptoms. |
Slightly reduced fitness; mild symptoms related to sickled cells. |
Lowest fitness; full effect of sickle cell anemia disorder. |
| With malaria |
Moderate fitness; more likely to die of malaria or suffer reduced fertility due
to its effects. |
Highest overall fitness; more likely to survive malaria and reproduce well. |
Lowest fitness; full effect of sickle cell anemia disorder. |
Malaria is a serious disease with an estimated 216 million cases and over 600,000 deaths
in 2010. In Sub-Saharan Africa, where malaria rates are highest, a child under the age
of five dies every minute from this disease. Doctors and scientists are working to help
prevent and treat this disease by designing new treatments, developing vaccines, working
to prevent mosquitoes from transmitting the malaria parasites, and by studying the
interrelatedness between the parasite, the insect host and the human host. At the center
of the connection between parasite, insect, and human lies evolution.
HIV and malaria are just two examples where an understanding of evolutionary principles
has proven to be a critical component in the effort to fight infectious disease. Other
prominent examples include tuberculosis, methicillin-resistant Staphylococcus aureus (MRSA), avian influenza, and pertussis. Evolution is at
work all around us, and every population of every organism is subjected to it.
Thus far, we have been exploring how subtle changes can occur within a population. We’ve
seen that these changes can lead to adaptation. The genetic makeup of populations also
can change through migration and interbreeding (gene flow) and even through the vagaries
of chance (genetic drift). But how does this relate to macroevolution? For example, can
microevolution possibly explain the origin of new and different species?
Macroevolution is a long-term process and includes the origin and extinction of species
and larger taxonomic groups. However, each and every event of macroevolution occurs through the processes of microevolution you just studied. The
two processes are continuous and are part of a unified whole.
As you should recall, microevolution occurs at the population level. But a population is
only a part of a larger collection that we refer to here as a biological lineage. A lineage is a group of populations that evolves
independently of other groups. Members of the same lineage can move between its
populations. Mating may occur between members of different populations in the same
lineage. Lineages change as their member populations evolve and exchange genes and
individuals with each other. To get a clearer sense for the nature of a biological
lineage, do the Learn By Doing activity below.
To recap, a lineage is a group of populations that can exchange genes and individuals and
that evolves as a unit as shown in the Figure below. The lineage evolves through changes
that occur in its component populations.
Evolution within a biological lineage.
Within a biological lineage, evolution occurs as the component populations evolve. The
diagram shows evolution of a biological lineage starting at an arbitrary reference point
(“baseline generation”). Each chevron represents a snapshot of the lineage at one point
in time. Circles (A-F) represent populations of various sizes linked by gene flow (white
lines). Population (A) goes extinct. A mutation produces a new adaptive trait that
spreads first through population E, then moves through gene flow to the remaining
populations.
In practice, biologists often use the term “species” to describe a biological lineage.
The definition of “species” you learned earlier in this Unit fits the idea of a lineage.
Consider the Roseate Spoonbill (Platalea ajaja). These birds use
their sensitive, flat bills to capture small animal prey in shallow water. There are
populations of Roseate Spoonbill in coastal and wetland areas within South America,
Central America, and the U.S. Gulf Coast. Individual Spoonbills can move from one
population to another, taking their genes and adaptive traits with them. Changes in the
genetic makeup of one population can affect the genetic makeup of other populations over
time, so the species as a whole evolves as a unit. Yet the evolution of the Roseate
Spoonbill does not affect the genetic makeup of other bird species. Five additional
species of Spoonbill live in different parts of Africa, Australia, and Eurasia. Each is
a distinct biological lineage.
Roseate Spoonbill, Platalea ajaja.
 By John James Audubon (Roseate
Spoonbill) Public domain
By John James Audubon (Roseate
Spoonbill) Public domain
Speciation is the formation of new biological lineages. It occurs
when an existing species splits or branches into two or more new species that evolve
independently of each other. Over very long periods of time, repeated branching of a
lineage can create groups of related species called clades. A
clade is a complete group of all species that descend from some common ancestor. The six
species of Spoonbill form a clade; all of them share unique adaptive traits not found in
other birds, most notably the distinctive bill. They all likely descended from a single
ancestral species that possessed these unique features.
Two additional members of the Spoonbill clade, genus Platalea.
Royal Spoonbill (left), Eurasian Spoonbill (right). All spoonbill species have a similar
bill shape and mode of feeding, but species vary in distribution, behavior, genetics,
coloration, structure, and plumage. Left image by Fir0002(Wikipedia) (Royal
Spoonbill mouth open) GFDL
1.2. Right image by Andreas Trepte (Eurasian
Spoonbill) CC BY-SA 2.5.
In the early 1700s, Carolus Linnaeus established the modern system for naming and
classifying organisms. In it, species are placed in nested groups based on their shared
characteristics. Species correspond to biological lineages. Higher levels of
classification are the genus, family, order, class, phylum, and kingdom. Each level is
nested within the next higher level; all members of a genus, for example, are members of
the same family, order, and so on. Below, the Linnaean hierarchy is shown for the
Roseate Spoonbill.
Table 2.Linnean classification is a system of nested groups.
| Species
Platalea ajaja |
Roseate Spoonbill |
One lineage, many populations |
| Genus
Platalea |
Spoonbills |
One clade containing 6 related species |
| Family
Threskiornithidae |
Ibises and Spoonbills |
One clade containing 13 related genera |
| Order
Pelecaniformes |
Herons, Ibises, and Pelicans |
One clade containing 5 related families |
| Class
Aves |
Birds |
One clade containing 33 related orders |
| Phylum
Chordata |
chordates |
One clade containing 14 related classes |
| Kingdom
Animalia |
animals |
One clade containing 36 related phyla, millions of species |
How does this classification system relate to macroevolution? Today, biologists strive to
place closely related species (members of a clade) within the same taxonomic groups. We
hypothesize that the members of a genus had a recent common ancestor; members of genera
within a family can be traced to an earlier common ancestor; and so forth. Thus the
taxonomic system is not merely a convenient way to organize species. It partly reflects
our understanding of how biological diversity has evolved over time.
The idea of common ancestry is very strongly supported by many lines of evidence. Like
plagiarized term papers, our genes contain many sequences that closely match those in
other species. Body structures and patterns of embryological development tell the same
story. And fossils provide a historic record of the traits of our ancestors. You will
see some such evidence in this Module.
To Learn More / Credits:
All taxonomic data based on current status in the Integrated Taxonomic Information
System, http://www.itis.gov/
Speciation is the formation of new species. We will assume in this course that a species
is a biological lineage, although there can be considerable debate among biologists
about how species are best defined in practice.
How can new species form? Recall that changes that occur in the genetic makeup of one
lineage do not directly influence the genetics of another lineage as we move forward
through time. Therefore speciation is the establishment of a new group that does not
exchange individuals or genes with its source lineage.
What could break up a biological lineage? Species can form if they are isolated from the
source lineage by geography. This is called allopatric speciation.
Allopatric translates to “different country.” Species may also form through genetic or
other changes that create a subgroup within a lineage that does not breed or exchange
individuals with the source population. A new species “pops up” right within, and
surrounded by, its parent species. This is called sympatric
speciation (translates to “same-country”).
Allopatric speciation begins when populations are separated in space by some kind of
geographic barrier. It can occur if geological changes break a species’ range into
separate “islands” of habitat. The diagram below illustrates this process:
 Allopatric speciation can occur if a geologic change creates a barrier to
dispersal (movement). The barrier stops or greatly reduces gene flow between groups of
populations. As they evolve independently, the groups diverge, eventually forming
separate species.
Allopatric speciation can occur if a geologic change creates a barrier to
dispersal (movement). The barrier stops or greatly reduces gene flow between groups of
populations. As they evolve independently, the groups diverge, eventually forming
separate species.
Allopatric speciation can occur in another way as well: through long-distance dispersal
and colonization of a new habitat. We can see the result of this process in islands far
out at sea: a few hardy colonists “make it” to an island to start a population; after
many generations they are distinct from their cousins on the mainland. This mechanism is
illustrated in the diagram below:
 Allopatric speciation can occur if a few individuals manage to disperse over a
barrier and start a new population that is distant from the source species. As they
evolve independently, the groups diverge, eventually forming separate species.
Allopatric speciation can occur if a few individuals manage to disperse over a
barrier and start a new population that is distant from the source species. As they
evolve independently, the groups diverge, eventually forming separate species.
The map of the world is a jigsaw puzzle of broken-up habitats (continents, oceans,
islands, mountain ranges, lakes, caves, river systems, forests, deserts...) occupied by
different regional or local species. Allopatric speciation helps us make sense of these
patterns: as Earth’s landscapes were reshaped and broken up by geologic processes,
living lineages also became separated and diverged into locally adapted species.
In some cases many closely-related species all live in the same geographic area and there
is no known barrier that divides them today or in the recent geologic past. These
species likely formed through sympatric speciation, which occurs without help from a physical barrier to dispersal. The diagram below shows a
general model for sympatric speciation:
 Sympatric speciation occurs when a subgroup arises within a species. It lives in
the same area but does not breed freely with the original species. Eventually the
subgroup may diverge enough to become a separate species.
Sympatric speciation occurs when a subgroup arises within a species. It lives in
the same area but does not breed freely with the original species. Eventually the
subgroup may diverge enough to become a separate species.
How could sympatric speciation happen? The drive to reproduce generally maintains the
integrity of species by assuring that all their populations will exchange genes with
each other. Sympatric speciation goes against this tendency; it requires the formation
of a group of finicky, “cliquish” breeders. Most of the well-known examples involve
genetic errors that produce offspring with extra chromosomes, a condition known as
polyploidy. Sometimes polyploid types form new species that can breed with each other
but are incompatible with the original species. Second, changes in ecology and breeding
habits can also isolate a group within a species.
To Learn More:
Hoeck, P.E.A. and others.
2010. Differentiation with drift: a spatio-temporal genetic analysis of Galápagos
mockingbird populations (Mimus spp.) Philosophical Transactions of the Royal Society of London B Biological Sciences
365: 1127–1138. doi:10.1098/rstb.2009.0311
You have probably noticed certain features that “run in families:” dark curly hair, an
oddly shaped ear, bushy eyebrows, freckles... Siblings are often similar in appearance
because they have inherited their genes from a common source.
In evolutionary biology, the same principle is extended to related lineages. Species with
a recent common ancestor are close relatives, like brother and sister. Their lineages
split apart not too long ago. Other species are much more distantly related, like second
cousins. They can be traced to a common ancestor, but this ancestor lived very long ago.
We can tell their degree of relationship by looking at homologous
features: shared features that were inherited from the same source and reflect
common ancestry. Two species that are closely related share many homologous features.
Species that are distantly related share only a few.
Not every similarity between two species is homologous. We are looking for features that
were inherited from a common source. Therefore the features should be based in genes
(not acquired through learning, for example). Homologous features will also be similar
in their details; there should be more than a passing
resemblance.
An analogy might help you to recognize what we’re getting at here. Two students are
brought into a professor’s office. They are shown their term papers, side by side.
Bill’s paper begins: “Phylogenetic biology is the exhaustive comparison of taxonomic
units in an attempt to elucidate the ancestral relationships among all life forms on the
planet Earth.” Sarah’s paper starts with the exact same
sentence. At several points, the papers have identical or extremely similar
wording.
The students are charged with plagiarism. Both claim to have written their own papers.
After all, the professor asked for a paper on phylogenetic biology, so of course the
papers will be similar! The professor counters this with a quick calculation: the odds
that two students’ papers would have such similar language by
chance are one in several trillion. The academic integrity board agrees: either one
student copied from the other, or they both copied language from the same outside
source.
In biology, the same sorts of judgments are made about similarities among species. When
inherited features are very similar in their details, biologists assume they were likely
inherited from a common source. One classic example involves the skeletal structure of
vertebrates.
 Color-coded homologous features of vertebrate forelimbs. Forelimbs serve
different functions in humans (arm), dogs (front leg), birds (wing), and whales
(flipper). Yet their underlying structure is similar. Here the major bone categories
are matched by color. Notice that the digits (“finger bones”) are partially fused in
dogs; in the bird the digits are more extensively fused and reshaped. By Волков
Владислав Петрович (Homology
vertebrates) CC0 1.0
Color-coded homologous features of vertebrate forelimbs. Forelimbs serve
different functions in humans (arm), dogs (front leg), birds (wing), and whales
(flipper). Yet their underlying structure is similar. Here the major bone categories
are matched by color. Notice that the digits (“finger bones”) are partially fused in
dogs; in the bird the digits are more extensively fused and reshaped. By Волков
Владислав Петрович (Homology
vertebrates) CC0 1.0
It seems unlikely that these four animals (not to mention thousands of others) would
develop such similar limb structures by chance. It also does not appear to be necessary.
Why should a whale flipper have embedded fingers, wrist bones, and three major limb
bones? If adaptive evolution was starting “from scratch,” it might “design” a flipper
with just a few bony plates. Instead, evidence supports the idea that all four-limbed
vertebrates descend from a common ancestor; they all inherit their curious and specific
arrangement of limb bones from that source. In separate lineages, adaptation has
reshaped the limbs and suited them to very different functions. At first glance, a whale
flipper and a hummingbird wing have little in common, but the details
of the structures point to shared ancestry. Let’s take a moment to assess your
understanding of homologous features.
Homologous Molecules and Cellular Structures
It is not just four-limbed animals that are related. According to current evolutionary
thinking, all life on Earth is related by ancestry. You, a bacterium, a fly, a fern, and
a Portabello mushroom all belong to a single clade. To some, this is a difficult or even
preposterous concept. What could you and a bacterium or mushroom possibly have in
common? And if you do have something in common, why do biologists think it was inherited
from the same source?
We may look very different, but unifying features are evident within our cells. For
example, all cells contain DNA. And to make use of their genes, all cells have
ribosomes: clusters of protein and RNA that carry out the synthesis of proteins.
 A model of the small subunit of the ribosome in Thermus
thermophilus, a bacterium that lives in hot springs. The structure shown is
composed of RNA (pink) and proteins (blue). In a functioning ribosome, this unit is
paired with a larger structure. By David S. Goodsell, RCSB Protein Data Bank (10 small
subunit) Public Domain
A model of the small subunit of the ribosome in Thermus
thermophilus, a bacterium that lives in hot springs. The structure shown is
composed of RNA (pink) and proteins (blue). In a functioning ribosome, this unit is
paired with a larger structure. By David S. Goodsell, RCSB Protein Data Bank (10 small
subunit) Public Domain
Every cell has ribosomes, but each organism’s ribosomes are built
according to a slightly different set of specifications. Here, then, is a characteristic
that we can compare and contrast among every single living species. That is just what
Carl Woese, a microbiologist at the University of Illinois, set out to do in the 1970s.
He obtained gene sequences for ribosomes of a wide range of species. He focused on part
of the small subunit, shown above for one species of heat-loving bacterium. Amazingly,
he could line up matching gene sequences (long series of the nucleotide bases A,G,C,T)
among various microbes, plants, animal, and fungi. This was painstaking work, done
without the aid of modern computers and software.
In 1990 Woese published a paper proposing a change in the classification system. He
reported that there were consistent differences in ribosomal gene sequences among three
major groups. Above the level of Kingdom, he proposed three Domains of life. Two of them
are made up of prokaryotes (Bacteria and Archaea). The third is called Eukarya and
includes all organisms whose cells have nuclei, including fungi, animals, plants, and
several groups of protists. Woese’s data have since been greatly expanded, and the new
data are consistent with the idea that the three Domains are the first three branches on
a unified tree of life.
Why do scientists think that the chemical similarities of cells reflect shared ancestry?
As with vertebrate limb structure, the genetic similarities among life forms are more
than a passing resemblance. DNA sequences are detailed, complex, and contain a great
deal of information. In a court of law, DNA evidence can be used to tie a suspect to a
crime scene sample: it is extremely unlikely that two long DNA sequences would show an
exact match unless they came from the same source. In evolutionary biology, the same
sort of reasoning applies: long chunks of DNA sequences match closely among species and
are evidence for shared ancestry. Thus we can now analyze inherited characteristics that
have been present for not just millions but billions of years.
In these ancient gene sequences we see the deepest roots of the tree of life.
Homologous features are the key sources of information for the construction of phylogenetic trees. A phylogenetic tree, or phylogeny, is a
diagram that shows how a biological lineage may have branched and formed clades over
time. A tree diagram is a hypothesis about how different species are related and is
subject to change as more data are gathered and as analysis techniques improve. To get a
feel for how phylogenetic trees work and what they mean, do the following activity.
As you have learned, shared characteristics can be used to organize species into groups,
with clades defined by unique inherited traits. Unfortunately, this procedure is often
quite difficult: there are millions of species to organize and an infinite number of
possible characteristics to compare! Many traits may be lost or reversed over time.
Consider the examples of tetrapods with one or both pairs of limbs reduced or missing
(snakes, some lizards, whales and dolphins, manatees, seals, etc.). Some changes also
occur quite predictably as adaptations to special environments. In the Arctic, foxes,
birds, mink, hares, bears, and more all have snow-white winter coats or feathers. They
are not closely related and did not all inherit their winter coloration from a common
ancestor. Instead, “snow white winter color” developed independently in each of these
lineages at different times and starting with different mutations.
Unlike many physical or behavioral traits, DNA sequences are an excellent source of data
on relationships. By looking at DNA, biologists have a way to directly and objectively
compare inherited information. For example, virtually all eukaryote species have a
gene in their mitochondria that codes for cytochrome C oxidase, an enzyme that is vital
to the process of aerobic respiration. This widespread gene is quite similar in most
species, but mutations do occur and tend to be preserved within a lineage. Subunit 2 is
a portion of the cytochrome C oxidase protein; its gene is composed of about 700
nucleotide base pairs. What does this gene say about the relationships among Carp,
Salamander, Sea Turtle, Human, and Mouse? The image below gives a glimpse of the
data.
 Comparison of cytochrome C oxidase subunit 2 for Common Carp, Tiger Salamander,
Green Sea Turtle, Human, and House Mouse. Highlighted nucleotides are identical for
at least 4 of the 5 species. The image shows only the first 100 bases in the
sequence; the full sequence contains a total of almost 700 bases. Image generated
using Geneious software v5.6,
http://www.geneious.com
Comparison of cytochrome C oxidase subunit 2 for Common Carp, Tiger Salamander,
Green Sea Turtle, Human, and House Mouse. Highlighted nucleotides are identical for
at least 4 of the 5 species. The image shows only the first 100 bases in the
sequence; the full sequence contains a total of almost 700 bases. Image generated
using Geneious software v5.6,
http://www.geneious.com
As you can see, there is a great deal of similarity in this gene among the five species.
This shouldn’t be too surprising: they are all vertebrate animals, close relatives in
the grand scheme of life’s diversity. There are clearly sections of the gene where all
the bases tend to agree; other regions show more differences. Do the differences between
the genes match our expectations about how Carp, Salamander, Sea Turtle, Human, and
Mouse are related? It is not easy for a human to sort through the sequences and count
differences one by one, but a computer can complete this task in a flash. Below is a
summary of how the full gene sequence for each species compares to that of the Common
Carp:
| Tiger Salamander |
162 differences |
76% identical to Carp |
| Green Sea Turtle |
176 differences |
74% identical to Carp |
| House Mouse |
200 differences |
71% identical to Carp |
| Human |
229 differences |
67% identical to Carp |
At least from the Carp’s perspective, the genetic data agree with our tree: the Tiger
Salamander is Carp’s closest match; Sea Turtle is in between; and Mouse and Human are
more distant!
Using modern computers and a variety of analytical techniques, biologists can now compare
vast amounts of genetic data among hundreds or even thousands of species. They can
sometimes even include DNA sequence data extracted from fossils! The result has been a
huge improvement in our ability to identify the clades within the tree of life.
To Learn More
Tree of Life web project:
http://tolweb.org/tree/
Travels in the Great Tree of Life, Peabody Museum:
http://archive.peabody.yale.edu/exhibits/treeoflife/index.html
Wellcome Trust Tree of Life website:
http://www.wellcometreeoflife.org/
Model Organisms and Human Health
Why does macroevolution matter? Is it just ancient history? Far from it! “Tree thinking”
is basic to progress in modern biology. It helps us deal with the vast diversity of life
in an organized fashion. We don’t have to start from “square one” with each species of
interest. Instead, we can use natural groupings (clades) to our advantage.
A phylogenetic perspective can help us deal with threats. When there is an outbreak of
food poisoning, genetic analysis can show that the harmful bacteria came from a
particular farm. If we are attacked by a new virus, we can compare its genes to those of
known pathogens. Once we place the virus within a clade, we can quickly get a handle on
what we’re facing, how it is likely to affect us, and how we can best combat it.
Phylogenetics can also help us get the most out of helpful species. You may be surprised
to learn that the familiar daffodil is a plant with medicinal potential. Although
daffodils are poisonous, drugs might be developed from chemicals that can be extracted
from the plant. One wild daffodil species in Spain (Narcissus
confusus) has been found to contain a chemical that slows the progression of
Alzheimer’s disease and another that inhibits replication of HIV, the AIDS virus.
 Narcissus confusus (inset) in its habitat in Spain.
Daffodils are poisonous but drugs might be developed from chemicals extracted or
modified from those found in the plant. Photos by A. Barra,
CC BY 3.0.
Narcissus confusus (inset) in its habitat in Spain.
Daffodils are poisonous but drugs might be developed from chemicals extracted or
modified from those found in the plant. Photos by A. Barra,
CC BY 3.0.
Based on these discoveries, scientists are interested in learning more about the
chemistry and therapeutic potential of daffodils. But where to look? There are up to 150
different species of Narcissus and countless varieties. It would
be inefficient and much too costly to do a full analysis on every species. Instead,
researchers are using “tree thinking” to narrow down the search. Future testing will
focus on close relatives of species that are already known to be chemically rich.
A second principle of macroevolution, common ancestry, is important for another reason.
Medical research focuses on the biology of humans. But let’s face it: humans make
terrible study subjects. We live too long, take up too much space, and have too many
inalienable rights to be of much use in the lab! Therefore biomedical researchers also
study other species as far-flung as worms, fruit flies, mice, fish, or rhesus monkeys.
They can tell us a great deal about our bodies, our genes, and even our diseases. Why?
Because these species have many inherited features that are very similar to our own.
When we learn something about a worm or a wallaby, we learn more about ourselves in the
process. Below we summarize just a few examples of the power of this approach.
| Discovery in Model Organism |
Application to Humans |
 A microscopic view of a fission yeast culture. Image by David O. Morgan, The Cell Cycle:
Principles of Control. No Restriction. Proteins that control cell division were discovered in the 1970s
through research in yeast (single-celled fungi) and sea urchins. Roles of
cyclins and cyclin-dependent kinases (CDKs) were found by studying mutant yeast
strains with unusual patterns of cell division. A microscopic view of a fission yeast culture. Image by David O. Morgan, The Cell Cycle:
Principles of Control. No Restriction. Proteins that control cell division were discovered in the 1970s
through research in yeast (single-celled fungi) and sea urchins. Roles of
cyclins and cyclin-dependent kinases (CDKs) were found by studying mutant yeast
strains with unusual patterns of cell division.
|
 A young girl receiving chemotherapy. National Cancer Institute,
Bill Branson (Photographer). Public Domain
Cell cycle controls are lost or disrupted in cancer. Several drugs
known as CDK inhibitors have been developed for use in chemotherapy as seen
above. Continued research in yeast, mice, and humans is being used to refine and
improve these treatments. A young girl receiving chemotherapy. National Cancer Institute,
Bill Branson (Photographer). Public Domain
Cell cycle controls are lost or disrupted in cancer. Several drugs
known as CDK inhibitors have been developed for use in chemotherapy as seen
above. Continued research in yeast, mice, and humans is being used to refine and
improve these treatments.
|
 Image by Bob Goldstein, UNC Chapel Hill. CC BY-SA 3.0
Microscopic roundworms (C. elegans) normally
live for 3 weeks. Those with mutations in certain genes can live twice as long. Image by Bob Goldstein, UNC Chapel Hill. CC BY-SA 3.0
Microscopic roundworms (C. elegans) normally
live for 3 weeks. Those with mutations in certain genes can live twice as long.
|
 Naples (1890s) Old couple. Photo in public
domain.
One of the genes identified in C. elegans FOXO)
has an allele that is associated with long life in humans. Several related
proteins work in a pathway that involves insulin signaling; therapies that
target this pathway may help extend healthy lifespan in humans. Naples (1890s) Old couple. Photo in public
domain.
One of the genes identified in C. elegans FOXO)
has an allele that is associated with long life in humans. Several related
proteins work in a pathway that involves insulin signaling; therapies that
target this pathway may help extend healthy lifespan in humans.
|
 A knockout mouse (left) that is a model of obesity, compared with
a normal mouse. Image by Lexicon Genetics Incorporated, Public Domain.
Thousands of strains of laboratory mice show specific diseases and
disorders like the obese mouse (left) compared to a normal phenotype mouse
above. Research on obese mice led to the discovery of leptin, a hormone involved
in the regulation of hunger. A knockout mouse (left) that is a model of obesity, compared with
a normal mouse. Image by Lexicon Genetics Incorporated, Public Domain.
Thousands of strains of laboratory mice show specific diseases and
disorders like the obese mouse (left) compared to a normal phenotype mouse
above. Research on obese mice led to the discovery of leptin, a hormone involved
in the regulation of hunger.
|
 Illustration of obesity and waist circumference. From left to
right, the "healthy" man has a 33 inch (84 cm) waist, the "overweight"
man a 45 inch (114 cm) waist, and the "obese" man a 60 inch (152cm)
waist.
Infographic: FDA/Renée Gordon. Public Domain.(1) [1]
Some obese humans produce too little leptin or have nonfunctional
leptin receptors in their brains, and thus are prone to overeating. Drugs may
help restore healthy appetite control in some of these people. Illustration of obesity and waist circumference. From left to
right, the "healthy" man has a 33 inch (84 cm) waist, the "overweight"
man a 45 inch (114 cm) waist, and the "obese" man a 60 inch (152cm)
waist.
Infographic: FDA/Renée Gordon. Public Domain.(1) [1]
Some obese humans produce too little leptin or have nonfunctional
leptin receptors in their brains, and thus are prone to overeating. Drugs may
help restore healthy appetite control in some of these people.
|
References / To Learn More:
Willcox, B.J. and others. 2008. FOXO3A genotype is strongly associated with human
longevity. Proceedings of the National Academy of Sciences 105: 13987-13992.
Spencer, G. 2002. Background on mouse as a model organism. National Human Genome Research
Institute website.
Partridge, L. and others. 2011. The new science of ageing. Philosophical Transactions of
the Royal
Society of London Biological Sciences 366: 6-8.
National Science Foundation / American Museum of Natural History. 2000.
Assembling the
Tree of Life: Harnessing Life’s History to Benefit Science and Society.
References
-
(2000).
Report of the Dietary Guidelines Advisory Committee on the
Dietary Guidelines for Americans, FDA..
What is Ecology?
In exploring biology thus far, we have focused on life from the “skin in”—you
have learned about the structure and function of cells and have explored the
chemical processes that enable life. But biology does not stop with this
inward-looking perspective. Biology also looks from the skin out at the
individual’s life in context. Biologists explore how you and other organisms get
food, how you change the world around you and in turn are influenced by factors
like temperature, environmental toxins, and other organisms.
 Ecology examines how groups of living organisms interact with each
other and with nonliving factors in their environment.
Ecology examines how groups of living organisms interact with each
other and with nonliving factors in their environment.
Ecology is the branch of biology that studies life at population and higher
levels of organization, emphasizing how groups of living organisms interact with
each other and with nonliving factors in their environment. The main levels of
analysis in ecology are population, community, ecosystem,
and biosphere. Let's examine the meaning of these terms to see how they differ
from one another, and yet build upon one another. The diagram below summarizes
how the levels of analysis relate and gives a specific example (the forest) to
guide your understanding.
Ecology’s Levels of Analysis
 Ecology focuses on interactions at the population level and above. In
the diagram above, the hierarchy is shown visually. Individuals of a species
that live in the same area make up a population. All the populations in a
region make up a community. Many different nonliving factors are also at
work in the same area. If we consider these factors as well, we are thinking
at the ecosystem level. Together, many different types of regional
ecosystems make up the global ecosystem, the biosphere.
Ecology focuses on interactions at the population level and above. In
the diagram above, the hierarchy is shown visually. Individuals of a species
that live in the same area make up a population. All the populations in a
region make up a community. Many different nonliving factors are also at
work in the same area. If we consider these factors as well, we are thinking
at the ecosystem level. Together, many different types of regional
ecosystems make up the global ecosystem, the biosphere.
Within an area defined by the ecologist, individuals of a single species that
live together and may breed with each other make up a population. All of the different populations of living organisms
living within an area make up an ecological community. In
the example above, the squirrels and sugar maples of a region, together with
humans plus hundreds of additional populations of plants, animals, fungi,
bacteria, and other organisms would make up a forest community. The forest ecosystem also includes non-living factors such as
chemicals in the soil, rainfall and other climate factors, and countless other
features of the environment that interact with living things in the region.
Additional ecosystems (lakes, grasslands, oceans, etc.) share our Earth with the
forest ecosystem. Together, all of the zones of Earth that support life make up
a giant interconnected system called the biosphere.
Many students have some difficulty distinguishing between the definitions of
ecological community and ecosystem. The community and ecosystem levels can cover exactly the
same area: communities are not literally “smaller than” or “contained within”
ecosystems. Instead, the ecosystem is a different way of looking at an area that
includes a broader set of factors and processes than the community level of
analysis. The community ecologist looks at a forest and sees particular types of
birds, trees, fungi, and insects eating each other and otherwise interacting.
The ecosystem ecologist looks at the same forest and may see the organisms in
less detail, but also considers how the trees build the soil or how floods shape
the landscape.
Population ecology is focused on how populations — of plants, animals, bacteria, and other
types of organisms — change over time. A population is a group
that includes all individuals of a particular species within a given area at one point
in time.
Population size, often represented by the variable N, is the total number of individuals in a population at a
particular point in time. Population size can be an abstract concept, particularly for
small organisms whose numbers can be astronomical. A single species of mosquito in a
swamp might easily number in the millions or even billions of individuals. It is often
better and more practical to describe such populations in terms of their density.
Population density is the total number of individuals of a species
per unit area or volume within a specified habitat or region. In many cases this number
can be pictured and measured more easily than population size itself. It also can be
used to compare populations that occupy areas of different size, allowing you to judge
where a population is more or less crowded.
As illustrated by the case of Valley Forge’s deer population, population size and density
are dynamic, or changeable, numbers. As humans we care about changes in the density and
sizes of other populations. We notice when the density of mosquitoes skyrockets after a
summer rain. We are concerned about the population sizes and densities of animals we
hunt, fish we harvest for food, and endangered species we seek to conserve. Much of
population ecology is directed toward predicting, understanding, and controlling changes
that occur in the populations of other species over time.
Why We Care about Populations
 In this image a mother white-tailed deer (Odocoileus
virginianus) and her two fawns forage in a suburban yard in Pennsylvania.
These fawns, if both survive to adulthood, will replace the mother and her mate. If
the mother produces additional successful offspring over her lifetime, the
population will grow. Most people enjoy watching deer, but overabundant deer can
damage gardens, pose a road hazard, and cause other problems for humans. By Glenn
Brinette (Deer) CC BY
2.0
In this image a mother white-tailed deer (Odocoileus
virginianus) and her two fawns forage in a suburban yard in Pennsylvania.
These fawns, if both survive to adulthood, will replace the mother and her mate. If
the mother produces additional successful offspring over her lifetime, the
population will grow. Most people enjoy watching deer, but overabundant deer can
damage gardens, pose a road hazard, and cause other problems for humans. By Glenn
Brinette (Deer) CC BY
2.0
Populations change through four primary processes. New members can arise by birth through reproduction of existing population members. In the photo on the
previous page, a white-tailed deer has given birth to two offspring (family sizes vary
widely among species). New population members may also immigrate
(move into the population) from other areas outside the boundaries set by the
researcher. A population declines through the death of its
existing members. The population may also decrease if members emigrate (move away to areas outside the boundaries enclosing the population).
To simplify calculations ecologists often assume that a population is closed - that
emigration and immigration do not occur. For this course we will adopt this idea and
assume that, unless otherwise stated, the populations we analyze are closed.
Researchers studying populations usually describe birth and death in terms of rates so
that they can compare different populations to each other on a similar basis. According
toFederal Bureau of Investigation Uniform Crime Report statistics, in 2010 there were
roughly 530 cases of murder in New York City and about 180 murder cases in New Orleans,
Louisiana. Think New York City is more dangerous? Raw numbers don’t tell the full story.
In 2010, New York City had a population of over 8 million people compared to New
Orleans’ population of about 350,000. Therefore the rate of
murder was almost 8 times greater in New Orleans than in NYC.
By calculating rates we can make fair comparisons between
populations regardless of their size. The simplest way to do this is by using per capita
(literally “per head”) rates where population size is included in the denominator of a
rate calculation. Per capita rates can be calculated for events like birth and death or
even occurrences like murders or car accidents. In each case, the calculation is
equivalent.
If N = population size at the beginning of a time period, the per
capita rate of some event is calculated as shown below for birth and death rates:
per capita rate of birth =
per capita rate of death =
Now you have some mathematical tools for describing a population’s status in terms of its
size, density, and birth and death rates. As we will see in the next page, the rates of
birth and death can be very helpful in projecting how a population will change over
time.
(1) Source: "The City of New York, Summary of Vital Statistics 2009"
Now that we know a bit about how to describe a population, how can we figure out how its
numbers will change over time? Let’s consider the relatively simple case of a closed
population, where there is no immigration or emigration. We can predict how a
population’s size will change over time simply by taking the difference between the
rates of birth and death:
- per capita rate of change = per capita rate of birth − per capita rate of death
A population will grow if its rate of birth is greater than its rate of death. The
population will remain constant if the two rates are equal—that is, if births are
balanced by deaths. It will decrease if the rate of death is greater than the rate of
birth.
Think of a population as a parade of generations, with each new crop of offspring
replacing the previous generation. For sexual species, the average female must produce
two offspring that live to reproduce: one to replace
herself, and another to replace her mate. Yet we know that most species attempt to
produce more—often far more—than one or two offspring. Furthermore, they often attempt
to live for several reproductive seasons, each time generating another set of offspring.
As long as conditions permit good survival and successful reproduction, any population’s
size will inevitably increase.
For any population, the actual quantity of increase (number added
to the population) will depend on how many you already have in the group. It can be
calculated as follows:
-
total number added per unit time = per capita rate of increase * starting N
That is, the per captita rate of increase multiplied by the starting population size (N).
Now you see that a rate of increase predicts how much a population will grow, and that
all species tend to increase if given good conditions for growth. Below are a table and
a graph that continue the process of growth for the Valley Forge NHP deer population,
using our estimated annual per capita growth rate of 0.39 deer added per deer per
year.
Exponential Model of Valley Forge NHP Deer Population
The population is projected to grow at a constant annual rate of increase (0.39 deer
added per deer per year, or 39% annual growth). Each year, the starting N is updated to reflect the growth of the previous year. For
example, the starting population for 1986 (236) = the base population from 1985 (170)
plus the growth from 1985 (66). Although the per capita rate of
growth remains constant, the number added each year increases with the base
population.
| Year |
N at Start of
Year |
Number Added |
| 1985 |
170 |
66 |
| 1986 |
236 |
92 |
| 1987 |
328 |
128 |
| 1988 |
457 |
178 |
| 1989 |
635 |
247 |
| 1990 |
882 |
344 |
| 1991 |
1226 |
478 |
| 1992 |
1704 |
665 |
| 1993 |
2369 |
924 |
| 1994 |
3293 |
1284 |
| 1995 |
4577 |
1785 |
Exponential growth
 Exponential growth of the Valley Forge NHP deer population assuming continued
growth at a constant annual rate of increase (0.39 deer added per deer per year or 39%
annual growth).
Exponential growth of the Valley Forge NHP deer population assuming continued
growth at a constant annual rate of increase (0.39 deer added per deer per year or 39%
annual growth).
The table and graph above depict a pattern of change called exponential
growth. In exponential growth, a quantity grows by a constant percentage each time step. As the quantity gets larger, so does
the actual amount of growth that occurs. Some familiar examples
of exponential growth involve finances. A bank account may earn 1% of its value in
interest each year.When the bank account’s value is $100, 1% amounts to a dollar. But if
the account already contains $1 million, a gain of 1% brings in $10,000!
You can recognize exponential growth as a pattern in which the numbers increase faster
and faster with each time step. A series of numbers with this property would be 2, 4, 8,
16, 32, 64, and so on. Visually, you can imagine exponential growth as a snowball
rolling down a hill, picking up snow as it goes: the bigger it gets, the faster it
grows. A wildfire spreading through dry grass might also grow exponentially. In a graph,
exponential growth shows up as a J-shaped curve.If you imagine the graph as a staircase,
each individual step is taller than the one that came before it.
A contrasting model of growth is linear growth. Here a quantity
grows by a constant number (not percentage) in each time
interval. A series of numbers with this growth pattern would be 2, 4, 6, 8, 10, 12, and
so on. Each time step the quantity increases by 2, no matter how big it might already
be. In a graph, linear growth appears as a straight line. A staircase is linear: the
risers are evenly spaced and you gain a set amount of height with each subsequent
step.
Compared to linear growth, the exponential growth pattern is a better starting point for
predicting how populations will change over time. It captures a little bit of reality,
in that a bigger group will have more individuals capable of producing offspring.
However, it is important to emphasize that the table and graph above are based on a
“what-if” exercise. They show numbers generated by a model of
how populations increase. This model assumes that the growth rate will remain constant
and predicts how the population will change if this condition is met.
All populations have the potential and tendency to increase. For sexual species, each
adult female must produce two adult offspring to replace herself and her mate and
thereby maintain a steady population size. But if conditions are right, individuals of
any type of organism will produce offspring in excess of this replacement number.
The exponential model of growth predicts what will happen if this potential is realized
each generation for an extended period of time. The population will grow faster and
faster the larger it gets, producing a characteristic J-shaped curve on a graph of
population size over time.
What actually happened to the deer population at Valley Forge NHP from 1985 onward? Data
are not available for the late 1980s or early 1990s. However, the record that is
available looks like this:
Estimated changes in deer population at Valley Forge NHP. Data are not available for the
time period from 1985 to 1996.Source:
A few things are evident in the graph. First, the population did not
increase to over 4500 by 1995 as predicted by the simple exponential growth model.
Instead, it increased to about 1400 until the early 2000s and then began to
fluctuate.
The exponential growth model assumes that populations will maintain constant rates of
birth, death, and increase as they grow larger. In reality, we often see that
populations stop growing—and sometimes even crash—due to the effects of limiting factors. Limiting factors are biotic or abiotic factors that limit populations by reducing birth rates,
increasing death rates, or both. Limiting factors may also increase rates of emigration
or decrease immigration.
Sometimes limiting factors act in an unpredictable way to reduce population sizes. Hard
freezes, fires, droughts, and floods are all examples of factors that could act to
quickly reduce a population. These factors most strongly affect small-bodied organisms
that are easy to kill such as insects, microbes, and weedy plants. Their populations
often show an erratic boom-and-bust pattern: population sizes shoot up when times are
good and crash when conditions are bad. Ecologists agree that it is difficult to predict
or model the changes in such populations, except by taking into account the weather or
other outside factors known to control them.
Other types of limiting factors act more gradually and have their greatest effects when
populations are crowded. Scarce resources, limited space, and infectious diseases are
important examples. These factors often play the greatest role in limiting large-bodied
organisms with extended life spans such as large animals and woody plants. For example,
deer survive frost well but are more likely to starve in a hard winter if there are many
mouths to feed. Over time, populations of such species limit
themselves: they remain close to a stable size called the carrying capacity. When a population is at its carrying capacity, it does not
tend to increase or decrease but tends to stay essentially the same over many
generations.
At least in principle, we can predict what will happen to a self-limiting population over
time: it should grow until it reaches its carrying capacity and then remain stable. This
pattern of change is calledlogistic growth. It is simple to
describe logistic growth with a math equation that allows a population to grow when it
is small but causes it to level off when it reaches a predetermined value (the carrying
capacity). A logistic model for the Valley Forge NHP is shown below, superimposed on the
actual population data from the park.
Logistic model and observed population sizes for deer at Valley Forge NHP.
 In purple (diamond symbols) are the observed population sizes for deer at Valley
Forge NHP. Based on these data, a logistic growth model was developed assuming that the
carrying capacity = 1312 deer and the average annual per capita rate of increase over
the period was 0.23, or 23%. The logistic model output is plotted with a green line /
square symbols.
In purple (diamond symbols) are the observed population sizes for deer at Valley
Forge NHP. Based on these data, a logistic growth model was developed assuming that the
carrying capacity = 1312 deer and the average annual per capita rate of increase over
the period was 0.23, or 23%. The logistic model output is plotted with a green line /
square symbols.
A graph of logistic growth shows up as a slightly S-shaped curve. Initial growth is
relatively slow because the population is small and has few individuals to give birth.
At moderate population sizes the population grows fastest: there are many parents but
the effects of crowding are not yet severe. As the population approaches its carrying
capacity, the effects of crowding start to reduce its growth. The rate of growth slows
and then stops.
Principles of population ecology are critically important to many enterprises including
game and fisheries management, conservation of rare and endangered species, and pest
control. How can a population be “managed”? Managers seek to control conditions for
survival and reproduction.
Management of threatened or endangered species may simply involve increasing birth and
reducing death rates as much as possible, though this is often easier said than done. To
help such species, conservationists may breed them in captivity and release individuals
back into the wild. Captive breeding programs have been used to aid in the recovery of
many species, including the peregrine falcon and the black-footed ferret. Most
endangered species management focuses on improving survival rates (reducing death rates)
by banning harvest of these species or trade in their products, by eliminating
introduced predators, or by improving habitat conditions.
The situation is more complicated when the goal is to manage a resource so that it can be
harvested. Consider a population of fish that supports a commercial fishery. Here, the
goal is to maximize the harvest rate while maintaining a healthy population size. How
can principles of population ecology help in choosing the best rate of harvest?
The general idea is that a population is like a bank account. Every so often, we can
remove the interest that has accumulated in a bank account. This
can continue indefinitely so long as we do not remove any of the principal that is earning the interest. Similarly, every so often we can
remove a population’s growth without causing the population to
decline: it will be reset to its beginning level and the harvested individuals will be
replaced by further reproduction and growth. Ideally, we should be able to find the
population size that provide the maximum level of growth (and harvest) each year.
Population modeling can help with this effort.
As you have just seen, the logistic model indicates that a harvestable population should
be maintained at a moderate size of about half its carrying capacity. At this point
there is a large increment of growth each year and these individuals can be harvested.
This is the general framework used by fisheries managers as they seek to maintain and
improve the productivity of fish populations. They often set regulations and allowable
harvest limits to try to keep populations close to the “sweet spot” at about 50% of
carrying capacity.
Fishery managed to maximize harvest.
 This idealized diagram shows a fish population managed to maximize the
sustainable harvest. The average size of the population is maintained at 50% of the
carrying capacity. Each year, the annual growth is harvested (glowing dashed lines =
harvest). The surviving population grows at a maximum rate and rebounds to enable
another harvest.
This idealized diagram shows a fish population managed to maximize the
sustainable harvest. The average size of the population is maintained at 50% of the
carrying capacity. Each year, the annual growth is harvested (glowing dashed lines =
harvest). The surviving population grows at a maximum rate and rebounds to enable
another harvest.
Population models help officials manage fisheries for maximum benefits to commercial
fishermen and recreational anglers. However, this approach can be risky. Models are not
the same as reality. Outside factors such as weather events, disease epidemics, and so
on can sometimes unpredictablydecimate fish populations. With fewer adults in the
population, the population cannot rebound after a harvest that would normally be
sustainable. Even just one bad year can set up a series of events in which the
population dwindles over time. Because of this unpredictability, many fisheries managers
try to maintain populations at a level that is a bit “too high” (say, 75% of carrying
capacity) and limit harvest rates accordingly. This reduces the amount of fish that can
be harvested but it also reduces the risk that harvests will drive the population
downward.
Endangered species and fisheries management are just a few of the areas in which
principles of population ecology are applied to solve real-world problems. Pest
management is often a very challenging exercise because pest species tend to reproduce
very rapidly and show a boom-and-bust pattern of growth. Even if we can induce a
bust—say, by spraying an insecticide—the population is likely to rebound with another
boom unless we can reduce the birth rate. Effective pest management often requires that
several strategies be used together with careful monitoring of the pest population.
Population management can also raise ethical issues. It involves life-and-death decisions
that can be very emotionally charged. At Valley Forge NHP, park managers recognized the
need to act as deer populations climbed past 1,000 and serious ecological damage began
to occur. The park’s plant diversity was severely threatened by the high deer numbers;
few tree seedlings or wildflowers were able to survive except within small fenced areas
(deer exclosures).
Most agreed that something should be done, but how should the
deer population be controlled? It would be unsafe to allow the public to hunt in the
park. Some citizens argued that birth control injections should be used to manage the
population, but evidence indicated that this would be expensive and ineffective. After
extensive deliberation and community input, a deer control program was begun. In the
winters of 2010 and 2011, sharpshooters were contracted to kill deer at the park; meat
was provided to an area food bank. Sharpshooters removed 600 deer in 2010 and 377 deer
in 2011. As a result, the deer population fell from 1,277 in 2009 to 374 in the spring
of 2012. Initial data indicate that many tree, shrub, and wildflower species are already
beginning to recover as a result.
To learn more / sources: Valley Forge NHP
White-Tailed Deer Management Page
Until now, we have focused on specific populations responding to limiting factors such as
weather, crowding, or fishing by humans. Community ecology broadens the focus to explore
how populations of different species interact with each other. An ecological community is the collection of all interacting species populations
within some defined area. Because animals move in and out of any given area, it can be
tricky to determine what populations belong within a community. For example, birds such
as herons may interact with pond communities by removing fish. They are therefore
included as part of the pond community because they can have an important effect on pond
life.
Scientists learn about species interactions first by direct observation. For example, it
is simple enough to discover a predator-prey relationship by watching a lion take down
an antelope, or by finding prey in a predator’s stomach. However, community ecologists
often want to go a step further and determine the consequences
of an interaction. How will a community change if a new species is added, or if an
existing population dies out? To find out, ecologists may do comparative observations or
experiments, as we will see in this module.
In several examples we will also see that community ecology is important to people.
Managers of nature preserves and wildlife parks seek to increase or maintain the
diversity of native species in the areas under their care. Community interactions may
also control the abundance of pests, disease agents, pollinators, fish, game animals,
and other species that have a direct effect on human well-being.
An ecological community can be described in many different ways. One statistic that is
often of interest is the species richness of a community: the
number of different species of organisms present in a given area. Some communities, such
as tropical rainforest or coral reef communities, have high species richness with
thousands of species of plants, animals, and microorganisms coexisting in a small area.
Other communities with harsher conditions (deserts, arctic tundra, salt lakes) may hold
far fewer species. Within any region, a given type of habitat will have a fairly
predictable level of species richness. Human activities that alter living conditions,
such as pollution or habitat destruction, can change the membership of communities and
usually will cause species richness to drop. Thus a naturally high level of species
richness is one indicator that a community is healthy and relatively unaffected by human
activities.
An interspecific interaction is an effect of one population on
another in a community. Although we are often focused on how one population affects the
size of another, ecologists also may look at how species interact in terms of their
activity, growth rates, body size, or other aspects of their well-being. Interactions
are classified according to their consequences for each species involved. The most
important types of interactions are summarized in the table below.
| Interspecific interactions classified by consequences for interacting
species. |
|---|
| Interaction |
Species 1 |
Species 2 |
Description |
Example(s) |
| mutualism |
benefits from presence of species 2 |
benefits from presence of species 1 |
Win-win interactions. May involve species trading materials, services, or
both. |
The cleaner wrasse is a small fish that eats parasites from mouths of larger
fish. Both benefit: wrasse gets food, big fish gets groomed. |
| predation |
predator benefits from presence of prey |
prey harmed by presence of predator |
Usually involves predator killing and eating prey. Also
includes more subtle types of win-lose interactions. |
Bird (predator) eats caterpillar (prey). Bird benefits, caterpillar is harmed.
Grasshopper (predator) eats plant (prey). Grasshopper benefits, plant is
harmed. |
| competition |
harmed by presence of competitor |
harmed by presence of competitor |
Lose-lose interactions. May involve two species interfering directly (fighting)
or using the same limiting resource. |
Two species of grass grow together in a meadow. Both require light, water, and
similar nutrients. If one species of grass is removed, the other species grows
better and reproduces more. |
|
In a community, any pair of species may potentially interact.
However, some interactions are much clearer and more easily predictable than others.
Direct interactions occur when two species make contact and affect
each other’s well-being without the participation of any third species. Some pairs of
species are intimately and physically connected, with a smaller species (symbiont)
living in or on the body of a larger species (host). These direct interactions are
described using the term symbiosis,which translates to “together living.”
In other cases the contact between direct interactors is more fleeting, as when a bee
visits a flower or when a hawk swoops down on its prey.
Mutualistic, or mutually beneficial, relationships are widespread
and important features of communities. Sometimes mutualism also involves symbiosis. Many
animals and plants are host to microorganisms that provide them with vital functions. In
other cases, equally important mutualistic transactions are carried out at a distance:
not all mutualisms are symbiotic. Plants, for example, reward animals for transportation
services that allow them to mate (pollination) and travel as seeds (seed dispersal).
Animals also may help each other in subtle ways.
Predation can be broadly defined as any win-lose interaction,
though it is most commonly used to describe situations where one species kills and eats
another. You are no doubt familiar with many spectacular examples, as when a pack of
wolves takes down a moose. More subtle examples of predation also exist. Sometimes the
predator will eat only part of the prey, allowing it to live another day. Though we
often use the term “herbivory” for the consumption of plants, the moose
might itself be considered a predator if it harms the plants on which it feeds. Many
forms of predation involve symbiosis. Such interactions are called parasitism
and may involve animal or a plant hosts that provide both habitat and food to
their harmful symbionts.
Competition is a lose-lose, or mutually harmful, relationship
between two species. Two species are competitors if each would be better off alone.
Clear examples of competition are often seen among plants that require very similar
resources, such as light, water, and certain mineral nutrients. Animals may compete for
space, sometimes fighting directly for territory or simply excluding each other from
living sites. Animals that eat similar foods may also sometimes make life harder for
each other, though here the degree of competition is often limited because each species
may eat slightly different foods.
Whenever ecologists study species interactions, they try to get clear data answering
“what-if” questions. What happens to prey populations if a predator is removed from a
community, or if a new predator shows up? Do two species really
compete; that is, do they each do better if they are alone than if they are living
together in a habitat? Can a species and its mutualist live apart, or are the two
species entirely dependent on each other? Sometimes we can learn about these issues
simply by observing what happens when introduced species—species
brought into an area by human activity—establish themselves in a community. We can also
see what happens to the larger community if a particular population is eradicated by
human activity. On a smaller scale, ecologists sometimes carry out true experiments. In
these studies ecologists deliberately manipulate the presence or abundance of species in
enclosures or in natural environments and then track what happens to other species as a
result.
Explore some examples of species interactions below. In each case you may be asked to
identify the type of interaction—mutualism, predation, or competition—and to clarify
exactly how the species interact.
Ecological interactions range from harmful to helpful and can take on many forms. Some
interactions involve exchanges of materials; others are more subtle and involve services
or behaviors. Mutualistic interactions often develop when two partners have
complementary abilities. For example, aphids are excellent plant sap drillers but ants
are much tougher and more mobile, so the trade between aphid and ant is quite logical.
Predation is a nearly universal interaction: almost every organism is food for something
else, and most animals eat living prey of some kind. Competition often develops where
individuals or species have similar requirements, like the plants that will crowd
together in a dense Alabama thicket if conditions permit it.
Ecological communities can be dizzyingly complex. A community may be home to thousands of
species, and every single one of them may be linked to several others through a variety
of interactions. Among all this complexity, ecologists have worked to discover the most
meaningful and important interactions: those that determine the stability and diversity
of the whole community.
One way to simplify the problem is to focus on a few particularly important species.
Species that are physically dominant (largest and/or most abundant) in communities are
sometimes called foundation species. They include the most abundant
trees within terrestrial forests, common grasses within grasslands, and reef-building
corals. Foundation species directly provide habitat and often food for most of the other
species in the community. Anything that threatens their well-being is likely to harm
many other species as well.
Along the coast of western North America, rocky areas are often home to a spectacular
community called the kelp forest. It is dominated by kelp, big brown algae (seaweeds)
whose fronds can stretch to dozens of meters in length. Kelp are clearly the foundation
species of the kelp forest: they provide food and shelter to a huge diversity of fish
and invertebrates including such economically important species as lobster and
rockfish.
Kelp and sardines off the California coast
 Kelp fronds shown here are surrounded by sardines and provide food and cover
for a wide range of marine animals. By NOAA (Kelp and
Sardines) CC BY-SA
2.0
Kelp fronds shown here are surrounded by sardines and provide food and cover
for a wide range of marine animals. By NOAA (Kelp and
Sardines) CC BY-SA
2.0
Most communities are clearly dependent on one or a few foundation species. But not every
important species has effects that are so obvious. In ecological communities, many
interactions are indirect.Indirect interactions, sometimes called
“ripple effects,” occur through chains of cause and effect. The effect of one species on
another is said to be indirect if one or more additional species
are involved in the interaction as intermediaries. Complexity of this sort is a source
of fascination and challenge for ecologists attempting to unravel how communities
work.
Indirect interactions can produce surprises in communities. Some species, called keystone species, may be very influential in communities even
though they are not particularly abundant or large. In architecture, a keystone is a
single wedge-shaped stone at the top of a stone arch that maintains the integrity of the
structure; its removal will cause both sides of the arch to collapse. A keystone
species, then is a species that has an unexpectedly strong effect on community stability
or diversity. Keystone species play unique roles and are not easily replaced by other
species within the community. We often discover their importance only after they are
eliminated by human actions.
Within kelp forests, human hunting revealed the importance of a keystone species. The
story begins with urchins, which are abundant bottom-dwelling grazers and scavengers.
Kelp are tough and fast-growing, but urchins (animals related tostarfish) can eat them
with their hard rasp-like mouth parts. Urchins are protected by their prickly spines and
a hard outer shell. In the absence of factors controlling their abundance, urchins can
increase to very high densities, producing what are sometimes called “urchin barrens”
devoid of kelp. Unlike kelp forests, urchin barrens do not support much life.
Purple sea urchins
 A thick aggregation of purple sea urchins at a tidepool in California. By Steve
Jurvetson (Purple
Urchins) CC BY 2.0
A thick aggregation of purple sea urchins at a tidepool in California. By Steve
Jurvetson (Purple
Urchins) CC BY 2.0
What factors normally keep urchins in check? In the cold waters off the west coast of
Alaska and Canada, evidence points to one factor as particularly critical: the presence
of sea otters. Historically, humans hunted sea otters for their fur, nearly eliminating
them by the late 1800s. More recently, sea otters have been reintroduced to many areas
where they had been absent. Since the 1980s, researchers, including James Estes of the
University of California Santa Cruz, have been tracking sea otter numbers and
documenting their effects on marine communities in Alaska and off the coast of British
Columbia. They have found that the sea otter is a keystone species in the kelp
forest.
Sea otters are uniquely suited to eating the urchins. With their dexterous paws and long
incisors, they can crack open the urchins, eating the soft flesh inside. Sometimes they
even use rocks as tools to crush tough prey. After eating an urchin, a sea otter
discards its empty shell, or test. A study published in 2011 by
Estes and Jane Watson reported that when broken tests sink to the bottom, remaining
urchins will flee from the immediate area. Thus, sea otters can reduce urchin numbers
and change urchin behavior. In this way, otters safeguard kelp and help to maintain
healthy kelp forests.
 California Sea Otter resting within a group off the coast of California. Note
the large teeth, which are used to break into sea urchins and help explain the
unique keystone role of sea otters in Alaskan and Canadian kelp forests. A frond of
kelp is wrapped around the otter’s abdomen. Note that kelp forests in California do
not appear to depend as directly on sea otters as those in Alaska or Canada. A wider
range of factors may act to control urchin numbers along the California coast. Left
image by Mike Baird (California Sea Otter) CC BY 2.0 Right
Image by Mike Baird (California Sea Otter resting) CC BY 2.0
California Sea Otter resting within a group off the coast of California. Note
the large teeth, which are used to break into sea urchins and help explain the
unique keystone role of sea otters in Alaskan and Canadian kelp forests. A frond of
kelp is wrapped around the otter’s abdomen. Note that kelp forests in California do
not appear to depend as directly on sea otters as those in Alaska or Canada. A wider
range of factors may act to control urchin numbers along the California coast. Left
image by Mike Baird (California Sea Otter) CC BY 2.0 Right
Image by Mike Baird (California Sea Otter resting) CC BY 2.0
Kelp forests provide a glimpse into the many facets of community ecology. They are
complex, with more than twenty species of kelp plus hundreds of animal species. They
also are structured in an understandable way, with some species interactions more
important than others. As ecologists continue to unravel community interactions, we are
improving in our ability to predict how communities will respond to factors like
hunting. Kelp forests are a treasured resource for recreational diving and fishing. Kelp
also are harvested for use in aquaculture and industry. The science of ecology can help
us learn more about kelp forests and supports our efforts to safeguard these dazzling
communities.
Source and To Learn More:Whipple,
WJ and RL Beschta. 2012. Trophic cascades in Yellowstone: The first 15 years after
wolf reintroduction. Biological Conservation 145: 205-213.
Bees and Community Interactions
A fly that Parasitizes Honeybees
 Fly parasites that may help explain colony collapse disorder in honeybees. The
figure above shows an adult fly (A), a fly laying its eggs on a bee host (B), and
the larvae emerging from the host (C). (Core et al., 2012)
Fly parasites that may help explain colony collapse disorder in honeybees. The
figure above shows an adult fly (A), a fly laying its eggs on a bee host (B), and
the larvae emerging from the host (C). (Core et al., 2012)
People are concerned about ecological community interactions for many reasons. For
example, animal pollinators help us produce crops including almonds, soybeans, apples,
tomatoes, coffee, cotton, and many more. In fact, over a third of global crop production
depends on animal pollinators. Many of these crops are pollinated by domesticated
honeybees. Originally native to Eurasia, honeybees were brought to North America by the
earliest European settlers. Native Americans are said to have called them the “white
man’s fly.” Honeybees and other pollinators transfer pollen from one flower to another,
helping to increase seed and fruit yield.
Ongoing declines in bee populations are a major focus for ecological research. Since
about 2006, North American beekeepers have been plagued by a complex problem called
colony collapse disorder, in which worker bees abandon their hives. Research has
implicated parasitic mites, viruses, pesticides, and other factors in causing bee colony
declines. In 2012 scientists documented another threat: honeybees are being parasitized
by a fly that was not previously known to interact with them. The fly lays its eggs on
worker bees and its larvae live within bees, feeding on their body tissues. When the fly
larvae are mature, the worker bee hostswander away from their hives at night and die
away from the colony. The fly larvae then abandon the host, beheading it as they
exit.
Even the gory interaction with decapitating flies probably cannot explain colony collapse
disorder all by itself. Instead, experts agree that many factors have likely worked
together to threaten bees. As we learn more about the habitat needs of bees and threats
to their existence, we may be able to find ways to protect them. In this way, biologists
hope to reinforce the ancient mutualism between bees, crop plants, and food
producers.
To learn more review the following sources:
- Core A, Runckel C, Ivers J, Quock C, Siapno T, et al. (2012). A New Threat to Honey
Bees, the Parasitic Phorid Fly Apocephalus borealis. PLoS ONE 7(1): e29639.doi:10.1371/journal.pone.0029639
- Krupke CH, Hunt GJ, Eitzer BD, Andino G, Given K (2012). Multiple Routes of
Pesticide Exposure for Honey Bees Living Near Agricultural Fields. PLoS ONE 7(1):e29268. doi:10.1371/journal.pone.0029268
- Lautenbach S, Seppelt R, Liebscher J, Dormann CF (2012). Spatial and Temporal Trends
of Global Pollination Benefit. PLoS ONE 7(4): e35954.doi:10.1371/journal.pone.0035954
Up to this point, we have focused on the living components of the environment. Consider a
suburban backyard that is home to diverse species, including robins, squirrels, ants,
oak trees, grass, rabbits, daisies, spiders, toads, mushrooms, and raccoons. These
living, or biotic, components together make up an ecological community. Its populations
affect each other directly and indirectly as we just explored. But each population also
interacts with a host of nonliving factors. A grass plant, for instance, requires light,
carbon dioxide gas, soil nutrients, and water. It is affected by temperature and by
factors like snow cover or fires. In turn, it influences nonliving factors as well. Its
roots, for example, hold soil in place.
To fully appreciate an organism’s role in the environment, we must go beyond the web of
life. We must also consider nonliving, or abiotic, components of the environment: rocks,
water, gases in the air, chemicals in soil and water, light, temperature, wind, and
waves. The combination of biotic and abiotic components forms an ecosystem. A community
is restricted to the populations of living organisms in an area; an ecosystem also
includes all of the nonliving physical and chemical factors that are important to these
populations.
In a healthy ecosystem, there is a continuous flow of energy that provides resources to
sustain a diverse community of life. As we will explore in this module, energy starts in
a nonliving form, usually as sunlight, and is captured and stored as chemical energy by
producers. It then moves through chains of consumers, dissipating as heat along the way.
A continuing supply of solar energy keeps this system in motion.
As they take up and release energy, growing organisms also absorb chemical nutrients and
release chemical wastes. There is a continuous exchange of material between the living
and nonliving portions of the ecosystem. Each chemical element retains its integrity but
takes on many different forms as chemical bonds are formed and broken. To see how this
material recycling takes place, think about a leaf on a tree. Its living tissue contains
organic molecules rich in carbon (C), hydrogen (H), nitrogen (N), oxygen (O), phosphorus
(P), sulfur (S), and other elements. In autumn, the leaf dies and falls to the ground.
Over time, the leaf decays. Bacteria and fungi feed on the leaf material. In the
process, its large organic molecules are broken down to simpler inorganic molecules.
Focusing on just one element, the nitrogen atoms that were in the leaf are now released
to the soil as ammonium (NH4+). To complete the cycle back to life, plants take up
ammonium through their roots and use its nitrogen to make proteins and nucleic acids.
Thus, nitrogen has cycled between the biotic and abiotic components of the
ecosystem.
Energy and nutrients take many complicated paths through an ecosystem. Feeding
relationships are a good place to start; they describe how atoms and calories move
through the living community. Take as an example the simple act of eating a tomato. A
tomato plant grows and produces fruit only if it has plenty of light and nutrients.
Chemical energy is stored in the bonds that join together the tomato’s organic
molecules. After you eat and digest a tomato, some of its molecules are broken down into
their subunits. Your cells can use some of that energy to make new molecules or run
processes in your cells. Much of it is released as heat.
The simple example above illustrates two transfers of energy: sunlight → tomato and
tomato → human. Every organism in an ecosystem must obtain its energy through one or
more such transfers. Some organisms are close to the source of energy (the tomato);
others are several steps down the line (a hawk that eats a bird that ate a caterpillar
that ate the tomato plant). We can break a community up into a series of food-based
groups called trophic levels. Trophic level 1 is composed of producers that
form the base of all ecosystems. Organisms in level 1 are eaten by organisms in level 2;
organisms in level 2 are eaten by organisms in level 3; organisms in level 3 are by
organisms in level 4, and so on.
The energy that fuels most ecosystems comes from the sun. Photosynthetic
producers such as plants are found in trophic level 1. Organisms in level 1
do not consume other living organisms to obtain nutrients. They can make simple organic
food molecules from inorganic raw materials using light energy from the sun. Plants,
algae, and cyanobacteria are the photosynthetic producers that make up trophic level 1
in most ecosystems. Organisms in level 2 and beyond are called consumers
because they obtain food by eating plants or by eating organisms that have eaten plants.
Animals, fungi, and many microbes are consumers. Consumers are identified as primary,
secondary and tertiary depending on their trophic level. Cows eat grass and are primary
consumers. When you consume a salad, you too are acting as a primary consumer. Humans
who eat meat from cattle act as secondary consumers.
In addition to the chains of consumers that eat living prey, many consumers feed on dead
organic material. Dead plants, dead animals, shed parts of animals such as fur or skin,
shed parts of plants such as leaves, and feces all contain nutrients and calories.
Animals that feed on dead organic matter are called detritivores; some of them
specialize on eating dead animals (e.g., vultures) and others feed on dead plant
material (e.g., earthworms, which consume decaying leaves). Bacteria and fungi that
colonize dead material and absorb food molecules from it are called
decomposers. Detritivores and decomposers extract remaining calories and
nutrients found in dead organisms and dung. In the process, they release simple
inorganic wastes to the environment, making chemical elements available to
producers.
A food chain is a group of organisms that are joined in a linear series of
feeding relationships. Each species in a food chain gains energy from a single source
and is, in turn, a source of energy to at most one consumer as shown in the picture
below:
 CAPTION: A simple food chain diagram. Light energy flows from the sun. The
plant uses that energy to produce food energy. The grasshopper eats the plant
leaves. The mouse eats the grasshopper and the snake eats the mouse.
CAPTION: A simple food chain diagram. Light energy flows from the sun. The
plant uses that energy to produce food energy. The grasshopper eats the plant
leaves. The mouse eats the grasshopper and the snake eats the mouse.
In the food chain above, the plant is the producer, the grasshopper is the primary
consumer, the mouse the secondary consumer and the snake is the top predator or tertiary
consumer. Food chains help us trace the flow of energy and materials through ecosystems.
Based on the transfers shown above, plants are in trophic level 1, grasshoppers are in
trophic level 2, mice are in level 3, and snakes are in level 4. Each level is dependent
on the previous level as a source of food and may provide nutrients and energy to a
subsequent level.
Food chains are not very realistic. In real ecosystems, food chains overlap and are
interconnected as food webs. Consumers rarely specialize on only one type of food. Many
of them are omnivores, feeding on more than one trophic level. Mice, for example, may
eat:
- plant seeds or fruits (acting as primary consumers, trophic level 2)
- grasshoppers (acting as secondary consumers, trophic level 3)
- dead snakes or snake eggs (acting as level 5 consumers)
In addition, most organisms are fed upon by more than one species. A mice could be eaten
by a snake, but it could also be eaten by an owl, a hawk, or a house cat. A complete
food web shows all of these possible feeding relationships. In diagrams that depict food
chains or food webs, the arrow points from the organism being eaten to the organism
doing the eating. In other words, the arrows follow the flow of energy and nutrients
through the ecosystem.
We have seen how food chains, trophic levels, and food webs can be
used to describe how energy and materials move through an ecosystem.
Although they are not as realistic as food webs, food chains and trophic
levels do provide us with some important insights. They help us
understand, for example, why top predators are rare and why meat costs
more than grain.
All organisms require energy for growth, reproduction, and
metabolism. But as energy flows through a food web, much of it is lost
at each transfer along the way. Let’s trace how energy moves through a
simple ecosystem consisting of tomato plants, caterpillars, and birds.
Transfer 1: sunlight → tomato plant. Most of the sunlight
energy that reaches the plant is reflected or absorbed and re-emitted
as heat. Some is captured by photosynthesis. Most of this is used by
the plant for aerobic respiration and ATP generation; ultimately this
energy is released as heat. Only about 1% of the incoming solar energy
is stored as calories in the molecules within the tissues of the growing
plant.
Energy transfer from the sun to producers
 Of
the available solar energy (100%), producers capture and store only
about 1% as growth that is then available as food calories to primary
consumers in the ecosystem. The rest of the energy (99%) is reflected
as light or released as heat.
Of
the available solar energy (100%), producers capture and store only
about 1% as growth that is then available as food calories to primary
consumers in the ecosystem. The rest of the energy (99%) is reflected
as light or released as heat.
Transfer 2: tomato plant → caterpillar. Much of the
energy in the leaf material eaten by a caterpillar is not digested and
is excreted in feces. Of the energy that is absorbed, most is used in
aerobic respiration and is released as heat. Only about 10% is stored
as calories in the molecules (fats, proteins, etc.) that make up the
tissues of the caterpillar.
Transfer 3: caterpillar → bird. Some of the energy in the
caterpillar is excreted in the bird’s feces. Most of what is absorbed
is used in aerobic respiration and is released as heat. Only about 10%
is stored as calories in the tissues of the bird.
Energy transfer through consumers
 Of
the food calories ingested, consumers store only about 10% as growth
that is then available as food calories to consumers in the next trophic
level. The rest is excreted in feces (calories in undigested food) or
is released as heat.
Of
the food calories ingested, consumers store only about 10% as growth
that is then available as food calories to consumers in the next trophic
level. The rest is excreted in feces (calories in undigested food) or
is released as heat.
If you are a bird-eating consumer such as a snake or hawk, very
little energy is available to you. Based on the estimates above, you
would have access to only 0.01% of the solar energy that fuels the
ecosystem as a whole.
As you can see, only about 1% of incoming solar energy is stored as
calories in the tissues of growing photosynthetic producers. This
energy is then passed up to higher trophic levels through a series of
transfers. On average, only about 10% of the available energy in one
trophic level is incorporated and stored as calories in the bodies of
the next level up. The rest of the energy is released undigested in
feces or is dissipated as heat. The result is that all ecosystems show a
pattern known as the energy pyramid in which energy
availability decreases with increasing trophic level. The bottom of the
pyramid contains producers (usually plants or algae). Each trophic
level of consumers (level 2 and above) becomes progressively smaller.
The amount of energy available to consumers at the top of the pyramid is
much smaller that what is available to organisms at lower levels.
The diagram below shows each trophic level as a block of color. In
keeping with real patterns as seen in many ecosystems, each block’s
area is 10% or one-tenth that of the preceding block. That leaves
mighty slim pickings for level 5!
Ecosystem energy pyramid
 A
realistically scaled energy pyramid. Blocks are scaled so that their
area shows the amount of energy available to each trophic level. 90% of
energy is lost as heat or waste with each transfer in a food chain.
A
realistically scaled energy pyramid. Blocks are scaled so that their
area shows the amount of energy available to each trophic level. 90% of
energy is lost as heat or waste with each transfer in a food chain.
In real ecosystems, energy availability can be measured in many
different ways. The mass of organisms at each trophic level can be
measured, or their total annual calorie requirements can be estimated.
In either case, the overall energy pyramid pattern remains quite
consistent. This helps to explain why huge hunting grounds support only
small numbers of top-level predators such as killer whales, great white
sharks, or tigers.
The energy pyramid also has implications for humans. Our diet is
very flexible. Strict vegetarians live on trophic level 2. Those who
eat a lot of animal products live closer to trophic level 3. When grain
is fed to animals much of its calorie content is used by the animals
themselves, and only a small fraction is available to us in the food
that is produced. Therefore people who eat a diet rich in animal
products generally have a greater total environmental impact—in terms of
crops consumed, fertilizers used, land area farmed, etc.—than those who
eat plant foods. And as seen in the largely vegetarian traditional
diets of rural China or India, a given land area can support more people
at lower cost if they live on trophic level 2.
Energy enters ecosystems as sunlight and dissipates from all living
things as heat. Producers (trophic level 1) have access to the
greatest amount of energy (sunlight). As they grow, they store up food
calories that supply all consumers with energy. Consumers feed on
producers directly (trophic level 2) or feed on each other through a
series of transfers that can be described as a food chain. The amount
of energy available to consumers declines by about 90% with each
transfer, so top predators at the end of long food chains tend to be
rare.
All living things are made of carbohydrates, lipids, proteins,
and nucleic acids, and they all contain roughly the same blend of
chemical elements. The most important are carbon (C), hydrogen (H),
oxygen (O), nitrogen (N), phosphorus (P), and sulfur (S). Earth has a
finite stock of each of these chemical elements, but the atoms are
immortal. In any transfer or reaction the total number of atoms of each
element will stay the same. Matter does not disappear or appear from
nothing; it is conserved.
Earth’s immortal atoms move through living things as we feed,
breathe, and excrete solid and liquid wastes. The same atoms are also
found in abiotic reservoirs, stored up within rocks, soil, water, and
air. They bond with other elements to take shape as many different
materials. Carbon, for example, makes up the backbone of all organic
macromolecules. Outside of life, it exists as carbon dioxide gas that
mixes into the air and dissolves into water. This gas gives carbonated
beverages their fizz. Limestone rock, coal, and diamonds are some solid
materials rich in carbon.
Organisms must obtain chemical nutrients in very specific forms.
You would starve without suitable organic macromolecules (food), even
if you were surrounded by carbon-rich limestone, air, and wood. A plant
has very different needs. It would starve without access to carbon
dioxide gas, even if you planted its roots in a juicy porterhouse steak.
Organisms’ needs are met through continuous recycling of chemical
elements. Direct biotic cycling occurs when producers use wastes
excreted by consumers; urine contains nitrogen and phosphorus compounds
that can act as plant fertilizer. Cycling also occurs through
decomposition. When an organism dies, its macromolecules are broken
down by bacteria or fungi and the elements are returned to soil, air or
water as simpler compounds. Physical processes (weather, formation and
erosion of rocks, etc.) also transform and transport elements. Biogeochemical cycles are the pathways that chemical elements follow through ecosystems; they involve life (bio) and nonliving components (geo) .
Biogeochemical Cycles
We will discuss four cycles that are key for living things: the
water, carbon, nitrogen, phosphorus cycles. Key features of each cycle
are summarized below in the table:
|
Water H2O |
Carbon C |
Nitrogen N |
Phosphorus P |
| main gaseous form |
water vapor (H2O) |
carbon dioxide (CO2) |
Nitrogen gas (N2) |
none |
| importance to life |
solvent that makes up most of the mass of all living cells; stabilizes temperature |
forms the backbone of carbohydrates, lipids, proteins, and nucleic acids |
found in proteins and nucleic acids |
found in phospholipids, ATP, and nucleic acids |
| abiotic reservoirs |
air, groundwater, ice, salt and fresh water bodies |
air, dissolved in water, soil, rock |
air, dissolved in water, soil |
dissolved in water, soil, rock |
| available to producers as |
liquid water |
carbon dioxide (CO2) in air or dissolved in water |
ammonium (NH4+) or nitrate (NO3−) dissolved in water |
phosphate (PO43−) dissolved in water |
| major driving processes |
physical processes (evaporation, precipitation) plus plant transpiration |
aerobic respiration and photosynthesis; formation and erosion of rocks |
bacterial action; for example, bacteria convert N2 gas from air to usable form for producers |
formation and erosion of rocks |
The Water Cycle
Water is an input to photosynthesis and a waste product of
aerobic respiration, so it is biotically cycled. These flows are
relatively small. Solar energy powers the major processes driving
Earth’s water cycle. Water evaporates, condenses in the air, returns to
Earth as precipitation, and is transported through wind, river flow,
and ocean currents. Land plants play an important role in the water
cycle. They take up water through their roots and release it as vapor
through tiny holes in their leaves called stomata. This process, called
transpiration, greatly accelerates the transfer of water from soil to
the atmosphere. A forest can increase humidity and even boost rainfall
in a region through this process.
The Global Water Cycle
 Water is cycled by physical processes between the oceans, atmosphere, glaciers, soil, and fresh water. Source: USGS (Water Cycle) Public Domain
Water is cycled by physical processes between the oceans, atmosphere, glaciers, soil, and fresh water. Source: USGS (Water Cycle) Public Domain
Humans also influence the water cycle by damming rivers and by
pumping groundwater. We slow the return of water to the ocean and
redistribute it to meet our needs; by far the largest human use of water
is crop irrigation.
The Carbon Cycle
Carbon is cycled through a variety of biological and physical
processes. Photosynthesis removes carbon dioxide from the atmosphere;
aerobic respiration by living plants and animals returns carbon to the
air. Decomposition, a combination of aerobic respiration and
fermentation carried out by microbes, takes carbon from dead material
and returns it to the atmosphere. In the much longer term, geologic
processes store carbon in fossil fuels and in rocks such as limestone.
This stored carbon is slowly returned to active circulation by erosion
of rock and by volcanic eruptions.
The Global Carbon Cycle
 “Fast”
flows and stores of carbon in the global carbon cycle. Numbers are in
gigatons or billions of tons of carbon. Numbers in parentheses are
stocks; yellow numbers are natural flows and red numbers are
human-generated flows in gigatons per year. Fossil fuels and deep
oceans hold large masses of carbon. Natural flows into and out of the
atmosphere (photosynthesis, respiration, decomposition, air-sea
exchange) are roughly balanced. Source: NASA (Carbon Cycle) Public Domain
“Fast”
flows and stores of carbon in the global carbon cycle. Numbers are in
gigatons or billions of tons of carbon. Numbers in parentheses are
stocks; yellow numbers are natural flows and red numbers are
human-generated flows in gigatons per year. Fossil fuels and deep
oceans hold large masses of carbon. Natural flows into and out of the
atmosphere (photosynthesis, respiration, decomposition, air-sea
exchange) are roughly balanced. Source: NASA (Carbon Cycle) Public Domain
The Nitrogen Cycle
Nitrogen is cycled mainly through biological processes. The atmosphere is a huge reservoir of nitrogen; it is almost 80% N2 gas. However, most life forms cannot use nitrogen gas. Plants and algae obtain nitrogen as nitrate (NO3−) or ammonium (NH4+).
These compounds dissolve in water and are absorbed directly (algae) or
taken up through the roots (plants). Bacteria are the key
intermediaries that drive the nitrogen cycle. Some bacteria, called
nitrogen fixers, transform N2 gas to ammonium that plants can
use. Bacterial and fungal decomposers break down dead organic matter
and also generate ammonium. In traditional and organic agriculture,
plant and animal wastes (particularly manure) are collected and
composted to favor the activity of decomposers and nitrifying bacteria.
The resulting nitrate-rich compost is spread on fields, providing
usable nitrogen to crop plants.
The Terrestrial Nitrogen Cycle
 Biological
cycling of nitrogen through terrestrial ecosystems. Only a few
chemical forms of nitrogen are available for uptake (assimilation) by
plants. Bacteria play multiple roles in the nitrogen cycle, including
nitrogen fixation and decomposition. Source: EPA (Nitrogen Cycle) Public Domain
Biological
cycling of nitrogen through terrestrial ecosystems. Only a few
chemical forms of nitrogen are available for uptake (assimilation) by
plants. Bacteria play multiple roles in the nitrogen cycle, including
nitrogen fixation and decomposition. Source: EPA (Nitrogen Cycle) Public Domain
The Phospohrus Cycle
Phosphorus does not have a gaseous form, so it is not cycled globally through the atmosphere.
Instead it circulates among living organisms, soil, water, and rocks. You can
think of the phosphorus cycle as a combination of two cycles: one fast and
local, the other very slow and global. The fast cycle is driven by producers,
consumers, and decomposers. Plants and algae take up phosphate dissolved in
water and use it to make organic compounds. Consumers feed on them and excrete
phosphorus in their feces and urine. Bacteria and fungi decompose dead organic
matter and return phosphates to the soil and water, completing the loop.
Producers are extremely efficient in taking up phosphate from water and
phosphorus is often a key resource that limits the growth of plants. Phosphorus
does not have a gaseous form, so it is not cycled globally through the
atmosphere. Instead it circulates among living organisms, soil, water, and
rocks. You can think of the phosphorus cycle as a combination of two cycles: one
fast and local, the other very slow and global. The fast cycle is driven by
producers, consumers, and decomposers. Plants and algae take up phosphate
dissolved in water and use it to make organic compounds. Consumers feed on them
and excrete phosphorus in their feces and urine. Bacteria and fungi decompose
dead organic matter and return phosphates to the soil and water, completing the
loop.
The slow phosphorus cycle involves the buildup, movement, and
erosion of rocks. Over time, phosphorus tends to follow the flow of
water downhill. Phosphorus-rich sediments build up on ocean and lake
bottoms, forming phosphate rocks over time. Seabird and bat colonies
can also produce concentrated deposits of guano (excrement) that is very
rich in phosphates. Through slow geologic processes, rocks containing
phosphorus can be lifted up to form new land masses and their erosion
can make phosphates available to producers once again.
Humans now play a huge role in the global nitrogen and phosphorus
cycles. Today, artificial fertilizer production fixes more nitrogen
than all natural processes combined. Phosphate mining removes
phosphorus from storage in rocks much more quickly than natural uplift
and erosion. Fertilizers run off farm fields and enter water bodies
directly; human and animal wastes also deliver excess nitrogen and
phosphorus to water bodies. The result is eutrophication, the
overfertilization of aquatic ecosystems by humans. Excess ammonium can
kill fish. Extra phosphates and nitrates fuel blooms of algae and
cyanobacteria. These turn water pea-soup green and can lead to fish
kills and other negative effects.
The stuff of life is continually recycled by biological and
physical processes. Each element follows its own unique pathway through
an ecosystem and is concentrated in specific abiotic reservoirs. Human
activities can strongly modify how natural chemical cycles work,
sometimes leading to the accumulation of wastes and environmental harm.
In the past, the science of ecology focused on nonhuman species. Rather than
studying cities or farms, ecologists have worked in “wild” places like forests,
mountain streams, coral reefs, and grasslands. Ecologists sought to unravel how
plants and animals in these places interacted with each other. The activities of
humans were viewed as a separate issue, outside the normal set of processes at work
in “natural” communities and ecosystems.
Today, however, ecologists recognize that humans have an influence on all
communities and ecosystems. In some ways, we are simply participants in and
members of ecosystems. Like other animals, we feed on the bodies of plants and
other animals; excrete gaseous, liquid, and solid wastes; and disturb small
areas of soil when we travel across the landscape on foot. In most of our
activities, however, humans have impacts that go far beyond those of other
animal species. What makes us different?
-
Population size. As we will discuss in this unit,
Earth’s total human population now exceeds 7 billion. Our total biomass is
far greater than that of all wild large animals (megafauna) combined, as is
the biomass of our domestic animals. We require huge volumes of food and
water simply to meet our most basic needs.
-
Affluence and consumption levels. Today, over a
billion humans live in high-income nations where most citizens enjoy a
standard of living that goes far beyond basic nutrition. Many of us live in
sturdy temperature-controlled buildings and have indoor plumbing, electric
lights, washing machines, refrigerators, electronic gadgets, and
automobiles. These items all require resources and generate wastes in their
production, use, and disposal.
-
High-impact technologies. Until about 1800, most human
activities were accomplished by the labor of humans and domestic animals.
Biodegradable materials were used. Impacts on ecosystems took a long time to
develop and much of the damage was repaired through natural processes.
Today, humans have harnessed outside energy sources (fossil fuels,
explosives, wind and flowing water, nuclear energy, and the like) to perform
work at an unprecedented scale. Humans now can rapidly transform landscapes
and intervene in basic natural processes. Advanced technologies have also
produced persistent (nonbiodegradable) chemical toxins and radioactive
wastes.
Each of the above factors promotes greater environmental impact if all other
factors are held equal. In real societies, however, all three factors change
over time and influence each other. This leads to some surprising patterns of
impact. For example, some environmental conditions are better in high-income
nations than in lower-income countries. In general, the air and water are
cleaner, industries are better-regulated, and forests are less heavily exploited
in higher-income nations. We can account for this in two ways. First, goods can
be consumed in one place but generate their impacts elsewhere. With global
trade, many of the impacts of consumption occur in developing nations where
goods are produced, dumped, or recycled. Second, more advanced technology is not
always more disruptive; technology can also be developed to reduce impact.
Examples of advanced low-impact technologies include renewable energy
technologies (solar panels, windmill generators), biodegradable plastics,
smokestack “scrubbers” that remove pollutants from power plant emissions, and
energy-efficient appliances and buildings.
Although there are many competing priorities, environmental concerns have become
more prominent in our society since the 1970s. Corporations have adopted
environmental goals as part of their mission statements. Nonprofit groups
advocate for the environment. Government programs promote specific environmental
goals. We use buzzwords like “sustainability” and “stewardship.” Products and
ideas are marketed as being “ecosafe,” “earth-friendly,” or “green.”
As a consumer, voter, employee, or business leader, you have some control over
environmental impact in your daily decisions. You should have a clear sense for
what sustainability really means. Sustainable technologies
meet human needs—economic and social—and preserve the productivity or
biodiversity of ecosystems over a long period of time. In any given case,
different options may maximize individual economic benefit, public welfare, or
environmental integrity. The most sustainable choice often involves finding a
compromise among these competing priorities.
One step toward sustainability is the careful use of renewable
resources: those that are replenished quickly enough to replace what we
consume. Resources are renewed through growth or other ongoing processes. Most
products of plants and animals are potentially renewable, so long as we do not
consume them too quickly. Many physical processes (solar energy input, river
flow, tidal flow, wind, flow of heat from Earth’s interior) also occur at a high
and sustained rate.Nonrenewable resources, by contrast, are replenished very
slowly. Such a resource can be thought of as a fixed stock. Once depleted, a
nonrenewable resource cannot be replaced in useful quantities. Most mineral
resources and fossil fuels are nonrenewable. Over time, if humans continue to
use these resources they will become increasingly scarce. A second factor in
sustainability involves the disposal or ultimate fate of materials and wastes we
produce. Biodegradable materials are more sustainable over
time because natural decomposition processes will break them down and recycle
any nutrients they contain. Nonbiodegradable materials tend to accumulate over
time and may cause negative environmental impacts. Some examples include
plastics and persistent toxic chemicals.
Renewable resources can be used in a sustainable way so long as the rate of use
does not exceed the rate of renewal. Nonrenewable resources cannot be used
indefinitely and technologies that rely heavily on them are unsustainable. In
the table below we summarize several examples of renewable and nonrenewable
resources.
| Renewable |
Nonrenewable |
| Foods produced from plants, animals, and other living organisms. Grains,
nuts, vegetable oils, fish, poultry, meat, dairy products, vegetables,
fruits, etc. |
Petrochemicals produced from oil and/or natural gas. Examples include
plastics, nylon, polyester, most pesticides, many food additives,
adhesives, solvents, and much more. |
| Fertilizers made from animal manure, animal byproducts, and composted
plant wastes. |
Artificial fertilizers made using natural gas, mined phosphate rock, and
mined potash (a source of potassium). |
| Construction and industrial materials from living plants, including
wood, paper, rayon cloth, plant-based plastics, natural rubber, bark
mulch, and medicinal compounds. |
Metal, cement, and glass, all of which are made using mined materials
and are usually produced with a high input of fossil fuel energy. |
| Fuels produced from plants or plant-derived by-products such as sawdust
or crop wastes. Power supplied by human labor or livestock. Electrical
energy produced from sunlight, tides, river flows, wind, and geothermal
heat. |
Fuels derived from coal, oil, or natural gas. Coal and natural gas are
used directly; oil is refined to create products like gasoline and jet
fuel along with many petrochemicals. |
Over time, human activities may have permanent negative effects on the
environment’s capacity to support life or provide resources to future
generations. Ultimately the degree and nature of our impact will depend on how
population size, affluence levels, and technologies change in the future. We
will explore these issues in more depth in this module. In the next page, we
will examine the history of the global human population, tracing some of the
factors that have enabled our dramatic expansion in numbers and in impact.
To grasp our collective impact as human beings, we must begin with some analysis
of our population’s size and technological reach. How many of us are there? How
did we get to our current abundance and affluence? What were some of the major
milestones along the way?
Based on fossil and genetic evidence, the first anatomically modern Homo sapiens arose in Africa about 200,000 years ago.
The history of humanity can be divided into three broad periods that represent
widely differing ways of life. We will call them the Stone Age, the Agricultural
Age, and the Industrial Age.
Stone Age. By 50,000 years ago, humans had developed many
features of Stone Age technology and culture. By 20,000 years ago, modern humans
had dispersed through much of the world. Stone Age humans obtained food by
fishing, hunting wild game, and gathering wild plant products. Food sources were
unreliable and most humans were nomadic, traveling widely to find food. Shelter,
clothing, and tools were made from stone, animal hides, and wood. Fire was used
as a source of heat and to modify the landscape for better hunting or travel.
Human labor was the main energy source.
Agricultural Age. This age started around 10,000 years ago.
It involved many (though not all) human cultures worldwide and extended through
the late 1700s. People began to domesticate plants and animals. Food supplies
became more reliable and abundant and diets expanded to include grains, poultry,
meat and dairy products from livestock, improved fruits and nuts, and more.
Agricultural Age humans stayed close to productive farms and pastures and built
the first permanent towns and cities. Humans began to extract and forge metal to
make durable tools, weapons, and ornaments. Energy sources expanded to include
labor from farm animals such as oxen and horses. Windmills and water mills were
also used as a source of power. Some cultures developed extensive water control
systems for irrigation of crops. Governments, organized religions, and written
languages flourished.
Industrial Age. The Industrial Age began in Europe in the
1700s and continues today. Agriculture continued to improve and cities continued
to grow. Global trade moved people and ideas around the world. Science helped to
spark new technologies. Machines harnessed external sources of energy to
accomplish all kinds of work. Fossil fuels became the main source of energy for
transportation, farm work, heating, cooling, manufacturing, mining, and other
activities. Scientific principles were applied to improve public health,
beginning with vast improvements to sanitation in cities. Sewage treatment, safe
municipal water supplies, public garbage disposal, and soap are all Industrial
Age innovations. Modern medical practices, including aseptic surgery,
antibiotics, and vaccinations, were developed. At the same time, the reliability
and quality of food supplies continued to improve.
Thus the world’s humans have gone through dramatic changes in their technologies
and living conditions. In the activity below, explore and learn more about how
rates of birth, death, and population growth changed as a result.
History of environmental impacts
Thus far, we have seen how human technology and population size have changed over
the past 200,000 years. How have humans impacted the environment over this time
span? Humans have had an impact on Earth’s ecosystems at every stage of our
history.
During the Stone Age, for example, human use of fire may have had a profound
effect on many ecosystems.By setting forest and grassland fires, humans favor
fire-adapted plant and animal species. Hunting may have depleted some food
resources and probably contributed to past animal extinctions as well.
During the Agricultural Age, humans cleared forests and created dams and
irrigation systems. These actions harmed many species and benefited others. In
some cases, resources like forests or fertile soils were depleted on a local or
regional scale, contributing to the collapse of human societies. Throughout this
history, however, human impacts on the environment were limited in their scope
and severity.
Starting with the Industrial Revolution, human impacts on the environment have
intensified. Many of them have become particularly extreme since about 1950.
Human activities generate impacts through three major mechanisms summarized
below.
-
Physical disturbance. Humans reshape the physical
structure of ecosystems by clearing forests, suppressing or setting fires,
building roads and cities, mining, maintaining croplands, and building water
control structures such as dams. This leads to biodiversity loss. It may
also increase our exposure to forest fires, floods, droughts, soil erosion,
landslides, and other physical hazards.
-
Resource depletion. Currently, the average citizen of
a developed nation consumes an average of 16 tons of minerals, ores, fossil
fuels, and biomass per year. Shortages may result if humans use resources at
an unsustainable rate. Wild plants and animals may be harvested to the point
of extinction. Degradation of soil can lead to crop failures. Minerals and
fossil fuels may be depleted to the point where their extraction becomes
increasingly expensive and disruptive.
-
Pollution. Humans release materials that harm
biodiversity or human health. Pollution may occur whenhumans greatly
increase the levels of naturally occurring materials in the air, water, or
soil. Other pollutants are novel synthetic chemical compounds, usually
derived from petrochemicals, that are toxic and persist in the
environment.
The scope of human actions and impacts is truly mind-boggling. The map below
illustrates our global impact using a “human footprint index” that summarizes
several different indicators.
 Humanity’s global environmental footprint. Areas least impacted by human
activities are shown in green and more heavily impacted regions are red, purple,
and black. This index is based on several different indicators of human presence
and activity: human population density, physical habitat disruption (built-up
areas, nighttime lights, land use/land cover), and accessibility (coastlines,
roads, railroads, navigable rivers).
By Center for International Earth
Science Information Network (CIESIN), Columbia University and Wildlife
Conservation Society, the Bronx Zoo, New York. By SEDAC (Human Footprint) Public Domain
Humanity’s global environmental footprint. Areas least impacted by human
activities are shown in green and more heavily impacted regions are red, purple,
and black. This index is based on several different indicators of human presence
and activity: human population density, physical habitat disruption (built-up
areas, nighttime lights, land use/land cover), and accessibility (coastlines,
roads, railroads, navigable rivers).
By Center for International Earth
Science Information Network (CIESIN), Columbia University and Wildlife
Conservation Society, the Bronx Zoo, New York. By SEDAC (Human Footprint) Public Domain
We humans are incredibly ingenious as individuals. But as part of an organized
culture that has accumulated knowledge since the Stone Age, our power is far
greater. Consider a gadget like a laptop computer. No one human really knows how
to make a laptop, and certainly no individual could manufacture one from scratch
working alone. Instead, thousands of individuals must contribute specialized
knowledge to make the parts and assemble them in a working unit. Making a laptop
also depends on extraction of metals and oil from deposits around the world, and
requires heavy inputs of fossil energy. Similar feats of cooperation and
innovation allow us to make airplanes, smart phones, heart monitors, reliable
automobiles, and thousands of other useful objects. Unfortunately, we also have
the power to do great damage to the environment and its ability to sustain life.
We simplify and reshape ecosystems. We overuse resources so that they become
scarce and costly. We make atomic weapons and synthesize chemicals that are both
persistent and toxic. We overload natural geochemical cycles, leading to the
accumulation of wastes. These and other impacts will be described further in
this module.
Next we will focus on one particular aspect of human impact that is very relevant
to the field of biology: how humans have changed biodiversity on a global
scale.
From earliest childhood, humans are fascinated by the diversity of life. Tourists flock
to African savannas, coral reefs, and tropical rain forests, cameras at the ready. Kids’
picture books are populated with bright, beautiful, and bizarre animal drawings.
Television nature programs, zoos, botanical gardens, and natural history museums provide
an up-close look at the real thing. At some level each of us feels interested in,
inspired by, or connected to nature in some form. And we are saddened to learn that much
of this diversity is threatened by human activity. What is at stake? What has been lost?
What can we do to protect what’s left?
What is biodiversity and Why Does it Matter?
Biodiversity is simply the diversity of life in an area. As seen in the photo
below, it can be measured at a number of different levels.
- Genetic diversity is the inherited variation among individuals within a
single species or population. It provides the raw material for
evolution.
- Species richness is the number of different species within a community.
- Ecosystem diversity is the variety of distinct ecosystem types (habitats)
within a region. In some places a wide array of habitats can form a diverse
patchwork of life.
 This scene in Romania illustrates diversity at several different
levels. Within one species of flower there is genetic diversity. Within the
meadow community there is a rich blend of species. At the landscape level
there is a patchwork of distinct ecosystem types (grassland and forest).
Many central European meadows have very high plant species diversityand are
maintained by grazing and/or mowing. By Joadl (Botzia) CC-BY-SA-3.0
This scene in Romania illustrates diversity at several different
levels. Within one species of flower there is genetic diversity. Within the
meadow community there is a rich blend of species. At the landscape level
there is a patchwork of distinct ecosystem types (grassland and forest).
Many central European meadows have very high plant species diversityand are
maintained by grazing and/or mowing. By Joadl (Botzia) CC-BY-SA-3.0
Earth is home to a diverse and vibrant riot of life. Over the past 400 years,
biologists have discovered, described, and named over 1.3 million species of
animals, plants, fungi, protists, and prokaryotes. Millions more exist but have
not yet been described.
Biodiversity is of great value to humans. Functioning natural ecosystems supply
us with countless benefits, many of which we take for granted. When was the last
time you paid—or even expressed thanks—for oxygen? Some of the most important
benefits provided by ecosystems and by specific wild species within them
include:
- Removal of excess nutrients, pathogens, and organic waste from sewage.
- Addition of oxygen and removal of carbon dioxide from the atmosphere.
- Physical protection of soils, unstable slopes, and coastlines by plants.
- Pollination of crops by wild animals including insects.
- Recreational opportunities for wildlife viewing, hunting, angling, and more.
- Products like lumber, fish, shellfish, fruits, mushrooms, latex for rubber, etc.
- Specific biochemicals that can be developed to produce pharmaceuticals and other valuable new products.
Threats to Biodiversity
As a whole, biodiversity may seem limitless. But when we look at specific
communities and species, we can see evidence to the contrary. Biodiversity is
reduced when populations are eliminated from local communities (local
extinction). Local extinctions can severely disrupt ecological communities and
may even lead to additional extinctions. This is particularly likely if keystone
species are lost, as you learned in the community ecology module. Over time,
local extinctions can lead to the loss of an entire species when the last
reproducing group dies out (global extinction). Global extinction is
irreversible: When a species goes extinct, we lose all future opportunities to
learn from it, use it, and appreciate it.
Human activities have affected biodiversity for thousands of years. In fact,
human hunting is one probable cause for the extinction of many large animal
species that ended about 10,000 years ago. We may never know for sure if humans
caused the demise of the woolly mammoth or the saber-toothed tiger, but we can
be quite sure that our activities severely threaten many species today. Tracking
and clarifying this problem is a major challenge for ecologists. Below is a
diagram showing how many species are threatened (or already extinct) among some
well-studied groups of plants and animals.
 Numbers of species in various status categories in 2010. Of the groups
assessed, amphibians had the highest number of species that are threatened
to some degree. High fractions of threatened species were found among
tropical reef-building corals and among cycads, a group of tropical trees.
Source: Global Biodiversity Outlook 3.0, Convention on Biological Diversity.
Data from assessments by the International Union for the Conservation of
Nature, a global coalition of scientists and nonprofit organizations. By
Convention on Biological Diversity (CBD). (Figure 4) Public Domain
Numbers of species in various status categories in 2010. Of the groups
assessed, amphibians had the highest number of species that are threatened
to some degree. High fractions of threatened species were found among
tropical reef-building corals and among cycads, a group of tropical trees.
Source: Global Biodiversity Outlook 3.0, Convention on Biological Diversity.
Data from assessments by the International Union for the Conservation of
Nature, a global coalition of scientists and nonprofit organizations. By
Convention on Biological Diversity (CBD). (Figure 4) Public Domain
Extinction is a naturally occurring process; thousands of species known only from
fossils attest to that fact. However, current rates of endangerment and
extinction are much faster than those estimated from a study of the fossil
record. Today, the vast majority of extinctions can be clearly attributed to the
environmental impacts generated by human activities. The major causes of
extinction can be categorized as follows:
-
Habitat loss. Human activities destroy or change
habitat so that it no longer supports the growth and reproduction of a
species. This is widely acknowledged as the most important direct threat to
biodiversity worldwide. Habitats that have been profoundly changed by human
activities include forests (clearing), grasslands (plowing and overgrazing),
rivers (damming), and wetlands (draining).
-
Introduced species. Humans move species out of their
natural range and into a new area. The new species prey upon, compete with,
change habitat for, or otherwise harm native species, resulting in their
extinction. This is a particularly important threat on islands and other
isolated habitats, where introduced predators may decimate native prey
species that are not adapted to their presence.
-
Overharvesting. Human harvesting—hunting, fishing,
logging, gathering, and so on—removes individuals more quickly than they can
be replaced by natural reproduction. This was historically a major threat in
North America and Europe, but today most fish and wildlife resources are
fairly well-protected. Open ocean fisheries and tropical mammals, by
contrast, are heavily impacted by human harvesting today. For example, an
estimated 80% of the world’s major ocean fisheries were fully exploited,
overexploited, depleted, or recovering from depletion in 2005.
-
Pollution. Wastes generated by human activities change
habitat conditions or threaten the health of organisms directly. Nutrient
pollution, for example, is a global problem that harms the diversity of
aquatic and some terrestrial communities. Pollution of the atmosphere by
greenhouse gases generates climate change, a problem so complex and severe
that it is often counted as a separate threat category.
In summary, species and communities worldwide face many threats. Very often, a single
species will be affected by multiple factors. In most cases, humans do not set out to
deliberately eradicate species. Instead, we cause extinction inadvertently when our
actions generate unexpected consequences.
In the past, humans were often unaware of the effects of their actions or did not try to
change course until it was too late. Today, with advances in technology and ecological
science, we can do much better. We have begun to effectively regulate or prohibit
harvesting, reduce some forms of pollution, protect remaining habitats, and control
introduced species. As a result, the status of many populations in high-income nations
or in priority areas is improving. In the United States, several species, including the
American beaver, the American bison, and the gray wolf, have been protected from
overharvesting and have recovered and returned to much of their former range. The bald
eagle and peregrine falcon were nearly driven extinct by the pesticide DDT and related
compounds that entered food chains, concentrated in the birds, and impaired their
introduction. Both species have recovered strongly since DDT was banned for use in the
U.S. in 1972. As seen in the graph below, these and similar cases have led to an overall
increase in many vertebrate animal populations within high-income nations in North
America, Europe, Australia, and Japan since 1970.
 The Living Planet Index is based on population sizes of vertebrate species that
are monitored over time. Values represent the change in average population sizes
over time. Positive values indicate that populations have increased; negative values
indicate population declines relative to the 1970 baseline. Since 1970, the Living
Planet Index shows slight progress in high-income nations and biodiversity declines
elsewhere. By Living Planet Report 2012. By WWF (Living reports) Public Domain
The Living Planet Index is based on population sizes of vertebrate species that
are monitored over time. Values represent the change in average population sizes
over time. Positive values indicate that populations have increased; negative values
indicate population declines relative to the 1970 baseline. Since 1970, the Living
Planet Index shows slight progress in high-income nations and biodiversity declines
elsewhere. By Living Planet Report 2012. By WWF (Living reports) Public Domain
Much of the world’s remaining biodiversity is in the tropics within low- and
moderate-income nations. Here, the biodiversity situation remains much more troubling.
Resources for conservation efforts are limited and high rates of human population growth
continue to drive habitat destruction and overharvesting in many of these nations.
Poaching (illegal hunting), forest destruction, poorly regulated mining, overfishing,
and destructive farming and livestock grazing practices are all contributing to
biodiversity decline that threatens thousands of unique and irreplaceable species. On
the positive side, conservationists are working very hard to protect wild habitats
within “biodiversity hotspots” that harbor a large diversity of species. Nongovernmental
organizations from high-income nations are spearheading these efforts. Through
investments and education, they are working with communities to develop sustainable
businesses that provide income while protecting the integrity of local ecosystems.
To Learn More / References:
Global Biodiversity Outlook 3.0
Living Planet Report 2012
In this page we will focus on human effects on the atmosphere and climate as a chief
example of our ecosystem-level impacts. You have probably heard and learned about global
warming and global climate change. Through this course we aim to help you improve your
knowledge about the science behind this issue and clear up any misconceptions you may
have about it.
A continuing increase in Earth’s ocean and land surface temperatures since the early
1900s is known as global warming. The phrase “global warming” may leave the false
impression that the Earth simply gets a bit cozier over time as this process continues.
Earth’s climate is a complex system. As the climate warms, temperatures are not evenly
adjusted upward by a fixed number of degrees across seasons and locations. Instead, we
are also seeing many dramatic weather anomalies in recent decades, including strong
hurricanes and tornadoes, protracted droughts, unusually severe heat waves, and even
record snowfalls. Instead of global warming, some like to say we are experiencing
“global weirding.” Anthropogenic global climate
change is a more appropriate description of how climate is responding to human
activities on a global scale. It is the full range of climatic disruptions that have
occurred as a probable result of human alteration of the atmosphere. In other words, it
is recent climate warming—and weirdness—that is probably caused by humans. The case for
global climate change can be summarized as follows:
-
Greenhouse gases are known to slow the escape of heat from Earth, and in this way
they warm the climate through a mechanism called the greenhouse effect.
- Humans have dramatically increased levels of greenhouse gases in the
atmosphere.
- The climate has warmed in parallel with and as a result of these changes in the
atmosphere.
Let’s look at some of this theory and evidence, beginning by thinking about how the
Earth’s overall temperature is determined.
Earth’s Energy Budget and the Greenhouse Effect
Energy enters the Earth system—its land, water, and air—as sunlight. Some of the
light is reflected back into space, but much of it is absorbed by land and
water. When materials absorb light, they warm up. Over time, they release energy
as heat, also known as infrared radiation. Eventually, all of the energy that
entered as sunlight escapes back into space as infrared radiation. Energy that
enters the Earth system as light is balanced by energy that exits as heat.
If the Earth had no atmosphere, heat would escape very rapidly. The Earth’s
night-time surface temperatures would be like those on the moon: −153° Celsius,
−243° Fahrenheit. Below is a diagram showing what Earth’s energy balance might
look like if there were no clouds to reflect light and no gases that could
interfere with heat’s escape.
 Hypothetical energy budget for Earth with no clouds (which reflect 20%
of incoming solar radiation) and with no greenhouse gases in the atmosphere.
Heat radiation would not be delayed on its trip to space, and Earth’s
surface would have low and very quickly changing temperatures. By NASA.
Public
Domain
Hypothetical energy budget for Earth with no clouds (which reflect 20%
of incoming solar radiation) and with no greenhouse gases in the atmosphere.
Heat radiation would not be delayed on its trip to space, and Earth’s
surface would have low and very quickly changing temperatures. By NASA.
Public
Domain
Lucky for us, Earth has an atmosphere comprising gases that make our atmosphere
act something like an insulating blanket. The atmosphere is a mixture of many
different gases that are held close to Earth’s surface by gravity. The two most
abundant gases in the atmosphere are N2,or nitrogen gas (78% of air
by volume), and O2, or oxygen gas (21%). These gases are transparent
to light and to heat radiation; that is, they do not interfere with sunlight
energy coming into Earth or with the heat radiating back into space. Several
much less abundant gases, however, do have a major effect on Earth’s energy
budget. These greenhouse gases absorb and reemit heat
waves (infrared radiation). Three important greenhouse gases are water vapor
(H2O), carbon dioxide (CO2), and methane
(CH4). Much of the heat (infrared) radiation that leaves Earth’s
surface is absorbed by greenhouse gases and reemitted back toward Earth. As a
result, these gases retain heat in the atmosphere. Instead of escaping
immediately to space, heat is delayed near the Earth’s surface and continues to
warm our atmosphere.
 Energy budget for Earth with its current atmosphere. Much of the
incoming sunlight is reflected by Earth’s surface (about 10%) and clouds
(about 20%). The rest of the energy (70%) is absorbed by materials in the
air, land, and water and is then reemitted as heat. Only a small fraction of
the emitted heat (about 12% of the total incoming sunlight energy) escapes
directly. The rest is absorbed by greenhouse gases in the atmosphere and
reemitted. This energy remains close to the Earth’s surface for a longer
period of time, thereby maintaining a warmer and more stable climate. Data
derived from two publications in 2009 summarizing 10 years’ worth of data
and presented by NASA. Public
Domain
Energy budget for Earth with its current atmosphere. Much of the
incoming sunlight is reflected by Earth’s surface (about 10%) and clouds
(about 20%). The rest of the energy (70%) is absorbed by materials in the
air, land, and water and is then reemitted as heat. Only a small fraction of
the emitted heat (about 12% of the total incoming sunlight energy) escapes
directly. The rest is absorbed by greenhouse gases in the atmosphere and
reemitted. This energy remains close to the Earth’s surface for a longer
period of time, thereby maintaining a warmer and more stable climate. Data
derived from two publications in 2009 summarizing 10 years’ worth of data
and presented by NASA. Public
Domain
As you just learned, greenhouse gases in the Earth’s atmosphere retain heat and
keep surface temperatures warm and relatively steady over time. This phenomenon
is called the greenhouse effect. It is a natural part of
the Earth’s climate system and helps make our planet livable. Currently,
however, the greenhouse effect is strengthened by a high and increasing level of
greenhouse gases in the atmosphere. Evidence indicates that human activity is
responsible for this increase.
Human activities have increased levels of greenhouse gases in the atmosphere.
In terms of its total effect on climate, the most significant greenhouse gas is
carbon dioxide. As of May 2012, the concentration of carbon dioxide in the
atmosphere is about 397 ppm (parts per million). How does this compare to past
levels?
- Today’s level is 26% higher than the level in 1958; levels have been
increasing steadily since that time based on monthly measurements that have
been taken at Mauna Loa observatory in Hawaii and at many other locations
worldwide.
 Increase in carbon dioxide at Mauna Loa Observatory in Hawaii since
from 1958 to June 2012. By Dr. Pieter Tans, NOAA/ESRL Full Mauna Loa CO2
record Public Domain.
Increase in carbon dioxide at Mauna Loa Observatory in Hawaii since
from 1958 to June 2012. By Dr. Pieter Tans, NOAA/ESRL Full Mauna Loa CO2
record Public Domain.
- The current level is almost twice as high as the long term average over the
past several hundred thousand years. These data come from analysis of
bubbles of air trapped in ice. Glacial ice has annual layers and can be
dated, allowing researchers to look back in time as they drill deeper into
the ice. The longest records now come from ice cores extending over 3 km
deep into an Antarctic glacier. Throughout the 800,000-year period of
record, CO2 levels never exceeded 300 ppm and were typically
around 220 ppm.
 The graph above shows carbon dioxide data from an ice core extending
400,000 years into the past; more recent data double that time span but show
a similar pattern. Carbon dioxide has fluctuated between about 170 ppm and
300 ppm; at no point did it approach the current level of nearly 400 ppm. By
NOAA evidence CO2
Public Domain
The graph above shows carbon dioxide data from an ice core extending
400,000 years into the past; more recent data double that time span but show
a similar pattern. Carbon dioxide has fluctuated between about 170 ppm and
300 ppm; at no point did it approach the current level of nearly 400 ppm. By
NOAA evidence CO2
Public Domain
The situation is similar for other greenhouse gases including methane and nitrous
oxide, each of which has increased dramatically since about 1900.
 Levels of three important greenhouse gases have all increased greatly
starting at around 1900. Values are in parts per million (ppm) or parts per
billion (ppb) which indicates the number of molecules of each gas in a
million or billion molecules of mixed air. By U.S. Global Change Research
Program. (Greenhouse Gases) Public Domain
Levels of three important greenhouse gases have all increased greatly
starting at around 1900. Values are in parts per million (ppm) or parts per
billion (ppb) which indicates the number of molecules of each gas in a
million or billion molecules of mixed air. By U.S. Global Change Research
Program. (Greenhouse Gases) Public Domain
Clearly, greenhouse gases are increasing. And you already know that human
population and impact have increased greatly through the Industrial Age, so it
is natural to suspect that human activities are the cause of recent changes in
atmospheric gases. Many lines of evidence confirm this. Specific human
activities and practices are known to emit greenhouse gases and are also known
to have increased in step with rising greenhouse gas concentrations.
-
CO2:
burning of fossil fuels, deforestation. Burning of coal, oil, and
natural gas transfers carbon from long-term storage in the Earth’s crust and
adds CO2 directly to the air. Deforestation reduces the overall
rate of photosynthesis and plant growth. It also returns carbon stored in
wood and soil to the atmosphere when wood is burned or when soils are warmed
up, encouraging decomposition.
-
Methane (CH4): fossil fuel production and transport, rice paddy
agriculture, ruminant livestock, landfilling of garbage, sewage
treatment. Methane-releasing decomposers (prokaryotes in the domain
Archaea) thrive under wet, low-oxygen conditions. Humans create methane
emissions by favoring the activity of these decomposers. Ruminant
livestock—cattle, goats, and so on—have this type of prokaryotes in their
stomachs and release methane as flatulence. Methane is also emitted when
natural gas escapes from wells or pipelines. In the future climate change
itself may also lead to big methane releases due to melting of permafrost
and other releases from long-term storage.
-
Nitrous oxide (N2O): agriculture, exhaust from internal combustion engines.
Humans add extra nitrous oxide (N2O) to the air through use
of artificial fertilizers and other agricultural practices. Nitrous oxide is
also produced when fuels or biomass are burned; high temperatures encourage
a reaction between N2 and O2 gases in the air.
Therefore the exhaust from internal combustion engines is a source of
nitrous oxide.
Many ongoing natural processes also influence levels of greenhouse gases, but
these processes have not changed in a way that can account for the extra
CO2 in the air. Typically natural processes cancel each other
out; they are part of cycle that is more or less in balance. Human activities,
by contrast, have a history of rapid increase that tracks very closely with the
observed increase in the air’s greenhouse gas levels over the past century.
 Global human carbon dioxide emissions from burning fossil fuels and
from cement production. Direct emissions have increased rapidly since 1950
in step with increases in atmospheric carbon dioxide. Graph by Mak Thorpe
using data from the Carbon Dioxide Information Analysis Center. By Mak
Thorpe. (Global Carbon Emissions) CC-BY-SA
Global human carbon dioxide emissions from burning fossil fuels and
from cement production. Direct emissions have increased rapidly since 1950
in step with increases in atmospheric carbon dioxide. Graph by Mak Thorpe
using data from the Carbon Dioxide Information Analysis Center. By Mak
Thorpe. (Global Carbon Emissions) CC-BY-SA
The Climate has warmed in association with increased greenhouse gas
levels.
As previously discussed, greenhouse gases absorb and reemit heat. There is a
clear theoretical basis for the idea that increases in greenhouse gas levels
should warm the climate. There is also an abundance of direct evidence that
climate has warmed in association with higher concentrations of greenhouse gases
over time. Coinciding with the observed increase in greenhouse gases, scientists
have documented substantial increases in the average temperatures of Earth’s air
and oceans, particularly since about 1950.
 Carbon dioxide and temperature in the Industrial Age. As
greenhouse gas concentrations have increased (shown here: carbon dioxide,
the most important greenhouse gas), average global temperature levels have
also risen. By U.S. Global Change Research Program Global Climate Change 4 Public Domain
Carbon dioxide and temperature in the Industrial Age. As
greenhouse gas concentrations have increased (shown here: carbon dioxide,
the most important greenhouse gas), average global temperature levels have
also risen. By U.S. Global Change Research Program Global Climate Change 4 Public Domain
Many other ongoing natural processes have an influence on the climate. Why do
scientists think greenhouse gas increases are the factor driving the recent
warming? Again, natural processes have not changed in a way that can explain the
observed warming of the climate. For example, the sun’s energy output changes
over time, and this can influence our climate. But these changes cannot account
for recent global warming. In fact, the sun’s energy output was considerably
lower than normal from 2005 to 2010, but the climate continued to warm over that
period.
Taken together, thousands of observations and trends provide evidence for global
climate change and indicate some of its consequences for life on planet Earth.
The following are a few of the many strong indicators of change:
Warm weather and ocean temperatures. In a record of weather
and ocean temperature data stretching back to 1900, the top five warmest years
were 2005, 2010, 1998, 2003, and 2002. Studies based on weather stations and
ocean temperature measurements around the world have repeatedly found a trend of
increasing temperatures since about 1900 with steep increases since around 1970.
The data for land weather stations are summarized in the graph below. As average
temperatures have increased, so has the frequency of extreme heat waves. These
are particularly dangerous in low-income nations like India, where people lack
air conditioning.
 Average temperatures from long term weather records since 1800 show an
increasing trend, particularly since the 1970s. In this graph, data from a
number of different studies are compared. The black line (labeled
“Berkeley”) is based on 1.6 billion records from 39,000 different weather
stations and 16 different data archives. The study was led by a “climate
skeptic” who processed the data to correct for biases and errors he had
thought were leading to false conclusions in other analyses. Yet the results
paralleled those of other studies by NASA, NOAA, HadCRU, indicating an
increase of about 0.9° Celsius since the 1950s. By Berkeley Earth Surface
Temperature project. Temperature
graph Public Domain
Average temperatures from long term weather records since 1800 show an
increasing trend, particularly since the 1970s. In this graph, data from a
number of different studies are compared. The black line (labeled
“Berkeley”) is based on 1.6 billion records from 39,000 different weather
stations and 16 different data archives. The study was led by a “climate
skeptic” who processed the data to correct for biases and errors he had
thought were leading to false conclusions in other analyses. Yet the results
paralleled those of other studies by NASA, NOAA, HadCRU, indicating an
increase of about 0.9° Celsius since the 1950s. By Berkeley Earth Surface
Temperature project. Temperature
graph Public Domain
Sea level rise. The average sea level has increased by an
estimated 0.2 m since 1900, both because the ocean water is expanding as it
warms and because glaciers on land are melting. Sea level rise is expected to
continue and accelerate with continued warming of the climate. Particularly when
coupled with more intense storms, increasing sea levels threaten human
settlements and natural ecosystems in low-lying coastal areas worldwide.
Ice and permafrost melting. The extent and thickness of
floating sea ice in the Arctic has declined in recent decades. Based on
satellite data, the area covered by thick multiyear ice decreased by about half
between 1980 and 2012. A majority of mountain glaciers are also shrinking in
thickness and area over time. Perpetually frozen soils (permafrost) have been
melting to increasing depths each summer in the Arctic. Such changes have many
implications. Sea ice is important to the ecology of polar bears and other
arctic animals; it acts as a platform for travel and foraging. Mountain glaciers
supply summer melt water to major river systems in Asia and elsewhere; glacier
retreat may reduce the reliability of water supplies for irrigation and other
uses. And melting of permafrost leads to landslides and releases additional
greenhouse gases to the atmosphere.
 A comparison showing how Pederson Glacier in Alaska has retreated since
1920; land and vegetation have also filled in what was previously a lagoon
habitat. By NOAA Pederson Glacier Public domain
A comparison showing how Pederson Glacier in Alaska has retreated since
1920; land and vegetation have also filled in what was previously a lagoon
habitat. By NOAA Pederson Glacier Public domain
Increased intensity or duration of drought. Climate change
is likely to reduce rainfall in some regions. Even if rainfall does not decline,
warmer temperatures lead directly to drier soils and lower water levels by
speeding up evaporation and boosting the rate at which plants use water.
Record-breaking droughts and wildfire seasons are some indicators that this
effect is already under way in some regions. Droughts threaten human well-being
by limiting crop production and by reducing the availability of water for
municipal use, navigation, power generation, and recreation.
Changes in species distributions. Many species’ geographic
ranges are shifting, following climate conditions toward historically cooler
areas as their existing habitats get warmer. Species are shifting toward the
poles: further north in the Northern Hemisphere and further south in the
Southern Hemisphere. In mountainous regions, species’ distributions are shifting
upward to higher elevations. Range shifts may lead to endangerment of species,
loss of species that provide economic resources, and northward spread of
tropical pathogens and their vectors (particularly mosquitoes).
Changes in seasonal patterns of life. As the climate warms,
springtime events—leaf emergence and flowering, nesting and migration of birds,
etc.—are occurring at earlier dates than in the past. A 2003 study reviewed data
from studies on 172 different species of plants, birds, butterflies, and
amphibians and found that springtime events had shifted toward earlier dates by
an average of 2.3 days per ten years; most of the studies extended over a period
of about 50 years. Such shifts can disrupt community interactions, particularly
since some species respond more quickly than others to changes in climate.
Studies have found that some birds arrive at summer breeding grounds only to
find that their prey (insects) have already completed their life cycles.
Similarly, some butterfly species are in trouble because their food plants are
developing tough leaves and beginning to wither earlier in the season, before
the caterpillars have hatched. To learn more about how butterflies are
responding to climate changes view the video in the “Changing Planet” series by
NBC Learn on “ The Adaption of Butterflies .”
We began this module by considering how three factors have changed over time: human
population size, affluence or material consumption, and human use of high-impact
technologies. Next we examined how these factors have led, through various mechanisms,
to effects on biodiversity and climate. But what does all this say about the future?
Here we will conclude by looking at how population, affluence, and technology may
change, and how these changes are likely to affect humanity’s impact on the global
environment.
Future global populations
Based on our graph showing how population has exploded during the Industrial Age,
you may assume that it will continue to increase dramatically with no end in
sight. Recall that world population began to grow rapidly in the 1800s. At this
time death rates began to fall rapidly with advances in public health worldwide.
Some of the most important factors were improved sanitation, basic medical care,
and nutrition; later the trend was reinforced by immunization and the use of
antibiotics. This health-driven reduction in death rates started in western
Europe, North America, and other industrialized nations. Today, all nations have
benefited to some degree from these trends; total longevity is increasing
worldwide and rates of infant and child mortality continue to fall. Death rates
are low and headed lower. Does this mean populations are growing equally fast
everywhere?
Fertility (which corresponds to the birth rate) is the main factor that
determines modern and future rates of population growth. Since about 1900, birth
rates have declined in industrialized, high-income nations. Why? Education and
economic opportunity for women, access to contraception, and changing economic
pressures have all contributed to reduced fertility in these countries. With low
rates of death and birth, populations are stable or even declining in many of
the world’s most affluent nations. In less developed low- and middle-income
nations, fertility rates are still high enough to generate rapid population
growth. In addition, these countries have populations with many young people
just now entering reproductive age. Therefore the populations of these nations
will continue to grow rapidly for years into the future.
Overall, the global population will continue to increase for at least a few
decades, and this increase will be driven mainly by growth in the low- and
middle-income nations of Africa and Asia. Experts predict that fertility will
continue to fall in most nations as they develop economically, as contraception
becomes more available, and as educational and economic opportunities for women
improve. If so, the world population is projected to peak at around 9 to 11
billion in 2050 and begin to decline thereafter.
Future changes in affluence and technology
As their populations continue to expand, trends and projections indicate that
low- and middle-income nations will also continue to increase in their
affluence. Automobiles, electronic gadgets, and household conveniences like air
conditioning and indoor plumbing are likely to reach more and more people in
populous and fast-growing economies like those of Brazil, India, and China. What
does this mean for the global environment? By 2050, projections suggest that the
world’s humans may use a total of 140 billion tons of minerals, ores, fossil
fuels, and biomass per year—three times the current consumption rate (United
Nations Environmental Programme, International Resource Panel, 2011). Will Earth
be able to sustain these high levels of consumption spread across a population
of 9 to 11 billion people? Much will depend on the next factor, technology.
After high standards of living have been achieved, societies have tended to shift
toward use of lower-impact and greener technologies. Take, for example, the use
of fossil fuels. Within the United States and Europe several trends such as
greater efficiency and a shift toward renewable and nuclear power have led to
reduced emissions of carbon dioxide per dollar of goods and services
generated.
Carbon dioxide emissions per dollar of
national economic activity in China, the United States, and France in 2009. For
each unit of economic activity, China generated four times as much carbon
dioxide than did France.
| China: 0.81 kg CO2 / $ GDP |
U.S.A.: 0.41 kg CO2 / $ GDP |
France: 0.18 kg CO2 / $ GDP |
| Heavy reliance on coal, older and less efficient industrial and consumer
technology |
Continued primary reliance on fossil fuels, newer and more efficient
technology |
Strong shift toward nuclear power, more energy-efficient technology |
Several important low-impact technologies are currently in various stages of
development. Some examples include renewable electric power (mainly solar and
wind power), use of plant and algal biomass as a source of renewable fuel, and
improvements in the sustainability of appliances and buildings. In many
industries, improvements are occurring gradually through better management
practices that reduce waste output, reduce energy and resource use, and reduce
harm to the environment. These efforts are often supported by certification
systems and ecolabels that help consumers choose lower-impact products. Examples
include the Forest Stewardship Council for sustainable forest products, the
Marine Stewardship Council for sustainable seafood, LEED certification for
sustainable buildings, and the U.S. EPA Energy Star and Water Sense labels for
energy- and water-efficient appliances.
If these trends continue and spread globally, humanity may be able to limit some
of its future environmental impacts through technological progress. However, new
and more sustainable green technologies are not guaranteed to succeed. They are
usually developed first in industrialized nations and their use may be limited
by cost. Ultimately, green technologies will reduce our collective environmental
impact only if they are widely used. To have a large effect, they must be
adopted widely in industrialized nations and then quickly transferred to the
fast-growing and populous nations of Asia and Africa. Major public and private
investments may be needed to meet this goal.
The challenge of global climate change
Climate change is the most troubling environmental impact of humanity because of
the global and potentially severe nature of its effects. How can humans tackle
such a big and complex problem? Efforts to deal with global climate change can
be placed in two broad categories: mitigation and adaptation.
Climate change mitigation is the
effort to reduce emissions of greenhouse gases or increase the rate at which
they are removed from the air, thereby slowing the pace and reducing the
severity of climate change. Some of the actions that could be taken to
accomplish this include energy conservation, widespread adoption of renewable
energy technologies, increased use of nuclear power, switching from coal to
natural gas, and capture and storage of CO2 from coal-burning power
plants. We can also work to increase the extent and growth of carbon-absorbing
forests. Changes to agriculture and waste disposal practices could help reduce
emissions of methane and nitrous oxides. At a fundamental level, efforts to slow
population growth may mitigate climate change simply by reducing population
growth, which is a key underlying factor driving all human impacts on the
environment.
Changes to mitigate climate change can be costly. Deciding whether to make such
changes requires detailed scientific analysis. How much will a given action help
to reduce climate change? What other costs and benefits will be generated?
Unfortunately, there is a limit to what we can reasonably expect to achieve with
mitigation. Some degree of climate warming has already occurred. Experts agree
that even with our best efforts to mitigate growth in greenhouse gas emissions,
these gases will continue to build up in the atmosphere and will continue to
modify climate for many decades.
Climate change adaptation is the effort to make humans and
ecosystems less vulnerable to the effects of ongoing and future climate change.
To reduce the consequences of climate change, we can develop crops that are
better adapted to a warmer and drier world; improve irrigation systems to
compensate for expected droughts; protect coasts from rising sea levels with sea
walls or with buffer zones of natural vegetation; improve emergency response
systems and preparedness; and deliberately move people, plants, and other
species to areas where the climate is likely to be more tolerable in the future.
Scientific assessments help to predict future changes and test the effectiveness
of adaptation strategies.
Use this table as a quick reference for the major elements.
| Atomic Properties of the major biological atoms |
|---|
| Atom |
Mass |
Covalent Bonds |
Electronegativity |
| H |
1 |
1 |
2.20 |
| C |
12 |
4 |
2.55 |
| N |
14 |
3 or 4 (e.g. NH4+) |
3.04 |
| O |
16 |
2 |
3.44 |
| P |
31 |
5 |
2.10 |
| S |
32 |
2 |
2.58 |
|
The following is a list of the key terms discussed in this Introduction to
Biology course and their meaning.
- A -
- Abiotic
-
(Definition)
An adjective that describes nonliving materials in the environment,
such as sunlight, rain, gases in the air, rocks, and chemicals in
the soil.
- Acids
-
(Definition)
substances that when dissolved in water form an excess of hydronium
ions (H3O+). Acids are hydrogen ion/proton (H+) donors. Acids taste
sour. Many foods and beverages are acidic, including citrus fruit
and tomato juice.
- Activation Energy
-
(Definition)
The amount of energy required by a chemical reaction in order for the
reaction to occur. All chemical reactions require some amount of
activation energy.
- Active Site
-
(Definition)
The part of an enzyme to which a substrate binds.
- Adenosine Triphosphate (ATP)
-
(Definition)
Adenosine triphosphate (ATP) is a nucleotide. It consists of a single
adenosine (the base adenine and the sugar ribose), linked to three
phosphate ions. It acts as a general energy source for most cellular
activities. It is however a relatively unstable molecule;
consequently, it is never used for the long-term storage of energy
in the cell. ATP is specialized for direct and rapid transfers of
energy.
- Adhesion
-
(Definition)
The attraction of water molecules to molecules other than water.
Capillary action (in which water will spontaneously climb up the
walls of a tube without pumping) is a result of the adhesion of
water molecules with the surface of a tube containing the water.
- Allele
-
(Definition)
An alternative form of a gene. An example would be genes that encode
eye color - some encode blue eyes (one allele), while others encode
brown, green or hazel eye colors (other alleles).
- Allopatric Speciation
-
(Definition)
The formation of a new species through the geographical isolation of
a portion of a population from the population as a whole.
- Amino Acids
-
(Definition)
A small organic molecule with the structure of an amino group, a
carboxylic acid group, and an “R” group, which are all bonded to a
single central carbon atom. The difference between the “R” group is
what distinguishes one amino acid from another. Amino acids are the
building blocks of proteins.
- Amino Acids, Aromatic
-
(Definition)
An amino acid with a side chain that contains a ring structure with
conjugated double bonds. Conjugated double bonds refer to the
alternating arrangement of bonds in a molecule: double-single-double
bond. The benzene ring is the best known example of an aromatic
group. Two amino acids, phenylalanine and tyrosine, contain the
benzene ring. Aromatic rings can include atoms other than
carbon.
- Amino Acids with Acidic Side Chains
-
(Definition)
Amino acids with acidic side chains contain a carboxyl group on the
side chain. At physiological pH, acidic groups lose protons (acting
as an acid) and become negatively charged.
- Amino Acids with Basic Side Chains
-
(Definition)
Amino acids with basic side chains contain basic nitrogen-containing
groups. At physiological pH, basic groups gain a proton (acting as a
base) and become positively charged.
- Anaphase
-
(Definition)
A stage within the mitosis phase of cell division (also known as cell reproduction). Anaphase starts when
sister chromatids separate from each other and ends when each set of
separated, sister chromatids arrives at the opposite poles of the
cell.
- Aneuploidy
-
(Definition)
A condition where an abnormal number of chromosomes and genetic
material migrates and attaches where it does not belong.
- Annealing
-
(Definition)
Binding of one nucleic acid chain to another.
- Anthropogenic Global Climate Change
-
(Definition)
It is the full range of climatic disruptions that have occurred as a
probable result of human alteration of the atmosphere. In other
words, it is recent climate warming—and weirdness—that is probably
caused by human activities and technology use.
- Antibiotic Resistance
-
(Definition)
A condition due to the presence of a plasmid in a cell that contains
a gene that encodes a protein that inactivates an antibiotic. Cells
containing this plasmid will be resistant, and therefore able to
grow, in the presence of the antibiotic.
- Aqueous Solutions
-
(Definition)
Solutions in which water is the solvent.
- Artificial Selection
-
(Definition)
Deliberate mating between two individuals who were selected based on
desired traits.
- Asexual Reproduction
-
(Definition)
A type of reproduction where genetically identical offspring are
created from a single parent. This type of reproduction does not
utilize meiosis or gametes. Bacteria and fungi are examples of
organisms that reproduce in this manner.
- Atom
-
(Definition)
The basic unit of matter that cannot be further broken down without
losing its unique properties. One atom consists of a dense nucleus
surrounded by a cloud of electrons. The diagram below represents an
atom of lithium.

- Atomic Mass
-
(Definition)
Mass of an atom. Can be approximated by adding the number of protons
and the number of neutrons.
- Atomic Number
-
(Definition)
Number of protons in each atom, which is equal to the number of
electrons in each atom--unless the atom is ionized. As seen in this
diagram of an atom, lithium has three protons in its nucleus.
Therefore the atomic number of lithium is 3.

- Autosomal
-
(Definition)
Describes a trait associated with alleles located on autosomes (non
sex chromosomes).
- B -
- Bases
-
(Definition)
Substances that when dissolved in water reduce the concentration of
hydronium (H3O+) ions. Bases are hydrogen ion/proton (H+) acceptors.
Bases taste bitter and feel slippery. Soaps are common basic
substances.
- Biodegradable Material
-
(Definition)
Materials capable of natural decomposition and which break down into
nutrients or elements that can be recycled. Biodegradable materials
are more sustainable over time because they can be recycled in an
ecosystem or biogeochemical cycle. Nonbiodegradable materials tend
to accumulate over time and may cause negative environmental
impacts.
- Biodiversity
-
(Definition)
Biodiversity is simply the diversity of life in an area.
- Biogeochemical Cycles
-
(Definition)
The processes that transfer chemical elements between biotic and
abiotic components in an ecosystem.
- Biological Lineage
-
(Definition)
A lineage is a group of populations that evolves independently of
other groups.
- Biological Macromolecules
-
(Definition)
Relatively large ("macro") molecules made by living organisms from
smaller molecular building blocks. There are four classes of
biological macromolecules: protiens, lipids, nucleic acids and
polysaccharides/complex sugars. For example, starch is a biological
macromolecule made by plants from smaller subunits, glucose; all
proteins are made of amino acids, and nucleic acids are made from
nucleotides.
- Biology
-
(Definition)
The scientific study of life. Biology is a vast subject divided into
many branches or subdivisions representing areas of specialization.
Branches of biology include: anatomy, biochemistry, ecology,
evolution, genetics, immunology, physiology, and many more.
- Biogenesis
-
(Definition)
The principle that living things come only from other living things.
- Biomass
-
(Definition)
The total amount (mass) of living organic materials within an
ecosystem or the mass of all members of some specified group of
organisms (e.g. producer biomass, insect biomass, etc.)
- Biosphere
-
(Definition)
All areas on, within, and around the planet Earth that are capable
of supporting life.
- Biotic
-
(Definition)
An adjective that describes living organisms or their remains.
Common characteristics of biotic (living) things are that they use
energy and raw materials to grow, sense and respond to changing
environments; they reproduce; and they consist of one or more
cells.
- Biotic Cycling
-
(Definition)
Cycling of chemicals among living organisms
- Buffers
-
(Definition)
Solutions which resist changes in pH by acting as either an acid or a
base. Blood is an example of a buffered solution. This means that if
a small amount of acid or base is introduced to the bloodstream,
components in your blood will neutralize the acid or base and the pH
of your blood will change only very slightly.
- C -
- Carbohydrates
-
(Definition)
An organic molecule that contains carbon, hydrogen, and oxygen in a
certain proportion. The primary functions of carbohydrates are to:
store energy, provide structure, and cell signaling and recognition.
Common carbohydrates are sugars and starches.
- Carrying Capacity
-
(Definition)
A stable population size. The maximum population size of a species
that an environment can sustain over a long period of time, given
the food, habitat, water and other necessities available in the
environment.
- Catalyst
-
(Definition)
A substance that speeds up a chemical reaction, but is not itself
chemically-altered in the process. A catalyst increases the rate of
a reaction, by decreasing the activation energy required for the
reaction to take place. Enzymes are biological catalysts.
- Cell
-
(Definition)
The smallest fundamental unit of structure and function in life.
Cells are fluid-filled spaces bound by a membrane. When first
formed, all cells include DNA and other macromolecules and are
organized to grow, reproduce, and respond to changes in the external
environment.
- Cell Cycle
-
(Definition)
A series of phases in the life of the cell through which it grows and
divides.
 Diagram depicting the cell cycle phases G1, S, and G2,
collectively referred to as the Interphase (I). G0 corresponds
to cells that do not divide further, such as some nerve cells.
M (red) corresponds to
mitosis, with the four phases of
mitosis designated below in colors yellow, gold, tan, and
orange.
Diagram depicting the cell cycle phases G1, S, and G2,
collectively referred to as the Interphase (I). G0 corresponds
to cells that do not divide further, such as some nerve cells.
M (red) corresponds to
mitosis, with the four phases of
mitosis designated below in colors yellow, gold, tan, and
orange.
- Cell Theory
-
(Definition)
The theory that new cells are formed from other existing cells, and
that the cell is a fundamental unit of structure, function, and
organization in all living organisms.
- Cell Wall
-
(Definition)
Protective and reinforcing structure found in certain cells, situated
outside the plasma membrane. Bacterial cell walls are mainly built
of peptidoglycan, although they may also contain lipidic molecules.
Among eukaryotes, plants and fungi possess cell walls, made of
cellulose and chitin, respectively.
- Centrioles
-
(Definition)
The place where the microtubules originate from during mitosis.
Centrioles are contained within the centrosomes.
- Characteristics
-
(Definition)
Heritable features, such as color and shape.
- Chemical Bonds
-
(Definition)
Attractions between atoms that hold atoms and molecules together.
There are three major types of chemical bonds that are important in
biology: i) covalent, ii) ionic, and iii)
hydrogen bonds.
Covalent bonds occur when two atoms share electrons. Ionic bonds
occur when two oppositely charged ions stick together.
- Chemical Potential Energy
-
(Definition)
Energy inherent to the structural arrangement of atoms or molecules
that may be released by a chemical reaction.
- Chemical Structures
-
(Definition)
Representations of a molecule showing arrangement of atoms and
chemical bonds. Simple structures represent atoms by one leter
symbols and covalent bonds by lines. Three-dimensional structures
represent arrangment of atoms and bonds in three-dimensional space.
For example, water can be represented by any of the following
structures: H-O-H and 3D representations.
- Chemistry
-
(Definition)
The study of matter and its structure, properties, and reactions.
Understanding the basic principles of chemistry is vitally important
in studying biology, as many biological interactions involve
chemistry.
- Chloroplast
-
(Definition)
An organelle within a plant cell which contains pigments such as
chlorophyl. Its primary function is to capture solar energy and
convert it into chemical energy through the process of
photosynthesis. A chloroplast contains its own DNA as a single
circular chromosome.
- Chromatin
-
(Definition)
A combination of DNA and proteins. When the cells divide, chromatin
condenses and becomes visible as chromosomes.
- Chromosome
-
(Definition)
Tightly coiled form of the DNA-protein complex. A thread-like
structure of nucleic acids and protein found in the nucleus of most
living cells, carrying genetic information in the form of genes.
- Cilum
-
(Definition)
A short hair-like projection (pl. cilia) - used in moving a cell or
substance from one place to another. It can be found on certain
eukaryotic cells, such as the cells of the respiratory system.
- Clade
-
(Definition)
A clade is composed of a common ancestor and all species that descend
from this common ancestor. A clade forms a distinct branch on the
tree of life.
- Climate Change Adaptation
-
(Definition)
Actions humans take to prepare for future changes in climate and
minimize harm to humans and ecosystems. It is the effort to make
humans and ecosystems less vulnerable to the effects of ongoing and
future climate change.
- Climate Change Mitigation
-
(Definition)
The effort to reduce emissions of greenhouse gases or increase the
rate at which they are removed from the air, thereby slowing the
pace and reducing the severity of climate change.
- Clones
-
(Definition)
The genetically identical offspring produced from asexual
reproduction.
- Codominant
-
(Definition)
A gene where two different alleles are both expressed in the
heterozygous condition.
- Codon
-
(Definition)
A sequence of three nucleotides in an mRNA molecule that specifies
which amino acid should be added to a growing polypeptide chain.
- Codon Optimization
-
(Definition)
Due to degeneracy in the genetic code, more than one codon can code
for the same amino acid. Different organisms prefer one codon over
another. The process of codon optimization is the use of prefered
codons when designing a gene to be expressed in a certain organism.
- Cohesion
-
(Definition)
Describes a property of matter in which particles tend to stick
together. Liquid water is cohesive and forms spherical droplets
because of its hydrogen bonds which attract the individual water
molecules to each other.
- Competition
-
(Definition)
A type of interspecific interaction where both species are
harmed.
- Consumer
-
(Definition)
An organism that must eat or absorb complex food molecules derived
from the bodies of other organisms. Consumers get their energy and
nutrients from such food molecules. Humans and other animals are
consumers, as are fungi and most bacteria.
- Control Group
-
(Definition)
A group of subjects in an experiment that does not receive the
treatment to be evaluated, but is otherwise similar to the
experimental group. The control group provides a strong basis for
comparison, demonstrating what happens in the absence of the factor
being tested. For example, in a study to test the effectiveness of a
drug, experimenters would predict that the control group
subjects—those who did not receive the drug—would not be cured over
the course of the study.
- Control Variable
-
(Definition)
Any variable in an experiment that is kept the same between the
control and experimental groups. For example, in a study to test a
drug, the control and experimental groups would each contain
subjects (people) of similar ages and similar numbers of men and
women. Additionally, scientists may also put all of the study
participants on the same diet and exercise plan.
- Covalent Bonds
-
(Definition)
Chemical bonds that form molecules and are a result of sharing of
electrons; electrons can be shared equally (non-polar covalent) or
unequally (polar covalent). In the diagram below that illustrates
the formation of a methane molecule, the carbon atom shares each of
its four (4) valence electrons with one hydrogen atom, which in turn
shares its one valence electron with the carbon atom.

- Crossing-over
-
(Definition)
Crossing over is a process in which genes swap positions between
chromatids of homologous chromosomes during Prophase I of meiosis.
The result of crossing over is a new combination of genes on each
chromosome and leads to increased genetic diversity.
- Cytokinesis
-
(Definition)
The division of the cytoplasm of a cell at the end of mitosis to form
two separate daughter cells. In animals cells, this occurs through
the pinching of the membrane at the center of the parental cell
while in plants, this occurs through the formation of a cell plate
as new cell wall forms to separate the daughter cells.
- Cytoplasm
-
(Definition)
The substance that fills the cell, composed mainly of water.
- D -
- Denatured State
-
(Definition)
The state in which unfolded protein chains become entangled with one
another. Extreme temperature and pH are two causes of protein
denaturation.
- Dependent Variable
-
(Definition)
An effect; a variable that is thought to change as a result or
consequence of some other variable. In an experiment, a dependent
variable is used to describe the result, or outcome. For example, in
a study to test a drug, the dependent variable might be the
proportion of subjects that are cured at the end of the study.
- Development
-
(Definition)
Change in structure and function that occurs in an orderly way as an
organism passes through its life cycle.
- Dietary Fiber
-
(Definition)
Indigestible carbohydrates, which cannot be degraded by human
digestive enzymes but that still play important roles in maintaining
health. Cellulose, which is a major component of cell walls, is one
of the largest contributors to dietary fiber.
- Dihybrid Cross
-
(Definition)
Cross between two organisms that are each heterozygous for two
distinct genes.
- Diploid
-
(Definition)
Referring to cells that contain two sets of chromosomes (i.e. pairs
of homologous chromosomes). One set of chromosomes is inherited from
the mother and the other set is inherited from the father. Diploid
cells are 2n. Somatic and germ cells are diploid.
- Disaccharide
-
(Definition)
A carbohydrate made of two monosaccharides linked together by a
covalent bond. Two common disaccharides are sucrose and lactose.
- DNA: Deoxyribonucleic Acid
-
(Definition)
The nucleic acid that contains genetic instructions for making RNA
and, ultimately, proteins in all living organisms. DNA is composed
of two strands of nucleotides, which are intertwined in a double
helix.
- DNA Ligase
-
(Definition)
An enzyme that will bind to DNA fragments held together by sticky
ends and reform the phosphodiester bond between the two DNA
fragments.
- DNA Polymerase
-
(Definition)
Enzyme involved in DNA replication, recognizes the primer and adds
nucleotides to the 3’ end of the primer.
- DNA Replication
-
(Definition)
Synthesis of a new DNA double helix. It is the process by which a
cell, when dividing, makes a copy of its DNA by an enzyme-catalyzed
reaction. Each strand in the existing double helix is used as a
template strand to build a new DNA strand. The result of DNA
replication is that the daughter cells produced in cell division
have the same DNA as the original cell.
- Dominant
-
(Definition)
Describes a trait that is expressed (manifested as a phenotype) even
when only one copy of the allele encoding the trait is present in
the genotype.
- E -
- Ecosystem
-
(Definition)
All the living (biotic) things in a particular area together with
the abiotic (nonliving) materials and conditions in that area; i.e.,
a biological community and its physical environment.
- Electron
-
(Definition)
Negatively charged subatomic particle that occupies shells
surrounding the nucleus and has a mass that is so small it is
considered to be zero.
- Electronegativity
-
(Definition)
The tendancy of an atom to hold shared electrons more close to its
nucleus. Atoms like oxygen have a high electronegativity. This means
when oxygen forms a covalent bond with an atom of lower
electronegativity, the shared electrons will stay closer to the
oxygen atom than to the other atom. Strongly electronegative atoms
bonded to weakly electronegative hydrogen atoms, in a molecule,
result in hydrogen bonding. The most important strongly
electronegative elements in biological systems are oxygen and
nitrogen.
- Elements
-
(Definition)
Matter consisting entirely of atoms with the same number of protons.
There are 92 elements found in nature. Hydrogen, with one proton, is
the most common element in the universe.
- Emergent Properties
-
(Definition)
Characteristics of a system that do not appear in any one of its
component parts alone, but that appear when all parts are combined.
- Energy
-
(Definition)
The capacity to do work or to make a change in the location,
temperature, or structure of matter.
- Energy Pyramid
-
(Definition)
A diagram that shows the energy available at each trophic level in an
ecosystem.
The pattern of energy flow in an ecosystem from producers (bottom of
the pyramid) to the highest trophic level consumer (levels 2 and up)
-- where only about 10% of the available energy in one trophic level
is incorporated and stored as calories in the bodies of the next
level up. The result of this is a pyramid in which energy
availability decreases as the trophic levels increase. Remember that
any energy not transferred to the next higher trophic level is
released as undigested materials in feces or is dissipated as heat.
- Endomembrane System
-
(Definition)
A term for a set of membranous structures found in eukaryotic cells
that are related to the synthesis, packaging, and distribution of
cellular molecules. It encompasses the endoplasmic reticulum (rough
and smooth), the Golgi apparatus, and vesicles.
- Enzyme
-
(Definition)
A protein that acts as a catalyst for chemical reactions in
biological organisms. Enzymes increase the speed of chemical
reactions. A protein that speeds up the rate of chemical reactions
that support life.
- Epigenetics
-
(Definition)
Epigenetics is the study of heritable changes in gene expression or
cellular phenotype that are not the result of changes in the
underlying DNA sequence (i.e., mutations) but rather through
different mechanisms (e.g., DNA methylation or histone remodeling).
- Epistasis
-
(Definition)
A single trait involving multiple genes where the effect of one gene
can mask the effect of a different gene.
- Eukaryotes
-
(Definition)
An organism with cells containing complex membrane-bound structures
(referred to as organelles) the most distinctive of which is the
nucleus; and other organelles such as mitochondria, chloroplasts,
cytoskeleton, and the Golgi apparatus. All species of animal, plants
and fungi contain eukaryotic cells.
- Evolution
-
(Definition)
A scientific theory explaining how and why genetic changes occur in
populations or higher-level groups over generations of time.
- Experimental Group
-
(Definition)
A group of subjects in an experiment that receives the treatment to
be evaluated. If the hypothesis is correct, the dependent variable
will change in a predictable way within the experimental group. For
example, in a study to test the effectiveness of a drug, a high
proportion of those in the experimental group would be cured or
helped by the treatment, if the hypothesis is correct.
- Expression Plasmid
-
(Definition)
A circular double stranded DNA molecule that contains all of the
necessary DNA sequences to allow for maintenance of the plasmid as
well as the production of mRNA from genes inserted into the
plasmid.
- F -
- F1 Generation
-
(Definition)
First filial offspring of the parents; the first generation of
offspring; the first child of a parent.
- F2 Generation
-
(Definition)
Second filial generation; offspring of the F1 generation; grandchild
of a parent.
- Flagellum
-
(Definition)
(pl. flagella) - A long whip-like projection used in moving the cell
from one place to another. It can be found in both prokaryotes and
eukaryotes.
- Food Chain
-
(Definition)
A group of organisms that are joined in a linear series of feeding
relationships starting with the producer and moving up the trophic
levels. An example would be grass to grasshopper to rat to owl:
- Food Web
-
(Definition)
A diagram showing all feeding relationships in a community;
emphasizes the complexity of real communities which generally have
many overlapping and interconnected food chains.
 Depiction of the food web associated with freshwater
wetlands. By Mark Sharp (EPA) [Public domain], via Wikimedia Commons
Depiction of the food web associated with freshwater
wetlands. By Mark Sharp (EPA) [Public domain], via Wikimedia Commons
- Foundation Species
-
(Definition)
A species that are physically dominant (largest and/or most abundant)
in communities.
- Functional Groups
-
(Definition)
Smaller groups of atoms within a larger molecule that have a
particular characteristic or function. Functional groups give a
molecule its characteristics and participate in predictable chemical
reactions.
- G -
- Gamete
-
(Definition)
A haploid, sex cell (egg or sperm) produced from germ cells that have
undergone meiosis. When two gametes join in fertilization the
resulting zygote is a complete diploid cell.
- Gene
-
(Definition)
A segment of DNA that carries specific information, ultimately
coding for a protein, which determines certain traits in an
organism.
The gene is the basic unit of inheritance. It is a segment of DNA
with instructions for protein synthesis. Genes are located on DNA
stands, and each gene is composed of a specific nucleotide sequence
that codes for the amino acid sequence of a protein.
- Gene Expression
-
(Definition)
Transcription of information encoded in a gene into RNA and
eventually a polypeptide chain. It is the process by which
information coded in a gene is accessed and used to produce RNA and
proteins.
- Gene Flow
-
(Definition)
The result of fertile members of a species moving into or out of a
population.
- Gene Pool
-
(Definition)
All of the genes and alleles present in a population at some point in
time.
- Genetic Drift
-
(Definition)
The change in a gene pool as a result of random chance.
- Genome
-
(Definition)
All the genetic information in an organism. The complete DNA sequence
of one set of chromosomes from an organism.
- Genotype
-
(Definition)
Alleles (i.e., one version of a gene) present in an organism.
- Germ Cell
-
(Definition)
A cell that in the body of a sexually reproducing organism that
produces gametes (eggs or sperm) through meiosis. Germ cells are
immature reproductive cells. In humans, germ cells are found in the
testes of men and ovaries of women.
- Glycogen
-
(Definition)
A polysaccharide that is stored in the liver and is composed of
glucose molecules linked together. Excess glycogen is converted to
fat. When food intake is insufficient, glycogen can be broken down
into glucose for energy.

- Golgi Apparatus
-
(Definition)
Modifies, stores, and exports materials within and out of the
cell.
- Greenhouse Effect
-
(Definition)
A phenomenon in which greenhouse gases in Earth's atmosphere support
heat retention and serve to maintain warm and relatively stable
surface temperatures.
Certain gases warm the climate by absorbing and re-emitting heat
radiation, keeping temperatures warmer and more stable near the
planet’s surface. Humans have strengthened this effect by adding
extra greenhouse gases to the atmosphere. Some results have included
increased temperatures, increased sea level, increasingly variable
weather, melting ice and permafrost, increasing droughts, shifts in
species distributions, and shifts in the timing of seasonal
events.
- Greenhouse Gas
-
(Definition)
Greenhouse gases absorb and reemit heat waves (infrared radiation).
Three important greenhouse gases are water vapor (H2O), carbon
dioxide (CO2), and methane (CH4). Much of the heat (infrared)
radiation that leaves Earth’s surface is absorbed by greenhouse
gases and reemitted back toward Earth. As a result, these gases
retain heat in the atmosphere. Instead of escaping immediately to
space, heat is delayed near the Earth’s surface and continues to
warm our atmosphere.
- Growth
-
(Definition)
Increase in size of an organism. Biological growth, unlike the
growth of a glacier or a mountain, is not merely an increase in
size; it also involves the reorganization of materials into the
unique structures of the organism.
- H -
- Habitat Loss
-
(Definition)
Human activities destroy or change a habitat so that it no longer
supports the growth and reproduction of a species. This is widely
acknowledged as the most important direct threat to biodiversity
worldwide. Habitats that have been profoundly changed by human
activities include forests (clearing), grasslands (plowing and
overgrazing), rivers (damming), and wetlands (draining).
- Haploid
-
(Definition)
Cells that contain only one set of chromosomes. Haploid cells are
referred to as "1n". Gametes (sperm and eggs) are haploid. In human
haploid gametes contain 23 chromosomes.
- Heterozygous
-
(Definition)
Having two different alleles for a trait present.
- Homeostasis
-
(Definition)
The tendency of organisms and cells to maintain stable internal
conditions. The term comes from the Greek words homeo (same, alike)
and stasis (standing).
- Homologous
-
(Definition)
Refers to two chromosomes that are a matched pair in a diploid cell.
A matched pair of chromosomes are the same length and contain genes
for the same characteristics at the same position on them. For each
homologous pair, one chromosome is inherited from the mother and the
other is inherited from the father.
- Homologous Features
-
(Definition)
Shared features/traits that were inherited from the same source and
reflect common ancestry. Remember these features/traits are based in
genes (not acquired through learning or the environment).
- Homologue
-
(Definition)
Refers to one of the other of a homologous pair of chromosomes. Each
is considered the homologue of the other.
- Homozygous
-
(Definition)
Both alleles present are identical.
- Hydrogen Bonds
-
(Definition)
Weak electrostatic attraction that occurs between the partial
positive charge on the H atom of one polar molecule and the partial
negative charge in some region of another polar molecule. The
separation of charge within a molecule (required for hydrogen
bonding between molecules) usually occurs where an electronegative
element (usually oxygen or nitrogen) is bonded to a hydrogen atom.
- Hydrophilic
-
(Definition)
Substances that dissolve in or are attracted to water. Hydrophilic
(from Greek meaning "water-loving")
refers to molecules that are water soluble. Hydrophilic molecules
contain polar functional groups that can form hydrogen bonds or
ionic bonds with water. Ionic and polar substances are
hydrophilic.
- Hydrophobic
-
(Definition)
Hydrophobic, or water-fearing, molecules do not interact with water
and are characterized by a complete lack of electronegative atoms.
In aqueous solutions the hydrophobic molecules are driven together
to the exclusion of water.
- Hypothesis
-
(Definition)
A proposed explanation of an observation; often referred to as an
“educated guess.” In the process of the scientific method, a
hypothesis is tested through experimentation and/or observation.
- I -
- Incomplete Dominant
-
(Definition)
A gene where the dominant allele is not expressed as strongly in the
heterozygote as in the homozygous dominant condition.
- Independent Variable
-
(Definition)
A cause or factor; a variable that is thought to cause another
variable to change. In an experiment, an independent variable is
deliberately changed in one group at the beginning of the study. For
example, in a study to test a drug, one group might be given the
drug and another group would not; the independent variable in this
example would be whether patients were given the drug.
- Indirect Interaction
-
(Definition)
A type of community interaction where the effect of one species on
another is exerted through one or more additional species acting as
intermediaries. This is sometimes referred to as the "ripple
effect".
- Inorganic
-
(Definition)
Any substance lacking molecules that contain a carbon atom bonded to
a hydrogen atom. Examples of common inorganic substances are: water,
oxygen gas, carbon dioxide and ionic salts.
- Interphase
-
(Definition)
The stage of the cell cycle when division (mitosis) does not occur.
During interphase, the cell grows, acquires nutrients, and
replicates both its chromosomes as well as its organelles.
Interphase consists of the
G1 (chromosomes condense),
S (DNA duplicates), and
G2 (DNA integritiy
checked and repaired) phases of the cell cycle. Cells spend the
majority of their time in interphase.
 Diagram depicting the cell cycle phases G1, S, and G2,
collectively referred to as the Interphase (I).
Diagram depicting the cell cycle phases G1, S, and G2,
collectively referred to as the Interphase (I).
- Interspecific Interaction
-
(Definition)
An effect of one population on another in a community; any
interaction between members of different species. This is a type of
community interaction and has three subtypes: mutualism, predation,
and competition.
- Introduced Species
-
(Definition)
Non-native species that are introduced in new habitats and
compete--often out-compete--species native to the habitat.
Humans move species out of their natural range and into a new area.
The new species prey upon, compete with, change habitat for, or
otherwise harm native species, resulting in their extinction. This
is a particularly important threat on islands and other isolated
habitats, where introduced predators may decimate native prey
species that are not adapted to their presence.
- Ion
-
(Definition)
An atom or molecule that has gained or lost one or more electrons
and consequently has a positive or a negative charge. Negatively
charged ions, called anions, form when a
neutral molecule or atom gains one or more electrons. Positively
charged ions, called cations, form when a
neutral molecule or atom looses one or more electrons.
- Ionic Bond
-
(Definition)
An attractive force generated by the interactions between ions of
opposite charges. An ionic bond forms due to an attraction between a
positive and a negative ion. No electron sharing occurs in the ionic
bond. In the formation of an ionic bond, electrons are said to be
transferred from one atom to another.
- Isotopes
-
(Definition)
Two atoms with the same atomic number (because they are the same
element and have the same number of protons), but different atomic
mass (because they have different numbers of neutrons). Carbon-12
(the number after the hyphen, 12 in this example, indicates the
atomic mass), which has 6 protons and 6 neutrons and Carbon-13,
which has 6 protons and 7 neutrons are two isotopes of carbon.
- K -
- Karyotype
-
(Definition)
Diagrammatic representation of an organism's genome. An image of the
chromosomes of a cell in metaphase where the chromosomes are
arranged in pairs by centromere position and size. Karyotypes are
used to count and analyze the chromosomes of an individual and can
also be used in the determination of chromosomal abnormalities.
- Keystone Species
-
(Definition)
A species that has an unexpectedly strong effect on the stability or
diversity of a community that is much larger than its abundance or
biomass would suggest.
- Kinetochore
-
(Definition)
Proteins on the centromere where microtubules attach. These attached
microtubules are called kinetochore microtubules.
- L-
- Lac Operator
-
(Definition)
A segment of DNA that is recognized by the lac repressor protein.
When the lac repressor protein is bound to the operator, no mRNA is
made from the genes that encode lactose metabolism.
- Lac Repressor
-
(Definition)
A protein, produced by the lacI gene, that binds to the lac repressor
DNA sequence, regulating the transcription of genes required for
lactose metabolism. The repressor is bound to the operator in the
absense of lactose, and released from the operator when lactose is
present.
- Law of Independent Assortment
-
(Definition)
Each pair of alleles segregates separately of any other pair of
alleles when gametes are formed.
- Law of Segregation
-
(Definition)
States that the two alleles for each gene separate from each other
when gametes form, so that each gamete contains one allele of each
gene.
- Ligand
-
(Definition)
An atom, ion, or molecule that binds to another, usually larger
chemical structure, to form a complex.
- Lipids
-
(Definition)
Organic marcromolecules that are largely nonpolar (electrons are
evenly distributed amongst atoms in a molecule) and as a result are
hydrophobic (“water-fearing”). Lipids perform many functions in the
cell including: storage of energy for long-term use in the form of
fats, insulation from the environment, and building blocks for
hormones. Lipids include fats, oils, waxes, phospholipids, and
steroids.
- M -
- Macroevolution
-
(Definition)
A change in a biological lineage including the origin or extinction
of species. This is evolution beyond the species level.
- Macromolecule
-
(Definition)
A large and complex molecule formed from combining smaller subunits,
and consisting of many atoms. There are four main types of
macromolecules that you will be learning about in this course:
carbohydrates, nucleic acids, lipids, and proteins.
- Matter
-
(Definition)
Anything that occupies space and has mass. The substance, consisting
of atoms and subatomic particles, composing all physical
objects.
- Meiosis
-
(Definition)
A type of cell division in which a single, diploid germ cell is
divided into four, haploid gamete cells. Meiosis only occurs in
organisms that sexually reproduce and results in the production of
sperm in males and egss in females.
- Meiosis II
-
(Definition)
The second half of the whole process of meiosis in which the sister
chromatids in each of the two haploid cells produced during meiosis
I are separated. Meiosis II results in the production of four
haploid gamate cells and is similar in process to mitosis.
- mRNA: Messenger RNA
-
(Definition)
The type of RNA molecules that contain instructions for making a
protein.
- Microevolution
-
(Definition)
Occurs when the type or frequency of the alleles and genotypes in a
population change over one to many generations of time
- Microorganism
-
(Definition)
A life form that cannot be seen with the naked eye; also called a
microbe. Microorganisms include bacteria, many single-celled
eukaryotes (plants, animals, fungi, and small creatures called
protists), and even some multicellular life forms.
- Microtubules
-
(Definition)
One type of fiber that makes up the cytoskeleton of a eukaryotic
cell. Microtubules consist of proteins called tubulins. Microtubules
aide in cell structure and movement and are also responsible for
moving the chromosomes during mitosis and meiosis.
- Mitochondrion
-
(Definition)
(pl. mitochondria) - the powerhouse of
eukaryotic cell; the organelle whose primary function is to perform
cellular respiration, to convert chemical energy into a form that
can be used directly by the cell -- Adenosine Triphosphate (ATP). A
mitochondrion contains its own DNA as a single circular chromosome.
- Mitosis
-
(Definition)
A type of cellular division in which a single, diploid, somatic cell
is divided into two genetically identical daughter cells. Mitosis
along with cytokinesis compose the mitotic (M) phase of the cell
cycle.
- Mitotic Phase
-
(Definition)
The phase in which the cell first divides its nucleus and then the
cytoplasm.
- Molecule
-
(Definition)
Two or more atoms held together by a chemical bond. The diagram below
illustrates a molecule of methane (CH
4), in which four
hydrogen (H) atoms are covalently bonded to one carbon (C) atom.

- Monomer
-
(Definition)
A small organic molecule that may bind chemically to other molecules
to form a polymer.
- Monohybrid Cross
-
(Definition)
Cross between two organisms, each of which is heterozygous for the
trait.
- Monosaccharide
-
(Definition)
A simple sugar (carbohydrate) containing carbon, hydrogen, and oxygen
atoms in a 1:2:1 ratio respectively. Some common monosaccharides are
glucose, fructose, and ribose.
- Mutation
-
(Definition)
Changes to the DNA nucleotide sequence. A permanent, irreversible,
and heritable change in DNA.
- N -
- Natural Selection
-
(Definition)
A process by which nature (i.e. the environment and all of its
components) impacts the evolution of a population.
- Neutral
-
(Definition)
Substances that are neutral, like pure water, have equal
concentrations of hydrogen (H+) and hydroxide
(OH-) ions.
- Neutralization
-
(Definition)
The process of combining an acid with a base, in which the hydrogen
ion/proton (H+) that was associated with water (as a hydronium ion,
H3O+) combines with the hydroxide ion (OH-) to produce water (HOH).
The general form of a neutralization reaction is:
- Neutron
-
(Definition)
Subatomic particle with a neutral charge that is contained in the
nucleus and has a mass of approximately 1 atomic mass unit.
- Nitrogenous Base
-
(Definition)
A molecule that is one of the three components that make a
nucleotide. There are five bases: adenine (A), guanine (G), cytosine
(C), thymine (T), and uracil (U). The DNA structure consist of four
bases: A, C, G, and T. The RNA molecule contains the bases: A, C, G,
and U.
- Non-Polar Amino Acid
-
(Definition)
An amino acid with non-polar side chains contain, primarily,
hydrocarbons and no polar functional groups containing
electronegative atoms. Note that the term “non-polar” refers only to
the side chain, while the amino acid as a whole is charged at
physiological pH due to the carboxyl and amino groups.
- Non-polar Functional Groups
-
(Definition)
Functional groups of a molecule that do not contain an
electronegative atom; therefore, the functional group is non-polar.
An example is a methy group -CH3.
- Nondisjunction
-
(Definition)
The failure of sister chromatids or homologous chromosomes to
separate during anaphase of either mitosis or meiosis.
- Nucleic Acids
-
(Definition)
Organic macromolecules, built from nucleotides, that carry out two
main functions in the cell: storage of genetic information and
synthesis of proteins. DNA and RNA are both nucleic acids.
- Nucleoid
-
(Definition)
A specific region in the cytoplasm of a prokaryotic cell where
genetic material is stored.
- Nucleosomes
-
(Definition)
A packaging unit of DNA in a eukaryotic cell consisting of DNA wound
around a protein core composed of eight histone molecules.
- Nucleotides
-
(Definition)
Molecules that make up the individual structural units of the nucleic
acids RNA and DNA. Each nucleotide is made up of three components: a
phosphate, a sugar, and a nitrogenous base.

- Nucleus
-
(Definition)
The word nucleus is used in two different contexts in the study of
biology. Loosely defined, nucleus means "center" or "core." Here, in
a study of basic chemistry, nucleus means "the center of an atom."
In this case, the nucleus is a central area in which the atom’s
heavy particles (protons and neutrons) are packed close together.
When discussing cell structure, the word nucleus refers to the
central organelle of the eukaryotic cell. It consists of the cell’s
DNA enclosed in a double-layered membrane and can be thought of as
the “command center” of the eukaryotic cell.
- Nutrients
-
(Definition)
Forms of matter that an organism requires and that the organism
cannot make for itself. Nutrients must be taken in from the outside
environment. Humans obtain nutrients from the food we eat and the
water we drink. Plants take up nutrients through their roots (water
and dissolved minerals) and from the air (carbon dioxide gas).
- O -
- Operon
-
(Definition)
Collection of genes that are transcribed on the same mRNA from a
single promoter. Usually, all of the genes code for enzymes in a
single biochemical pathway, allowing coordinated control of the
expression of all of the enzymes in one pathway.
- Organ
-
(Definition)
A collection of tissues grouped together based on a common general
function. Some common organs in the human body are the heart, lungs,
and kidneys.
- Organ System
-
(Definition)
Functionally-related organs that work together to carry out a
function throughout an organism’s body. Your body is made up of many
organ systems, including the skeletal, digestive, and circulatory
systems.
- Organelle
-
(Definition)
A compartment inside the cells of eukaryotes that contain specific
groups of macromolecules and carry out specific cellular
functions.
- Organic Molecules
-
(Definition)
Molecules containing a carbon atom that is covalently bonded to a
hydrogen atom (C-H bonds). Many organic molecules also contain
oxygen, nitrogen, or sulfur. All living organisms are composed of
four major classes of large carbon-containing molecules: proteins,
carbohydrates, lipids, and nucleic acids. The term
organic is in common use these days. For example,
you can buy organically grown tomatoes or
clothes made from organically grown cotton.
In these cases, organic refers to the way the tomatoes
and cotton were grown — without the use of man-made pesticides or
fertilizers, and nurtured only by natural substances. Here, organic
is used to denote a natural process. You can see then that the word
organic is used in two different ways. Be careful
not to confuse the two. It can also be said that organic
molecules (such as carbon-containing proteins,
carbohydrates, lipids, and nucleic acids) are natural molecules. But
not all naturally-occurring molecules contain carbon, for example,
water and common table salt. Are water and salt naturally occurring?
Yes. But are they organic? No, because they are not built from
carbon.
- Organism
-
(Definition)
An organism is an individual living entity that survives and
reproduces as a unit. Examples include a single bacterial cell, a
plant grown from a single seed, or you—as an individual human being.
Any life form - animal, plant, fungus, bacteria, protist, or
single-celled entity.
- Origin of Replication
-
(Definition)
A sequence of DNA that serves as a binding site for proteins involved
in initiating DNA replication.
- Overharvesting
-
(Definition)
Human harvesting—hunting, fishing, logging, gathering, and so on —
removes individuals more quickly than they can be replaced by
natural reproduction. This was historically a major threat in North
America and Europe, but today most fish and wildlife resources are
fairly well-protected. Open ocean fisheries and tropical mammals, by
contrast, are heavily impacted by human harvesting today.
- P -
- P Generation
-
(Definition)
Parental generation.
- Pedigree
-
(Definition)
Mapping or charting of a family history, showing the occurrence of a
trait or characteristic. Mated individuals are connected by a
horizontal line, and children are connected to them by vertical
branches extending down from the line. Individuals expressing a
genetic trait are shaded; and, individuals not expressing the trait
are not shaded.
 Maps used to trace genetic traits through generations of
individuals. Symbols: Males are squares. Females are circles.
Maps used to trace genetic traits through generations of
individuals. Symbols: Males are squares. Females are circles.
- Peptide Bond
-
(Definition)
A covalent bond that links amino acids together to form proteins.
Produced when the carboxyl group of one amino acid reacts with the
amino group of another amino acid.
- Periodic Chart
-
(Definition)
A tabular categorization of all of the elements arranged in order of
increasing atomic number. Also called the Periodic Table, the table
is organized such that elements with similar properties are grouped
in the same column (called a chemical group) and elements with the
same number of electron shells appear in the same row (called a
period).
 Periodic table of the chemical elements. By Cepheus [ Public
Domain] via Wikimedia Commons.
Periodic table of the chemical elements. By Cepheus [ Public
Domain] via Wikimedia Commons.
- pH
-
(Definition)
A measure of the concentration of hydrogen ions (H+) in a
solution. Solutions with a pH less than 7 are acidic. Solutions with
a pH of 7 are neutral. Solutions with a pH greater than 7 are basic.
A one-point change in pH is equal to a ten-fold difference in the
concentration of hydrogen ions (H+).
- Phenotype
-
(Definition)
Physical or physiological characteristic present; also defined as the
manifestation of the genes in an organism.
- Phospholipid Bilayer Membrane
-
(Definition)
Phospholipid molecules (phosphate group bound to two fatty acid
tails) aligned with fatty acid tails pointing inwards such that a
double layer of phospholipids is formed. Cellular membranes are
composed primarily of this bilayer of phospholipids.
- Phylogenetic Tree
-
(Definition)
Phylogenetic tree (also called phylogeny), is a tree diagram that
represents a hypothesis as to how a biological lineage may have
branched and formed clades over time. Remember that as a hypothesis,
phylogenetic trees are subject to change as more data are gathered
and as analysis techniques improve.
 A phylogenetic tree of living things, based on RNA data and
proposed by Carl Woese, showing the separation of bacteria,
archaea, and eukaryotes. By Eric Gaba, NASA Astrobiology
Institute. [Public domain], via Wikimedia Commons
A phylogenetic tree of living things, based on RNA data and
proposed by Carl Woese, showing the separation of bacteria,
archaea, and eukaryotes. By Eric Gaba, NASA Astrobiology
Institute. [Public domain], via Wikimedia Commons
- Physical Disturbance
-
(Definition)
Humans reshape the physical structure of ecosystems by clearing
forests, suppressing or setting fires, building roads and cities,
mining, maintaining croplands, and building water control structures
such as dams. This leads to biodiversity loss. It may also increase
our exposure to forest fires, floods, droughts, soil erosion,
landslides, and other physical hazards.
- Placebo
-
(Definition)
A substance having no medicinal benefit that is administered to the
control group in a study so that these study participants do no know
if they are in the control or experimental group. Placebos in drug
trials are often sugar pills or a vitamin formulated to look like
the drug being tested. Interestingly, sometimes patients taking a
placebo will report that they notice an improvement in the medical
condition the drug is designed to treat or even experience a real
medical improvement all because they think they are taking the new
drug. This phenomenon is called the placebo effect.
- Plasma Membrane
-
(Definition)
A structure surrounding all types of cells, separating it from the
external environment. It constitutes a semipermeable boundary, where
certain substances can cross and others cannot. Chemically, the
plasma membrane (also called the cell membrane) is a double
layer of phospholipids (phospholipid bilayer) containing embedded
proteins and sometimes sterols.
- Pleiotropy
-
(Definition)
Single gene with multiple effects.
- Polar Amino Acid
-
(Definition)
An amino acid with
polar side chains contain polar uncharged
groups, for example amide and hydroxyl.
- Polar Covalent Bond
-
(Definition)
A covalent bond that forms between a highly electronegative atom
(e.g. N and O) and a non-highly electronegative atom. This results
in an uneven distribution of the charge (because the electrons spend
more time around the electronegative atom) causing one end of the
bond to have a more positive charge on the end with the
non-electronegative atom and a more negative charge on the end with
the electronegative atom.
- Polar Functional Groups
-
(Definition)
Functional groups that contain an electronegative atom rendering the
functional group polar. Examples are the hydroxyl group (-OH) and
amino (-NH3+).
- Pollution
-
(Definition)
Materials released or discarded by humans that harm human health or
life in ecosystems.
Wastes generated by human activities change habitat conditions or
threaten the health of organisms directly. Nutrient pollution, for
example, is a global problem that harms the diversity of aquatic and
some terrestrial communities. Pollution of the atmosphere by
greenhouse gases generates climate change, a problem so complex and
severe that it is often counted as a separate threat category.
- Polygenic
-
(Definition)
A single trait resulting from the interaction of multiple genes.
- Polymer
-
(Definition)
These are large molecules consisting of repeating structural units,
or monomers, connected by covalent chemical bonds. Larger organic
molecules (macromolecules) consist of a carbon/oxygen/nitrogen
skeleton (backbone) with other atoms branching off from this
structure.
- Polysaccharide
-
(Definition)
A carbohydrate consisting of long chains of monosaccharides. Some
common polysaccharides are starch, glycogen, and cellulose.
- Population
-
(Definition)
All the individuals of a single species living within the same area
and are likely to breed with one another.
- Principle of Dominance
-
(Definition)
States that some traits are dominant and can mask recessive
traits.
- Producers
-
(Definition)
Organisms that make simple organic food molecules from inorganic raw
materials using light energy from the sun and do not consume other
living organisms to obtain nutrients. Producers make up trophic
level 1 in most ecosystems. Plants, algae, and cyanobacteria are
examples of producers.
- Prokaryotes
-
(Definition)
A unicellular organism lacking a nucleus or other membrane-bound
organelles.
- Prophase
-
(Definition)
This is the first stage of mitosis. In prophase, the nucleus is
broken down, the chromosomes (duplicated during the S phase of the
cell cycle) condense, and the mitotic spindles form.
- Proteins
-
(Definition)
Organic macromolecules made up of amino acids connected by peptide
bonds. Proteins serve many functions, some of which include:
catalyzing reactions as enzymes, storage, replication, transmission,
and regulation of genetic information, and helping maintain
structure in an organism.
- Proton
-
(Definition)
Positively charged subatomic particle that is contained in the
nucleus and has a mass of approximately 1 atomic mass unit.
- Punnett Square
-
(Definition)
Table method used to assess probabilities of outcomes in
genetics.
- R -
- Recessive
-
(Definition)
Describes a trait that is masked by the dominant trait and is only
expressed in the homozygous condition.
- Renewable Resource
-
(Definition)
Material used or consumed by humans that can be replenished
sufficiently to prevent complete consumption of that material.
Resources are renewed through growth or other ongoing processes.
- Reproduction
-
(Definition)
The process by which an individual organism gives rise to offspring,
passing on its genetic information to the next generation.
- Repressor
-
(Definition)
Protein that binds to DNA near promoter sites, reducing the amount of
mRNA that is generated from that promoter, and consequently the
amount of protein that is translated from the mRNA. The ability of
the repressor to bind to DNA is often controlled by small molecules,
i.e. the lac repressor is released from DNA in the presence of
lactose.
- Resource Depletion
-
(Definition)
Material used or consumed by humans that is nearing or at depletion
and may not be replenishable. Currently, the average citizen of a
developed nation consumes an average of 16 tons of minerals, ores,
fossil fuels, and biomass per year. Shortages may result if humans
use resources at an unsustainable rate. Wild plants and animals may
be harvested to the point of extinction. Degradation of soil can
lead to crop failures. Minerals and fossil fuels may be depleted to
the point where their extraction becomes increasingly expensive and
disruptive.
- Restriction Endonuclease
-
(Definition)
An enzyme that recognizes and cleaves a specific DNA sequence.
Example: EcoR1 binds to the sequence GAATTC and cleaves between the
G and the A.
- Ribonucleic Acid (RNA)
-
(Definition)
The nucleic acid composed of nucleotides in a single strand whose
primary function is protein synthesis.
- Ribosomal RNA (rRNA)
-
(Definition)
The type of RNA that is component of a ribosome, and which assists
with the process of translating the instructions for making proteins
that are present in messenger RNA (mRNA).
- Ribosome
-
(Definition)
Cytoplasmic structures which function as assembly sites for proteins.
Particles made up of RNA and proteins that is the site of protein
synthesis. In prokaryotes they are found in the cytoplasm, in
eukaryotes they are mainly associated to a part of the endoplasmic
reticulum, named rough endoplasmic reticulum due to its dotted
appearance.
- Ribosome Binding Site
-
(Definition)
Sequence on mRNA that is responsible for binding of the mRNA to
prokaryotic ribosomes.
- RNA Polymerase
-
(Definition)
Enzyme involved in transcription, build an RNA strand using DNA as a
template.
- S -
- Scientific Experiment
-
(Definition)
A structured and active process used to test a hypothesis. In an
experiment, the scientist has some form of control over the
variables at work in the system under study. Typically some variable
is deliberately changed by the experimenter and other variables are
monitored to see if they change as a result.
- Scientific Inquiry
-
(Definition)
The application of scientific observation, experimentation and the
scientific method to study, interpret and predict natural phenomena
in the world around us.
- Scientific Observation
-
(Definition)
A process used to explore and describe patterns in nature. In a
strictly observational study, the scientist does not have control
over the conditions or variables at work in the system under study.
The scientist reports what has happened without taking steps to
intervene in the system.
- Segregation
-
(Definition)
The two alleles for each trait separate when gametes form.
- Selection
-
(Definition)
Process in which characteristics of a population change predictably
over many generations. Selection takes forms such as natural
selection (favors traits that aid in survival to reproductive age),
sexual selection (favors traits that boost mating success), and
artificial selection (favors traits that are chosen by human
breeders).
- Selective Permeability
-
(Definition)
A property of the cell membrane wherein only certain molecules or
ions can cross the membrane by diffusion. In this way the cell can
maintain homeostasis by controlling what enter and exits the cell.
- Sex-Linked
-
(Definition)
Describes a trait associated to alleles located on sex chromosomes,
most commonly it is X-linked.
- Sexual Reproduction
-
(Definition)
A more complicated form of reproduction where two haploid, gametes
(sperm and egg) fuse to create a diploid zygote. This type of
reproduction produces offspring that are genetically different from
their parents.
- Sexual Selection
-
(Definition)
Natural selection arising through preference by one sex for certain
characteristics in individuals of the other sex.
- Sister Chromatid
-
(Definition)
One of two identical copies of a chromosome duplicated during the S
phase of the cell cycle. A centromere connects two sister chromatids
together. When joined together sister chromatids compose one
chromosome, and chromatids are separated from each other during
mitosis or meiosis.
- Solute
-
(Definition)
Component of a solution that is present in the smallest quantity and
which dissolves in a solvent.
- Solutions
-
(Definition)
Homogeneous mixtures of solvent and solute.
- Solvent
-
(Definition)
Component of a solution that is present in the greatest quantity and
in which something else is dissolved.
- Somatic Cell
-
(Definition)
Any nonreproductive cell found in multicellular organisms. That is,
any cell except a germ cell or gametes (sperm and egg cells) found
in a muticellular organism. Examples are lung and heart cells, nerve
cells, and blood cells.
- Speciation
-
(Definition)
Speciation is the formation of new biological lineage as one species
splits into two or more species.
- Species
-
(Definition)
A group of organisms whose members can and will breed with each other
to produce fertile offspring.
- Species Richness
-
(Definition)
The number of different species of organisms present in a given area.
This is a statistic used to describe an ecological community.
- Spontaneous Generation
-
(Definition)
A disproven principle stating that life could originate from
inanimate matter on an ongoing basis.
- Starch
-
(Definition)
A branching polysaccharides consisting of linked glucose molecules.
Starch is made by producers, not animals. Starch can be broken down
into individual glucose molecules that can be used to build ATP.
- Start Codon
-
(Definition)
Codon in the mRNA that represents the first amino acid to be
incorporated. It is almost always AUG.
- Sterols
-
(Definition)
Also known as steroid alcohols, these are an important subgroup of
steroids widely distributed in animal and plant lipids. The most
familiar type of animal sterol is cholesterol which builds steroid
hormones, are sources for vitamins D and K, and helps maintain cell
membrane consistency.
- Sticky End
-
(Definition)
A single stranded end on DNA. Produced by the activity of most
restriction endonucleases. The bases on one single stranded segment
can "stick" to another single stranded end by forming complementary
hydrogen bonds between the bases on each strand.
- Stop Codon
-
(Definition)
Codon in the mRNA that signals the termination of the polypeptide
chain. Three stop codons are UAG, UAA, or UGA.
- Substrate
-
(Definition)
A molecule that binds to enzymes. Upon bonding to the enzyme, the
substrate molecule is converted into a new molecule.
- Subunit
-
(Definition)
Structural unit of a larger molecule or a protein in a multi-protein complex.
This term is similar, but not identical to the term monomer.
- Surface Tension
-
(Definition)
The capacity of a liquid’s surface to resist being ruptured when
placed under tension or stress.
- Sustainable Technology
-
(Definition)
Solutions that meet human economic and social needs while preserving
the productivity or biodiversity of ecosystems over a long period of
time.
- Symbiosis
-
(Definition)
A type of direct community interaction between pairs of species that
are intimately and physically connected, with a smaller species
(symbiont) living in or on the body of a larger species (host).
These direct interactions are described using the term symbiosis,
which translates to “together living.”
- Sympatric Speciation
-
(Definition)
The formation of a new species (from within a population) in the same
geographic area without a known geographical barrier that divides
them today or in the recent geologic past.
- T -
- Telophase
-
(Definition)
This is the final stage of mitosis. In telophase, new nuclear
envelopes form around the separated chromosomes at each pole of the
cell, the chromosomes unfold back into chromatin, nucleoli reappear,
and the cell continues to elongate.
- Terminator
-
(Definition)
A sequence of DNA at the end of the mRNA that signals the termination
of transcription by RNA polymerase.
- Tissue
-
(Definition)
A groups of similar cells carrying out the same detailed function
within an organism. In the lung, for instance, the lining of airways
comprises one type of tissue: a layer of similar cells that forms a
sealed surface.
- Trait
-
(Definition)
Form of a characteristic represented.
- Transfer RNA (tRNA)
-
(Definition)
The type of RNA, directly involved in protein synthesis, that
transports amino acids to ribosomes to be incorporated into an
emerging protein.
- Translation
-
(Definition)
The process by which the information stored in messenger RNA is used
to synthesize proteins. The information in the RNA (a nucleic acid)
is converted to a new chemical form, amino acids.
- Transcription
-
(Definition)
Reading the DNA and encoding an mRNA molecule with information to be
taken to protein-synthesizing regions of the cell.
It is the process through which a complementary copy of
protein-coding mRNA is synthesized, using one strand of DNA as a
template. The new RNA strand is identical to the complement of the
single strand of DNA from which it was transcribed except that the
base thymine (T) in the DNA strand is replaced by the base uracil
(U) in the RNA strand.
- Trophic Level
-
(Definition)
Groupings of species in a community based on their feeding
relationships. These food based groupings are called trophic levels.
Trophic level 1 is composed of producers that form the base of all
ecosystems. Organisms in level 1 are eaten by organisms in level 2;
organisms in level 2 are eaten by organisms in level 3; organisms in
level 3 are by organisms in level 4, and so on.
- True-Breeding
-
(Definition)
Describes organisms that when bred only have offspring with the same
phenotype as the parents; the organism is homozygous at the
genotypes of interest.
- V -
- Valence Electrons
-
(Definition)
The electrons in the outermost shell of the atom, which are
available for chemical bonding. This diagram of a carbon atom
illustrates that carbon has four (4) valence electrons.

- Variable
-
(Definition)
A characteristic of a subject that can vary from one subject to the
next or over time. A variable may be a category to which a subject
can be assigned (for example: male or female) or it may be measured
precisely (for example: body mass).
- Vesicle
-
(Definition)
Membrane-bound structure used to isolate and transport materials in a
cell.
- Virus
-
(Definition)
An acellular infectious particle, made of a nucleic acid surrounded
by a protein coat and sometimes with an additional envelope. Viruses
need to infect a host in order to replicate.
- Z -
- Zygote
-
(Definition)
The newly formed diploid cell that is produced when two haploid
gametes unite. In animals this occurs when a sperm fertilizes an
egg.
Biologists have different ways of representing chemical structures. Each type conveys
different information.
Portions of this course are built on materials developed and generously provided by University of Maryland University College, made
available with permission under a CC-BY-NC license.
Direct use of specific activities and media elements are noted throughout the
course.
Development Team
The development and ongoing improvement of an OLI course is always a
collaborative effort, built on the time, talent and commitment of many
individuals. This OLI Biology Course is no exception.

| Course Authors: |
Affiliation |
| Ana Marie Barral |
National University |
| Beth Carpenter |
University of Maryland University College |
| Anya Goodman |
California Polytechnic State University |
| Jon Hoekstra |
Heartland Community College |
| Brian Kram |
Prince George Community College |
| Debra McLaughlin |
University of Maryland University College
|
| Wendy Riggs |
Redwood Community College
|
| Gordon Rule |
Carnegie Mellon University |
| Suzanne Wakim |
Butte Community College |
| Kathy Warner |
University of Maryland University College |
| Other Contributors: |
Affiliation |
| Diana Bajzek |
Carnegie Mellon University |
| Norman Bier |
Carnegie Mellon University |
|
Michaele Brown |
Carnegie Mellon University |
| Renee Fisher |
Carnegie Mellon University
|
| Jim Greeno |
Carnegie Mellon University
|
| Michelle Meyers |
Editor |
| Candace Orsetti |
University of Maryland University College |
| Sandy Raysor |
Carnegie Mellon University |
| Robin Searles-Adenegan |
University of Maryland University College |
| Keris Simmonds |
University of Maryland University College |
| Cheryl Templeton |
Carnegie Mellon University |
| Daniel Williams |
Winston Salem State University |
 Biology montage. Photographs donated by Eric Guinther, 2004.
Wikimedia.
Biology montage. Photographs donated by Eric Guinther, 2004.
Wikimedia.
 Every day, we are bombarded with reports of new discoveries in biology
that are exciting, relevant, and sometimes controversial. See University of Oxford (2012, June
18)
Every day, we are bombarded with reports of new discoveries in biology
that are exciting, relevant, and sometimes controversial. See University of Oxford (2012, June
18)